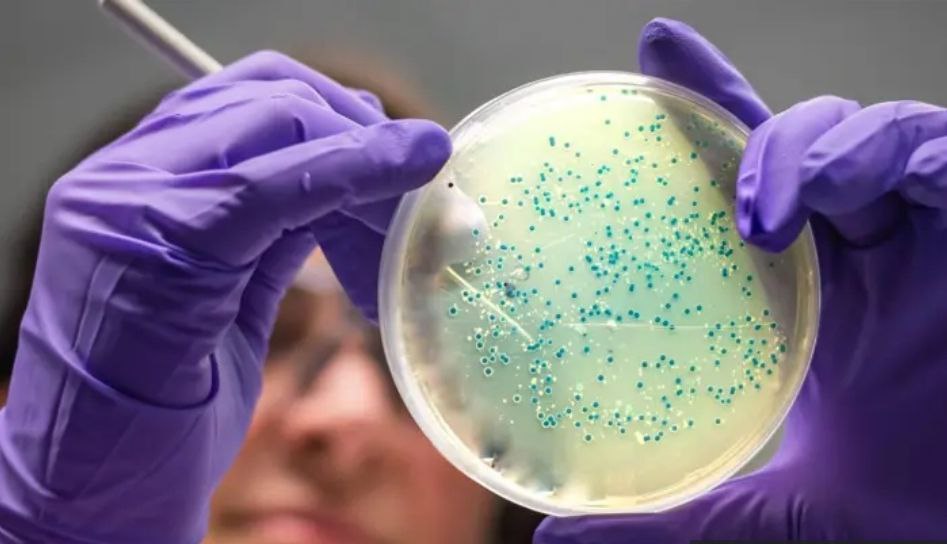

برگزاری نشست تخصصی با هدف توسعه رشته کریکت در هیئت ورزشهای ناشنوایان استان تهران
به گزارش پایگاه خبری پهنه پرواز، فتانه امیری، رئیس انجمن کریکت فدراسیون ورزشهای ناشنوایان، با علی پازوکی، رئیس هیئت ورزشهای ناشنوایان استان تهران، و حسین


به گزارش پایگاه خبری پهنه پرواز، فتانه امیری، رئیس انجمن کریکت فدراسیون ورزشهای ناشنوایان، با علی پازوکی، رئیس هیئت ورزشهای ناشنوایان استان تهران، و حسین

تیم پاراتنیس روی میز دوبل پسران ایران موفق شد با شکست تیم قزاقستان به فینال بازیهای پاراآسیایی جوانان صعود کند. به گزارش پایگاه خبری پهنه

یک فعال حقوق معلولان با اشاره به اجرای ناقص قانون حمایت از حقوق افراد دارای معلولیت در نامهای به مسئولان درخواست کرد که برای اجرای

پژوهشهای جدید نشان میدهد که تجمع چربی در بدن حتی در افرادی با وزن ظاهراً سالم میتواند خطر حملات قلبی و سکته مغزی را افزایش

رئیس مرکز روابط عمومی و اطلاعرسانی وزارت بهداشت اعلام کرد که متأسفانه میزان مرگ در برخی استانهای کشور از میزان تولد جلو زده است. حسین

پژوهشگران دانشگاه تگزاس A&M موفق شدند با یک روش نوین که به گفته خودشان «ابرشارژ سلولی» نام دارد، سطح انرژی سلولهای پیر و آسیبدیده را

دانشمندان با بررسی علمی آنچه بهعنوان «قاعده مادربزرگها» در مورد شستن پوست شناخته میشود، دریافتند که این توصیههای سنتی برای شستن مناطقی از بدن که

برخلاف باور رایج میان عموم مردم، پژوهشهای علمی نشان میدهد که مصرف ویتامین C (C) نه میتواند از بروز سرماخوردگی جلوگیری کند و نه اثر

آرمانهای درمان بیماریهای سختدرمان مانند سرطان در ایران با پیشرفتهای اخیر در پزشکی هستهای بیش از گذشته به واقعیت نزدیک شده است و در استان

آب آشامیدنی بخش اساسی سلامت انسان است و انتخاب بین آب بستهبندی (آب بطری) و آب لولهکش شهری موضوعی مهم در سلامت عمومی و سبک

بهگزارش خبرنگار پایگاه خبری پهنه پرواز به نقل از کتاب ایران (ایبنا)، ششمین جشنواره ملی داستان کوچک ایرانی با انتشار فراخوان از سوی انجمن ملی

آیین پاسداشت طرح ملی سیمرغ کوههای ایران با هدف بررسی و قدردانی از صعود ۳۱ قله مرتفع در ۳۱ استان کشور، در تالار استاد شهید

قهوهخانه «رمضون یخی» یکی از قدیمیترین و خاطرهانگیزترین قهوهخانههای تهران است که هنوز هم با همان هویت تاریخی خود به فعالیت ادامه میدهد و پاتوقی

اولین مرکز جامع توانمندسازی افراد دارای معلولیت در استان تهران ظرف یک ماه آینده افتتاح خواهد شد؛ مرکزی که با هدف ارائه خدمات تخصصی آموزشی،

عشق همیشه عامل اصلی نگهداشتن رابطههای زوجین نیست؛ تحقیقات و تجربه روانشناسان نشان میدهد که سازش مؤثر و هوشمندانه در روابط میتواند پیوند زندگی مشترک

رئیس سازمان بهزیستی کشور اعلام کرد که پرداخت مستمری به مددجویان این سازمان از این پس بر اساس دهکهای اقتصادی خانوادهها انجام خواهد شد تا

پیشتازی بانوان با ۱۴ مدال؛ افق روشن برای المپیکهای آینده کاروان بزرگ «عاشقان ایران» در بیستوپنجمین دوره بازیهای المپیک تابستانی ناشنوایان ۲۰۲۵ توکیو، با کسب

قیمت سمعک به ۱۰۰ میلیون تومان رسید؛ ناشنوایان: بیمه هیچ کمکی نمیکند افزایش چشمگیر قیمت سمعک و نبود حمایتهای مؤثر بیمهای، زندگی بسیاری از ناشنوایان

نمایشگاه جدید آثار عبدالحمید پازوکی با عنوان «۱۲ روز» از ۲۱ آذرماه تا ۹ دیماه در گالری سهراب برپا خواهد شد؛ رویدادی هنری که در

در تقویم ایرانی، روز زن و مادر تنها یک مناسبت تقویمی نیست؛ بزرگداشتی است بر مقام والای زن، بر وجودی که لطافت را با استقامت

هر مادری، در سکوت شب و شلوغی روز، تکیهگاهی میسازد که بر دوش آن، نسلها قامت راست میکنند. مهر مادرانه نه در کلام، بلکه در

برخی از آموزههای رایج روانشناسی — مانند اهمیت «خودآگاهی»، «خودباوری» و «خودبهبوددهی» — در نگاه نخست مثبت و سازنده به نظر میرسند. اما «پارادوکس روانشناسی

ادبیات معاصر ایران این روزها با روندی تازه روبهروست: «معنازدایی» بهعنوان یک ژست ادبی و رویکرد غالب در آثار نویسندگان جوان و نوگرا ظاهر شده

خلاقیت اغلب بهعنوان لحظهای ناگهانی و الهامبخش تصور میشود؛ لحظهای که ایدهای ناب از ناکجاآباد به ذهن خطور میکند. اما روانشناسی خلاقیت تصویر دقیقتری ارائه

به گزارش پایگاه خبری عصر ایران، «رشد فردی» فرایندی آگاهانه و مستمر است که به فرد کمک میکند خود را بهتر بشناسد، تواناییها و ضعفهایش

به گزارش پایگاه خبری پهنه پرواز کنگره ۶۰، خودشناسی بهعنوان ابزاری بنیادین در کاهش توقعات فردی و ساختن روابط سالم مطرح شده است. در گفتوگو

به گزارش پایگاه خبری پهنه پرواز، اورژانس اجتماعی وابسته به سازمان بهزیستی کشور اعلام کرده است که ۳۸۵ مرکز این مجموعه در سراسر کشور بهصورت

مصطفی نکولعلآزاد، رئیس فدراسیون ورزشهای ناشنوایان، با اشاره به دستاوردهای اخیر کاروان ایران در المپیک ناشنوایان تأکید کرد که بزرگترین چالش این حوزه همچنان تأمین

علی سامخانیان نخستین دیدار خود را در مسابقات پاراتنیس روی میز بازیهای پاراآسیایی جوانان با موفقیت پشت سر گذاشت و آغاز درخشانی برای کار خود

بدن زن صرفاً یک کالبد زیستی نیست؛ بیشتر شبیه دفتری قدیمی است که هر تجربه خطی تازه بر صفحاتش میگذارد. برخی خطها پررنگاند و برخی

رقابتهای پاراوزنهبرداری دختران در دستههای وزنی ۴۱ و ۴۵ کیلوگرم با کسب دو مدال ارزشمند طلا توسط نمایندگان کشورمان، آغاز درخشانی را برای تیم ایران

کتاب «هنر ظریف بیخیالی» رویکردی متفاوت به زندگی ارائه میدهد — برخلاف توقع برخی از آثار خودیاری، این کتاب ما را به پذیرش واقعیتها، تمرکز

به گزارش پایگاه خبری پهنه پرواز بسیاری از ما بارها با وسوسه خرید ناگهانی یا فشار اجتماعی برای «همگانی بودن» مواجه میشویم — اما روانشناسان

در جدیدترین شبیهسازی انجامشده توسط هوش مصنوعی ChatGPT، نتایج گروه ایران در جام جهانی پیشبینی شده است. طبق این تحلیل، ایران با پیروزی مقابل مصر

سؤالی که بسیاری از افراد در انتخاب میان لبنیات با آن مواجه هستند، این است که پنیر سالمتر است یا ماست؟ متخصصان تغذیه با بررسی

بسیاری از ما از کودکی آموختهایم که «فداکاری بیدریغ» در روابط، نشانه عشق و مسئولیتپذیری است؛ اما روانشناسان هشدار میدهند که این «الگوی نجاتدهنده» میتواند

به گزارش پایگاه خبری پهنه پرواز بیشفکری یکی از چالشهای رایج ذهنی است که میتواند تمرکز، آرامش و اعتمادبهنفس را کاهش دهد. با این حال،

سومین مرحله استعدادیابی دانشآموزان دختر ناشنوا و تلفیقی استان کرمان با هدف شناسایی استعدادهای برتر و تقویت پشتوانه تیمهای پایه برگزار شد. این رویداد ورزشی

وزیر تعاون، کار و رفاه اجتماعی از آغاز مرحله پنجم طرح کالابرگ با شیوهای جدید خبر داد و اعلام کرد که حساب سرپرستان خانوار تحت

دکتر محمد جمالیان، نماینده مردم اراک و عضو کمیسیون بهداشت و درمان مجلس شورای اسلامی، در جریان بازدید نمایندگان مجلس و مسئولان جامعه خیرین حامی

کمیته ملی پارالمپیک با هدف تسهیل پوشش خبری و ارائه خدمات رسانهای گستردهتر به رسانههای داخلی و روابط عمومی فدراسیونهای ورزشی، فضای ابری ویژهای را

به گزارش پایگاه خبری پهنه پرواز به نقل از یورونیوز فارسی، در گزارشی که سازمان ملل منتشر کرده است، تأکید شده است که «رقابت جهانی

به گزارش پایگاه خبری پهنه پرواز به نقل از منابع معتبر پزشکی، عفونت ریه — چه باکتریایی، ویروسی یا قارچی — میتواند با طیف وسیعی

به گزارش پایگاه خبری پهنه پرواز به نقل از وبسایت علمی (منتشرشده در ترجمه مقاله اصلی)، سلولها برای تشخیص اینکه «کجای بدن هستند» و «چه

به گزارش پایگاه خبری پهنه پرواز به نقل از وبسایت فارسی Euronews، دستگاههای پایش قند خون ساخت Abbott Diabetes Care به نام حسگرهای FreeStyle Libre

به گزارش خبرگزاری خبرآنلاین، تحقیقات جدید نشان دادهاند که ویتامین C میتواند تا حد قابل توجهی از سلولهای ریه در برابر آسیب ناشی از ذرات

به گزارش خبرگزاری خبرآنلاین، پژوهشی جدید که در مجله Nature Communications منتشر شده، نشان داده است که سلولها و مولکولهای ریز مغزی چگونه شبکههای بزرگ

به گزارش پایگاه خبری پهنه پرواز، مقالهای با موضوع «چگونه آموزش مجدد شریک خود را متوقف کنیم: پذیرش به عنوان یک عمل عشق بزرگسالان» تأکید

به گزارش پایگاه خبری پهنه پرواز، جمعی از مددجویان سازمان بهزیستی و کمیته امداد با ارسال پیام و گزارشهای مردمی نسبت به تأخیر واریز مستمری،

به گزارش پایگاه خبری پهنه پرواز، دکتر سعید سلگی مدیر ورزش قهرمانی کمیته ملی پارالمپیک و سخنگوی کاروان ایران در بازیهای پاراآسیایی جوانان، در نشست

لیگ برتر پومسه باشگاههای کشور در بخش بانوان، با معرفی قهرمانان و برترینها در خانه تکواندو به کار خود پایان داد. این رقابتها که با

به گزارش پایگاه خبری پهنه پرواز بنا بر اعلام روابطعمومی هفتمین جشنواره بینالمللی فیلم پرواز، همزمان با آغاز این دوره از جشنواره، حکم دبیر هنری

به گزارش پایگاه خبری پهنه پرواز، گروهی از پژوهشگران آمریکایی با روش نوآورانهای توانستهاند از طریق انتقال میتوکندری — «باتریهای طبیعی» سلول — به احیای

به گزارش پایگاه خبری پهنه پرواز، حدود ۲۴۰۰ سال پیش، اراتوستن، دانشمند یونانی، با استفاده از یک تکه چوب و سایه آن توانست محیط زمین

دکتر فتانه امیری افراد دارای معلولیت، بخشی جداییناپذیر از جامعه هستند و مانند سایر شهروندان از حقوق اساسی برخوردارند. این حقوق شامل دسترسی برابر به

به گزارش پایگاه خبری پهنه پرواز، براساس تازهترین گزارشهای سازمان جهانی بهداشت (WHO)، بیماری سرخک دوباره با سرعت در سطح جهانی در حال شیوع است.

به گزارش پایگاه خبری پهنه پرواز، وزارت بهداشت در تازهترین بیانیه خود خطاب به عموم مردم اعلام کرده است که مصرف دنبه گوسفندی تأثیری بر

به گزارش پایگاه خبری عصر ایران، والدین زیادی هستند که گاهی بدون قصد و از سر خستگی و تنش، فریاد بر سر فرزندانشان میزنند؛ اما

به گزارش پایگاه خبری پهنه پرواز، بدن زن تنها یک ساختار زیستی نیست، بلکه همانند دفتری قدیمی است که هر تجربه خطی تازه بر صفحات

به گزارش پایگاه خبری پهنه پرواز، دومین جلسه مجمع خیرین و حامیان فدراسیون ورزشهای ناشنوایان همزمان با روز جهانی معلولان و با حضور مصطفی نکولعلآزاد

به گزارش پایگاه خبری پهنه پرواز، تنها دو روز تا آغاز بازیهای پاراآسیایی جوانان دبی ۲۰۲۵ باقی مانده و کاروان ورزشی کشورمان خود را برای

به گزارش پایگاه خبری پهنه پرواز، همزمان با افزایش آلودگی هوا، نگاه بسیاری از خانوادهها به سمت تعطیلی مدارس معطوف میشود؛ گویی سادهترین و سریعترین

پژوهشگران در آزمایشگاه زیستمولکولی اروپا (EMBL) با استفاده از یک ابزار جدید مبتنی بر هوش مصنوعی، موفق شدند معمای بیش از یک قرن در زمینه

بر اساس گزارش منتشرشده، یارانه نقدی و کالابرگ آذر ۱۴۰۴ برای دهکهای مشمول افزایش یافته است. به گزارش پایگاه خبری پهنه پرواز طبق اعلام، برای

ما گاهی با وجود اینکه از خطر میترسیم، خودمان آگاهانه سراغ ترس میرویم — فیلم ترسناک، ترن هوایی، خانه ترسناک یا هر تفریح مهیج دیگری.

پژوهشها نشان میدهد که مردم کشور ژاپن، با داشتن هفت عادت ساده روزمره، نسبت به جمعیت خود بیشترین تعداد صدسالگی را دارند — راز آنها

بهدنبال صدور حکمی از سوی مصطفی نکولعلآزاد، رئیس فدراسیون ورزشهای ناشنوایان، هادی شفقی بهعنوان سرپرست انجمن دو و میدانی این فدراسیون منصوب شد. به گزارش

مراسمی با هدف قدردانی از نقشآفرینان کاروان ایران در المپیک ناشنوایان ۲۰۲۵ توکیو، در اداره ورزش و جوانان شهرستان ری برگزار شد. در این مراسم،

تیم ملی پاراشنای جوانان ایران با ترکیبی کامل و قدرتمند عازم بازیهای پاراآسیایی جوانان امارات میشود. در این دوره، ملیپوشان کشورمان شامل امیررضا بهرامی، سپهر

روایتی از شکاف شفافیت در نهادهای مدنی و ضرورت ایجاد بازرسی ویژه این مقاله به دنبال تخریب هیچ نهاد یا گروهی نیست؛ مسئله، نبود سازوکار

افراد دارای معلولیت نقش بسیار مهمی در شکلدهی جوامع ما ایفا میکنند؛ آنها با نوآوری، رهبری و تلاش برای عدالت، تأثیرگذار هستند. با این حال،

ما گاهی جذب افرادی میشویم که شخصیت و رفتارشان کاملاً متفاوت از ماست: فردی آرام ممکن است عاشق کسی پرشور و تکانشی شود. به گزارش

هر روز ممکن است در زندگی روزمره، مراقبتها و محبتهای سادهٔ اطرافیان — مانند آماده کردن یک قهوه داغ یا یک لبخند — تبدیل به

به گزارش پایگاه خبری پهنه پرواز ارتباطات نقش محوری در زندگی شخصی و حرفهای ما دارند. از گفتگوهای روزمره گرفته تا روابط کاری و خانوادگی،

توجه انتخابی به توانایی ما برای تمرکز روی یک محرک مشخص در میان مجموعهای از محرکهای مختلف اطراف گفته میشود.به بیان سادهتر، یعنی قدرت انتخاب

روز جهانی افراد دارای معلولیت که هر ساله در سوم دسامبر (۱۲ آذر) گرامی داشته میشود، فرصتی برای بازنگری در نگاه جامعه و تقویت توجه

محمد سلمانی شورغین، در مصاحبه با پایگاه خبری پهنه پرواز از چالش ها و موفقیت های خود می گوید. او فارغالتحصیل رشته کامپیوتر در مقطع

فراگیرسازی یعنی طراحی آموزش به شکلی که همهٔ دانشآموزان—با هر نوع توانایی، تفاوت فردی یا نیاز ویژه—بتوانند یاد بگیرند و در کلاس حضور فعال داشته

روز جهانی افراد دارای معلولیت، فرصتی دوباره است تا با افتخار و احترام، اراده، توانایی و حضور الهامبخش میلیونها فرد دارای معلولیت را در جامعه

به گزارش پایگاه خبری پهنه پروازبه مناسبت گرامیداشت روز جهانی معلولین، جشنواره ورزشی ویژه توانیابان در سالن شهید ثامنی شهرداری اراک برگزار شد. این رویداد

عفونت ریه زمانی رخ میدهد که باکتریها، ویروسها یا قارچها به راههای هواییِ تحتانی — شامل نای، برونشها یا کیسههای هوایی (ریه) — حمله میکنند.

سازمان بهزیستی استان تهران اعلام کرد امسال مددجویان دارای معلولیت که دارای مدرک فنی‑حرفهای هستند، میتوانند تا ۲۰۰ میلیون تومان وام قرضالحسنه با نرخ ۴٪

انسداد روده، وضعیتی است که در آن عبور طبیعی مواد غذایی، مایعات و گازها در روده — چه روده کوچک و چه روده بزرگ —

به گزارش پایگاه خبری پهنه پرواز Wegovy / Mounjaro و داروهای مشابه برای کاهش وزن — که بهعنوان «آمپولهای لاغری» شناخته میشوند — این روزها

رئیس سازمان بهزیستی کشور در نشست اخیر مدیران این سازمان تأکید کرد برای حل چالشها و پیشبرد مأموریتهای بهزیستی، لازم است رویکرد «اجتماعیسازی» و «جریانسازی»

در تازهترین مطلب منتشرشده در کنگره ۶۰ آمده است که تغییر صفات و شخصیت انسان، «یکشبه» یا ناگهانی ممکن نیست. به گزارش پایگاه خبری پهنه

سازمان ملل متحد شعار رسمی روز جهانی افراد دارای معلولیت در سال ۲۰۲۵ را اعلام کرد. به گزارش پایگاه خبری پهنه پرواز، شعار امسال بر

پانزدهمین مرحله اردوی آمادگی تیم ملی پارادوومیدانی جوانان، در مسیر آمادهسازی برای حضور در مسابقات پاراآسیایی جوانان امارات ۲۰۲۵، از دهم تا شانزدهم آذرماه در

کتاب «روانشناسی آموزش و توانبخشی افراد با نیازهای ویژه» یکی از منابع جامع و کاربردی در حوزه آموزش ویژه است که با رویکردی علمی، به

به گزارش پایگاه خبری پهنه پرواز تیم ملی پاراشنای ایران با ترکیبی کامل و امیدبخش، در پنجمین دوره بازیهای پاراآسیایی جوانان دبی ۲۰۲۵ شرکت خواهد

به گزارش پایگاه خبری پهنه پرواز؛ «معبد قدمگاه آذرشهر» بنایی صخرهای با قدمتی تقریباً ۳٬۰۰۰ تا ۵٬۰۰۰ ساله است که در دامنه کوه، نزدیک روستای

به گزارش پایگاه خبری پهنه پرواز؛ کارشناسان تربیتی تأکید میکنند که روش «تربیت کنترلمحور» — یعنی تکیه صرف بر نصیحت، دستور و اعمال قدرت —

به گزارش پایگاه خبری پهنه پرواز؛ تحقیقات جدید دانشمندان نشان میدهد مغز انسان در طول زندگی از بدو تولد تا پیری، پنج «دوره» یا «عصر»

به گزارش پایگاه خبری پهنه پرواز؛ تغذیه مناسب نقش مهمی در حمایت از ریهها ایفا میکند — هم در پیشگیری از مشکلات ریوی و هم

مصطفی رحماندوست، شاعر، نویسنده، مترجم و یکی از تأثیرگذارترین چهرههای ادبیات کودک و نوجوان ایران، با بیش از پنج دهه فعالیت ادبی و فرهنگی، نقشی

به گزارش پایگاه خبری پهنه پرواز به نقل از ستاره صبح؛ در دنیای پرهیاهوی امروز، «شفافیت فکر» یکی از ارزشمندترین مهارتهایی است که میتوان در

پژوهش تازهای که توسط محققان انجام شده و در “فهرست ۱۰۰ انتخاب پرریسک مردم” جای گرفته است، نشان میدهد تصمیمات شغلی در زندگی مدرن بیش

به گزارش پایگاه خبری پهنه پرواز؛ سفر زیارتی مشهد مقدس در سال ۱۴۰۴ مطابق روال هرساله و با برنامهریزی و هماهنگی بنیاد خیریه معلولین ایرانیان

یادگیری همیارانه شرایطی است که در آن دو یا چند دانشآموز برای درک بهتر یک مفهوم یا انجام یک تکلیف، بهصورت مشترک همکاری میکنند. در

به گزارش پایگاه خبری پهنه پرواز؛ نشست توجیهی و فنی سرپرستان تیمهای اعزامی به پنجمین دوره بازیهای پاراآسیایی جوانان دبی ۲۰۲۵ با حضور رییس و

در آستانه روز جهانی افراد دارای معلولیت ۲۰۲۵، سازمان ملل متحد شعار امسال را با عنوان «تقویت رهبری افراد دارای معلولیت برای آیندهای فراگیر و

به گزارش پایگاه خبری پهنه پرواز در آستانه روز جهانی آگاهیبخشی در حوزه معلولیت و بنا بر اعلام روابطعمومی جشنواره بینالمللی فیلم پرواز، فراخوان هفتمین

به گزارش پایگاه خبری پهنه پرواز تحقیقات روانشناختی و اجتماعی متعدد نشان میدهند که «ایمان و معنویت» (یا دینداری) — وقتی به شکل سالم و

یکی از سوالهای رایج ورزشکاران و افرادی که به دنبال کاهش وزن هستند این است: دویدن یا پیادهروی در شیب مثبت، کدام تأثیر بیشتری بر

سازمان جهانی بهداشت (WHO) به تازگی راهنمای جامع و بهروزرسانی شدهای برای تشخیص و درمان ناباروری منتشر کرده است. به گزارش پایگاه خبری پهنه پرواز

در فضای فکری و رسانهای امروز ایران، جامعه میان دو صدای متضاد گرفتار شده است: روایتی که جهان را از دیدگاه ایدئولوژیک محدود میبیند و

در گزارشی از عصر ایران بررسی میشود که بسیاری از ما وقتی احساس میکنیم «تنبل» شدهایم، در واقع گرفتار قضاوت سریع درباره خود هستیم —

به گزارش پایگاه خبری پهنه پرواز مطابق گزارش ISNA، یبوست مشکلی است رایج که کیفیت زندگی را تحت تأثیر قرار میدهد. اما تحقیقات جدید نشان

حضور یک فرد با سابقه جنایی در یک برنامه تلویزیونی، نه تنها شوکی به بینندگان وارد کرد، بلکه فرصتی برای تأمل درباره مسیر تولید و

در جامعه امروز، تصویری که رسانهها و ساختارهای اقتصادی از «زیبایی» ارائه میدهند، بدن طبیعی را به حاشیه رانده و «بدن استاندارد و عملشده» را

بسیاری از افراد تجربه ناخوشایندی هنگام دیدن عکس خود دارند؛ احساس «بد بودن» یا «زشت دیده شدن» در تصاویر، معمولتر از آن است که فکر

یکی از چالشهای بزرگ در مسیر دستیابی به اهداف، عادت به غر زدن و شکایت مداوم است. روانشناسان معتقدند که این رفتار نه تنها انرژی

با افزایش موارد عفونتهای تنفسی، پرسش درباره «بهترین روشهای پاکسازی ریه از عفونت» به یکی از دغدغههای رایج شهروندان تبدیل شده است. پزشکان تأکید دارند

محققان با تحلیل اسکن مغزی حدود ۳٬۸۰۰ نفر از نوزادی تا ۹۰ سالگی نشان دادهاند که مغز انسان در طول زندگی، از بدو تولد تا

کاروان اعزامی جمهوری اسلامی ایران برای حضور در پنجمین دوره بازیهای پاراآسیایی جوانان دبی، با ترکیبی مقتدر و انگیزهای مضاعف راهی این رقابتها میشود. این

میتوانستیم عملکرد بهتری داشته باشیممسئولیت نتایج کاروان با من است رئیس فدراسیون ورزش های ناشنوایان پس از پایان المپیک ۲۰۲۵ توکیو گفت: رشد مدال آوری

وزارت ورزش و جوانان در پیامی رسمی، از تلاش و افتخارآفرینی کاروان «عاشقان ایران» در بیستوپنجمین دوره بازیهای المپیک ناشنوایان در توکیو قدردانی کرد. به

مراسم اختتامیه بیستوپنجمین دوره بازیهای المپیک ناشنوایان با حضور کاروان ورزش ایران برگزار شد. در این مراسم، حسین تبرته فراهانی ورزشکار شایسته کاراته، وظیفه پرافتخار

به گزارش پایگاه خبری پهنه پرواز، رقابتهای قهرمانی آسیا و اقیانوسیه فوتبال هفت نفره به میزبانی اندونزی برگزار شد و تیم ملی کشورمان با اقتدار

نویسنده: بیژن همدرسی حضور جناب دکتر ظفرقندی وزیر محترم بهداشت، درمان و آموزش پزشکی در جلسه علنی چهارم آذرماه ۱۴۰۴ مجلس و پاسخ به پرسشهای

به گزارش پایگاه خبری پهنه پرواز، معاون توسعه مدیریت و منابع سازمان بهزیستی کشور از نهاییشدن مجوز برگزاری دومین آزمون استخدامی ویژه افراد دارای معلولیت

به گزارش پایگاه خبری پهنه پرواز، ایجاد هیجان مثبت در دانشآموزان یکی از مهمترین عوامل تأثیرگذار بر یادگیری پایدار و افزایش انگیزه تحصیلی است. یکی

این مشکل ممکن است به دلیل اختلال در جهتیابی و تشخیص درست سمتها در برخی از دانشآموزان باشد. وقتی کودک قادر به تشخیص دقیق راست

سهراب سپهری، شاعر و نقاش برجسته معاصر ایران، با آثارش دنیایی خاص از آرامش و تأمل را برای مخاطبان خود به ارمغان آورد. خانه او،

با تغییرات سریع فرهنگی و اجتماعی در جامعه، یکی از نگرانیهای اصلی والدین، موضوع ادب و احترام در نسل نوجوان است. بسیاری از پدر و

همایش جدیدی با هدف معرفی ظرفیتهای گردشگری خراسان جنوبی و به ویژه بیابان لوت برگزار شد که در آن علاوه بر محققان، سرمایهگذاران بومی مقیم

تغییرات مثبت و رشد فردی اغلب میتواند مانند یک تجربه غیرملموس و دشوار برای شناسایی و پذیرش باشد. به گزارش پایگاه خبری پهنه پرواز این

آیا تا به حال توجه کردهاید که افراد متولد دهه ۶۰ معمولاً جوانتر از همنسلان خود در دهههای ۷۰ و ۸۰ به نظر میرسند؟ این

به گزارش پایگاه خبری پهنه پرواز هموروئید و سرطان روده دو بیماری متفاوت هستند که علائم مشابهی را در برخی موارد به اشتراک میگذارند، اما

مدیریت خشم در محیط کار یکی از مهارتهای ضروری برای هر کارمند است، بهویژه زمانی که عصبانیت و نارضایتی از کارفرما به وجود میآید. به

فاطیما بوش از مکزیک، عنوان «دختر شایسته جهان» در سال 2025 را به خود اختصاص داد و به عنوان ملکه زیبایی جهان معرفی شد. این

کاروان ورزش ایران با نام «عاشقان ایران»، پس از درخشش بینظیر در بیست و پنجمین دوره بازیهای المپیک ناشنوایان که در توکیو برگزار شد، به

تیم ملی فوتبال هفت نفره ایران، که اخیراً موفق به کسب مدال طلای مسابقات قهرمانی آسیا و اقیانوسیه شده است، امروز به میهن بازگشت. این

تحقیقات جدید نشان میدهد که نسل Z (۱۸ تا ۲۶ ساله) بیش از سایر نسلها از مرخصی استعلاجی استفاده میکند. به گزارش پایگاه خبری پهنه

به گزارش پایگاه خبری پهنه پرواز به نقل از خبرگزاری مهر، سیدسعید هاشمی نظری، معاون بهداشت دانشگاه علوم پزشکی شهید بهشتی، مهمترین روشهای پیشگیری از

کمیته امداد امام خمینی (ره) مستمری خانوارهای تحت پوشش خود را در سال ۱۴۰۴ افزایش داد تا حمایت از اقشار کمدرآمد و نیازمند مؤثرتر شود.

در سالهای اخیر، درمان سرطان روده بزرگ (کولون) تحولات قابل توجهی یافته است و گزینههای جدیدی برای بیماران فراهم شده است. به گزارش پایگاه خبری

استرس بخشی طبیعی از زندگی است، اما وقتی بیش از حد شود، سلامت جسم و روان را تهدید میکند. خوشبختانه با راهکارهای ساده و مؤثر

برای آنکه ۴۰۰ هزار میلیارد تومان بودجه آموزش و پرورش به نتیجه و اثر واقعی منجر شود، نیاز به شجاعت تصمیمگیری و توافق ملی بر

وزارت ورزش و جوانان در پی قهرمانی ارزشمند تیم ملی فوتبال هفتنفره جمهوری اسلامی ایران در رقابتهای آسیا–اقیانوسیه، پیام تبریکی صادر کرد و این موفقیت

سازمان ملل متحد شعار رسمی روز جهانی افراد دارای معلولیت در سال ۲۰۲۵ را اعلام کرد. شعار امسال بر نقش کلیدی رهبری افراد دارای معلولیت

گاهی در سکوت مراقبه، یا هنگام شنیدن موسیقیای عمیق، لرز ظریفی در درونمان شکل میگیرد؛ سینه گرم میشود، نفس آرامتر جریان مییابد و حس میکنیم

عرفان ستاری، آزادکار توانمند تیم ملی، با پیروزی مقتدرانه در دیدار ردهبندی وزن ۹۷ کیلوگرم مسابقات کشتی آزاد المپیک ناشنوایان ۲۰۲۵، به مدال برنز دست

محمدرسول قمرپور، آزادکار شایسته کشورمان، در رقابتهای کشتی آزاد وزن ۱۲۵ کیلوگرم بازیهای المپیک ناشنوایان ۲۰۲۵ به مقام نایبقهرمانی دست یافت و مدال نقره این

زینب حسنپور، کاراتهکای توانمند کشورمان، در رقابتهای کاراته بیستوپنجمین دوره بازیهای المپیک ناشنوایان توانست با عملکردی موفق به فینال وزن منهای ۵۵ کیلوگرم صعود کند

بررسی دگرگونیهای تاریخی مفاهیم دینی از جذابترین عرصههای پژوهشی در فرهنگ اسلامی است. بسیاری از اصطلاحات رایج دینی، در گذر زمان معانی تازهای یافتهاند؛ گاه

کمکهزینه تأمین وسایل بهداشتی مربوط به آبانماه ۱۴۰۴ برای افراد دارای ضایعه نخاعی و همچنین معلولان شدید و خیلی شدید بسترگرا تحت پوشش سازمان بهزیستی

در رقابتهای کاراته بیست و پنجمین دوره بازیهای المپیک ناشنوایان در توکیو، سارا ادریا نماینده شایسته کشورمان در وزن منهای ۶۱ کیلوگرم توانست مدال برنز

به گزارش پایگاه خبری پهنه پرواز به نقل از خبرآنلاین، حقوقدانان میگویند نوجوانان کار در ایران، با وجود ظاهر «فعال و مستقل»، در حقیقت قربانی

زیگورات چغازنبیل، یکی از باستانیترین و باشکوهترین آثار معماری تمدن ایلام، در منطقه شوش خوزستان واقع شده است. این بنای تاریخی که حدود سال ۱۲۵۰

لوازم تحریر فانتزی شامل خودکارها، مدادها، دفترها و دیگر وسایلی هستند که طراحیهای جذاب، رنگهای متنوع و شخصیتهای کارتونی دارند. استفاده از این ابزارها میتواند

به گزارش پایگاه خبری پهنه پرواز به نقل از فرارو، فیلم «دختر لر» یکی از آثار برجسته و تاثیرگذار تاریخ سینمای ایران است که مسیر

به گزارش عصر ایران، دانشمندان علوم اعصاب میگویند بسیاری از تصمیمهای انسان پیش از رسیدن به سطح آگاهی در مسیرهای عصبی عمیق مغز شکل میگیرند.

به گزارش پایگاه خبری همشهری آنلاین، متخصصان معتقدند افرادی که بالای ۵۰ سال هستند و تاکنون ورزش منظمی نداشتهاند، میتوانند با فعالیت بدنی کوتاه و

در دنیایی که نویسندگان نگران کوتاه شدن دامنه توجه خوانندگان هستند، هانا توماس اووزه در یادداشتی میگوید کنار گذاشتن یک رمان پیش از پایان، لزوماً

به گزارش پایگاه خبری پهنه پرواز و به نقل از روابطعمومی فدراسیون ورزشهای ناشنوایان، در ادامه رقابتهای کشتی فرنگی بیستوپنجمین دوره بازیهای المپیک ناشنوایان ۲۰۲۵

به گزارش پایگاه خبری پهنه پرواز، صبح روز پنجشنبه به همت خانم نوری، مسئول مرکز نیکوکاری شهدای گمنام، و با هماهنگی خانم ذاکری، رئیس کمیته

به گزارش پایگاه خبری پهنه پرواز و بنا بر اعلام روابطعمومی کمیته ملی پارالمپیک، روحالله رستمی ملیپوش پرافتخار پاراوزنهبرداری ایران، عصر امروز در رقابتهای دسته

به گزارش پایگاه خبری پهنه پرواز و به نقل از روابطعمومی فدراسیون ورزشهای جانبازان و توانیابان، کاروان کشورمان با ترکیب تنها شش ورزشکار در رشتههای

برخی اقدامات به ظاهر مهربانانه برای حمایت از گربهها و حیوانات شهری، در واقع میتواند به محیط زیست و خود حیوانات آسیب برساند. به گزارش

سازمان هدفمندسازی یارانهها اعلام کرد که از این پس تمام سرپرستان خانوار ملزم به ثبت شماره شبا (حساب بانکی) خود در سامانه «سیمین» هستند تا

«رابطه آگاهانه» مفهومی تازه اما عمیق در دنیای امروز است؛ نوعی نگاه متفاوت به عشق که در آن، یک رابطه تنها محلی برای رفع نیازهای

ادبیات پستمدرن که پس از جنگ جهانی دوم شکل گرفت، یکی از جریانهای مهم و اثرگذار دنیای ادبیات است؛ جریانی که با کنار گذاشتن روایتهای

به گزارش پایگاه خبری پهنه پرواز صندوق بازنشستگی کشوری در گزارشی تازه، مجموعهای از راهکارهای کاربردی را برای تقویت حافظه و کاهش خطر زوال عقل

گاه در میانهی یک مراقبه آرام، هنگام گوشدادن به موسیقیای عمیق یا حتی در طبیعت، احساسی سرشار از حضور و آرامش در بدن شکل میگیرد؛

جلسه فنی رقابتهای پاراوزنهبرداری در چارچوب بازیهای همبستگی کشورهای اسلامی ریاض ۲۰۲۵ برگزار شد. در این نشست، مسئولان کاروان پاراوزنهبرداری کشورمان نیز حضور داشتند و

در آستانه برگزاری بازیهای پارالمپیک ۲۰۲۸ لسآنجلس، نکات کلیدی برنامه این دوره منتشر شده است؛ دورهای که با چندین اتفاق مهم و برخی نوآوریها همراه

گفتوگوی درونی منفی لزوماً مخرب نیست. اگر با آگاهی و مهربانی هدایت شود، میتواند تمرکز، رشد شخصی و خودشناسی را تقویت کند. این صدای درونی

راهنمای کامل آزمایشها و روشهای تشخیصی سرطان روده بزرگ (کولون و رکتوم) یکی از سرطانهای قابل پیشگیری است و تشخیص زودرس نقش مهمی در درمان

سابسیژن یکی از مؤثرترین روشهای درمانی برای از بین بردن اسکارهای فرورفته، بهویژه جای جوشهای عمیق است. در این روش پزشک با استفاده از سوزنهای

دومین نشست شورای راهبردی آکادمی کمیته ملی پارالمپیک با حضور اعضای شورا و به میزبانی کمیته ملی پارالمپیک برگزار شد. این جلسه با هدف بررسی

سیزدهمین مرحله اردوی متصل به اعزام تیم ملی پاراوزنهبرداری جوانان بانوان از ۳۰ آبان تا ۱۶ آذر در کمپ تیمهای ملی فدراسیون ورزشهای جانبازان و

تیم ملی میکس تپانچه ۱۰ متر ناشنوایان ایران متشکل از مهلا سمیعی و بیژن غفاری در چهارمین روز رقابتهای المپیک ناشنوایان ۲۰۲۵ ژاپن، موفق به

تحقیقات جدید نشان میدهد که انسانها ممکن است دارای یک «حس هفتم» باشند که به توانایی «لمس از راه دور» مرتبط است. این کشف توسط

به گزارش پایگاه خبری پهنه پرواز در گزارشی از عصر ایران ادعا شد که «جمعیت سالمندان بالای ۶۰ سال ۶۰ درصد افزایش یافته است». این

اخیراً خبری مبنی بر افزایش ۵۰ درصدی حقوق بازنشستگان منتشر شد که واکنش رسمی مسئولان را به همراه داشت. بررسیها نشان میدهد این خبر به

به گزارش پایگاه خبری پهنه پرواز تحقیقات نشان میدهد سندروم روده تحریکپذیر (IBS) بهخودیخود باعث سرطان نمیشود. این اختلال، عملکرد روده را تحت تأثیر قرار

رئیس دبیرخانه ستاد هماهنگی و پیگیری مناسبسازی کشور اعلام کرد که دو اپلیکیشن جدید با هدف تسهیل ارتباط ناشنوایان با سامانههای امدادی طراحی و راهاندازی

استفاده از واژههای نامناسب در مدرسه رفتاری است که باید با رویکردی آموزشی، تربیتی و مرحلهبهمرحله اصلاح شود، نه صرفاً با تنبیه. به گزارش پایگاه

فریدون الهامی: امیدوار به صعود هر دو تیم والیبال ساحلی از مرحله مقدماتی هستم سرمربی تیم های ملی والیبال ساحلی ناشنوایان ابراز امیدواری کرد که

نویسنده : بیژن همدرسی اتیسم در ایران، برخلاف بسیاری از کشورها، هنوز در قالب یک قانون جامع و فراگیر تعریف نشده و همین موضوع باعث

مراسم بزرگداشت شمس لنگرودی، شاعر، نویسنده، بازیگر و خواننده شناختهشده ادبیات معاصر ایران، روز دوشنبه ۲۶ آبان در خانه هنر صوفی برگزار شد. به گزارش

پایگاه خبری پهنه پرواز در ادامه سلسله معرفی افراد موفق دارای معلولیت، این بار به سراغ مهدیه لطفی، فارغالتحصیل کارشناسی ارشد مهندسی کامپیوتر – نرمافزار

یک تحلیل تازه در ایراناینترنشنال با عنوان «سکوت ساختاری: تحلیل سلامت روان مردان در سایه مردسالاری» هشدار میدهد که رنجهای روانی مردان صرفاً مسألهای فردی

به گزارش پایگاه خبری پهنه پرواز به نقل از روابط عمومی فدراسیون ورزشهای جانبازان و توانیابان، مسابقات قهرمانی آسیا و اقیانوسیه فوتبال هفت نفره از

۲ دختر تیرانداز ایران در بازی های المپیک ناشنوایان به مرحله نهایی تپانچه ۱۰ متر راه یافتند. به گزارش پایگاه خبری پهنه پرواز به نقل

سرطان مغز استخوان بدخیم، عمدتاً مولتیپل میلوما، از سلولهای پلاسمایی مغز استخوان منشأ میگیرد و با تولید پروتئین غیرطبیعی (پاراپروتئین) همراه است. این بیماری پیشرونده

براساس گزارش پایگاه خبری پهنه پرواز به نقل از روزنو، مبلغ مستمری مددجویان تحت پوشش بهزیستی و کمیته امداد در سال ۱۴۰۴ با افزایش ۴۰

مراسم رونمایی از پوستر چهلوسومین دوره جشنواره جهانی فیلم فجر روز شنبه ۲۴ آبان ۱۴۰۴ در شهر شیراز و در جوار آرامگاه سعدی برگزار شد.

به گزارش پایگاه خبری پهنه پرواز بر اساس بخشنامه جدید صندوق بازنشستگی کشوری، شرایط بازنشستگی برای مادران شاغل پس از اجرای قانون «حمایت از خانواده

به گزارش پایگاه خبری پهنه پرواز بر اساس اعلام پایگاه خبری فردا نیوز، پرداخت مستمری آبان ماه مددجویان تحت پوشش کمیته امداد امام خمینی(ره) و

به گزارش پایگاه خبری پهنه پرواز براساس اعلام رسمی، پرداخت مستمری آبان ماه مددجویان تحت پوشش سازمان بهزیستی کشور و کمیته امداد امام خمینی(ره) از

به گزارش پایگاه خبری پهنه پرواز به نقل از ایرنا، احمد میدری، وزیر تعاون، کار و رفاه اجتماعی، اعلام کرد که شیوه جدید طرح کالابرگ

تیم رباتیک ایران در مسابقات روبوکاپ آسیا و اقیانوسیه ۲۰۲۵ که در ابوظبی برگزار شد، موفق شد عنوان قهرمانی و مدال طلا را به دست

به گزارش پایگاه خبری پهنه پرواز در گفتوگویی که با خبرگزاری کتاب ایران (ایبنا) منتشر شده است، علیرضا اعتصام پژوهشگر و نویسنده، با نگاهی انتقادی

به گزارش پایگاه خبری پهنه پرواز به نقل از خبرآنلاین، مدیرکل دفتر روابط بینالملل ستاد مبارزه با مواد مخدر اعلام کرد که ایران با کمبود

تمرینات تیم ملی پاراوزنهبرداری جوانان از امروز در کمپ تیمهای ملی فدراسیون ورزشهای جانبازان و توانیابان آغاز شد. به گزارش پایگاه خبری پهنه پرواز به

نماینده بدمینتون بانوان ایران در نخستین رقابت خود در المپیک ۲۰۲۵ ناشنوایان مقابل حریف ژاپنی تن به شکست داد. به گزارش پایگاه خبری پهنه پرواز

کودکان دارای آسیب بینایی مجموعهای از ویژگیهای خلقی و هیجانی دارند که شناخت آنها میتواند مسیر آموزش، تربیت و رشد اجتماعیشان را هموارتر کند. این

کاروان ورزش ناشنوایان ایران که با نام «عاشقان ایران» و با شعار «تا آخرین نفس برای وطن» در المپیک بیست و پنجم شرکت کرده است،

روانشناسی موسیقی شاخهای میانرشتهای از علوم است که رابطهی انسان و موسیقی را از زاویه ذهن، احساس و رفتار بررسی میکند. این علم تلاش میکند

کمیته ملی پارالمپیک با صدور پیامی، کسب عنوان سوم مسابقات بسکتبال با ویلچر قهرمانی آسیا و اقیانوسیه ۲۰۲۵ تایلند و دستیابی به سهمیه حضور در

به گزارش پایگاه خبری پهنه پرواز نتایج یک گزارش از یورونیوز فارسی نشان میدهد که تصور «برابری کامل» در رابطه عاطفی میتواند زمینهساز نارضایتی و

مراسم اختتامیه نهمین جشنواره بینالمللی فیلم شهر عصر پنجشنبه ۲۲ آبان در برج میلاد تهران برگزار شد و جمعی از چهرههای سینمایی و فرهنگی در

شرکت Meta قابلیت جدیدی تحت عنوان Quick Connect را برای عینکهای هوشمند خود ارائه کرده که به کاربران امکان میدهد با یک لمس ساده، تماس بگیرند

هواوی در پتنتی تازه، از یک فناوری نوآورانه برای عینکهای واقعیت افزوده و واقعیت مجازی پرده برداشته است. بر اساس این طرح، بند عینک علاوه

به گزارش پایگاه خبری پهنه پرواز به نقل از هم میهن آنلاین، کتاب «اعتیاد و روند ابژهسازی معتاد: چهار دهه بعد از انقلاب ۱۳۵۷» نوشته

همزمان با فرا رسیدن هفته کتاب و کتابخوانی، فرهنگسرای خاوران با میزبانی از جمعی از نویسندگان برجسته و علاقهمندان به ادبیات، ویژهبرنامهای با عنوان «در

در آستانه برگزاری بیستوپنجمین دوره بازیهای المپیک ناشنوایان ۲۰۲۵، جمعی از مسئولان کاروان ورزشی ناشنوایان ایران با پیمان سعادت سفیر جمهوری اسلامی ایران در ژاپن

یکی از وجوه خودخواهی ما انسانها این است که بیش از آن که خواهان خوشبختی عزیزانمان باشیم، عاشق آنیم که آنها آن گونه که ما

در جریان رقابتهای بسکتبال با ویلچر قهرمانی آسیا و اقیانوسیه ۲۰۲۵ در تایلند، تیم ملی بسکتبال با ویلچر مردان ایران با نمایشی قدرتمند موفق شد

در مراسمی ویژه در شهرستان اشنویه، تندیس قهرمان بیبدیل پارالمپیک جهان و ایران، سیامند رحمان، با حضور عبدالکریم حسینزاده معاون رئیسجمهور در امور توسعه روستایی

در دل محدودیتها، گاهی انسانهایی میدرخشند که نامشان برازندهی مسیرشان است. «ستاره اسدی» یکی از آن ستارههاست؛ بانویی پرتلاش، هنرمند و ورزشکار که با وجود

به گزارش پایگاه خبری پهنه پرواز به نقل از روابط عمومی کمیته ملی پارالمپیک و به نقل از فدراسیون ورزشهای نابینایان و کمبینایان، جمعی از

به گزارش پایگاه خبری پهنه پرواز رفتار دویدن یا جدا شدن ناگهانی کودکان از والدین در محیطهای عمومی، که به آن Wandering (سرگردانی) گفته میشود،

به گزارش پایگاه خبری پهنه پرواز فواد شمس، روزنامهنگار و تحلیلگر سیاسی، به زندگی خود پایان داد. دوستان و نزدیکان وی این خبر را تأیید

به گزارش پایگاه خبری پهنه پرواز در نشست معرفی و بررسی کتاب آوای یک زندگی نوشته توکا ملکی که در شهرک کتاب بهار اصفهان برگزار

گزارش پایگاه خبری پهنه پرواز به نقل از ایرنا، در چهلوسومین کنفرانس عمومی یونسکو در سمرقند، منشور کوروش بزرگ بهعنوان نمادی از فرهنگ، صلح و

گزارش پایگاه خبری پهنه پرواز به نقل از پایگاه خبری انتخاب، توماس فریدمن تحلیلگر بینالمللی در یادداشتی تأکید کرده است که جهان امروز وارد دورهای

نتایج تحقیقات جدید دانشگاه هاروارد نشان میدهد که هیچ انسانی در تمام طول زندگی همیشه شاد نیست و شادی واقعی تنها به احساس لذت یا

به گزارش پایگاه خبری پهنه پرواز به مناسبت روز جهانی آگاهی از استرس، کارشناسان حوزه سلامت روان بر اهمیت ذهنآگاهی (Mindfulness) بهعنوان یکی از مؤثرترین

دکتر جلیل کوهپایهزاده، رئیس فدراسیون ورزشهای جانبازان و توانیابان، عصر امروز چهارشنبه ۲۱ آبانماه با حضور در اردوی تیم ملی والیبال نشسته مردان، از نزدیک

به گزارش از پایگاه خبری پهنه پرواز آیین بدرقه نمایندگان ناشنوای استان مرکزی که عازم بیستوپنجمین دوره المپیک ناشنوایان جهان هستند، با حضور دکتر مهدی

به گزارش پایگاه خبری پهنه پرواز، با حکمی از سوی دکتر کوهپایهزاده، رئیس فدراسیون ورزشهای جانبازان و توانیابان، دکتر حسن حمزهزاده به عنوان مشاور رئیس فدراسیون

به گزارش پایگاه خبری پهنه پرواز، صبح امروز نخستین گروه از کاروان اعزامی جمهوری اسلامی ایران به بیستوپنجمین دوره بازیهای المپیک ناشنوایان ۲۰۲۵ توکیو راهی ژاپن

به گزارش پایگاه خبری پهنه پرواز و به نقل از فدراسیون ورزشهای جانبازان و توانیابان، در پنجمین روز از مسابقات قهرمانی بسکتبال با ویلچر آسیا و

به گزارش پایگاه خبری پهنه پرواز، نرگس ژیانعابد، معاون امور توانبخشی بهزیستی خراسان رضوی، از اتصال سامانه پرداخت سماکارت توانخواهان به بستر حملونقل هوشمند تپسی خبر

به گزارش پایگاه خبری پهنه پرواز، رئیس سازمان بهزیستی کشور اعلام کرد که از مجموع ۱۵۸ ایستگاه متروی تهران، تنها یک سوم آنها برای افراد دارای

به گزارش پایگاه خبری پهنه پرواز، همایون ارشادی، بازیگر ماندگار سینمای ایران، مسیر زندگی پرفراز و نشیبی را پشت سر گذاشت که از دل دغدغههای

به گزارش پایگاه خبری پهنه پرواز، در گزارشی از وبسایت کنگره ۶۰، یکی از اعضا تجربه شخصی خود را از مسیر دستیابی به تناسباندام و

به گزارش پایگاه خبری پهنه پرواز، شهرستان کرج با دارا بودن تنوع اقلیمی، فرهنگی و تاریخی، یکی از مناطق مستعد گردشگری در کشور به شمار

به گزارش پایگاه خبری پهنه پرواز، کتاب «بیرون جهیدن از صف مردگان» نوشتهی مارگارت اتوود، نویسنده برجسته کانادایی و خالق آثاری چون «سرگذشت ندیمه»، با

به گزارش پایگاه خبری پهنه پرواز، سکته چشمی یکی از وضعیتهای اورژانسی چشم است که در آن جریان خون به شبکیه کاهش یافته یا قطع

⃣ یادگیری همیارانه یادگیری همیارانه شرایطی است که در آن دو یا چند نفر با یکدیگر تلاش میکنند تا مفهومی را یاد بگیرند. بر خلاف

با حضور قائممقام بانک سپه و رئیس فدراسیون ورزشهای جانبازان و توانیابان، اردوی تیم ملی فوتبال هفت نفره برگزار شد و از تمرینات ملیپوشان بازدید

۱. سلامت کودک را از طریق چشمپزشک و متخصص شنوایی بررسی کنید.۲. فضایی آرام و بدون استرس در خانه ایجاد کنید.۳. زمانهایی را به بازی

در گفتوگویی با رسانهها، زن جوانی از مشکلات و فشارهای روحی شدیدی سخن گفته است که از سوی همسرش متحمل میشود. او اعلام کرده که

مجلس شورای اسلامی اصلاحاتی در قانون مهریه تصویب کرده است که طبق آن، از لحظه ثبت دادخواست اجرای مهریه توسط زوجه، هرگونه انتقال اموال مرد

به گزارش پایگاه خبری پهنه پرواز در جلسهای که روز یکشنبه ۱۸ آبان ۱۴۰۴ با حضور مسئولان سازمان بهزیستی و اعضای کمیسیون اصل ۹۰ مجلس

به گزارش پایگاه خبری پهنه پرواز فرهنگستان زبان و ادب فارسی به تازگی واژه «چرخک» را بهعنوان معادل فارسی کلمهی «ویلچر» معرفی کرد. این واژه

بر اساس گزارش پایگاه خبری پهنه پرواز، تیم ملی پاراوزنهبرداری ایران در رقابتهای جهانی ۲۰۲۵ قاهره، بار دیگر افتخاری بزرگ برای ورزش کشور رقم زد

بر اساس گزارش پایگاه خبری پهنه پرواز، دو ملیپوش تنیس روی میز ناشنوای کشورمان، سما شهبازی و فرزاد چراغی، وارد آخرین مرحله اردوی آمادهسازی خود

به گزارش پایگاه خبری پهنه پرواز به نقل از هشتینو، آرامسازی ذهن ناآرام نیازمند اجرای روشهای ساده و کاربردی است. برخی از موثرترین راهکارها شامل

به گزارش جماران، اداره کل حقوقی قوه قضاییه با استناد به قانون هدفمند کردن یارانهها اعلام کرده است که واریز یارانه به حساب کودکان یا

مطالعه و تحقیقات نشان میدهد که مدیریت افکار منفی، نقش مهمی در سلامت روان و کیفیت زندگی دارد. برخی از تکنیکهای موثر برای جلوگیری از

داشتن وسایل اضافی در خانه و محل کار، علاوه بر شلوغی و بهم ریختگی، میتواند باعث استرس و کاهش کارایی شود. رهایی از این وسایل،

به گزارش تابناک، فضلالله رنجبر، سخنگوی کمیسیون اجتماعی مجلس شورای اسلامی، با اشاره به تخلفات مطرحشده درباره انجمن اوتیسم ایران در زمینه جذب منابع مالی،

جلسهای به منظور بررسی همکاری مشترک فدراسیون ورزشهای ناشنوایان و سازمان زیباسازی شهرداری تهران برگزار شد تا تصاویر قهرمانان ناشنوای اعزامی به بازیهای المپیک ۲۰۲۵

گزارش از تحریریه پایگاه خبری پهنه پرواز آیا تا به حال احساس کردهاید بدنتان از آنِ شما نیست؟ گویی از بیرون به خود نگاه میکنید،

مسابقات قهرمانی آسیا و اقیانوسیه بسکتبال با ویلچر ۲۰۲۵ به میزبانی تایلند در حال برگزاری است و ایران نیز نمایندهای پرافتخار در جمع داوران این

در حالی که جهان با سرعتی بیسابقه به سمت تحول دیجیتال پیش میرود، هوش مصنوعی به مهمترین عامل تغییر در اقتصاد جهانی تبدیل شده است.

به گزارش پایگاه خبری پهنه پرواز در تازهترین گزارش منتشر شده، کارشناسان فناوری با نگرانی از پیشرفت سریع سیستمهای هوش مصنوعی تاکید میکنند که احتمال

پژوهشگران مؤسسه فناوری ماساچوست (MIT) با طراحی بنچمارکی تازه به نام WorldTest نشان دادهاند که مدلهای هوش مصنوعی برخلاف تصور عمومی، هنوز توانایی «درک واقعی»

🔹️به گزارش پایگاه خبری پهنه پرواز به نقل از روابط عمومی فدراسیون ورزش های جانبازان و توان یابان، هفتمین مرحله اردوی آمادگی تيمملی والیبالنشسته اعزامی

🔹️تیم ملی پاراجودو ایران با کسب ۲ نشان طلا، یک نقره و یک برنز به عنوان نایب قهرمانی رقابتهای قهرمانی آسیا دست یافت. 🔹️به گزارش

در دنیایی که گاه نگاهها تنها ویلچر را نماد معلولیت میدانند، سهیلا ایوبی با روحیهای خستگیناپذیر و ارادهای مثالزدنی، تعریفی تازه از توانمندی و امید

اعضای کاروان ورزش ایران در المپیک ناشنوایان شامل کادر سرپرستی و اجرایی، ورزشکاران و مربیان در قالب گروه های مختلف عازم محل برگزاری این بازی

به گزارش ایسنا، معاون تعاون و امور اجتماعی بنیاد شهید و امور ایثارگران کشور اعلام کرد: جانبازان واجد شرایط میتوانند برای دریافت و تحویل خودروی

عشق تنها یک احساس گذرا نیست؛ بلکه ترکیبی از عاطفه، تعهد، ارتباط و پذیرش است که میان انسانها شکل میگیرد و نیازهای روانی، عاطفی و

به گزارش بوکاپو، خودآگاهی یکی از مهمترین مهارتهای زندگی فردی و مدیریتی است که به ما کمک میکند افکار، احساسات و رفتارهای خود را بهتر

به گزارش سازمان بهزیستی کشور، مستمری مددجویان این سازمان برای آبانماه ۱۴۰۴ روز شنبه ۲۰ آبانماه از طریق بانک رفاه کارگران به حساب خانوارهای تحت

به گزارش پایگاه خبری پهنه پرواز، امروزه سفر به فضا دیگر تنها در اختیار فضانوردان حرفهای و مأموریتهای دولتی نیست؛ با ظهور شرکتهای خصوصی بزرگ

به گزارش روابطعمومی فدراسیون ورزشهای ناشنوایان، صبح امروز جلسه هماهنگی و توجیهی کاروان اعزامی جمهوری اسلامی ایران به بیستوپنجمین دوره بازیهای المپیک ناشنوایان ۲۰۲۵ توکیو،

به گزارش پایگاه خبری پهنه پرواز سازمان بهزیستی کشور پرداخت مستمری خانوارهای تحت پوشش برای آبان ۱۴۰۴ را طبق برنامه انجام داد. زمان معمول واریز

چرا بعضیها نمیتوانند دست از عکس گرفتن بردارند»از نگاه روانشناسی، علاقه زیاد به گرفتن سلفی دلایل متفاوتی دارد: جستجوی توجه و تأیید اجتماعی: لایکها و

به گزارش پایگاه خبری پهنه پرواز و بر اساس اعلام رسمی سازمان بهزیستی کشور و کمیته امداد امام خمینی (ره)، میزان مستمری ماهانه مددجویان در

بر اساس تحلیلهای روانشناسی، پوشیدن لباس قرمز تنها یک انتخاب ظاهری نیست، بلکه بیانگر قدرت درونی و اعتماد به نفس بالا است. تحقیقات نشان میدهد

حمید حسنی، پژوهشگر زبان و ادبیات فارسی، از افت چشمگیر دقت زبانی در میان جوانان ابراز نگرانی کرد و گفت: «دانشآموزان و حتی دانشجویان رشته

ساناز حصیری، هنرمند و کارآفرین توانمند، متولد ۳۱ اردیبهشت ۱۳۶۶ در تهران و ساکن کرج است. او با مدرک کارشناسی مدیریت بازرگانی و بیش از

ماجد راشد، رئیس کمیته پارالمپیک آسیا، با حضور در موزه هانگژو ۲۰۲۲ ضمن گرامیداشت میراث چهارمین دوره بازیهای پاراآسیایی، دیدارهایی مهم در راستای توسعه همکاریهای

علی محمودی خلخالی، تنها نماینده شنای ایران در المپیک ناشنوایان ۲۰۲۵، وارد آخرین مرحله اردوی آمادهسازی خود شد تا با آمادگی کامل در این رقابت

یادگیری همیارانه یکی از مؤثرترین راهکارها برای ایجاد هیجان مثبت در میان دانشآموزان است. در این روش، دو یا چند نفر با هدف درک بهتر

برای آمادهسازی کودکان قبل از نوشتن، میتوان مراحل زیر را با فعالیتهای جذاب و بازیمحور اجرا کرد: ۱. آمادهسازی عضلات دست و هماهنگی چشم و

مطالعهای منتشرشده در نشریه Ambio نشان میدهد ایرانیها از بین ۶۱ کشور، در رتبه دوم جهان از نظر همبستگی ذهنی و عاطفی با طبیعت قرار

دانشمندان مؤسسه پیکاور در MIT در پژوهشی تازه نشان دادهاند که مغز انسان هنگام بازگشت به تمرکز پس از حواسپرتی، از الگوهای موجی و چرخشی

بر اساس اعلام رسمی وزارت تعاون، کار و رفاه اجتماعی، مرحله پنجم طرح کالابرگ الکترونیکی از اواخر آبانماه ۱۴۰۴ آغاز میشود. در این مرحله، میزان

تازهترین اثر محمود دولتآبادی با عنوان «پنج: چهار نمایشنامه و یک فیلمنامه» توسط انتشارات وزن دنیا با همکاری نشر سلوک منتشر شد. این کتاب ۴۸۸

شرکت تویوتا در نمایشگاه Japan Mobility Show 2025 از صندلی رباتیکی با نام Walk Me رونمایی کرد؛ محصولی هوشمند که میتواند برای افراد دارای محدودیت

به گزارش پایگاه خبری پهنه پرواز به نقل از روابط عمومی فدراسیون ورزشهای جانبازان و توانیابان، ششمین مرحله اردوی آمادگی تیم ملی والیبال نشسته بانوان

مطالعهای تازه که در ژورنال Nature منتشر شده است، نشان میدهد که مدارهای حرکتی مغز انسانها و میمونها تنها منتظر دریافت پیامهای حسی نیستند؛ بلکه

استان تهران با تسهیل روند فرزندخواندگی، امکان واگذاری کودکان به خانوادههای متقاضی را اکنون در مدت دو تا پنج ماه فراهم کرده است. به گزارش

دوران نوجوانی مرحلهای حساس و چالشبرانگیز در رشد فرزندان است؛ زمانی که آنها در حال شکلدهی هویت شخصی، استقلال و مهارتهای اجتماعی هستند. والدین نقش

به گزارش پایگاه خبری پهنه پرواز تحقیقات جدید نشان میدهد که اختلاف سنی میان زوجها میتواند تأثیرات مهمی بر رضایت رابطه، طول عمر و احساس

پژوهشی تازه توسط محققان Universidad Miguel Hernández de Elche نشان میدهد که گروه خاصی از نورونها در بخش Basolateral amygdala مغز میتوانند نقش کلیدی در

پس از بیش از دو دهه انتظار، سرانجام موزه بزرگ مصر در ضلع غربی اهرام جیزه افتتاح شد؛ بنایی عظیم و مدرن که میراث چند

ویژگیهای تکالیف در سطح «دانش» از منظر طبقهبندی بلوم تکالیف سطح دانش (Knowledge) در طبقهبندی بلوم به پایینترین سطح یادگیری تعلق دارند. در این سطح،

نشست اعضای هیأت اجرایی کمیته ملی پارالمپیک با حضور رئیس و معاونان رسانه ملی برگزار شد. به گزارش پایگاه خبری پهنه پرواز به نقل از

یازدهمین اردوی آمادهسازی تیم ملی کاراته ناشنوایان کشور با حضور المپینهای این تیم در کمپ تیمهای ملی فدراسیون ورزشهای ناشنوایان آغاز میشود. به گزارش روابط

نمایش «تفاهم علیه سوتفاهم» به نویسندگی و کارگردانی حمید اصغری تتماج و با تهیهکنندگی و اجرای طرح از سوی آموزشگاه و دفتر فیلمسازی هلیافیلم، آمادهی

نخستین جلسه رسمی انجمن کریکت ناشنوایان ایران روز دوشنبه ۱۲ آبانماه ۱۴۰۴ با حضور رییس، دبیر و نایبرئیس انجمن برگزار شد. به گزارش پایگاه خبری

مطالعهای منتشرشده در روزنامه «دنیای اقتصاد» نشان میدهد که تورم مزمن در جامعه باعث میشود افراد برای بازسازی حس توانمندی و امنیت روانی خود، به

معاون امور توانبخشی سازمان بهزیستی کشور اعلام کرد که اجرای قانون پرداخت حق پرستاری به افراد دارای معلولیت شدید و خیلی شدید در جریان است،

در صنعت ماءالشعیر، رنگ شیشه بطریها فقط انتخاب ظاهری نیست؛ بلکه دلیل علمی و تاریخی دارد.بطریهای قهوهای (کهربایی) بیشترین محافظت را در برابر اشعه ماورای

بر اساس گزارش منتشر شده، در مرحله پنجم اجرای طرح کالابرگ الکترونیکی، تنها خانوارهای دهکهای ۱ تا ۷ درآمدی مشمول دریافت یارانه کالاهای اساسی قرار

رئیس مرکز توانمندسازی و اشتغال سازمان بهزیستی از ثبت اطلاعات بیش از ۲۸۰ هزار زن سرپرست خانوار در سامانه اشتغال این سازمان خبر داد. این

براساس اعلام سید جواد حسینی، رئیس سازمان بهزیستی کشور، بیش از ۸۵ درصد نوجوانان ۱۲ تا ۱۸ ساله ایرانی دستکم در یک شبکه اجتماعی عضویت

روز پنجشنبه هشتم آبانماه، تمرینات منظم ورزش پاراکورنهول با حضور جمعی از ورزشکاران، مربیان و مسئولان ورزشی در بوستان رازی تهران برگزار شد. به گزارش

در پایان رقابتهای جام جهانی پاراتیراندازی ۲۰۲۵ در العین امارات، تیم ملی ایران با عملکردی درخشان توانست با کسب ۶ مدال رنگارنگ و ثبت چند

تیم ملی پاراجودو نابینایان و کمبینایان کشورمان، برای حضور در رقابتهای قهرمانی آسیا، بامداد امروز عازم قزاقستان شد تا بار دیگر نام ایران را در

در اقدامی امیدبخش برای توسعه و پشتیبانی از ورزشکاران ناشنوا، انجمن خیرین و کارآفرینان فدراسیون ورزشهای ناشنوایان رسماً آغاز به کار کرد. این نشست با

رئیس سازمان نظام پرستاری کشور از تدوین بسته جامع حمایت از پرستاران خبر داد و گفت: این طرح با هدف ارتقای وضعیت معیشتی، رفاهی و

در محوطه تاریخی گندیشاپور در شهرستان دزفول، مجموعهای از اقدامات عمرانی و حفاظتی برای بهبود زیرساختهای گردشگری و افزایش امنیت این محوطه باستانی اجرا شده

در سالهای اخیر، پدیدهای جالب در میان جوانان متولد دهه ۱۳۷۰ و ۱۳۸۰ دیده میشود؛ نسلی که به «نسل Z» معروفاند و برخلاف نسلهای پیشین،

در دنیای پرسرعت امروز، بسیاری از افراد احساس میکنند ذهنشان کندتر از همیشه کار میکند؛ تمرکز پایین آمده، حافظه کوتاهمدت یاری نمیکند و تصمیمگیری دشوار

تنگی نخاع یکی از شایعترین اختلالات ستون فقرات است که در اثر کاهش فضای کانال نخاعی و فشار بر نخاع یا ریشههای عصبی ایجاد میشود.

به گزارش پایگاه خبری پهنه پرواز، کارشناسان آموزشی و رسانهای تأکید دارند که سواد رسانهای در جوانان یکی از مهارتهای حیاتی برای زندگی امروز است.

به گزارش روابط عمومی فدراسیون ورزشهای جانبازان و توانیابان و به نقل از کمیته ملی پارالمپیک، هادی رضایی، سرمربی تیم ملی والیبال نشسته مردان ایران،

عبدالرضا توسلی خواه در جایگاه پنجم ایستاد در چهارمین روز از رقابت های جام جهانی پاراتیراندازی، ملی پوشان کشورمان به مصاف حریفان خود رفتند. به

کودکان دچار اختلال کمتوجهی – بیشفعالی (ADHD) با چالشهای ویژهای در محیطهای آموزشی روبهرو هستند که نیازمند تدابیر علمی و برنامهریزی شده برای حمایت تحصیلی

شخصیت کاریزماتیک ویژگی ذاتی نیست؛ بلکه با تمرین، آگاهی و اصلاح رفتارها میتوان آن را پرورش داد. افراد کاریزماتیک توانایی جلب اعتماد و توجه دیگران

واحد خاکدان، نقاش برجسته و چیرهدست ایرانی، در ۷۵سالگی چشم از جهان فروبست. او از معدود هنرمندانی بود که توانست با نگاهی شاعرانه، به اشیای

بسیاری از انسانها زندگی خود را به دست شرایط میسپارند؛ درست مانند کشتیای که بدون ناخدا در امواج سرگردان است. اما تفاوت انسانهای موفق در

در یادداشتی با عنوان «عدالت معیشتی، پایه عدالت آموزشی» تأکید شده است که دستیابی به عدالت در نظام آموزش، بدون تأمین معیشت معلمان ممکن نیست.

وزارت بهداشت هشدار داد: رژیم «فستینگ» راه سالم کاهش وزن نیست! دفتر بهبود تغذیه جامعهی وزارت بهداشت تأکید کرد که باور عمومی نسبت به تأثیر

در روزگاری که جنگ، نفرت و تبعیض، آرامش انسان را تهدید میکند، یاد و اندیشهی کوروش بزرگ – بنیانگذار امپراتوری هخامنشی و نماد دادگری –

با اعلام کمیته بینالمللی پارالمپیک (IPC) سیما لیموچی از ایران نامزد دریافت جایزهی فعالان داوطلب در ورزشهای پارالمپیکی شد. به گزارش روابطعمومی فدراسیون ورزشهای جانبازان

در روز جهانی مربی، با نهایت احترام و عشق، سر تعظیم فرود میآوریم در برابر انسانهایی که با صبر، دانایی و ایمان، مسیر موفقیت و

تیمهای ملی بسکتبال با ویلچر بانوان و آقایان کشورمان جهت شرکت در رقابتهای قهرمانی آسیا و اقیانوسیه عازم کشور تایلند شدند. این مسابقات فرصتی ارزشمند

نسل Z، نوجوانان و جوانانی که با اینترنت، شبکههای اجتماعی و دنیای دیجیتال بزرگ شدهاند، ویژگیهای خاص و توقعات متفاوتی دارند. آنها میخواهند دیده شوند،

پژوهشها نشان میدهد که بازی در فضای باز و طبیعت نقش مهمی در تقویت اعتماد به نفس، خوداتکایی و یادگیری کودکان دارد. در دنیای امروز

تغذیه مناسب نقش بسیار مهمی در رشد ذهنی، تمرکز و توان یادگیری دانشآموزان دارد. مغز انسان برای عملکرد مطلوب به مواد مغذی متنوع، انرژی کافی

ابوذَر شهپری، رئیس انجمن مراکز دانشبنیان و نخبگان کشور، در یادداشتی برای باشگاه خبرنگاران جوان نوشت: نسل Z، متولدین حدود سالهای ۱۹۹۵ تا ۲۰۱۰، نخستین

برای داشتن ذهنی شاداب، حافظه قوی و تمرکز بالا، رعایت چند عادت ساده اما مداوم میتواند تفاوت بزرگی در سلامت مغز ایجاد کند.۱. فعالیت بدنی

در گفتوگویی با خبرگزاری مهر، غلامحسین نوفرستی، متخصص رادیوتراپی و آنکولوژی و استاد پیشکسوت دانشگاه علوم پزشکی مشهد، تأکید کرد که ترس از سرطان اغلب

به گزارش پایگاه خبری پهنه پرواز، دکتر فتانه امیری، رئیس انجمن کریکت ناشنوایان ایران و نماینده فدراسیون جهانی کریکت ناشنوایان در کشور، طی حکمی از

به گزارش پایگاه خبری پهنه پرواز، محمدعلی یوسفیزاده، مدیرعامل آسیاتک، در دومین روز نمایشگاه تراکنش و در پنل «گذار از شعب فیزیکی بر بستر هوش

به گزارش پایگاه خبری پهنه پرواز، طی مراسمی رسمی، ایرج خرازی بهعنوان مدیرکل جدید دفتر بازرسی، عملکرد و پاسخگویی به شکایات وزارت میراث فرهنگی، گردشگری

به گزارش پایگاه خبری پهنه پرواز، در دهههای اخیر گرایش نوینی در معماری ظهور کرده است که به جای حذف طبیعت، آن را در دل

زندگی پرمشغله و استرسزا گاهی ذهن ما را پر از افکار منفی و اضطراب میکند. خوشبختانه با چند راهکار ساده و عملی میتوان این چرخهی

به گزارش پایگاه خبری پهنه پرواز، دولت با اعلام رسمی رئیس سازمان برنامه و بودجه، واریز ۵۰۰ هزار تومان کالابرگ یارانهای به ازای هر نفر

به گزارش پایگاه خبری پهنه پرواز، علی نصیریان، هنرمند پیشکسوت سینما، تئاتر و تلویزیون، با تأسف از درگذشت دو کارگردان برجسته، داریوش مهرجویی و ناصر

به گزارش پایگاه خبری پهنه پرواز، کمکمعیشت مهرماه ۱۴۰۴ مربوط به بند (پ) تبصره (۱۲) ویژهی معلولان شدید و خیلی شدید تحت پوشش سازمان بهزیستی

تئوری انتخاب؛ نگاهی تازه به مسئولیت فردی و روابط انسانی «تئوری انتخاب» یکی از تأثیرگذارترین نظریههای روانشناسی نوین است که توسط دکتر ویلیام گلاسر، روانپزشک

به گزارش پایگاه خبری پهنه پرواز و به نقل از کمیته ملی پارالمپیک، رسول حجاریان ملیپوش پاراتیراندازی کشورمان در ماده P1 تپانچه بادی آقایان فردا

به گزارش پایگاه خبری پهنه پرواز و به نقل از روابطعمومی کمیته ملی پارالمپیک، کمیته برگزاری بازیهای پارالمپیک زمستانی «میلان و کورتینا ۲۰۲۶» از سکوی

آموزشگاه علمی-تخصصی اردستانی سه دهه تجربه در آموزش کودکان با نیازهای ویژه! آموزشگاه اردستانی با مربیان متخصص و با ۳۰ سال سابقه درخشان ملی و

ورزشهای تیمی نقش بسیار مهمی در افزایش اعتمادبهنفس، تقویت مهارتهای اجتماعی و بهبود کیفیت زندگی افراد دارای معلولیت ایفا میکنند. فعالیت در یک تیم ورزشی،

پرستاران، آن فرشتگان بینام و نشان، هر روز و هر شب با فداکاری، صبر و مهربانی در کنار بیماران هستند و گاهی جان خود را

به مناسبت میلاد باسعادت حضرت زینب کبری(س) و گرامیداشت روز پرستار، از زحمات و تلاشهای مستمر خانم صالحی، عضو کادر درمان فدراسیون ورزشهای جانبازان و

به گزارش پایگاه خبری پهنه پرواز دومین جشنواره فرهنگی ورزشی ناشنوایان منطقه آزاد اروند با حضور جمعی از ورزشکاران ناشنوا و کمشنوا در آبادان برگزار

رقابتهای جام جهانی پاراتیراندازی العین ۲۰۲۵ با حضور ۲۱۳ ورزشکار از ۳۹ کشور از سهشنبه ششم آبان ماه آغاز میشود. این مسابقات از ۶ تا

داشتن دانشآموزان باانگیزه، یکی از کلیدهای موفقیت در آموزش است. انگیزه همان نیرویی است که باعث میشود یادگیری از یک کار اجباری به یک تجربه

از نگاه بسیاری از فیلسوفان، انسان در مسیر خوشبختی تنها دو راه پیشِرو دارد: لذتبردن از زندگی یا عملکردن به وظیفه. این دو نگرش که

داشتن عادت «آمادهشدن برای انجام کارها» یکی از سادهترین و در عین حال مؤثرترین روشها برای افزایش بهرهوری و نظم در زندگی است. این عادت

روانشناسی مثبت شاخهای از علم روانشناسی است که بهجای تمرکز بر مشکلات و بیماریها، بر توانمندیهای انسان، احساسات مثبت و کیفیت زندگی تأکید دارد. هدف

پژوهشی تازه نشان میدهد مغز مردان با افزایش سن سریعتر از مغز زنان کوچک میشود، با این حال زنان بیش از مردان در معرض ابتلا

به گزارش پایگاه خبری پهنه پرواز، دکتر فتانه امیری، ریاست انجمن کریکت ناشنوایان ایران، با معرفی رسمی دبیر و نایبرئیس انجمن کریکت ناشنوایان ایران به

به گزارش پایگاه خبری پهنه پرواز به نقل از خبرگزاری مهر، محمدرضا ظفرقندی، وزیر بهداشت، درمان و آموزش پزشکی، از گسترش همکاری میان وزارت بهداشت

به گزارش پایگاه خبری کتاب نیوز، کتاب «امید؛ راهنمای بقا در سختیها» به قلم جین گودال، داگ آبرامز و گیل هادسون، با ترجمه زهرا حسینیان

در مراحل گذشته، مبلغ کالابرگ برای دهکهای ۱ تا ۳ برابر ۵۰۰ هزار تومان و برای دهکهای ۴ تا ۷ معادل ۳۵۰ هزار تومان بود.

به گزارش پایگاه خبری روزنو، مستمری مهرماه ۱۴۰۴ مددجویان تحت پوشش سازمان بهزیستی کشور طبق روال جدید در روز شنبه ۲۰ مهرماه از طریق بانک

به گزارش پایگاه خبری پهنه پرواز به نقل از عصر ایران، فروتنی فکری یکی از ویژگیهای بنیادین رشد فردی و اجتماعی است؛ مفهومی که یادآور

واریز کالابرگ دهکهای اول تا نهم در آبانماه ۱۴۰۴ به گزارش پایگاه خبری اقتصاد گلد، مرحله پنجم طرح کالابرگ الکترونیکی ویژه دهکهای اول تا نهم

به گزارش پایگاه خبری پهنه پرواز به نقل از خبرآنلاین، فراموش کردن نام افراد یکی از رایجترین چالشهای ذهنی است و معمولاً نشانهای از بیماری

به گزارش پایگاه خبری پهنه پرواز به نقل از روابط عمومی کمیته ملی پارالمپیک و فدراسیون ورزشهای جانبازان و توانیابان، دوازدهمین مرحله اردوی تیمهای ملی

به گزارش پایگاه خبری پهنه پرواز به نقل از روابط عمومی فدراسیون ورزشهای ناشنوایان، فرحناز ارباب سرمربی تیم ملی کاراته دختران ناشنوا، ورزشکاران خود را

به گزارش پایگاه خبری پهنه پرواز به نقل از روابط عمومی فدراسیون ورزشهای جانبازان و توانیابان، همزمان با هفته تربیتبدنی و ورزش، دکتر کوهپایهزاده رئیس

بر اساس گزارش منتشر شده در جهان صنعت نیوز، دمای هوا در کشور نسبت به میانگین ۵۰ سال گذشته حدود ۹ دهم درجه سانتیگراد بالاتر

به گزارش پایگاه خبری پهنه پرواز، چهارمین جشنواره توسعه ملی گردشگری پایدار و خلاق با همت سرای فرزانگان استان مرکزی و میزبانی خانه موزه ابراهیم،

در دوران نوجوانی، بروز رفتارهای ناهنجار و پرخاشگرانه امری طبیعی است که به دلیل تغییرات هورمونی، اجتماعی و روانی رخ میدهد. والدین میتوانند با روشهای

بر اساس اعلام رئیس مرکز اطلاعات و رفاه ایرانیان، فاز جدید طرح کالابرگ الکترونیکی از آبان ۱۴۰۴ آغاز شد. این طرح با هدف هدفمند کردن

با کوتاهتر شدن روزها و کاهش شدت نور خورشید در فصل پاییز، بسیاری از افراد احساس افت انرژی، کاهش تمرکز و بیحوصلگی را تجربه میکنند.

به گزارش پایگاه خبری پهنه پرواز به نقل از روابط عمومی فدراسیون ورزشهای جانبازان و توانیابان، یازدهمین مرحله اردوی آمادگی تیم ملی جوانان پاراشنا با

دکتر غفور کارگری رییس کمیته ملی پارالمپیک، با صدور پیام تبریکی انتخاب مجدد دکتر پیرحسین کولیوند را به ریاست جمعیت هلال احمر جمهوری اسلامی ایران

به گزارش پایگاه خبری پهنه پرواز ، بر اساس اعلام سازمان بهزیستی کشور، کمکمعیشت مهرماه ۱۴۰۴ موضوع بند (پ) تبصره (۱۲) برای معلولان شدید و

در چارچوب برنامههای چهارمین جشنواره بینالمللی همام، نشست تخصصی با عنوان «گام به گام تا سفر ایمن و آسان» برگزار خواهد شد. سخنران این نشست،

چهارمین جشنواره بینالمللی همام ویژه هنرمندان معلول و جانباز از تاریخ ۱ تا ۷ آبانماه ۱۴۰۴ در فرهنگستان هنر برگزار شد. این رویداد فرهنگی و

در شرایطی که آلودگی هوا به یکی از نگرانیهای اصلی سلامت عمومی تبدیل شده، پژوهشهای جدید نشان میدهند که مصرف میوهها میتواند بهعنوان یک راهکار

بازیگر خردسال فیلم ماندگار «خانه دوست کجاست؟» ساخته عباس کیارستمی، احمد احمدپور، در سن ۴۴ سالگی در تهران درگذشت. او نقش محمدرضا را در این

خانوارهای مشمول طرح کالابرگ الکترونیک باید تا پایان آبانماه نسبت به دریافت و استفاده از اعتبار کالابرگ خود اقدام کنند. بر اساس اطلاعیه منتشرشده، در

به گزارش روابط عمومی فدراسیون ورزشهای ناشنوایان ناشنوایان، طی حکمی از سوی مصطفی نکولعلآزاد، رئیس فدراسیون، دکتر شاهین سلطانپور به عنوان مدیر تیمهای ملی فدراسیون

مراسم بدرقه کاروان تیم ملی پاراتیراندازی ایران پیش از اعزام به رقابتهای جام جهانی العین امارات، در فضایی معنوی و در کنار مزار شهید گمنام

به گزارش روابط عمومی فدراسیون ورزشهای ناشنوایان، بنا بر پیشنهاد رئیس انجمن کاراته ناشنوایان و با حکم مصطفی نکولعلآزاد، رئیس فدراسیون و تأیید شورای فنی،

به گزارش روابط عمومی کمیته ملی پارالمپیک و به نقل از کمیته برگزاری بازیهای پاراآسیایی آیچی-ناگویا ۲۰۲۶، مراسم «یکسال مانده تا آغاز بازیهای پاراآسیایی» با

به گزارش روابط عمومی کمیته ملی پارالمپیک و به نقل از فدراسیون ورزشهای جانبازان و توانیابان، نخستین دوره بازیهای جهانی ساحلی سازمان بینالمللی World Abilitysport

سرگیجه هنگام تغییر وضعیت خواب، مانند بلند شدن سریع از رختخواب، معمولاً ناشی از افت ناگهانی فشار خون است. این وضعیت که به آن «سرگیجه

تفاله قهوه نهتنها برای درست کردن نوشیدنی مفید است، بلکه در خانه کاربردهای جالب دیگری هم دارد. یکی از این روشها، اضافه کردن تفاله قهوه

ویتامین D، یا کلسیفرول، یکی از ریزمغذیهای حیاتی است که نقش مهمی در جذب کلسیم و فسفر دارد و سلامت استخوانها، کارکرد عضلات و سیستم

به گزارش ایسکانیوز، پژوهشهای جدید نشان میدهد که نوشیدن قهوه حدود دو تا چهار ساعت پس از بیدار شدن، بیشترین تأثیر را در بهبود خلقوخو،

به گزارش شهرخبر، طرح کالابرگ الکترونیک از اول آبان بهصورت رسمی اجرا و پرداخت آن آغاز میشود. یکی از نمایندگان مجلس در این باره اعلام

ستاد اطلاعرسانی چهلودومین جشنواره بینالمللی فیلم کوتاه تهران، فهرست نامزدهای بخشهای مختلف مسابقه ملی این رویداد را منتشر کرد. بخش فیلم کوتاه اقتباسی داوران: مرجان

به مناسبت هفته سلامت استخوان (۲۶ مهر تا ۲ آبان)، یک متخصص تغذیه در کرمانشاه درباره راههای حفظ سلامت استخوانها توضیح داد و تأکید کرد

بدنمندی مفهومی است که نشان میدهد بدن، جسم و ساختار فیزیکی ما در فرآیندهای ذهنی، شناختی و زبانی حضور فعال دارند. به عبارت دیگر، ذهن

سازمان بهزیستی کشور اعلام کرد که کمکهزینه تأمین وسایل بهداشتی مهر ماه ۱۴۰۴ برای معلولان ضایعه نخاعی و معلولان شدید و خیلی شدید بستری تحت

کمیته برگزاری بازیهای المپیک و پارالمپیک زمستانی میلان و کورتینا ۲۰۲۶ به همراه مجموعهی ترییناله میلان از پوسترهای رسمی این رویدادهای زمستانی رونمایی کرد. این

به گزارش روابطعمومی فدراسیون ورزشهای ناشنوایان به نقل از هیأت استان گلستان، مراسم بدرقه ملیپوشان و اعضای کادر اجرایی گلستان اعزامی به المپیک ناشنوایان ۲۰۲۵

امیرحسین دوستعلی، نویسنده کتاب ،در گفتوگو با خبرگزاری کتاب ایران (ایبنا) از نبود حمایت برای نویسندگان کتاباولی و مشکلات مالی آنها در مسیر چاپ آثارشان

آیا ذهن انسان تنها پردازشگر افکار است یا میتواند در شکل دادن به واقعیت نقش داشته باشد؟ این پرسش، محور اصلی مفهوم هیپنوتیزم کوانتومی است؛

بانوان تهرانی میتوانند در قالب طرح ملی غربالگری سرطان پستان از خدمات ماموگرافی رایگان بهرهمند شوند. این طرح از ۲۶ مهر تا ۳ آبان در

بیماری کبد چرب معمولاً بهصورت خاموش پیشرفت میکند، اما گاهی نشانههای هشداردهندهای در پاها ظاهر میشود. این علائم ممکن است در نگاه اول بیاهمیت به

از آبان ۱۴۰۴، طرح کالابرگ الکترونیکی با سه تغییر اساسی اجرایی میشود تا معیشت خانوارهای کمدرآمد تقویت و کارایی طرح افزایش یابد. ۱. ثابت ماندن

مطالعات اخیر نشان میدهد بیش از نیمی از نوجوانان ایرانی، گفتوگو با والدین خود را «کم یا بسیار کم» توصیف کردهاند. این آمار زنگ خطری

سایپا و کمیته امداد تفاهمنامهای امضا کردند تا هزار دستگاه وانت به مددجویان تحت پوشش این نهادها اهدا شود. مراسم امضای این تفاهمنامه با حضور

آزاده عابدینزاده، سرپرست اداره میراث فرهنگی، گردشگری و صنایع دستی سازمان منطقه آزاد قشم، از شکوفایی هنر و خلاقیت زنان کارآفرین در روستای جهانی سهیلی

در تازهترین رخداد سینمای کوتاه ایران، از پوستر و تیزر رسمی فیلم کوتاه «نُشنیدنی» رونمایی شد. این اقدام در چارچوب معرفی اثر به مخاطبان و

در کتابخانه عمومی امیرکبیر کرج بخشی ویژه برای نابینایان و کمبینایان وجود دارد که نزدیک به ده سال است با عشق و دلسوزی توسط داریوش

حمام مصطفوی یکی از بناهای تاریخی ارزشمند استان مرکزی است که در شهرستان خنداب از توابع اراک واقع شده و قدمت آن به دوران پهلوی

نمایشگاه نقاشیهای محمدعلی سعیدی با عنوان «باغ ایرانی» از روز جمعه دوم آبانماه ۱۴۰۴ در گالری خط سفید افتتاح میشود و تا ۱۲ آبان ادامه

مریم کاظمیپور، سرپرست کاروان ایران در بازیهای پاراآسیایی جوانان ۲۰۲۵ دبی، از ترکیب متنوع و پرقدرت تیم ایران در این رقابتها خبر داد. وی اعلام

با حکم علیرضا بسیح، دبیرکل فدراسیون ورزشهای ناشنوایان، و تأیید شورای فنی فدراسیون، ابوالقاسم مسکینی از قهرمانان المپیک ناشنوایان، به عنوان کمکمربی تیم ملی فوتبال

یک کارشناس علوم ورزشی در گفتوگو با ایسنا تأکید کرد که ورزشکاران نسبت به افراد عادی به تغذیه دقیقتر و هدفمندتر نیاز دارند. تغذیه ورزشی

به گزارش «ایران زندگی»، پرداخت یارانه نقدی مهرماه ۱۴۰۴ از امروز (دوشنبه، ۲۸ مهرماه) آغاز شد. بر اساس اعلام رسمی، یارانه نقدی دهکهای اول تا

به گزارش ایسنا، دکتر سعید صادقیه اهری، معاون بهداشت دانشگاه علوم پزشکی اردبیل، در نشست خبری خود با اشاره به اهمیت پیشگیری از بیماریهای استخوانی

مرحله یکچهارم نهایی مسابقات بوچیا باشگاهی کشور با حضور ۱۲ تیم در مجموعه ورزشی شهید عظیمی در بابلسر برگزار شد. این رقابتها که با هدف

رجبعلی لباف خانیکی، باستانشناس و پژوهشگر میراث فرهنگی، در یادداشتی به اهمیت خلاقیت و سازگاری انسانهای گذشته با طبیعت پرداخته است. او میگوید: ساکنان ایران

تیم ملی گلبال مردان ایران با پیروزی ۳ بر ۲ مقابل تایلند، به فینال رقابتهای قهرمانی آسیا-پاسیفیک ۲۰۲۵ راه یافت و سهمیه حضور در مسابقات

سامانه بهزیستی جهت بارگذاری مدارک دانشجویی نیمسال جاری فعال شد.دانشجویان گرامی لازم است مدارک خود را در اسرع وقت در سامانه بارگذاری کنند.مدارک مورد نیاز:

پژوهشهای جدید نشان میدهد تحریک عصب واگ (یکی از مهمترین اعصاب بدن) میتواند به شکل مؤثری در کاهش بیخوابی و اضطراب نقش داشته باشد. این

کارشناسان سلامت تأکید میکنند که فعالیت بدنی منظم و رعایت رژیم غذایی متعادل، دو عامل کلیدی در حفظ سلامت و استحکام استخوانها هستند. به گفته

دکتر حسین چناری، مشاور حوزه کسبوکارهای آموزشی، در گفتوگویی با عصر ایران بر اهمیت تغییر در شیوههای آموزشی تأکید کرد و گفت: نسل Z به

تصور کنید هر قدمی که برمیدارید، نه تنها عضلاتتان را قویتر میکند، بلکه ارتباطات مغزی شما را فعالتر میکند. هفته تربیت بدنی فقط فرصتی برای

در سالهای اخیر، بهویژه پس از بحران کرونا، هزاران جوان ایرانی از نسل Z راهی تازه برای امرار معاش پیدا کردند: کار از پشت لپتاپ

مطالعات علمی نشان میدهد که نوشتن با دست فراتر از یک مهارت ساده نوشتاری، میتواند حافظه و تمرکز مغز را تقویت کند. زمانی که ما

چهارمین جلسه از سلسله نشستهای «در جستوجوی روایت ایرانی» به کتاب «بیاسمی» نوشته احمد شاکری اختصاص یافته است. این برنامه روز دوشنبه، ۲۸ مهرماه از

ایستگاه متروی مریم مقدس در خیابان کریمخان تهران، تنها یک ایستگاه شهری نیست؛ بلکه نمادی از ایمان، هنر و همزیستی ادیان در پایتخت ایران بهشمار

براساس گزارشی از دیجیاتو، نتایج پژوهش شرکت Amerisleep نشان میدهد که حدود ۷۰ درصد از اعضای نسل Z (متولدین بین ۱۹۹۷ تا ۲۰۱۲) به دلیل

طبق گزارشی از گیل خبر، تمرینهای ذهنی روزانه میتوانند نقش مهمی در افزایش تمرکز، تقویت حافظه و بهبود سلامت روان داشته باشند. کارشناسان معتقدند همانطور

اولین مرحله اردوی آمادگی و انتخابی فوتسال ID آقایان با هدف تشکیل تیم ملی و حضور در رقابتهای جهانی اسپانیا آغاز شد. به گزارش روابط

پلتفرم اسنپ سرویس درخواست خودرو را برای کاربران نابینا و کمبینا دسترسپذیر کرده تا رفتوآمد آنها سادهتر و راحتتر انجام شود. بر اساس آمار منتشرشده،

با حکم مصطفی نکولعلآزاد، رئیس فدراسیون ورزشهای ناشنوایان، بهروز مبشری به عنوان رئیس انجمن والیبال سالنی ناشنوایان کشور منصوب شد. در متن حکم صادره، با

یافتههای یک مطالعه پژوهشگران کانادایی و آمریکایی که در مجله «جاما» منتشر شد، ارتباط میان استفاده از شبکههای اجتماعی و کاهش تواناییهای شناختی نوجوانان را

در جستجوی خوشبختی، بسیاری از ما به دنبال دستاوردها، روابط یا لذتهای روزمره هستیم. اما پژوهشها نشان میدهند که اعتماد به دیگران، خود و جریان

نشست معرفی و نقد کتاب «ایران دل» روز چهارشنبه ۲۳ مهر ۱۴۰۴ در تالار زندهیاد یدالله ثمره بنیاد سعدی برگزار خواهد شد. در این مراسم،

در همایشی با عنوان «جهان ایرانی: ساسانی و پساساسانی» که در پژوهشگاه علوم انسانی برگزار شد، جمعی از پژوهشگران تاریخ، زبانشناسی و فرهنگ ایران، به

پژوهشی تازه که نتایج آن در نشریه علمی Cerebral Cortex منتشر شده، نشان میدهد تکامل هوش در انسان ممکن است بهایی پنهان در برداشته باشد:

به گزارش روابط عمومی فدراسیون ورزشهای جانبازان و توانیابان، وبیناری با حضور دکتر کوهپایهزاده رئیس فدراسیون، دکتر سعادتیار سرپرست دپارتمان آموزش آکادمی ملی پارالمپیک، طارق

دکتر محمدرضا عارف، معاون اول رئیسجمهور، در دیدار با مدالآوران پارادو و میدانی قهرمانی جهان اظهار داشت: «ورزشکاران توانیاب کشورمان با تلاش و پشتکار خود،

سازمان بهزیستی کشور اعلام کرد که حق پرستاری خانوادهمحور مربوط به مهرماه 1404 برای افراد دارای معلولیت جسمیحرکتی شدید و خیلی شدید و همچنین معلولان

به گزارش پایگاه خبری پهنه پرواز در شصتمین سالگرد تأسیس تماشاخانه سنگلج، استاد علی نصیریان با حضور در جمعی صمیمی از هنرمندان تئاتر، خاطرات جوانی

با حکم نکولعلآزاد رئیس فدراسیون، میلاد ماهانراد به عنوان عضو هیات رئیسه و مشاور فرهنگی و هنری رییس فدراسیون ورزشهای ناشنوایان منصوب شد. به گزارش

ملی پوشان دسته مثبت ۱۰۷ کیلوگرم کشورمان به مصاف حریفان خود رفتند. به گزارش پایگاه خبری پهنه پرواز به نقل از روابط عمومی فدراسیون ورزش

در حالی که تعیین مهریه بر اساس سکههای طلا همچنان رایج است، اما در دادگاههای خانواده پروندههایی مشاهده میشود که مهریههایی با داراییهای غیرمتعارف در

دیزنی با قراردادی هنگفت، حق اقتباس از رمانهای «موجودات ناممکن» (Impossible Creatures) نوشتهی کاترین راندل را خریداری کرده است تا جانشینی برای هری پاتر بسازد.

ید یک عنصر شیمیایی با نماد I و عدد اتمی ۵۳ است که در گروه هالوژنها قرار دارد. این عنصر به صورت جامد براق و

نشست نقد و بررسی کتاب «جمال و جلال رمان: واکاوی پنج رمان بیروط، غمسوزی، فصل توتهای سفید، گروگانکشی و سفر به آتش» به همت انتشارات

در دنیایی که فناوری و علم با شتابی شگفت انگیز پیش میروند، «هوش مصنوعی» دیگر صرفاً یک واژهی آیندهنگرانه نیست؛ بلکه سنگ بنای تغییرات عمیق

رسیدن به اندامی خوشفرم و متناسب، نیازمند انتخاب تمرینهای اصولی و پایبندی به اجرای صحیح آنهاست. حرکات ترکیبی، بهدلیل درگیر کردن چندین گروه عضلانی بهصورت

کلیهها از اندامهای حیاتی بدن هستند که با دفع سموم، تنظیم مایعات و کنترل فشار خون، نقشی اساسی در سلامت انسان دارند. با این حال،

برای پیشگیری از پوکی استخوان، محققان توصیه میکنند که در ساعات ابتدایی روز، برخی عادات سالم را در برنامه روزانه خود بگنجانید: نوشیدن یک لیوان

گردشگری گورستان، که به آن «تافوفیلیا» نیز گفته میشود، در سالهای اخیر رشد قابلتوجهی داشته و برای علاقهمندان فرصتی منحصربهفرد فراهم میکند تا با فرهنگ،

فرضیه «زمین بنفش» پیشنهاد میکند که در دوران باستانی زمین، حیات فتوسنتزی اولیه ممکن است بهجای رنگ سبز، بنفش بوده باشد. این ایده توسط پروفسور

درد استخوان در زنان یکی از مشکلات شایع است که میتواند دلایل مختلفی داشته باشد و کیفیت زندگی را تحت تأثیر قرار دهد. در ادامه

رئیس انجمن علمی متخصصان ریه ایران اعلام کرد که حدود ۸۵ درصد از موارد سرطان ریه در کشور به مصرف سیگار مربوط میشود. این آمار

قهوه و چای دو نوشیدنی پرمصرف در سراسر جهان هستند که هر دو اثرات قابلتوجهی بر عملکرد مغز، خلقوخو و میزان هوشیاری دارند. با وجود

انجمن آمریکایی بانک خون و درمانهای زیستی (AABB) در گفتوگویی اختصاصی با دکتر مریم اسدی، دانشمند و پژوهشگر ایرانی حوزه ژنتیک مولکولی و پزشکی بازساختی،

در دیداری صمیمانه در مجلس شورای اسلامی، مصطفی نکولعلآزاد رئیس فدراسیون ورزشهای ناشنوایان، بههمراه دکتر پوریا سهرابی رئیس شورای راهبردی فدراسیون و سید رامین موذنی

مدیرکل پیشگیری از معلولیتها و تلفیق اجتماعی سازمان بهزیستی کشور با ارسال نامهای رسمی از تمامی مدیران کل بهزیستی استانها خواست تا نهایت همکاری را

مدال برنز جهان بر گردن نیکو روزبهانی ملی پوش دسته مثبت ۸۶ کیلوگرم پاراوزنه برداری بانوان کشورمان موفق به کسب مدال برنز جهان شد. به

پژوهشگران با استفاده از نور LED و نانوپوستههای قلع، روشی نوین برای هدفگیری و نابودی سلولهای سرطانی ابداع کردهاند که میتواند عوارض جانبی دردناک شیمیدرمانی

کتاب «عادتهای اتمی» نوشته جیمز کلیر، یکی از پرفروشترین کتابهای حوزه توسعه فردی است که در سال ۲۰۱۸ منتشر شد. این کتاب به اهمیت عادتهای

دانشمندان دانشگاه سون یاتسن چین لایهای نازک و شناور ابداع کردهاند که با نور خورشید میتواند آبهای آلوده را تصفیه کند. این فناوری حتی در

خواب کافی نه تنها برای سلامت جسم ضروری است، بلکه بر کارکرد مغز، خلقوخو و توانایی تصمیمگیری نیز تأثیرگذار است. در ادامه چند راهکار مؤثر

بسیاری از رفتارهای روزمره ما به صورت ناخودآگاه انجام میشوند؛ از چککردن بیوقفه تلفن همراه گرفته تا بهتعویق انداختن کارها. این عادتها به مرور بخشی

به گزارش خبرآنلاین، ترکیب طبیعی دارچین و سیب یکی از بهترین دمنوشهای فصلی برای تقویت سیستم ایمنی بدن به شمار میآید. این نوشیدنی خوشعطر و

به گزارش ایسنا، دکتر آسیه الفتبخش، معاون پژوهش و آموزش پژوهشگاه سرطان معتمد جهاد دانشگاهی، از اجرای موفق ژندرمانی سرطان پستان برای نخستین بار در

نمایشگاه نقاشی «پیروان پوسیدگی» تازهترین مجموعه آثار میترا ابراهیمی، از ۱۱ تا ۲۲ مهرماه در گالری سهراب برپا شد؛ مجموعهای که بازتابی از دغدغههای انسان

با پایان رقابتهای لیگ باشگاههای کشور بوچیا بانوان – جام شهدای بهزیستی، تیم زنجان توانست با عملکردی درخشان، عنوان قهرمانی این دوره از مسابقات را

در آستانه هفته پارالمپیک، مراسم باشکوه گرامیداشت روز ملی پارالمپیک با حضور جمعی از مسئولان فدراسیون ورزشهای جانبازان و توانیابان، ملیپوشان و قهرمانان رشتههای پارادوومیدانی،

نویسنده انوشه میرمجلسی نام «ناصر تقوایی»، فیلمساز جریانساز و اندیشمند موج نوی سینمای ایران، با روایتهای متفاوتی گره خورده است. اما شاید هیچ روایت و

کارشناسان حوزه اجتماعی معتقدند که مفهوم رفاه کودکان در ایران نیازمند بازنگری و تحول بنیادین است. به گفته آنان، رفاه کودک تنها به مسائل اقتصادی

بر اساس تازهترین رتبهبندی جهانی سال ۲۰۲۵، ایران با میانگین ضریب هوشی ۱۰۶.۳۰ در جایگاه چهارم جهان قرار گرفته است. این آمار نشان میدهد که

پتاسیم یک عنصر شیمیایی ضروری است که در بدن انسان نقش حیاتی دارد. نماد شیمیایی آن K است و یک الکترولیت مهم به حساب میآید.

ذهن انسان، هر روز میزبان هزاران فکر است؛ برخی آرام و روشن، و برخی تیره و سنگین. افکار منفی، اگر مجال ماندن پیدا کنند، بهتدریج

در دنیایی که ذهنها زیر بار افکار، صداها و اضطرابهای بیپایان خسته شدهاند، «مانترا» همچون زمزمهای آرام از درون، راهی برای بازگشت به تعادل است.

گاهی ذهن پر میشود از افکار، دغدغهها و احساساتی که مجال گفتنشان را نداریم. نوشتن، سادهترین و در عین حال مؤثرترین راه برای رهایی از

مصطفی نکولعل آزاد، رئیس فدراسیون ورزشهای ناشنوایان اعلام کرد که با حمایت همهجانبهی دکتر دنیامالی، وزیر ورزش و جوانان، این فدراسیون روزبهروز در مسیر رشد

روز جهانی عصای سفیدتاریخ برگزاری: ۱۵ اکتبر (۲۳ مهر)هدف و اهمیت این روز چنین بیان شده است: آداب برخورد با کاربران عصای سفید: با پرداختن

امروز، زمین آرامتر میچرخد تا صدای گامهایی شنیده شود که شاید کمتر دیده میشوند؛ گامهایی که با عصای سپیدشان مسیر تاریکی را میکاوند و به

سلامت روان کودکان، ستون اصلی رشد و یادگیری مؤثر آنها است. کودکی که دچار اضطراب، ترس یا احساس بیارزشی باشد، توانایی یادگیری و تمرکز مؤثر

حفظ سلامت مغز و حافظه تا سنین بالا امکانپذیر است. کارشناسان هشت عادت ساده را برای تقویت حافظه و عملکرد شناختی توصیه میکنند: فعالیت بدنی

پژوهشگران مؤسسه علم و فناوری اوکیناوا در ژاپن با مطالعه بر روی موشها دریافتند که تجربه شکست میتواند تأثیر قابلتوجهی بر رفتار و جایگاه اجتماعی

به گزارش خبرآنلاین، مسعود فیروزکوهی کارشناس تغذیه با اشاره به اهمیت تغذیه صحیح و فعالیت بدنی منظم برای حفظ سلامت استخوانها گفت: رعایت اصول تغذیهای

در آستانۀ برگزاری چهلودومین جشنواره بینالمللی فیلم کوتاه تهران، اعضای هیأت انتخاب بخش داستانی مسابقۀ سینمای ایران معرفی شدند. به گزارش پایگاه اطلاعرسانی انجمن سینمای

کورتیزول که معمولاً از آن با عنوان هورمون استرس یاد میشود، یکی از مهمترین هورمونهای بدن است که توسط غدد فوق کلیوی (آدرنالها) ترشح میشود.

به گزارش روابط عمومی ادارهکل ورزش و جوانان استان مرکزی، دکتر محمد مرادی، مدیرکل ورزش و جوانان استان مرکزی، در همایش روز ملی پارالمپیک با

به گزارش روابط عمومی فدراسیون ورزشهای ناشنوایان، مصطفی نکولعلآزاد، رئیس فدراسیون ورزشهای ناشنوایان، به همراه علیرضا بسیح دبیر فدراسیون، با حضور در فرمانداری تهران با

به گزارش روابط عمومی کمیته ملی پارالمپیک و به نقل از فدراسیون ورزشهای جانبازان و توانیابان، پنجمین مرحله از تمرینات تیم ملی پارادوومیدانی کشورمان با

بیستم مهرماه، در تقویم فرهنگی ایران، به نام لسانالغیب حافظ شیرازی مزین است؛ شاعری که بیتردید یکی از شگفتانگیزترین چهرههای تاریخ اندیشه و ادب ایرانی

سیوهفتمین جشنواره بینالمللی فیلمهای کودکان و نوجوانان با برگزاری مراسم اختتامیه در اصفهان به کار خود پایان داد. در این مراسم، از چهرههای شاخص سینمای

مهندسی بافت (Tissue Engineering) در سالهای اخیر بهعنوان یکی از پیشروترین حوزههای پژوهش زیستپزشکی، انقلابی در درمان آسیبهای استخوانی ایجاد کرده است. این علم با

فناوریهای نوین بار دیگر مرز میان انسان و ماشین را درنوردیدهاند؛ این بار با ورود به قلمرو ذهن. گزارش خبرآنلاین از موج جدید سرمایهگذاریها در

در دنیایی که هر روز بیشتر از گذشته از «تحول دیجیتال» و «شهر هوشمند» میشنویم، افراد دارای معلولیت هنوز با موانعی روبهرو هستند که حتی

تنبلی تخمدان یا سندرم تخمدان پلیکیستیک (PCOS) یکی از مشکلات شایع در میان زنان است که میتواند منجر به بینظمی قاعدگی، افزایش هورمونهای مردانه، رشد

در مقالهای که سایت «عصر ایران» منتشر کرده است، به مشکلی بنیادین در زبان فارسی اشاره شده: نوسان در معنای کلمات. این پدیده که در

مهدیه محمدیان در رده پنجم گروه C ایستاد به گزارش پایگاه خبری پهنه پرواز به نقل از روابط عمومی کمیته ملی پارالمپیک و به نقل

سرمربی تیم های «الف» و «ب»والیبال ساحلی ناشنوایان که این تیم ها را برای اعزام به المپیک ۲۰۲۵ آماده می کند، در مورد شرایط تمرینی

حافظ شخصی آستانهنشین است. آستانۀ یعنی درگاهِ یک ساختمان، یعنی دَمِ در. آستانه در برابر صدر قرار دارد. صدر مجلس یعنی بالاترین جای جلسه که

آکادمی نوبل سوئد در مراسمی رسمی اعلام کرد که هان کانگ، نویسنده برجسته اهل کره جنوبی، برنده جایزه نوبل ادبیات سال ۲۰۲۴ شده است. او

در مسابقات بینالمللی اختراعات ژنو ۲۰۲۵، یک دانشجوی رشتهی شیمی کاربردی از دانشگاه مراغه موفق به کسب نشان طلا شد؛ افتخاری که نام ایران را

پیشرفت سریع هوش مصنوعی، در کنار فرصتهای شگفتانگیز علمی و پزشکی، سایهای از تهدید را نیز بر سر آیندهی بشر گسترانده است. فناوریای که میتواند

سرپرست بهزیستی مازندران با ملیپوشان تکواندو بانوان ناشنوایان دیدار کرد به گزارش پایگاه خبری پهنه پرواز به نقل از روابطعمومی فدراسیون ورزشهای ناشنوایان به نقل

اسحاق نیا به دو نشان طلا دست یافت / حسن ختام روز درخشان جوانان ایران در قاهره روز طلایی کاروان پاراوزنهبرداری کشورمان با ۲ مدال

نتایج یک پژوهش جدید که در همایش «هفته گوارش اروپا» (United European Gastroenterology Week 2025) ارائه شد، نشان میدهد مصرف منظم نوشابههای معمولی و حتی

دانشمندان در پژوهشی تازه به کشفی شگفتانگیز رسیدهاند: خلاقیت در هوش مصنوعی ویژگی اضافه یا برنامهریزیشده نیست، بلکه نتیجه طبیعی محدودیتهای درونی مدلهای یادگیری است.

نتایج پژوهشی جدید نشان میدهد که مصرف روزانه آلو خشک میتواند به زنان یائسه کمک کند تا استخوانهای قویتری داشته باشند و خطر شکستگی را

محققان دانشگاه شیکاگو دریافتهاند که در نقطهای از زندگی، ما به شکلی غیرمنتظره شروع به «اجتناب از اطلاعات» میکنیم؛ یعنی مغزمان را خاموش میکنیم حتی

آرزو ذکاییفر؛ رئیس مرکز توسعه کارآفرینی، اشتغال و توانمندسازی سازمان بهزیستی کشور اعلام کرد: دانشآموزان تحت پوشش سازمان بهزیستی که واجد شرایط بورسیه هستند، میتوانند بهصورت

نویسنده: دکتر هادی صمدی مهمترین توصیهی آلبرت الیس، بانی رواندرمانی عقلانی _ هیجانی، این است که «رفتار یا باور نامعقول یک فرد را نقد کن،

حسن محمد حسین پور ملی پوش پاراوزنهبرداری کشورمان در دسته ۸۰ کیلوگرم است که فردا ساعت ۱۷:۲۰ عصر به وقت ایران به مصاف حریفان خود

امروز ۱۸ مهرماه و آغاز هفته پارالمپیک است. هفته پارالمپیک از ۱۸ تا ۲۴ مهرماه برگزار میشود و برای هر یک از روزهای این هفته

مقالهای از دنیای اقتصاد با عنوان «تفکر معکوس؛ کلید شفافیت ذهنی» به معرفی روشی خلاقانه برای تفکر و حل مسئله میپردازد که میتواند دید ما

وبسایت هشتینو در مقالهای با عنوان «ذهن آشفته، زندگی آشفته» به بررسی تأثیر شلوغی ذهن بر کیفیت زندگی و معرفی چند روش ساده برای رسیدن

بر اساس گزارشی از یورونیوز فارسی، پژوهشها نشان میدهد حدود یک نفر از هر صد نفر ممکن است ویژگیهایی از روانپریشی (Psychopathy) را در خود

سازمان بهزیستی کشور از برگزاری مراکز توانبخشی و مراکز تحت پوشش خود در سال ۱۴۰۴ خبر داد و تأکید کرد که این طرحها در سراسر

لیلا زندوکیلی به عنوان مشاور استعدادیابی در مدارس استثنایی فدراسیون منصوب شد به گزارش پایگاه خبری پهنه پرواز به نقل از روابط عمومی فدراسیون ورزشهای

ملی پوشان جوان کشورمان با همراهی فدراسیونهای مربوطه و کادر فنی در حال آماده سازی برای شرکت در این بازی ها هستند. بازی های پاراآسیایی

به گزارش برنا از استان مرکزی، مراسم بزرگداشت روز ملی پارالمپیک روز ۲۴ مهرماه ساعت ۸:۳۰ صبح در مجموعه ورزشی شهدای ۵ مرداد اراک برگزار

در آستانه آغاز مسابقات قهرمانی جهان پاراوزنهبرداری ۲۰۲۵ در مصر، ملیپوشان جوان کشورمان آمادهی رویارویی با حریفان خود هستند.امیرعلی رشیدیمهر، نماینده شایسته ایران در دستهی

در اقدامی نوآورانه و کاربردی، ویلچری طراحی و ساخته شده است که قابلیت عبور از پلهها را دارد. این وسیله توانسته است یک تحول بزرگ

ششمین مرحله اردوی آمادگی تیم ملی والیبال نشسته مردان اعزامی به بازیهای پاراآسیایی ناگویا در شهر خرمآباد، استان لرستان برگزار شد. به گزارش روابط عمومی

در راستای گسترش همکاریهای آموزشی و ورزشی، مصطفی نکولعلآزاد، رئیس فدراسیون ورزشهای ناشنوایان، با دکتر لشگری، مدیرکل ورزش و تربیت بدنی دانشگاه آزاد اسلامی، دیدار

در مراسمی رسمی با حضور رئیس سازمان بهزیستی کشور، امیر قلعهنویی، سرمربی تیم ملی فوتبال ایران، به عنوان سفیر ملی ورزش و نشاط اجتماعی سازمان

شاید تصور کنید آینههای داخل آسانسور فقط برای مرتب کردن ظاهر یا زیبایی فضا هستند، اما در واقع پشت این طراحی ساده، دلایل روانشناختی و

گزارشی از خبرگزاری ایلنا نشان میدهد که بسیاری از افراد دارای معلولیت در ایران با مستمری ماهانه حدود دو میلیون و ۸۰۰ هزار تومان روزگار

ساییدگی زانو یا آرتروز زانو یکی از شایعترین مشکلات مفصلی است که معمولاً در اثر افزایش سن، اضافهوزن یا فشارهای مکرر به مفصل زانو ایجاد

در مراسمی که روز دوشنبه توسط مجمع نوبل در مؤسسه کارولینسکا برگزار شد، ماری ای. برونکوف، فِرد رامسدل و شیمون ساکاگوچی به پاس پژوهشهای نوآورانهشان

در مقالهای منتشر شده در عصر ایران، تفاوتهای میان افرادی بررسی شده است که با وجود توانمندیهای علمی مشابه، مسیرهای متفاوتی در زندگی حرفهای خود

در چهلودومین جشنواره بینالمللی فیلم کوتاه تهران، بخش «مقاومت» با رویکرد «خِردمحوری و اندیشهورزی» برگزار میشود. این بخش غیررقابتی شامل آثار داستانی، مستند، تجربی و

بخشی از بیماریها و مشکلات سلامتی که در دوران سالمندی بروز میکنند، ناشی از عوامل ژنتیکی هستند؛ اما عاملی مهمتر که تأثیر زیادی دارد سبک

با افزایش سن، حفظ تناسب اندام، تعادل و انرژی روزانه اهمیت ویژهای پیدا میکند. رعایت چند نکته ساده میتواند به زنان بالای ۵۰ سال کمک

در اقدامی نمادین و همسو با شعار روز جهانی گردشگری با عنوان «گردشگری و تحول پایدار»، اردوی تفریحی–آموزشی ویژه ناشنوایان بهصورت رایگان در مشهد برگزار

مراسم بدرقه کاروان پاراوزنهبرداری کشورمان اعزامی به مسابقات قهرمانی جهان ۲۰۲۵ مصر، صبح امروز در فضایی معنوی و در جوار مزار شهید گمنام واقع در

کتاب «برتری خفیف» (The Slight Edge) نوشتهی جف اولسون (Jeff Olson) یکی از کتابهای بسیار محبوب در زمینهی موفقیت شخصی، رشد فردی و ایجاد عادات

اردوی فرهنگی و تفریحی بنیاد خیریه معلولین ایرانیان با حضور بیش از ۲۵۰ نفر از افراد دارای معلولیت و خانوادههایشان، از ۲۹ شهریور تا ۲

به گزارش پایگاه خبری پهنه پرواز به نقل از روابط عمومی فدراسیون ورزشهای جانبازان و توانیابان، معاون توسعه ورزش بانوان وزارت ورزش و جوانان، موفقیت

پژوهشگران استرالیایی موفق به توسعه فناوری جدیدی مبتنی بر هوش مصنوعی شدهاند که میتواند به شناسایی دقیق نواحی مغزی مسئول بروز صرع در کودکان کمک

بسیاری از مواد غذایی که به عنوان «سالم» شناخته میشوند، در صورت مصرف بیش از حد، ممکن است خطر سنگ کلیه را افزایش دهند. این

در تازهترین اظهارات جنسن هوانگ، مدیرعامل شرکت انویدیا، آمده است که کشورها به زیرساخت مستقلی برای هوش مصنوعی نیاز دارند — آنقدر که او میگوید،

در دنیای امروز که اطلاعات بهراحتی در دسترس است، آموزش صرفِ حفظ کردن دیگر کافی نیست. کودکان باید بیاموزند چگونه فکر کنند، تحلیل کنند و

ملی پوش پارادوومیدانی کشورمان در ماده پرتاب وزنه رکورد جهان را شکست و طلا گرفت. به گزارش پایگاه خبری پهنه پرواز به نقل از روابط

به گزارش پایگاه خبری پهنه پرواز دکتر احمد دنیامالی در پیامی، موفقیت کاروان ورزشکاران کشورمان در مسابقات پارادومیدانی قهرمانی جهان را تبریک گفت متن پیام

در تقارن جشن ملی مهرگان، طبیعت رنگارنگ پاییز و روز جهانی گردشگری، فرصتی مغتنم برای معرفی ظرفیتهای بیبدیل ایران در عرصه گردشگری به جهان فراهم

رییس مرکز سرمایهگذاری وزارت میراث فرهنگی، گردشگری و صنایع دستی ایران، در گفتوگویی با ایرنا، بر لزوم تبدیل میراث مشترک کشورهای منطقه به شبکهای برای

با فرا رسیدن فصل پاییز و تغییرات جوی، خطر ابتلا به بیماریهای عفونی و تنفسی افزایش مییابد. منابع طب ایرانی برای مقابله با این تهدید،

پژوهشهای تازه نشان میدهند که رژیم غذایی کتوژنیک، علاوه بر نقش آن در کنترل وزن و بهبود عملکرد متابولیک، ممکن است تأثیری قابلتوجه بر کاهش

در دنیای پرهیاهوی آپارتماننشینی امروز، بالکن میتواند نقش یک «پناهگاه طبیعی» را برای جسم و روان ایفا کند. کارشناسان معتقدند که حضور در فضایی نیمهباز

در آستانه روز جهانی سالمندان، مدیرعامل سازمان بیمه سلامت ایران اعلام کرد که این سازمان با توسعه پوشش بیمهای و کاهش هزینههای درمانی، در تلاش

پژوهشهای تازه نشان میدهند که شببیداری و کمخوابی مداوم، تأثیر مستقیمی بر کاهش ترشح «هورمون عشق» یا همان اکسیتوسین دارد؛ مادهای که نقش مهمی در

نتایج تازه تحقیقات علمی نشان میدهند که حافظه انسان از ظرفیتهای پنهانی برخوردار است که با روشهای خاصی میتوان آن را «تقویت» کرد — به

ملی پوش پارادوومیدانی کشورمان در ماده پرتاب کلاب به مصاف حریفان خود رفت. به گزارش پایگاه خبری پهنه پرواز به نقل از روابط عمومی فدراسیون

نویسنده : روح ا.. قطبی مدیر عملیات تور (Tour Operations Manager) فردی است که مسئولیت اصلی او برنامهریزی، هماهنگی و نظارت بر تمام جزئیات یک

اعضای تیم ملی تکواندو ناشنوایان در هر دو بخش گیوروگی و پومسه، دور جدید تمرینات شان برای شرکت در بازی های المپیک ۲۰۲۵ در تهران و

زهرا نوعپرست، مدیرکل دفتر توانبخشی سازمان بهزیستی، در گفتوگویی درباره نقش فناوریهای نوین در بهبود کیفیت زندگی ناشنوایان و کمشنوایان، به اهمیت هوش مصنوعی و

جشن مهرگان در فرهنگ ایران باستان پس از نوروز، یکی از مهمترین آیینهای ملی و مردمی به شمار میرفته است. این جشن نماد اعتدال پاییزی

پروفسور مریم میرزاخانی، ریاضیدان برجسته ایرانی و استاد دانشگاه استنفورد، یکی از درخشانترین چهرههای علمی معاصر است که نامش با افتخار در تاریخ علم ثبت

استان کرمان میزبان برنامه استعدادیابی والیبال بانوان ناشنوای ایران شد؛ رویدادی که با هدف شناسایی استعدادهای برتر و زیر نظر ندا نولا هویزه، سرمربی تیم

در هفتمین روز مسابقات پارادوومیدانی قهرمانی جهان ۲۰۲۵ در هند، علیاصغر جوانمردی، ملیپوش کشورمان در ماده پرتاب وزنه کلاس F35 با پرتابی به طول ۱۷.۱۷

در آستانه جشن مهرگان، شایسته است به دو میراث فرهنگی بینظیر اما کمتر شناختهشده بپردازیم: «تخت سلیمان» و آیین «قالیشویان». این دو رویداد نهتنها جلوههایی

به گزارش عصر ایران، دوره اوان کودکی (زیر هفت سالگی) یکی از حساسترین مراحل رشد انسان است، اما در ایران توجه کافی به آموزش و

به گزارش عصر ایران، سعیده سادات موسوی، دکترای تکنولوژی آموزشی، با تأکید بر اهمیت تلفیق فناوری و آموزش در مدارس اظهار داشت: اگر نظام آموزشی

به گزارش ایبنا، مینا شکیباراد نویسنده و پژوهشگر لرستانی با اشاره به اهمیت افسانهها و متلهای بومی این خطه تأکید کرد که این روایتهای کهن

به گزارش ایسنا، سلامت روانی دانشآموزان یکی از موضوعات مهم و حیاتی نظام آموزشی کشور است که نیازمند همکاری و همافزایی همه دستگاههای اجرایی میباشد.

در خبری منتشر شده در خبرآنلاین آمده است که شرکت یادشده، اقدام به توزیع وعده غذای رایگان در بازهای ۲۰ دقیقهای میکند. ظاهراً هدف اصلی

گزارش تازهای از دنیای اقتصاد نشان میدهد که کمبود ویتامین D میتواند یکی از دلایل اصلی بروز دردهای استخوانی باشد. این ویتامین نقشی اساسی در

نکولعلآزاد رئیس فدراسیون بهمراه داودی نایب رئیس از اردوی تیم ملی تنیس روی میز در رباط کریم بازدید کردند به گزارش روابط عمومی فدراسیون ورزشهای

علی اصغر جوانمردی ملی پوش پارادوومیدانی کشورمان در ماده پرتاب وزنه است که فردا ساعت ۱۶ عصر به وقت ایران به مصاف حریفان خود می

ملی پوش پارادوومیدانی کشورمان با شکستن رکورد جهان عنوان قهرمانی و مدال طلا مسابقات را از آن خود کرد. به گزارش پایگاه خبری پهنه پرواز

به گزارش پایگاه خبری پهنه پرواز، مراسم گرامیداشت روز جهانی ناشنوایان به دعوت دکتر مصطفی نکو لعل آزاد رئیس فدراسیون ورزشهای ناشنوایان و با حضور

رئیس سازمان بورس و اوراق بهادار گفت: واریز مرحله دوم سود سهام عدالت سال مالی منتهی به ۲۹ اسفندماه ۱۴۰۲ شرکتهای سرمایهپذیر از فردا (چهارشنبه)

روند سالمندی جمعیت در ایران با سرعتی نگرانکننده در حال افزایش است. بر اساس گزارشها، سهم افراد ۶۵ سال به بالا از جمعیت کشور از

برای داشتن خوابی بهتر و بیدار شدن سرحال با ۶ تا ۷ ساعت خواب، میتوانید از عادتهای خواب ژاپنی الهام بگیرید. در ادامه، برخی از

دانشمندان دانشگاه کمبریج و دانشگاه عبری اورشلیم، آزمایشی جالب را با چتجیپیتی انجام دادند تا توانایی این مدل در یادگیری و حل مسائل ریاضی را

رئیس سازمان بهزیستی کشور در آیین افتتاح نخستین کلینیک مشاوره ویژه ناشنوایان، از دستاوردهای مهم این سازمان در حوزه حمایت از افراد دارای اختلال شنوایی

اختر صیادی، عضو وابسته مرکز خدمات تخصصی تولید محتوای سلامت و پژوهشکده علوم بهداشتی جهاددانشگاهی، در گفتوگویی با خبرآنلاین توضیح داد که اصلاح سبک زندگی

نتایج یک بررسی جامع علمی نشان داده است که ذرات ریز پلاستیکی، شامل میکروپلاستیکها و نانوپلاستیکها، میتوانند وارد بافت استخوانی بدن انسان شوند و حتی

تحقیقات جدید نشان میدهد نزدیک به ۴۰ درصد از نسل Z — متولدین اواخر دهه ۱۹۹۰ تا اوایل دهه ۲۰۱۰ — توانایی نوشتن مؤثر با

با افزایش سن، توانایی مغز برای دفع مواد مضر کاهش مییابد و همین موضوع میتواند زمینهساز بیماریهایی مانند زوال عقل شود. بررسیها نشان داده است

بیماری اماس (اسکلروز چندگانه) در سالهای اخیر در ایران با رشد چشمگیری مواجه شده است. بر اساس گزارشها، حدود ۱۲۰ هزار نفر در استانهای مختلف

شعر فارسی همواره مملو از ابیات عاشقانه و غزلهای شورانگیز است و در این میان، اسماعیل خویی یکی از شاعران برجسته معاصر به شمار میرود.

تحقیقات روانشناسی نشان میدهد که زمان روز نقش مهمی در کارایی ذهن و کیفیت تصمیمگیری دارد. مغز انسان طی روز نوسانات انرژی و تمرکز را

یکی از پرسشهای همیشگی در حوزه سلامت و بهداشت فردی این است که بهترین زمان برای دوش گرفتن، صبح است یا شب؟ هرچند پاسخ قطعی

بیماری اماس (MS) یکی از شایعترین بیماریهای خودایمنی سیستم عصبی مرکزی است که بیشتر جوانان ۲۰ تا ۴۰ ساله را درگیر میکند. این بیماری به

در روزهای اخیر همزمان با اجرای طرح جدید دولت برای شناسایی دهکهای درآمدی و حذف یارانه نقدی بخشی از خانوارها، نگرانیهایی در میان جامعه معلولان،

نویسنده فریبا بکتاش فناوری دیجیتال صنعت گردشگری را متحول کرده است و نسل جدید مسافران، به ویژه نسل Z، شیوه سفر خود را بر اساس

مرحله دوم معاینات پزشکی و تستهای آمادگی جسمانی گروه دوم ملیپوشان ناشنوای اعزامی به بازیهای المپیک تابستانی ناشنوایان ۲۰۲۵ توکیو، امروز در مجموعه ورزشی آزادی

دکتر غفور کارگری، رئیس کمیته ملی پارالمپیک، به همراه دکتر سعید سلگی، معاون ورزش قهرمانی کمیته، از اردوی تیم ملی پاراجودوی نابینایان و کمبینایان بازدید

دوازدهمین دوره رقابتهای قهرمانی جهان پارادوومیدانی با حضور بیش از ۱۲۰۰ ورزشکار از ۱۰۴ کشور جهان در دهلی نو آغاز شد. این مسابقات شامل ۱۸۶

برای نخستین بار در تاریخ صنعت گردشگری ایران، آیین اعطای «نشان سبز هتلهای ایران» روز پنجشنبه ۵ مهرماه همزمان با روز جهانی گردشگری در سالن

در راستای سیاستهای جدید سازمان بهزیستی کشور، فرزندان مراکز بهزیستی تنها در صورت توانمندسازی شغلی و روانی، امکان ترخیص خواهند داشت. این رویکرد با هدف

در سالهای اخیر، با بازگشایی مدارس، آسیبهای اجتماعی در اطراف و داخل مدارس افزایش یافته است. کارشناسان حوزه آموزش بر این باورند که در سایه

زنان هنرمند سیستان و بلوچستان با دستان پرتوان خود، هنر دیرینه سوزندوزی و صنایع دستی را به ابزاری برای اشتغالزایی و معرفی فرهنگ غنی این

دکتر کارل ای. پیکهاردت، روانشناس با تجربه، در کتاب «بقا در دوران نوجوانی فرزندتان» نقشه راهی برای عبور والدین از مسیر پرچالش دوران نوجوانی فرزندان

مطالعهای جدید نشان میدهد که آگاهی ممکن است از قدیمیترین بخشهای مغز انسان نشأت بگیرد. دانشمندان حدود ۳۵ سال پیش با جدیت بیشتری به سوالاتی

پژوهشی تازه از دانشگاه بوستون نشان میدهد مغز انسان هنگام مواجهه با یک رویداد مهم یا هیجانانگیز، نه تنها همان لحظه را بهخوبی ثبت میکند،

ژاله قائممقامی (۱۲۸۶–۱۳۵۹) از نخستین زنان شاعر معاصر ایران بود که در خانوادهای اهل فرهنگ در تهران متولد شد. او از همان نوجوانی به شعر

یک روانشناس خانواده تأکید کرد: والدین میتوانند با ایجاد نظم در خواب و بیداری، تغذیه مناسب و آشنایی تدریجی فرزندان با فضای مدرسه، نقش مهمی

مدیرکل بهزیستی استان قزوین گفت: اجرای چرخه کامل ساماندهی معتادان متجاهر از مرحله جمعآوری تا توانمندسازی، میتواند نقش مؤثری در کاهش آسیبهای اجتماعی و ارتقای

نویسنده : بیژن همدرسی در جوامع امروز، فشارهای روانی و اختلالات هیجانی به یکی از چالشهای جدی سلامت عمومی تبدیل شده است. در کنار روشهای

تیم ملی فوتبال نابینایان ایران در چهارمین دیدار خود از رقابتهای جام ملتها که به میزبانی هند در حال برگزاری است، مقابل کره جنوبی به

تیم ملی بسکتبال با ویلچر مردان ایران با ترکیبی از بازیکنان جوان، باتجربه و لژیونر در تورنمنت چهارجانبه ترکیه حضور یافت تا خود را برای

اختلالات خواب میتوانند یکی از اولین و مهمترین علائم مشکلات روانی باشند. افرادی که دچار اضطراب، افسردگی یا استرس مزمن هستند، اغلب مشکل در به

مطالعات جدید نشان میدهد که نرخ ناتوانی شناختی در آمریکا طی یک دهه گذشته بهطور قابل توجهی افزایش یافته است، بهویژه در میان افراد زیر

به گزارش سازمان بهزیستی، تعداد افراد دریافتکننده مستمری در حوزه توانبخشی به ۱۰۴,۹۹۹ نفر رسیده است نرگس ژیانعابد، معاون توانبخشی بهزیستی استان، اعلام کرد که

خستگی مغزی مثل خستگی جسمی طبیعی است؛ تمرکز کاهش مییابد، انگیزه کم میشود و حس کسلی سراغمان میآید. اما با چند راهکار ساده میتوان انرژی

فرمول قدیمی «پسانداز کن، سرمایهگذاری کن و صبور باش» دیگر برای نسل Z جواب نمیدهد. دلیلش روشن است: شرایط اقتصادی امروز با گذشته فرق دارد.

گاهی پیش میآید که حتی سادهترین کارها برایمان سخت میشوند و هیچ انرژی یا انگیزهای برای شروع نداریم. اما واقعیت این است که حس و

اختلال نعوظ (Erectile Dysfunction) به شرایطی گفته میشود که مرد نتواند نعوظ کافی ایجاد کرده یا آن را در طول رابطه حفظ کند. گاهی این

فاطمه عباسی، معاون توانبخشی سازمان بهزیستی کشور، پیرو وعده سازمان بهزیستی در خصوص افزایش سرانه کمک هزینه تامین لوازم بهداشتی از پرداخت سرانه ۱۵ میلیون

اعضای تیم های ملی دوومیدانی مردان و زنان که برای شرکت در بازی های المپیک ناشنوایان آماده می شوند، تمرینات خود را در قالب چهارمین

ملی پوش پارادوومیدانی کشورمان در ماده پرتاب وزنه به مصاف حریفان خود رفت. به گزارش پایگاه خبری پهنه پرواز به نقل از روابط عمومی فدراسیون

از یک نگاه کلان میتوانیم دشمنانمان را به دو دستۀ بزرگ تقسیم کنیم: دشمنان بیرونی و دشمن درونی. منظور از دشمنان بیرونی همۀ انسانهایی هستند

مغز نوجوانان در دوران رشد، بهویژه در سنین ۱۲ تا ۲۵ سال، در حال بازسازی و تغییرات گستردهای است. در این دوره، مغز بهطور فعال

در دنیای پرشتاب امروز، زندگی مدرن ما را وادار کرده چند کار را با هم انجام بدهیم. کارها مانند برجی لرزان که هر لحظه بیم

پژوهشگران دانشگاههای زوریخ سوئیس و کالیفرنیای جنوبی آمریکا به تازگی موفق به شناسایی روشی نوین برای درمان آسیبهای مغزی ناشی از سکته مغزی شدهاند. این

با آغاز سال تحصیلی جدید، بسیاری از والدین و معلمان با این پرسش مواجهاند که چرا دانشآموزان نسل Z نسبت به درس خواندن بیمیل هستند.

با آغاز سال تحصیلی جدید، گزارشها حاکی است که دانشآموزان در برخی مناطق کشور با مشکلات جدی در سواد خواندن روبهرو هستند. در برخی مدارس،

استیو جابز هوش را فقط به عدد IQ محدود نمیدانست. از نگاه او، باهوشتر بودن یعنی توانایی وصل کردن نقاطی که دیگران نمیبینند و دیدن

پژوهشگران برای نخستین بار موفق شدند بخشی از مغز را شناسایی کنند که مانند یک شمارندهی داخلی مسافت عمل میکند و به ما کمک میکند

در دومین دیدار از رقابتهای جام ملتهای فوتبال نابینایان هندوستان، تیم ملی ایران برابر تیم قدرتمند انگلستان به میدان رفت و در یک بازی سخت

یکی از شهروندان روایت میکند:به دلیل سرماخوردگی و تنگی نفس با ویلچر به اورژانس بیمارستان خیریه غیاثی مراجعه کردم. پس از معاینات اولیه، گفتند باید

رئیس سازمان بهزیستی کشور اعلام کرد که میزان وام خرید یا ساخت مسکن ویژه افراد دارای معلولیت افزایش یافته است. بر این اساس، مبلغ وام

از فردا تمرینات تیم ملی شنا جوانان جانباز و توانیاب در مجموعه ورزشی آزادی کلید میخورد.به گزارش روابط عمومی فدراسیون ورزشهای جانبازان و توانیابان، این

به مناسبت هفته جهانی گردشگری و در تقارن با میلاد خجسته حضرت عبدالعظیم حسنی (ع)، دومین رویداد ملی «گفتاورد میراث فرهنگی و گردشگری ایران» برگزار

لکُووورین (Leucovorin) که به نام اسید فولینیک نیز شناخته میشود، یک داروی قدیمی است که عمدتاً برای کاهش عوارض شیمیدرمانی و درمان کمبود اسید فولیک

در سالهای اخیر، پیشرفتهای علمی در حوزه پزشکی امکان تشخیص برخی بیماریها را بدون نیاز به روشهای تهاجمی مانند کولونوسکوپی فراهم کرده است. یکی از

با افزایش سن، سلامت جسمی و روانی تغییرات زیادی را تجربه میکند. در این دوران، پیشگیری و تشخیص زودهنگام بیماریها از اهمیت ویژهای برخوردار است.

با افزایش سن و سالمندی جمعیت، بیماری آلزایمر یکی از چالشهای مهم سلامت عمومی محسوب میشود. هرچند این بیماری پیشرونده است، اما با تشخیص زودهنگام

اگر اخیراً مصرف کافئین خود را کاهش دادهاید، ممکن است متوجه شده باشید که خوابهایتان زندهتر و واضحتر شدهاند. این تجربه برای بسیاری از افراد

هشت عضو کانون پرورش فکری کودکان و نوجوانان ایران در بیستوچهارمین دوره مسابقه بینالمللی نقاشی محیطزیست ژاپن (GKOA) موفق به کسب افتخارات ارزشمندی شدند.در این

پیشرفتهای علمی در سالهای اخیر نشان میدهد که ژندرمانی و سلولدرمانی میتوانند به عنوان روشهایی نوین و امیدبخش برای درمان سرطان به کار گرفته شوند.

با آغاز سال تحصیلی جدید، یکی از دغدغههای اصلی والدین و معلمان، حفظ انگیزه دانشآموزان دبیرستانی است. کارشناسان تعلیم و تربیت در گزارشی که به

روز جمعه بوستان نرگس تهران میزبان رقابت مهیج پارا کُرنهول ویژه افراد دارای معلولیت بود؛ رویدادی ورزشی که با همکاری مدیریت ورزش و معاونت ورزش

در نشست مشترک مسئولان فدراسیون ورزشهای جانبازان و توانیابان با روسای انجمنهای ورزشی، دکتر جلیل کوهپایهزاده بر لزوم توجه به همه رشتهها، برنامهریزی دقیق برای

در جریان برگزاری کنفرانس و مجمع عمومی کمیته بینالمللی پارالمپیک (IPC) در سئول، دکتر غفور کارگری رییس کمیته ملی پارالمپیک ایران و مشاور ویژه رییس

سامسونگ بهتازگی فناوری نوینی معرفی کرده که به کمک گوشیها و ساعتهای هوشمند میتواند نشانههای اولیه زوال شناختی و آلزایمر را شناسایی کند. این روش،

پلیسیتمی (Polycythemia) به افزایش غیرطبیعی تعداد گلبولهای قرمز خون اطلاق میشود که میتواند منجر به غلظت خون و افزایش خطر لختهشدن، سکته و فشار خون

در ایران، پدیده بازنشستگی پیش از موعد به حدی گسترش یافته که گفته میشود فردی میتواند با ۳۵ سال سن بازنشسته شود. مصطفی سالاری، مدیرعامل

استان مازندران با افزایش چشمگیر موارد ابتلا به دیابت و فشار خون روبهروست؛ موضوعی که هشدار قرمز برای سلامت جامعه است. سن ابتلا به این

مقالهی زومیت به بررسی یک مدلسازی علمی (بر پایه مطالعهای از دانشگاه استنفورد) میپردازد که اثر اجرای «ساعت استاندارد دائمی» — یعنی حذف تغییر ساعت

تیم ملی کاراته دختران ناشنوا تنها سه روز پس از پایان اردوی قبلی، بار دیگر تمرینات آمادهسازی خود را آغاز کرد. این اردو در مسیر

تیم ملی پاراتیروکمان کشورمان پیش از شروع مسابقات قهرمانی جهان، تمرینات خود را در محل برگزاری رقابتها در کره جنوبی انجام داد. این مسابقات از

اردوی آمادهسازی تیم ملی بوچیا جوانان (بانوان و آقایان) از پنجم مهرماه در مشهد مقدس آغاز شد و تا دوازدهم همین ماه ادامه خواهد داشت.

امروز، در روز جهانی صلح، ما در جهانی زندگی میکنیم که به نظر همزمان دو حقیقت متضاد را در آغوش گرفته است. از یک سو،

گزارشها نشان میدهد که میزان تجرد قطعی در ایران روندی صعودی دارد و این موضوع به عنوان یک زنگ خطر جدی برای آینده جمعیتی کشور

با کاهش ساعات روز در فصلهای پاییز و زمستان، بدن انسان تولید کمتری از ویتامین D دارد. این کمبود میتواند به خستگی، افت خلقوخو و

مطلب منتشر شده در «چیدانه» به بازسازی فضاهای خانگی و شهری توسط جوانان نسل Z میپردازد و نشان میدهد چگونه این نسل با خلاقیت، نوآوری

سوختگی با آب جوش یکی از شایعترین حوادث خانگی است که بسته به شدت آن، میتواند از یک آسیب سطحی تا جراحت جدی متغیر باشد.

عزت نفس یکی از پایههای اصلی سلامت روان و موفقیت دختران است. دخترانی که احساس ارزشمندی و خودباوری بیشتری دارند، با اعتمادبهنفس بالاتری با چالشهای

پژوهشها نشان میدهد چند عادت ساده صبحگاهی میتواند به حفظ سلامت استخوانها و کاهش خطر پوکی استخوان کمک کند:✔️ نوشیدن یک لیوان آب پس از

ابوالفضل ظریفپور فردا به مصاف حریفان خود می رود ملی پوش پاراشنا کشورمان در رقابتهای قهرمانی جهان فردا به آب می زند. به گزارش پایگاه

روز چهارشنبه ۲۶ شهریورماه ۱۴۰۴، اداره سلامت معاونت اجتماعی و فرهنگی منطقه ۱۸ با هدف فعالسازی کارگروههای کانون افراد دارای معلولیت، نشستی در مجتمع بهزیستی

از روز شنبه ۲۹ شهریور ۱۴۰۴، فاز دوم مرحله چهارم طرح کالابرگ الکترونیکی به اجرا درآمد. در این مرحله، سرپرستان خانوار در دهکهای چهارم تا

محمد جهانشاهی، دبیر کمیته ملی طبیعتگردی و گردشگری سبز، در گفتوگو با میراثباشی از طرحی بنیادین برای ارتقای کیفیت اردوهای دانشآموزی خبر داد. او با

محققان میگویند پنج حس کلاسیک برای انسان کافی نیست و بر اساس یک مدل ریاضی تازه، حافظه زمانی به بیشترین ظرفیت خود میرسد که انسان

دوازدهمین دورهی رقابتهای #پارادو و میدانی قهرمانی جهان با حضور بیش از هزار ورزشکار از شنبه پنجم مهرماه آغاز میشود. به گزارش پایگاه خبری پهنه

اعضای تیم ملی تیراندازی مردان و زنان در هر دو بخش تپانچه و تفنگ، تمرینات آماده سازی خود برای شرکت در بازی های المپیک را

پژوهشی که در نشریه معتبر Nature منتشر شده نشان میدهد دارویی به نام CX546 میتواند پس از آسیب نخاعی، فعالیت سلولهای بنیادی عصبی-اپاندیمی (epNSPCها) را

تیم ملی بسکتبال با ویلچر 3 نفره بانوان آماده بازی های پاراآسیایی جوانان امارات می شود. به گزارش پایگاه خبری پهنه پرواز به نقل از

جشنواره بینالمللی فیلم پرواز، در پی گفتگوی اخیر فتانه امیری، رئیس جشنواره با رئیس یکی از جشنواره های جهانی قدم اول برای ایجاد همکاریهای بینالمللی

کتاب «Journal of the British Embassy to Persia» نوشته ویلیام پرایس که در سال ۱۸۳۲ میلادی (۱۲۱۱ هجری قمری) در لندن منتشر شد، یکی از

به مناسبت روز شعر و ادب فارسی که همزمان با بزرگداشت استاد شهریار برگزار میشود، فرصتی فراهم شده تا نگاهی دوباره به تاریخ و مسیر

رنگها تنها بخشی از زیبایی بصری نیستند؛ آنها میتوانند به طور مستقیم بر احساسات، انرژی و حتی کارایی ذهنی ما اثر بگذارند. روانشناسی رنگها نشان

عبدالحسین زرینکوب، ادیب، تاریخنگار، نویسنده و منتقد برجسته ایرانی، در ۲۴ شهریور ۱۳۷۸ چشم از جهان فروبست؛ اما نام و آثارش همچنان در ادبیات و

ماه در یک روند آهسته اما مداوم در حال دور شدن از زمین است. به گفته دکتر استفن دیکربی، فیزیکدان و منجم دانشگاه ایالتی میشیگان،

ظروف تفلون به دلیل خاصیت نچسب بودنشان سالهاست جایگاه ویژهای در آشپزخانهها دارند. اما همین ظروف زمانی که خش برمیدارند، میتوانند به تهدیدی جدی برای

نه گفتن یکی از مهمترین مهارتهای زندگی است. مهارتی که اگر آن را یاد بگیریم، نه تنها از فشارها و تعهدات اضافی رها میشویم، بلکه

تیم ملی پاراتیروکمان کشورمان صبح امروز برای حضور در مسابقات قهرمانی جهان ۲۰۲۵ راهی کرهجنوبی شد. ملیپوشان اعزامی ایران در این رقابتها عبارتند از: فاطمه

به گفته سرمربی تیم ملی بدمینتون دختران ناشنوا، دعوت از بدمینتون بازان شنوا به اردوهای آتی تنها نماینده اعزامی ایران به المپیک ناشنوایان، در برنامه

ملی پوشان بسکتبال با ویلچر کشورمان در تورنمنت ترکیه برابر تیم لهستان به پیروزی رسیدند. به گزارش پایگاه خبری پهنه پرواز به نقل از روابط

کسب مقام دوم و سوم پتانک توسط ورزشکاران هیات ورزشهای بیماران خاص استان مرکزی در مسابقات منطقه ای شهرکرد به گزارش پایگاه خبری پهنه پرواز

بسیاری از زبانآموزان وقتی شروع به یادگیری زبان جدید میکنند، به طور ناخودآگاه هر جمله یا عبارت را مستقیماً به فارسی ترجمه میکنند. این عادت

تیم ملی کاراته دختران ناشنوا که خود را برای شرکت در بازیهای المپیک آماده میکند، پس از پشت سر گذاشتن ۱۱ مرحله اردوی آمادهسازی، وارد

تیم ملی پاراشنا کشورمان امروز برای شرکت در مسابقات قهرمانی جهان عازم سنگاپور شد.سینا ضیغمینژاد، ابوالفضل ظریفپور و محمدحسین کریمی سه ورزشکار شایسته ایران هستند

ثمینه باغچهبان، نویسنده و فرزند جبار باغچهبان، بنیانگذار نخستین کودکستان و مدرسه ویژه ناشنوایان ایران، در ۹۷ سالگی درگذشت. به گزارش ایسنا، نوشآفرین انصاری، دبیر

در بیشتر نقشههای جهان، جهت شمال در بالای صفحه قرار دارد. این استاندارد، با وجود اینکه هیچ قاعده طبیعی برای آن وجود ندارد، به تدریج

در نخستین کنگره بینالمللی تروما که بهصورت آنلاین برگزار شد، هاشم قادری، رئیس این کنگره، با اشاره به یافتههای پژوهشی، اعلام کرد که بیش از

مراسم پاسداشت هنرمندان پیشکسوت و گرامیداشت سیزدهمین سالگرد تأسیس مؤسسه هنرمندان پیشکسوت، شامگاه سهشنبه ۲۵ شهریور ۱۴۰۴ در هتل پارسیان انقلاب تهران برگزار شد. این

مطالعهای تازه از سازمان نایتلاین فرانسه نشان میدهد مشکلات سلامت روان در میان دانشجویان اروپایی به شدت افزایش یافته است. این گزارش که بر پایه

امید جهان، خواننده و آهنگساز محبوب موسیقی پاپ و محلی ایران، در ۴۴ سالگی بر اثر سکته قلبی درگذشت. او فرزند محمود جهان، هنرمند نامدار

جوش سر سیاه یکی از رایجترین مشکلات پوستی است که بیشتر روی بینی، پیشانی و چانه دیده میشود. علت آن تجمع سبوم (چربی طبیعی پوست)

سوزندوزی زنان استان سیستان و بلوچستان هنری است که ریشههایش در عمق تاریخ این سرزمین کهن جای گرفته و از زمان کودکی جزئی از زندگی

تعویض بهموقع مسواک نقش مهمی در سلامت دهان و دندان دارد. توصیه کارشناسان این است که هر ۳ تا ۴ ماه یکبار مسواک خود را

رئیس سازمان پژوهش و برنامهریزی آموزشی از اجرای طرحی جدید برای تقویت مهارت خوشنویسی دانشآموزان خبر داد. در این طرح، کتاب «خط تحریری» بهصورت آزمایشی

دوران نوجوانی یکی از حساسترین مراحل زندگی است که با تغییرات رفتاری، احساسی و ذهنی زیادی همراه میشود. در این دوران بسیاری از والدین متوجه

یارانه نقدی مرحله ۱۷۵ مربوط به شهریورماه ١٤٠٤ به حساب سرپرستان خانوارهای دهکهای اول تا سوم در سراسر کشور واریز شد و هماکنون قابل برداشت

نمایشگاه ویژهی «قدرت ورزش، اهداف توسعه پایدار و همکاریهای بینالمللی؛ آیندهای متصل با آیچی-ناگویا ۲۰۲۶» از امروز ٢۵ شهریور آغاز شد. به گزارش پایگاه خبری

افکار منفی معمولاً زمانی سراغمان میآیند که آسیبپذیرتر هستیم؛ نیمهشبها یا هنگام روز که ذهن خسته است. این افکار میتوانند انرژیمان را ببلعند، وضوح فکری

امواج غولآسا یا «سرکش» سالها برای دریانوردان به شکل افسانهای ترسناک مطرح بودند، اما پژوهشهای جدید نشان دادهاند که این پدیده توضیح علمی روشنی دارد.

کتابخوانی تنها راهی برای سرگرمی و گذراندن وقت نیست؛ بلکه بهعنوان ابزاری قدرتمند میتواند ذهن نوجوانان را برای تحلیل بهتر و تصمیمگیریهای آگاهانهتر آماده کند.فواید

رمان باران تابستان اثر مارگریت دوراس، روایت زندگی خانوادهای فقیر و حاشیهنشین است که با تکیه بر قدرت کتابها و خاطره درختی تنومند به معنا

دکتر جواد نظری، رئیس دانشگاه علوم پزشکی اراک، از جایگاه برجسته استان مرکزی در ارائه خدمات بیمهای به بیماران خاص و صعبالعلاج خبر داد و

دکتر فتحالله توسلی، نماینده مردم بهار و کبودرآهنگ در مجلس شورای اسلامی، با حکم رئیس فدراسیون ورزشهای ناشنوایان بهعنوان حامی و سفیر ورزش ناشنوایان ایران

در جریان سفر سید محمد پولادگر، نایبرییس کمیته ملی پارالمپیک، به همراه مسعود اشرفی مسئول طرح توسعه فکری جنبش پارالمپیک به امارات، دیدارها و نشستهای

اردوی آمادهسازی تیم ملی پاراوزنهبرداری بانوان در دو ردهی جوانان و بزرگسالان از ۲۷ شهریور تا ۱۲ مهرماه در کمپ تیمهای ملی فدراسیون ورزشهای جانبازان

سید محمد پولادگر رییس پیشین فدراسیون تکواندو ایران و نایب رییس،کمیته ملی پارالمپیک، با حکم سانگ جین کیم رییس اتحادیه تکواندو آسیا (ATU) به عنوان

محققان دانشگاه استنفورد در مطالعهای نوین دریافتهاند که افزایش فعالیت در ناحیهای مشخص از مغز به نام هسته رتیکولار تالاموس میتواند باعث بروز رفتارهای مرتبط

در مقالهای که در خبرآنلاین منتشر شده است، به بررسی تفاوتهای میان خال گوشتی و زگیل پرداخته شده است. این دو ضایعه پوستی از نظر

پژوهشگران ژاپنی در حال توسعه دارویی هستند که میتواند رشد دندانهای از دسترفته در انسان را تحریک کند. این دارو با مسدود کردن پروتئینی به

خانهتکانی شهریور، بهعنوان یک سنت دیرینه، نه تنها برای استقبال از فصل پاییز بلکه بهعنوان یک اقدام بهداشتی و روانشناختی مهم در نظر گرفته میشود.

همه ما تجربه کردهایم که بعضی افراد بدون تلاش زیاد، در هر جمعی توجهها را به خود جلب میکنند. آنها لزوماً زیباترین یا ثروتمندترین نیستند،

ستاد توسعه علوم و فناوریهای شناختی با اختصاص ۸۲۰ میلیارد ریال از پروژه توسعه فناوری «تحریک عمقی مغز» برای درمان بیماری پارکینسون حمایت میکند. این

شادی در ایران امروز تنها یک تجربه شخصی یا تفریحی نیست، بلکه میتوان آن را نوعی «فناوری اجتماعی» دانست؛ ابزاری که امید و نشاط را

با شروع فصل پاییز، بسیاری از افراد دچار خوابآلودگی، خستگی و بیحوصلگی میشوند. کوتاه شدن روزها، کاهش نور خورشید و سرد شدن هوا باعث تغییراتی

جوش واژن یکی از مشکلات شایع زنان است که معمولاً بهصورت برآمدگیهای کوچک یا بزرگ، قرمز، دردناک یا چرکی در ناحیه تناسلی دیده میشود. این

رئیس کل سازمان نظام پزشکی ایران، محمد رئیسزاده، با هشدار نسبت به بحران کمبود پزشک متخصص در کشور، تأکید کرد که سیاستهای نادرست در حوزه

یک کارشناس صنعت اسباببازی تأکید کرد بهجای تمرکز صرف بر مشکلات اقتصادی و خروج ارز، بهتر است از تجربه موفق عروسک «لبوبو» درس گرفت تا

پژوهشی تازه نشان میدهد مصرف منظم شیرینکنندههای مصنوعی و کمکالری مانند آسپارتام، ساخارین، آسهسولفام K، اریتریتول، سوربیتول و زایلیتول میتواند با افت تواناییهای شناختی مغز

کلسترول بالای خون بهویژه افزایش کلسترول بد (LDL) یکی از عوامل اصلی بروز بیماریهای قلبی و عروقی است. با این حال، تغییرات ساده در سبک

جوش کمر یکی از مشکلات پوستی شایع در میان مردان و زنان است که میتواند دلایل مختلفی داشته باشد. مهمترین علتها شامل تغییرات هورمونی مانند

پیری فرآیندی طبیعی است اما برخی خوراکیها میتوانند سرعت آن را بیشتر کنند. بر اساس گزارش ایسنا، مصرف مداوم برخی مواد غذایی موجب افزایش التهاب،

نشست فصلی دبیران کانون افراد دارای معلولیت مناطق ۲۲گانه شهرداری تهران به میزبانی اداره سلامت منطقه ۲۲ برگزار شد. این نشست با محوریت بررسی شیوهنامه

رییس فدراسیون تنیس روی میز از اردوی آماده سازی تیم ملی تنیس روی میز ناشنوایان بازدید کرد به گزارش پایگاه خبری پهنه پرواز به نقل

وقتی از تجریش به سمت قلۀ توچال میرویم، در میدان سربندِ محله دربند تهران، تندیسی از یک کوهنورد دیده میشود که یادگار و افتخاری برای

اردوی تیم ملی دوومیدانی جانبازان و توان یابان در کمپ تیم های ملی فدراسیون برگزار می شود. به گزارش پایگاه خبری پهنه پرواز به نقل

نشست کمیسیون پزشکی آکادمی ملی پارالمپیک با حضور مسئولین آکادمی و نمایندگان فدراسیون های همکار برگزار شد. به گزارش پایگاه خبری پهنه پرواز به نقل

سینما، آن هنر جاودان که با نوری سحرآمیز بر پرده سفید، رویاها را جان میبخشد و داستانها را از دل انسانها به قلب جهان منتقل

طبق گزارش جدید زومیت، گوشیهای گوگل پیکسل در نیمه اول سال ۲۰۲۵ سریعترین رشد را در میان برندهای پریمیوم تجربه کردهاند. دادههای مؤسسه کانترپوینت نشان

نوشتن به زبان فارسی مؤثر و گیرا نیازمند رعایت نکاتی کلیدی است که میتواند نوشتار را روشنتر، خواندنیتر و تأثیرگذار کند. در ادامه به تعدادی

از اسفند ۱۴۰۳، پرداخت مستمری مددجویان تحت پوشش سازمان بهزیستی و کمیته امداد بهصورت منظم در روز بیستم هر ماه انجام میشود. همچنین طبق اعلام

خودآزاری رفتاری پیچیده و اغلب نتیجه مشکلات روانی مانند افسردگی، اضطراب یا ناتوانی در تنظیم احساسات است. پژوهشهای تازه نشان میدهد که ترکیب درمانهای روانشناختی،

ریزهخواری به مصرف بیبرنامه و پراکنده خوراکیهای کوچک بین وعدههای اصلی گفته میشود. این رفتار معمولاً به دلیل نداشتن برنامه غذایی مشخص، وجود خوراکیهای وسوسهبرانگیز

در شروع هر سال تحصیلی، یکی از مهمترین دغدغههای معلمان، ایجاد محیطی عادلانه و کارآمد برای یادگیری است. توجه به تفاوتهای فردی دانشآموزان نه تنها

گیلان در روزهای پایانی تابستان ۱۴۰۴ شاهد موج بیسابقهای از ورود گردشگران بود. طبق اعلام یوسف سلمانخواه سرپرست ادارهکل میراثفرهنگی، گردشگری و صنایعدستی استان، از

ادبیات آسیای شرقی با سبک خاص و داستانهای عمیق، جهانی متفاوت از فرهنگ، فلسفه و زندگی روزمره ارائه میدهد. در ادامه، پنج رمان برتر که

کتابخوانی با کودکان بازمانده از تحصیل نیازمند صبر، خلاقیت و انعطافپذیری است. هدف این است که کودک احساس کند خواندن یک تجربه لذتبخش و قابل

پنیر یکی از پرمصرفترین مواد غذایی در جهان است و علاوه بر طعم و ارزش غذایی، نقش مهمی در سلامت روده و میکروبیوم ایفا میکند.

متدولوژی کراسفیت با رویکرد علمی و ساختار مقیاسپذیر خود، تحولی جدی در حوزه تناسب اندام و سلامت ایجاد کرده است. این برنامه نه تنها افراد

امروزه بخش بزرگی از زندگی انسانها به فضای مجازی گره خورده است. کودکان نیز از همان سالهای ابتدایی زندگی، چه با حضور مستقیم در شبکههای

وارن تیرنی، روانشناس ایرلندی، مدتی طولانی با علائمی مثل گلودرد شدید، دشواری در بلع و درد مداوم روبهرو بود. او برای اطمینان، به چتجیپیتی مراجعه

یکی از مهمترین چالشهای کلاسهای درس، مدیریت تفاوتهای فردی دانشآموزان است؛ موضوعی که اگر به درستی انجام شود، میتواند کیفیت یادگیری و فضای عاطفی کلاس

پنجمین مرحله اردوی آماده سازی تیم ملی فوتبال ناشنوایان برای حضور در بازی های المپیک ۲۰۲۵ با حضور ۲۲ بازیکن برگزار می شود. به گزارش

مدیرعامل شرکت فناوری بنیاختههای رویان از آغاز ارائه خدمات درمانی به بیماران مبتلا به آرتروز شدید با استفاده از «وارتوسل»، نخستین فراورده سلولی مشتق از

برنامه های آماده سازی تیم ملی کاراته دختران برای حضور در بازی های المپیک ناشنوایان وارد یازدهمین مرحله اردو شد. به گزارش روابط عمومی فدراسیون

مستمری شهریور ماه 1404 #مددجویان تحت پوشش #سازمان بهزیستی به #حسابکارت بانک رفاه این عزیزان #واریز گردید 💵 1نفره: 1/400/000 تومان💵 2نفره: 1/990/000 تومان💵 3نفره:

دکتر کارگری: سند تحول بنیادین چراغ راه پارالمپیک ایران است کارگاه آموزشی تفکر استراتژیک و سند تحول کمیته ملی پارالمپیک، امروز، ویژهی مدیران و کارشناسان

وقتی محدودیتها به زندگی وارد میشوند، خیلیها تصور میکنند مسیر موفقیت بسته است. اما انسانهایی هستند که محدودیت را به فرصت تبدیل میکنند. سارا رضایی،

آزمونها همواره بخش مهمی از مسیر تحصیلی و حرفهای افراد در سراسر جهان بودهاند. برخی از این آزمونها به دلیل سطح بالای دشواری، رقابت شدید

خط هیروگلیف، سیستم نوشتاری پیچیدهای بود که مصریان باستان برای ثبت وقایع مذهبی، تاریخی و روزمره خود استفاده میکردند. این خط که بر روی دیوارهای

کورتیزول که به هورمون استرس معروف است، نقش مهمی در واکنش بدن به فشارهای روانی و شرایط هیجانی دارد. این هورمون توسط غدد فوقکلیوی ترشح

گزارشها نشان میدهد که تعدادی از رواندرمانگران در جلسات درمانی بدون اطلاع بیماران خود از ابزارهایی مانند ChatGPT استفاده کردهاند؛ اقدامی که موجی از خشم

بیماری کبد چرب غیرالکلی (NAFLD) یکی از شایعترین اختلالات کبدی است که معمولاً در مراحل اولیه بیعلامت است. با این حال، برخی نشانهها ممکن است

مرکز روابط عمومی و امور بینالملل وزارت تعاون، کار و رفاه اجتماعی، جزئیات نحوه استفاده و زمانبندی مراجعه سرپرستان خانوار برای دریافت اقلام مرحله چهارم

حجت شکیبا، نقاش برجسته و از چهرههای ماندگار هایپررئالیسم در ایران که سالها در کنار علی حاتمی در پروژههای سینمایی همکاری داشت، این روزها گزیدهای

کمیته جهانی #پاراوزنه_برداری IPC، امروز هفدهم شهریور، با انتشار ویدئویی به مروری بر حضور و قهرمانی علیاکبر غریبشاهی و احمد امینزاده در سنگینوزن و فوقسنگین

به گزارش پایگاه خبری پهنه پرواز به نقل از روابط عمومی فدراسیون ورزشهای ناشنوایان و به نقل از هیات ورزشهای ناشنوایان استان تهران، سومین دوره

معاون رئیسجمهور در امور زنان و خانواده در دیدار اعضای هیات رئیسه کمیته ملی پارالمپیک با قدردانی از تلاشهای قهرمانان پارالمپیک تأکید کرد که دولت

شیاف پروژسترون یک داروی هورمونی است که معمولاً برای حمایت از بارداری، درمان اختلالات قاعدگی، نازایی و هورموندرمانی جایگزین استفاده میشود. این دارو میتواند بهصورت

بیش از یک میلیارد نفر در جهان، معادل ۱۵٪ جمعیت، با نوعی از معلولیت زندگی میکنند. دوران همهگیری کرونا نشان داد که دسترسی دیجیتال تا

اعضای تیم ملی تیراندازی مردان و زنان در دو بخش تپانچه و تفنگ تمرینات خود را برای حضور در بازی های المپیک در قالب ششمین

نویسنده : دکتر دیمیتریوس تساتیرس دکتر دیمیتریوس تساتیرس (Dimitrios Tsatiris) روانپزشک و استاد بالینی روانپزشکی در دانشگاه علوم پزشکی شمالشرقی اوهایو است. او متخصص در

بسیاری از تصمیمات پرهزینه و مخرب در ایران، از تخصیص نادرست منابع تا سیاستهای ارزی اشتباه، ریشه در دادههای غلط و مشاورههای غیرعلمی دارد. اینجا

ادرار کردن زیر دوش حمام برای بسیاری از افراد کاری طبیعی و حتی بهظاهر بهداشتی به نظر میرسد. برخی آن را راهی برای صرفهجویی در

تبادل پین یا نمادهای ویژه کشورهای شرکت کننده در بازی های پارالمپیک از حاشیه های جذاب این رویداد بزرگ است. به گزارش پایگاه خبری پهنه

در نشست مشترک وزرای ورزش و جوانان، آموزش و پرورش و رؤسای فدراسیونهای ورزشی، بر لزوم همکاری سهجانبه میان وزارتخانههای ورزش، آموزش و پرورش و

با وجود پیشرفتهای روزافزون شبکههای مخابراتی، هنوز هم بسیاری از کاربران در شرایط خاص با مشکل ضعف سیگنال مواجه میشوند؛ مسئلهای که میتواند در مواقع

آموزش احترام به بدن، مرزهای شخصی و توانایی «نه گفتن» به کودکان، یک ضرورت تربیتی و روانشناختی است. این آموزشها باید از سنین پایین آغاز

اخیراً پژوهشهایی نشان دادهاند که مدلهای هوش مصنوعی مانند ChatGPT و Gemini ممکن است به پرسشهای حساس و خطرناک، نظیر روشهای خودکشی، پاسخهایی ارائه دهند

بیاحترامی در زندگی مشترک میتواند آسیبهای جدی به رابطه وارد کند و زمینهساز مشکلات روانی و تربیتی برای فرزندان شود. این رفتار نه تنها اعتماد

دریاچه جوربند یکی از جاذبههای طبیعی کمتر شناختهشده استان مازندران است که در نزدیکی شهرستان نور قرار دارد. این دریاچه در روستای جوربند واقع شده

شناخت و اصلاح رفتارهایی مانند خودمحوری، اجتناب از تصمیمات دشوار و منفیگرایی، نخستین گام برای تبدیل شدن به یک مدیر موفق و الهامبخش است. ویژگی

در عصر دیجیتال، فناوریهای ارتباطی زندگی ما را احاطه کرده و امکان برقراری ارتباط لحظهای با دیگران را فراهم میکنند. با این حال، تحقیقات نشان

التهاب یکی از عوامل مهم در بروز بسیاری از بیماریهای مزمن از جمله مشکلات رودهای است. متخصصان تغذیه میگویند رژیم غذایی سالم و سرشار از

تمرینات ملی پوشان تیم #پاراشنا برای حضور در مسابقات قهرمانی جهان سنگاپور از امروز ۱۵ شهریور ماه آغاز شد. به گزارش پایگاه خبری پهنه پرواز

انجمن شطرنج فدراسیون ورزش های جانبازان و توان یابان دونین دوره مسابقات آنلاین این رشته را برگزار کرد. به گزارش پایگاه خبری پهنه پرواز به

سومین المپیاد و پارالمپیاد استعدادهای برتر ورزش تهران در خانه والیبال افتتاح شد به گزارش پایگاه خبری پهنه پرواز به نقل از روابط عمومی فدراسیون

دوران یائسگی با تغییرات هورمونی همراه است و میتواند علائمی مانند گرگرفتگی، تعریق شبانه، خشکی واژن و مشکلات خواب را ایجاد کند. هورموندرمانی یکی از

در دنیای پر از فشارها و انتظارات، هنر رها کردن یکی از مؤثرترین روشها برای کاهش استرس و دستیابی به آرامش درونی است. رها کردن

در دنیای پرمشغله امروز، تقویت تمرکز و حافظه اهمیت ویژهای دارد. با رعایت برخی عادات و تمرینهای ساده میتوان عملکرد ذهن را بهبود بخشید و

دریاچه ولشت چالوس، یکی از جواهرهای پنهان طبیعت ایران، در شمال غربی استان مازندران و نزدیکی شهر چالوس واقع شده است. این دریاچه کوهستانی با

مدیریت زمان یکی از بزرگترین چالشهای صاحبان کسبوکارهای درمانی است. وظایف روزمره گاه آنقدر زمانبر و خستهکننده میشوند که فرصت تمرکز بر رشد و توسعه

با افزایش احتمال فعالسازی مکانیسم ماشه، بار دیگر اقتصاد ایران در کانون توجه قرار گرفته است. این سازوکار که ذیل قطعنامه ۲۲۳۱ شورای امنیت و

راهآهنها فقط مسیرهایی برای جابهجایی مسافر و کالا نیستند؛ برخی از آنها بهقدری اهمیت تاریخی و مهندسی دارند که در فهرست میراث جهانی یونسکو جای

پیادهروی یکی از سادهترین و در عین حال مؤثرترین فعالیتهای ورزشی برای حفظ سلامتی است. بسیاری از ما شنیدهایم که باید روزانه ۱۰ هزار قدم

رئیس فدراسیون ورزش های ناشنوایان ضمن ارائه گزارشی از اقدامات صورت گرفته در این فدراسیون بر کسب مدال طلا در بازی های المپیک ژاپن تاکید

وزیر ورزش و جوانان گفت: نگرش ما در موضوع قهرمانی این است که بتوانیم اقتدار ورزش کشور را در عرصههای جهانی نشان دهیم. یکی از

۶ شهریور ۱۴۰۴ – خبر آنلاین – فاطمه علمدار، جامعهشناس، در نشست «زندگی و جنگ» به بررسی تأثیر جنگ بر زندگی فردی و اجتماعی پرداخت

۱۲ شهریور ۱۴۰۴ – زومیت – رویداد «حال کار» با محوریت تابآوری و چابکی سازمانی در سالن خیریه رعد برگزار شد. این رویداد که به

خبرفوری – ۱۴ شهریور ۱۴۰۴ – در سالهای اخیر فشار اجتماعی برای بلندقد بودن در میان نوجوانان شدت گرفته و بسیاری از آنها برای رسیدن

اصفهان – ایرنا – سید جواد حسینی، معاون وزیر و رئیس سازمان بهزیستی کشور، اعلام کرد که پس از ۱۲ سال تلاش و برنامهریزی، چهار

ساییدگی زانو یکی از مشکلات شایع مفصلی است که میتواند باعث درد، محدودیت حرکت و کاهش کیفیت زندگی شود. درمان این مشکل تنها به دارو

مراسم اهدای مدال اولین روز از رقابتهای قهرمانی کشور پاراشنا با نظارت کمیته بین المللی پارالمپیک به گزارش پایگاه خبری پهنه پرواز ۲۱۴ ورزشکار از

چهارمین مرحله اردوی آماده سازی تیم ملی تکواندو دختران برای حضور در بازی های المپیک ناشنوایان با حضور چهار ورزشکار اعزامی به این بازی ها

به گزارش پایگاه خبری پهنه پرواز به نقل از روابط عمومی سازمان بهزیستی کشور در راستای تفاهم نامه منعقده فی ما بین سازمان بهزیستی کشور

هدفونهای Neurable با حسگر EEG و هوش مصنوعی، وضعیت مغز و تمرکز شما را بررسی کرده و به پیشگیری از بیماریهای مغزی کمک میکنند.معرفی هدفونهای

چیپس سیبزمینی میتواند سلامت شما را تهدید کند. از رادیواکتیویته و روغنهای مضر گرفته تا بیماریهای قلبی و سرطان، همه چیز درباره مضرات مصرف چیپس

در نخستین سالگرد بازیهای پارالمپیک ۲۰۲۴ پاریس، تصویر مرتضی مهرزاد، ملیپوش تیم والیبال نشسته ایران، در میان ۱۵ عکس برتر این رویداد بزرگ ورزشی قرار

متاتوضیح (Meta Description):سرطان مثانه چیست؟ علائم شایع، عوامل خطر، روشهای تشخیص و درمان سرطان مثانه را به صورت کامل و جامع بخوانید و از نکات

دریاچه نئور، یکی از زیباترین جاذبههای طبیعی استان اردبیل است که در ارتفاعات کوههای تالش قرار دارد. این دریاچه با چشماندازی بینظیر، آبوهوای خنک و

صدای مفاصل هنگام حرکت ممکن است طبیعی باشد، اما در بسیاری از مواقع میتواند نشانهای از ضعف استخوانها یا مشکل در بافت همبند باشد. یکی

گرفتگی رگ قلب چیست؟ گرفتگی رگ قلب یکی از شایعترین بیماریهای قلبی است که میتواند در هر سنی حتی در جوانان بروز کند. سبک زندگی

به گزارش روابطعمومی فدراسیون ورزشهای ناشنوایان، نخستین جلسه هماهنگی برای اجرای طرح ملی استعدادیابی دوومیدانی بانوان ناشنوا به مناسبت هفته جهانی ناشنوایان، به صورت وبیناری

ملی پوشان جوان تیم #پاراشنا دور جدید تمرینات خود را به میزبانی تبریز آغاز می کنند. به گزارش پایگاه خبری پهنه پرواز به نقل از

رقابت های هفته دوم مسابقات لیگ حرفه ای تیراندازی جانبازان و توان یابان در سالن فدراسیون برگزار شد. به گزارش پایگاه خبری پهنه پرواز به

عرق کردن فرایندی طبیعی برای تنظیم دمای بدن است، اما وقتی تعریق در نواحی قابل مشاهده مانند سر و صورت بیش از حد رخ دهد،

ایلان ماسک در تازهترین اقدام نوآورانه خود از پروژهای به نام Blindsight رونمایی کرده است؛ فناوریای که به گفته او میتواند بینایی را به افراد

رویکرد جدی کمیته ملی پارالمپیک در پاراآسیایی جوانان؛ سرمایهگذاری برای لسآنجلس ۲۰۲۸ و ناگویا ۲۰۲۶ نشست هماهنگی بازی های پاراآسیایی جوانان ۲۰۲۵ دوبی به ریاست

با برگزاری مجمع انتخاباتی هیئت ورزش های جانبازان و توان یابان استان مرکزی، نصیری به عنوان رئیس این هیئت انتخاب شد. به گزارش پایگاه خبری

مصطفی لهسایی یکی از مربیان متعهد و تاثیرگذار کشتی ایران است که با صبوری، تخصص و ایمان قلبی به تواناییهای کشتیگیران ناشنوا، توانسته مسیری روشن

سما شهبازی، دانشجوی کارشناسی مهندسی عمران و ورزشکار با استعداد کشور، توانسته است علیرغم محدودیتها و کمبود امکانات، در رشته کاشت حلزون به موفقیتهای چشمگیری

آنجلو کاسیمیرو، نوجوان ۱۵ ساله اهل فیلیپین، موفق شد با استفاده از یک جفت کفش، انرژی برق تولید کند. نه بهصورت استعاری، بلکه واقعی! اختراع

نویسنده : فرلی لجروود رشد و بلوغ در دوران پیری میتواند با آرامش و رضایت همراه باشد، اما برخی عادات میتوانند این روند را مختل

انسان موجودی است که برداشتها و قضاوتهای دیگران درباره او، بر پایه حواس و رفتارهایش شکل میگیرد. مثلث نور، صوت و حس، اساس درک ما

امروزه رسانههای اجتماعی بخش جداییناپذیر زندگی کودکان و نوجوانان شدهاند. با این حال، حضور در این فضا بدون آگاهی و نظارت میتواند خطرهایی جدی برای

پوکیاستخوان یکی از شایعترین مشکلات دوران سالمندی است که خطر زمینخوردگی و شکستگی استخوانها را افزایش میدهد. متأسفانه هنوز باور غلطی وجود دارد که سالمندان

بسیاری از فیلسوفان و روانشناسان بر این باورند که تجربه سختیهای کوچک و خودخواسته میتواند همانند واکسنی برای ذهن عمل کند. در این روش، فرد

تصور کنید تنها با تغییر محل زندگی، بدون خرید کفش ورزشی یا ثبتنام در باشگاه، بتوانید روزانه هزار قدم بیشتر راه بروید. تحقیقات جدید نشان

سرمربی تیم ملی تنیس روی میز با تاکید بر اینکه این رشته با تیم کامل در بازی های المپیک شرکت نمی کند، گفت که صعود

هفته دوم مسابقات لیگ حرفهای پاراتیراندازی بزرگداشت مقام شهدا و جانبازان دفاع مقدس ۱۲ روزه در سالن فدراسیون برگزار شد. به گزارش پایگاه خبری پهنه

مدال رسمی مسابقات قهرمانی جهان #پاراشنا – سنگاپور ۲۰۲۵ با طراحی آلوشیوس گان، ملیپوش بوچیای سنگاپور رونمایی شد. به گزارش پایگاه خبری پهنه پرواز به

نویسنده : روح ا.. قطبی از مهمترین یادگارهای معماری ایرانی، کاروانسراها هستند که ایرانیان در پیدایی و موجودیت آن، پیشقدم بودند و به گفته هردوت،

رئیس مرکز رشد دانشگاه علوم پزشکی تهران با اشاره به چالشهای صنعت داروسازی کشور، پدیدهی «انبارهای پُر و قفسههای خالی» را یکی از معماهای اصلی

پژوهشهای جدید در حوزه علوم اعصاب نشان میدهد که خاطرات انسان مانند فیلم ضبطشده در مغز ذخیره و بازپخش نمیشوند، بلکه هر بار هنگام یادآوری،

نشست تخصصی «عصر داستان» با حضور الهام فلاح، نویسنده و مدرس داستاننویسی، چهارشنبه گذشته در مؤسسه آفرینشهای هنری آستان قدس رضوی در مشهد برگزار شد.

ایمونوتراپی یا ایمنیدرمانی، یکی از پیشرفتهترین روشهای درمانی است که با هدف تقویت سیستم ایمنی بدن، توانایی شناسایی و نابودی سلولهای سرطانی را افزایش میدهد.

بررسی برنامه راهبردی رشته پاراتنیس روی میز/ اهدای حکم مشاورفنی به هادی رضایی به گزارش پایگاه خبری پهنه پرواز به نقل از روابط عمومی فدراسیون ورزشهای

نیایشگاه پارس بانو یا پیربانو از مکان های شناخته شده زرتشتیان ایران است و زرتشتیان اعتقاد دارند كه بانویی پاكدامن در آنجا از دست دشمنان

دور جدیدی از تمرینات ملی پوشان جوان تیم #بوچیا برای حضور در بازی های پاراآسیایی جوانان دبی ۲۰۲۵ از فردا دهم شهریور ماه آغاز می

به گزارش پایگاه خبری پهنه پرواز به نقل از روابط عمومی سازمان بهزیستی کشور حق پرستاری خانواده محور مرداد ماه 1404 #معلولان #جسمی حرکتی #شدید

تیم ملی تکواندو ناشنوایان که از شرکت کنندگان در بازی های المپیک است، از روز دوشنبه تمرینات خود را در بخش گیوروگی دنبال می کند و

بادام یکی از مغزهای مغذی و غنی از ویتامینها، پروتئینها و چربیهای سالم است که به تقویت مغز، استخوانها، سیستم ایمنی و تأمین انرژی پایدار

این روزها در شبکههای اجتماعی عباراتی مانند «هورمون قاتل»، «شکم کورتیزولی» یا «علت چاقیهای مکرر» بهطور گسترده دستبهدست میشوند. این شعارها بخشی از کمپینهای بازاریابی

نتایج یک پژوهش تازه نشان میدهد ترکیبی از تمرینهای ورزشی منظم و رفتاردرمانی شناختی (CBT) میتواند روند بهبودی بیماران مبتلا به سندروم قلب شکسته (Takotsubo)

نسل Z بیش از هر نسل دیگری با استرسهای روزانه دست و پنجه نرم میکند؛ فشارهای تحصیلی، نگرانیهای شغلی، وابستگی به شبکههای اجتماعی و حتی

پژوهشهای جدید نشان میدهد بسیاری از واژههای مرتبط با طبیعت در حال ناپدید شدن از زبان هستند. کلماتی مانند «رودخانه»، «چمنزار»، «ساحل»، «منقار» و «شاخه»

استفاده بیش از حد از تلفنهای هوشمند در میان نوجوانان، به یک چالش جدی برای خانوادهها و حتی سلامت روانی نسل جوان تبدیل شده است.

ترکیب دو نفره تیم ملی تنیس روی میز مردان و زنان برای حضور در بازی های المپیک نهایی شد. به گزارش روابط عمومی فدراسیون ورزش

به گزارش پایگاه خبری پهنه پرواز به نقل از روابطعمومی فدراسیون ورزشهای جانبازان و توانیابان، دوره مربیگری درجه ۳ بسکتبال با ویلچر با هدف ارتقای

مهدی اخوانثالث، متخلص به «م. امید»، یکی از برجستهترین شاعران معاصر ایران است که با ترکیب مهارت در قالبهای کلاسیک و نوآوری در فرمهای نوین،

سد میجران در دل جنگلهای جنترودبار و بر روی رودخانه نسارود واقع شده است. این سد خاکی با هسته آسفالتی از سال ۱۳۸۲، نقش مهمی

تحقیقات مشترک دانشگاه بیلهفلد آلمان و دانشگاه وارویک انگلستان نشان میدهد مصرف قهوه در ساعات صبح میتواند خلقوخو را بهطور چشمگیری بهبود دهد و احساس

دکتر عبدالرحیم اسداللهی، عضو هیئت علمی دانشکده بهداشت دانشگاه علوم پزشکی شیراز و متخصص سالمندشناسی، معتقد است سالمندی نشانهای از موفقیت در زندگی است؛ اما

گاهی ذهن ما بهقدری پر از صدا و گفتوگوهای بیپایان میشود که آرامشمان بر هم میریزد. پژوهشهای علمی نشان میدهد با بهکارگیری روشهای مشخص میتوان

دریاچه وان، بزرگترین دریاچه قلیایی جهان در شرق ترکیه، صحنه پدیدهای دیدنی و علمی است؛ جریاناتی شیریرنگ که سطح آب را به نقاشیهای طبیعی تبدیل

معاون امور توانبخشی بهزیستی همدان اعلام کرد که در دولت چهاردهم، بیش از ۳۳ هزار معلول زیر پوشش خدمات این سازمان قرار دارند که از

یک روش نوین جراحی در حوزه بیماریهای زنان معرفی شده که میتواند تحولی اساسی در درمان ایجاد کند. این تکنیک که لاپاراسکوپی از طریق واژن

#حق پرستاری مرداد ماه 1404 افراد #ضایعه نخاعی تحت پوشش #سازمان بهزیستی به #حساب کارت بانک رفاه این عزیزان #واریز گردید 🔻 #کمری🔻 #سینهای🔻 #گردنی

ملی پوشان جوان فدراسیون ورزشهای جانبازان و توانیابان در رشتههای مختلف در این رویداد حضور پیدا خواهند کرد. بازی های پاراآسیایی جوانان دبی ۲۰۲۵ از

دولت با اجرای طرحی حمایتی، حقوق ماهانه ۱۳ میلیون تومانی و پوشش بیمهای ویژه برای زنان خانهدار، دانشجویان و مادران دارای سه فرزند در مناطق

محمدرضا طیبی، پرتابگر وزنه ایران و قهرمان آسیا در این رشته، با قرار گرفتن در رتبه ۳۰ رنکینگ فدراسیون جهانی، موفق به کسب سهمیه حضور

قطع و وصل ناگهانی برق یا نوسانات شدید ولتاژ، از مهمترین دلایل آسیبدیدگی وسایل برقی هستند. بسیاری از لوازم خانگی مدرن مانند یخچال، تلویزیون، کولر،

پرل باک، نویسندهی آمریکایی برنده جایزه نوبل ادبیات، در رمان مشهور خود با نام «مادر» تصویری پررنگ و چندلایه از زندگی زنان در جامعهی سنتی

سازمان بهزیستی کشور اعلام کرد با همکاری دانشگاههای علوم توانبخشی و علامه طباطبایی، طرح آموزش و تربیت ۳ هزار مشاور تخصصی حوزه سالمندان را اجرا

دوران بارداری همراه با تغییرات فراوانی در بدن است، اما یکی از مهمترین مشکلاتی که میتواند مادر و جنین را تهدید کند، کبد چرب در

بازگشت تیم ملی پرافتخار بوچیا از مسابقات بینالمللی قزاقستان تیم ملی بوچیای کشورمان پس از درخشش در رقابتهای بینالمللی قزاقستان و کسب ۷ مدال رنگارنگ،

موفقیت همیشه مسیر آسانی ندارد؛ گاهی در دل محدودیتها و چالشهاست که استعدادها شکوفا میشوند. مهلا سمیعی، ورزشکار پرتوان و پرامید، یکی از چهرههایی است

مطالعات علمی نشان میدهند که آمیگدال، بخشی از مغز مسئول پردازش احساسات، نقش کلیدی در ایجاد و تقویت ترس دارد. آمیگدال با دریافت اطلاعات از

همراه با وعدههای غذایی حاوی چربی: برای بهبود جذب امگا-۳، آن را با وعدههای غذایی حاوی چربیهای سالم مصرف کنید. تقسیم دوز: اگر دچار عوارض

دیرتر ابتلا به بیماریها: مطالعات نشان دادهاند که صدسالهها دیرتر دچار بیماریهایی مانند سکته قلبی میشوند. بهعنوان مثال، تنها ۸ درصد از آنها در سن

محققان توصیه میکنند برای جلوگیری از پوکی استخوان، انجام فعالیتهای خاصی در صبح مؤثر است. این فعالیتها شامل نوشیدن آب برای هیدراتاسیون، مصرف صبحانهای غنی

ایران در حال تبدیل شدن به یک قطب پیشرو در حوزه سلول درمانی در منطقه خاورمیانه و شرق مدیترانه است. این کشور با توسعه مراکز

اعضای تیم های ملی کشتی آزاد و فرنگی به منظور کسب آمادگی بیشتر برای حضور در بازی های المپیک، دومین مرحله اردوی خود را برگزار

خانه حسن پور از بناهای قدیمی شهر اراک است که در مجموعه بافت قدیمی اراک و در اولین گذر سمت چپ بعد از چهارسوق بازار و در مقابل

کمیته بینالمللی پارالمپیک (IPC) در گزارشی پژوهشمحور اعلام کرد که بازیهای پارالمپیک اکنون در جمع شناختهشدهترین رویدادهای ورزشی جهان قرار دارد. به گزارش پایگاه خبری

اولین اردوی آمادهسازی تیم کریکت با ویلچر ایران از ۱ تا ۳ شهریورماه ۱۴۰۴ با حمایت ویژه مصطفی دیندار مهربان، ریاست هیأت ورزشهای جانبازان و

عناب در طب سنتی ایران بهعنوان یک داروی طبیعی شناخته شده که خواص فراوانی برای بدن دارد. این میوه کوچک میتواند به بهبود عملکرد سیستمهای

شخصیت نوع ب با ویژگیهایی مانند آرامش، بیخیالی و آزادمنشی این روزها بیش از پیش مورد توجه قرار گرفته است. در حالی که پژوهشهای علمی

بوی بد دهان یا هالیتوزیس، مشکلی شایع است که میتواند ناشی از عوامل مختلف باشد. خوشبختانه در بسیاری از موارد، با رعایت بهداشت دهان و

در اهواز، روشی نوین درمانی برای بیماران قلبی اجرا شده که امکان درمان بدون نیاز به سفرهای طولانی و پرهزینه به تهران را فراهم کرده

جعفر احمدی در یادداشتی با عنوان «چه خوب شد که دریاچه ارومیه خشک شد» تأکید میکند که این عبارت نه نشانه خوشحالی، بلکه تلنگری تلخ

پنیر یکی از مواد غذایی پرمصرف در سفره صبحانه ایرانیان است. اما همواره این پرسش مطرح بوده که آیا مصرف آن در ابتدای روز برای

نویسنده : سایه قهیه ای رییس هیات ورزشهای بیماران خاص و پیوند اعضا استان مرکزی گفت: گسترش ورزش در میان بیماران خاص و پیوند اعضا

مرحله چهارم اردوی آمادهسازی تیم ملی فوتبال ناشنوایان برای حضور در بازیهای المپیک از ۶ تا ۱۴ شهریور در کمپ تیمهای ملی برگزار میشود. به

پنجمین مرحله اردوی آمادگی تیم ملی والیبال نشسته مردان ایران، در آستانه حضور در مسابقات پاراآسیایی ناگویا، از تاریخ ۶ تا ۱۴ شهریورماه به میزبانی

سه سوارکار تیم ملی المپیک ویژه ایران با درخشش در مسابقات منطقهای مِنا ۲۰۲۵ در العین امارات، توانستند با کسب پنج مقام ارزشمند در رشتههای

موفقیت همیشه در گرو پشتکار و اراده است. گاهی محدودیتها نه تنها مانع رشد نمیشوند، بلکه سکوی پرشی برای رسیدن به قلههای افتخار هستند. «ندا

پیادهروی یکی از سادهترین و کمهزینهترین فعالیتهای ورزشی است که تأثیر قابلتوجهی بر سلامت عمومی و بهویژه بهبود وضعیت قلب و عروق دارد. متخصصان میگویند

هوش هیجانی به معنای توانایی شناخت، مدیریت و بهکارگیری درست احساسات است و نقشی کلیدی در روابط فردی و کاری دارد. کارشناسان برای تقویت این

ابنسینا، حکیم نامدار ایرانی که آثار او در پزشکی، فلسفه و عرفان ماندگار است، نگاهی جامع به انسان داشت و رابطه تنگاتنگ جسم، روح و

کلسترول که معمولاً با بیماریهای قلبی و عروقی شناخته میشود، در واقع نقش بسیار مهمی در سلامت مغز دارد. این ماده بخش مهمی از غشای

در روزی که ورزش معنا و روح تازهای گرفت، ملیپوشان بوچیای کشورمان با ارادهای پولادین و روحیهای تسلیمناپذیر، صحنه رقابتهای بینالمللی قزاقستان را به سکویی

با حکم رئیس فدراسیون؛ علی آبنیکی رئیس انجمن تنیس ناشنوایان شد به گزارش روابط عمومی فدراسیون ورزش های ناشنوایان، با صدور حکمی از سوی مصطفی

در دنیایی که بسیاری محدودیتها را مانع میدانند، کسانی هستند که همان محدودیتها را به سکوی پرتابی برای موفقیت تبدیل میکنند. امیرعلی علیزاده یکی از

کاروانسرای شاه عباسی اراک یکی از یادگارهای ارزشمند دوران صفویه است که در روستای کاروانسرا و در حاشیه رشتهکوههای هفتاد قله واقع شده است. این

حضور منظم سوارکاران ایران در المپیک ویژه منطقه منا ۲۰۲۵ کاروان سوارکاران ایران در مسابقات المپیک ویژه منطقه منا ۲۰۲۵ که به میزبانی امارات برگزار

ملیپوشان ایرانی در رقابتهای بینالمللی بوچیای قزاقستان خوش درخشیدند. فرزانه دلارامی و ندا غایبی با عملکردی تحسینبرانگیز موفق به کسب مدالهای نقره و برنز شدند؛

اعضای تیم اعزامی کاراته دختران به بازی های المپیک ناشنوایان در هر دو بخش کومیته و کاتا به منظور حضور در دهمین اردوی آماده سازی

به گزارش پایگاه خبری پهنه پرواز به نقل از روابط عمومی فدراسیون ورزش های ناشنوایان به نقل از هیأت استان تهران؛ جمعی از کوهنوردان ناشنوا

مدیرکل میراث فرهنگی استان مرکزی، مسجد جامع ساوه را نمونهای موفق از احیای معنوی و کارکردی بناهای تاریخی دانست و تأکید کرد: برگزاری رویدادهای فرهنگی

در ایران باستان، پزشکی تنها یک حرفه نبود؛ بلکه بخشی از سامان دینی، اجتماعی و سیاسی جامعه به شمار میآمد. پزشکان در جایگاهی میان دانش،

تحقیقات نشان میدهند که برخلاف تصور رایج، بسیاری از افراد با افزایش سن نه تنها غمگینتر نمیشوند، بلکه حتی از جوانترها شادتر و رضایتمندتر زندگی

مطالعات علمی اخیر نشان میدهد که یوگا، بیش از هر ورزش دیگری، میتواند کیفیت خواب را بهبود ببخشد. بر اساس نتایج بررسی ۲۲ مطالعه با

تعریف وازکتومی یک عمل جراحی ساده و سرپایی برای پیشگیری دائم از بارداری در مردان است. در این روش، لولههای وازدفران (مسیر انتقال اسپرم) قطع

ایسنا – در گرامیداشت روز پزشک، مسئولان و دستاندرکاران حوزه سلامت با تأکید بر جایگاه والای جامعه پزشکی، این روز را فرصتی برای قدردانی از

پریا پیری برابر حریفی از کرهجنوبی نتیجه را واگذار کرد پریا پیری ملی پوش کشورمان در کلاس BC3 در سومین دیدار خود در مرحله مقدماتی،

موفقیت همیشه فقط در شرایط آسان بهدست نمیآید. گاهی در دل محدودیتهاست که استعدادها و ارادههای بزرگ شکوفا میشوند. «مرضیه نقیزاده» از تهران، دختری است

اولین دوره اردوی آمادگی ورزش کریکت با ویلچر در ایران، از اول شهریور ماه ۱۴۰۴ در شهر محمدیه استان قزوین آغاز شد. این اردو که

تیم ملی دانشآموزی ایران در رقابتهای المپیاد جهانی نجوم و اخترفیزیک که در مومبای، هند برگزار شد، با کسب مدالهای ارزشمند، بار دیگر افتخار آفرینی

به گزارش ایرنا، تکریم بیمار یکی از اصول اساسی در ارائه خدمات پزشکی است، اما در بسیاری از مطبهای دزفول این موضوع مغفول مانده است.

دانشمندان بریتانیایی روش جدیدی برای ردیابی مسیر گسترش سرطان پستان ابداع کردهاند که از الماس بهره میبرد. این روش بهعنوان جایگزینی ایمن و غیررادیواکتیو برای

به گزارش ایسنا، عضو هیئت علمی دانشگاه علوم پزشکی گلستان با اشاره به جایگاه رفیع پزشکان در جامعه، تأکید کرد: «پزشکان نهتنها حافظان جان انسانها

در روزهای اخیر تصاویر و ویدئوهایی از خروج بخار و گاز از دهانه قله دماوند منتشر شده و پرسشهایی درباره احتمال فوران آتشفشان به وجود

اعتماد به نفس در سخنرانی یک ویژگی ذاتی نیست، بلکه مهارتی است که با تمرین و تکرار به دست میآید. بسیاری از افراد در ابتدای

اعضای تیم ملی کاراته ناشنوایان ایران، پس از پشت سر گذاشتن پنج مرحله اردو، وارد ششمین اردوی آمادهسازی خود شدند تا مهیای حضور در بیست

پریا پیری با اختلاف یک امتیاز برابر حریفی از عربستان نتیجه را واگذار کرد به گزارش پایگاه خبری پهنه پرواز به نقل از روابط عمومی

در دنیایی که برخی محدودیتها میتوانند سد راه رویاها شوند، هستند کسانی که نشان میدهند هیچ مانعی بزرگتر از اراده انسان نیست. میثم پوررئوفی، متولد

سیدناصر عمادی، پزشک و استاد دانشگاه علوم پزشکی تهران، در کودکی برادرش را به دلیل نبود پزشک از دست داد و همین حادثه انگیزهای شد

لرزش بدن میتواند به دلایل مختلفی ایجاد شود، اما یکی از مهمترین عوامل آن کمبود ویتامینها و مواد معدنی است. رعایت یک رژیم غذایی کامل

پیش از آغاز مراسم افتتاحیه رقابتهای بینالمللی قزاقستان، کلاسبندی ورزشکاران اعزامی به این رویداد از سوی متخصصین صورت گرفت. به گزارش پایگاه خبری پهنه پرواز

مهران افراشته برابر حریفی از قزاقستان به پیروزی رسید به گزارش پایگاه خبری پهنه پرواز به نقل از روابط عمومی فدراسیون ورزشهای جانبازان و توان

بهنام رئوفی، ورزشکاری پرتلاش و متولد تهران، نمونهای از پشتکار و اراده است. با وجود ناشنوایی مادرزادی، او مسیر موفقیت را در دنیای ورزش هموار

در ادبیات فارسی، شعر نو و شعر سپید دو سبک مهم مدرن محسوب میشوند که گاهی با یکدیگر اشتباه گرفته میشوند، اما ویژگیهای مشخص خود

تحقیقات روانشناسی نشان میدهند که داشتن دشمن یا موضوعی که نفرت در مورد آن مشترک باشد، میتواند دوستیها را عمیقتر کند. وقتی دو نفر یک

عفونت ریه زمانی ایجاد میشود که ویروس، باکتری یا قارچ وارد ریهها شده و باعث التهاب در مجاری تنفسی گردد. واکنش سیستم ایمنی به این

از نگاه روانشناسان، بسیاری از عادتهای ساده روزمره میتوانند به مرور زمان توانایی ذهنی ما را کاهش دهند. ضریب هوشی مؤثر (Effective IQ) تنها به

در دل روستای تاریخی «کاروانسرا» و در حاشیه رشتهکوههای هفتاد قله، بنایی ارزشمند از دوران صفوی جا خوش کرده است؛ کاروانسرای شاه عباسی اراک. این

به مناسبت هفته جهانی ناشنوایان، اولین دوره استعدادیابی دوومیدانی بانوان ناشنوا در روزهای ۱۰ و ۱۱ مهرماه برگزار خواهد شد. این برنامه با هدف شناسایی

سازمان غذا و داروی آمریکا (FDA) بهتازگی قطره چشمی نوینی با نام تجاری ویز (Vizz) را تأیید کرده است. ماده اصلی این دارو «آسکلیدین» بوده

در پی برگزاری موفق گردهماییهای بزرگ پارالمپیکی شامل کنفرانس APC 2025، مراسم جوایز آسیایی و مجمع عمومی کمیته پارالمپیک آسیا، ماجد راشد، رئیس این کمیته

در مقالهای از کتاب کاله، نقش اسیدهای چرب امگا ۳ و پروتئین در حفظ سلامت مغز بررسی شده است. این دو ماده مغذی با اثرات

احساس خستگی دائمی یکی از شکایات شایع در زندگی روزمره است که بسیاری از افراد آن را تجربه میکنند. برخلاف تصور عمومی، این وضعیت تنها

یادگیری ریاضی برای بسیاری از کودکان چالشبرانگیز است و والدین اغلب نگران این هستند که فرزندشان در درک مفاهیم ریاضی ضعف داشته باشد. برخی کودکان

آبسه مقعدی یک عفونت باکتریایی در غدد اطراف مقعد است که با درد شدید، تورم و ترشح چرک همراه میشود. در صورت عدم درمان، ممکن

مدت زمان حضور دانشآموزان در مدرسه یکی از شاخصهای مهم نظام آموزشی است. این زمان در کشورهای مختلف تفاوت چشمگیری دارد و بازتابی از فرهنگ،

یکی از باورهای رایج این است که شستشوی بینی با آب میتواند خطرناک باشد. اما دکتر سیدعلی جواد موسوی، فوقتخصص ریه، در برنامه «اینجا طبیب»

کتاب «چگونه فوراً با هر کسی ارتباط برقرار کنیم» نوشته لیل لوندز، فراتر از یک اثر نظری است. این کتاب را باید یک جعبهابزار ارتباطی

دکتر دنیامالی: تفاوتی میان طلای پارالمپیک با طلای المپیک نیست/ به دنبال اختصاص ۲۰ درصد بودجه استانها به ورزش پارا هستیم وزیر ورزش و جوانان

حمیدرضا صابری، رئیس انجمن تنیس روی میز ناشنوایان، با حضور در اردوی آمادهسازی ملیپوشان این رشته، از نزدیک روند تمرینات و آمادگی تیم برای حضور

نشست مسئولین فرهنگی فدراسیونهای حاضر در بازیهای پاراآسیایی جوانان دبی ۲۰۲۵، با میزبانی کمیته ملی پارالمپیک برگزار شد و فرصتی برای تبادل نظر و بررسی

نمک بدن، که گاهی به آن نمک حمام نیز گفته میشود، از دانههای ریز نمک تشکیل شده و به پاکسازی پوست و ایجاد حس طراوت

احساس خوشحالی یکی از مهمترین دغدغههای هر فرد در زندگی است. در دنیای امروز، با فشارهای روزمره و چالشهای مختلف، بسیاری از مردم به دنبال

محبوبه میرقدیری، نویسنده رمان کسی بخواند یا نخواند در گفتوگویی با خبرگزاری کتاب ایران (ایبنا) توضیح داد که در این اثر کوشیده است به سراغ

ترس جمعی از سالمندی متولدان دهه ۶۰، امروز که به میانسالی رسیدهاند، سالمندی را دورهای مبهم، ناراحتکننده و هراسآور میدانند. آنان تصویر روشنی از آینده

به گزارش خبرآنلاین، استفاده از پستانک مخصوص بزرگسالان در سالهای اخیر به پدیدهای عجیب اما رو به گسترش در کشورهای مختلف مانند چین، کره جنوبی

سرمربی تیم ملی شنا ناشنوایان، علیرضا ایزدی، ترکیب دو نفره این تیم را برای حضور در بازیهای المپیک ناشنوایان ژاپن نهایی کرد. به گزارش روابط

نویسنده : روح الله.. قطبی توریسم مسئولانه دستهی خاصی از توریسم نیست؛ بلکه حوزهی میان توریسم انبوه و اکوتوریسم را در نظر میگیرد و هدف

بیژن غفاری، ورزشکار کمشنوا از استان تهران، کسی است که با وجود محدودیتهای جسمی و سختیهای مالی، توانسته افتخارات متعددی در رشته تیراندازی با تپانچه

نشست مشترک مدیران کمیته ملی پارالمپیک با رئیس هیات مدیره اتاق مشترک بازرگانی ایران و امارات برگزار شد. به گزارش پایگاه خبری پهنه پرواز به

کولرها با کاهش رطوبت هوا، محیطی خنک و قابلتحمل ایجاد میکنند اما همین فرایند میتواند به خشکی پوست و مجاری تنفسی منجر شود. وقتی رطوبت

بسیاری از ما همچون باری سنگین، رنجش را با خود حمل میکنیم. اما راه رهایی چیست؟ نخستین گام، پرورش دلسوزی و همدلی است؛ اینکه تلاش

نویسنده رضا تربتی تصور کنید که در دل طبیعتی بکر، دریاچهای آرام یا سواحل ساحلی زیبا در انتظار شماست، جایی که صدای آرامشبخش امواج به

مصطفی نکو لعلآزاد، رئیس فدراسیون ورزشهای ناشنوایان در نشست خبری امروز (دوشنبه ۲۷ مرداد) با اشاره به دستاوردهای بزرگ این فدراسیون طی یک سال اخیر،

با توجه به اجرای سهمیه سه درصدی معلولان در این آزمون از افراد دارای معلولیت برای ثبتنام دعوت میشود.متن اطلاعیه به شرح زیر است:به اطلاع

همیشه این پرسش مطرح است که چگونه دیگران را بشناسیم و با چه معیاری دوستان و استادانِ خود را برگزینیم؟ یکی از پاسخهایی که شمس

نخستین جلسه شورایعالی روز و هفته پارالمپیک برگزار و بر نقش آفرینی سازمانها در توسعه جنبش پارالمپیک و ارتقای آگاهی عمومی نسبت به ورزش های

در جهانی که گاه کوچکترین مانع میتواند سد راه رویاها شود، هستند کسانی که با ارادهای بزرگ، محدودیتها را به سکوی پرش موفقیت تبدیل میکنند.

تهران، کلانشهری پرهیاهو، سالهاست با سه مشکل جدی دست و پنجه نرم میکند: هزینه سنگین مسکن، ترافیک و آلودگی نفسگیر، و ناترازی در تأمین آب

لهجهها تنها شکل متفاوتی از سخن گفتن نیستند؛ آنها آینهای از تاریخ، فرهنگ و هویت مردمان ایراناند. هر لهجه، قصهای از سرزمین مادری را روایت

در بسیاری از خانوادهها بعد از مراسم ترحیم، سؤالی رایج در اذهان شکل میگیرد: «چرا عزیز فوتشدهمان در خواب به دیدارمان نمیآید؟» در این گزارش،

همزمان با آغاز رسمی شمارش معکوس سه ساله تا برگزاری نخستین دوره بازیهای پارالمپیک در لسآنجلس، کمیته برگزاری این رویداد، از دو نماد اختصاصی جدید

در جریان کنفرانس و مجمع عمومی کمیته پارالمپیک آسیا، از نشان (لوگو) و شعار رسمی پنجمین دوره بازیهای پاراآسیایی جوانان دبی ۲۰۲۵ رونمایی شد. به

انجمن قلب آمریکا و کالج قلب و عروق آمریکا، با استناد به آخرین پژوهشها، دستورالعملهای بهروزرسانیشدهای برای کنترل فشار خون بالا منتشر کردند. این بهروزرسانی

یک ایمپلنت مغزی مجهز به هوش مصنوعی توانست قدرت تکلم یک بیمار فلج را پس از ۱۸ سال بازیابی کند. این رابط مغز و رایانه

بیش از نیمی از افراد جامعه گرایش درونگرایی دارند، اما در محیطهای کاری اغلب نادیده گرفته میشوند. پژوهشها نشان میدهد مدیران درونگرا در تیمهایی با

شهرام لاسمی، مجری شناختهشده برنامههای کودک در مصاحبه با «رک »مجید واشقانی از تجربههای تلخ زندگیاش پرده برداشت. شهرام لاسمی، مجری شناختهشده برنامههای کودک در مصاحبه

احمد میدری، وزیر تعاون، کار و رفاه اجتماعی، اعلام کرد که در سال جاری بیشترین میزان افزایش حقوق مربوط به بازنشستگان بوده است. او گفت:

خیلیها تجربه کردهاند که پیش از رخ دادن یک اتفاق ناخوشایند، دلشوره یا حسی عجیب داشتهاند. برخی این حس را نوعی توانایی پیشبینی آینده میدانند.

گاهی روابط گذشته برایمان زخمی بر جای میگذارند؛ دردهایی که شاید فراموش نشوند اما در دل خود درسهای بزرگی دارند. شکستها و دلخوریها اگر درست

بسیاری از توصیههای سنتی که به سالمندان داده میشود، نه تنها سودی برای ذهن و بدن ندارند، بلکه میتوانند سرعت پیری مغز را بیشتر کنند.

ماهی غذایی پرخاصیت است، اما در طب سنتی طبع آن سرد و تر شناخته میشود. وقتی این طبع سرد با آبلیمو — که خودش هم

سندرم استاندال یا «سندرم فلورانس» یک واکنش روانتنی نادر است که در برخورد با آثار هنری بسیار زیبا، بهویژه در فلورانس ایتالیا، رخ میدهد. این

اگر همیشه بهخاطر طولانی بودن آثار کلاسیک از خواندنشان صرفنظر کردهاید، این هفت شاهکار کوتاه انتخابی عالی هستند. آثاری که میتوان در یکی دو روز

سونوگرافی واژینال یا اندوواژینال یکی از روشهای تصویربرداری دقیق و ایمن است که به کمک امواج صوتی، رحم، تخمدانها و ساختارهای لگنی زنان را بررسی

به گزارش پایگاه خبری پهنه پرواز به نقل از روابط عمومی کمیته ملی پارالمپیک، در این متن به آغاز رسمی بازی های پارالمپیک ۲۰۲۸ و

پنجمین مرحله اردوی آماده سازی تیم ملی تیراندازی برای حضور در بازی های المپیک ناشنوایان، همزمان در دو بخش تفنگ و تپانچه مردان و زنان

«۷ هفته آموزشی معلمان ورزش مدارس استثنایی»موضوع وبینار اولین هفته:«مهارتهای حرکتی پایه برای کودکان با نیازهای ویژه» مدرس دومین وبینار:جناب آقای دکتر امید جهانسوز (هیات

از جادههای باستانی گرفته تا مسیرهای دریایی پرخطر، مسیرهای تجاری در طول تاریخ تاثیر شگرفی بر جوامع مختلف داشتهاند. این مسیرها نهتنها کالاهای کمیاب مانند

صغری ربیعیفرد، متولد ۱۳۶۸ در تهران، یکی از بانوان ورزشکار ناشنوای کشور است که با وجود محدودیت شنوایی ۸۰ درصدی، توانسته در عرصههای بینالمللی بدرخشد.

شهرستان ساوه، موسوم به «خرده طلا»، یکی از قدیمیترین مراکز تمدن ایران است که در متون تاریخی از آن بهعنوان «جبال» یا «عراق عجم» یاد

پژوهشگران دانشگاه جانهاپکینز موفق به کشف نقش پروتئینی به نام اینترسِکتین در تعامل بین سلولهای مغزی شدند. این پروتئین، حبابهای کوچک حملکننده پیامهای عصبی (وزیکولهای

یک متخصص تغذیه و رژیمدرمانی میگوید پوسته تخممرغ یکی از بهترین و اقتصادیترین منابع کلسیم برای افرادی است که رژیم غذایی آنها کمکلسیم است یا

پژوهشگران دانشگاه استنفورد موفق شدهاند یک رابط مغز-رایانه (BCI) بسازند که میتواند جملاتی را که تنها در ذهن افراد شکل میگیرد — بدون اینکه بلند
پژوهشگران دانشگاه امآیتی از هوش مصنوعی برای ابداع دو آنتیبیوتیک جدید استفاده کردهاند که میتواند باکتریهای مقاوم مانند سوزاک و مرسا (استافیلوکوک اورئوس مقاوم به

نسل Z امروز بهعنوان خوششانسترین نسل تاریخ معرفی میشود. سم آلتمن، مدیرعامل OpenAI، معتقد است این نسل به ابزارهایی دسترسی دارد که پیشتر فقط در

لحن صمیمی و دوستانهویژگیها: گرم، ملایم، نزدیککاربرد: ایجاد حس همدلی، گفتگوهای شخصی، دلجویی، فضای امن و راحتمثال: «میدانم روز سختی داشتی، بیا با هم یک

در ایران، همانند بسیاری از کشورهای دیگر، هر حکومتی تلاش میکند اسناد و مدارک حکومتهای پیشین را از بین ببرد. این امر سبب شده درباره

در حاشیه کنفرانس پارالمپیک آسیا، دکتر کوهپایهزاده با اندرو پارسونز، رئیس IPC دیدار کرد و موافقت اولیه وی برای برگزاری کنفرانس علمی ویستا در آسیا

پایگاه خبری پهنه پرواز اینبار به سراغ یکی از چهرههای افتخارآفرین ورزش ایران رفته است؛ بانویی که با وجود ناشنوایی عمیق، توانسته پرچم ایران را

ابوذر ربیعزاده، فرزند عبدالعلی، فارغالتحصیل کارشناسی ارشد مهندسی برق قدرت، با ۷۰ درصد کمشنوایی مادرزادی، یکی از پرافتخارترین ورزشکاران ناشنوای کشور است. او با وجود

امیرحسین زارع، ورزشکار جوان و پرانرژی از تبریز، متولد سال ۱۳۷۸، عضو تیم ملی دوومیدانی در ماده پرتاب دیسک است. او که دانشآموخته کارشناسی و

جزیره قشم، در جنوب ایران و همسایگی تنگه هرمز، میزبان فرهنگی کهن و غنی است که حاصل قرنها زندگی مردم در تعامل با دریا و

از سوی کمیته پارالمپیک آسیا، زهرا نعمتی بانوی پرافتخار ایرانی، به عنوان مسئول برتر آسیا انتخاب شد. به گزارش پایگاه خبری پهنه پرواز به نقل

دکتر احمد دنیامالی در پیامی خطاب به زهرا نعمتی، دریافت جایزه مسئول برتر آسیا را که از سوی کمیته پارالمپیک آسیا اعطا شد، تبریک گفت

حسن آریایی کیا، ورزشکاری که با آسیب نخاعی از ناحیه مهرههای سینهای، طی ۱۴ سال تلاش و ارادهای استثنایی، موفق به کسب افتخاراتی همچون قهرمانی

در دنیای امروز با گسترش فناوری و دسترسی آسان کودکان به اطلاعات، پدیدهای به نام «سندروم همین الان میخوامش» شکل گرفته است. این سندروم که

در طول شب، زمانی که ما چراغها را خاموش کرده و به خواب میرویم، برخی از وسایل برقی در خانه همچنان برق مصرف میکنند. این

پژوهشی جدید نشان میدهد که مغز نوزادان برخلاف باورهای گذشته، چندان ناپخته نیست و آنها از همان ابتدا توانایی ساخت مدلهای شناختی پیشرفتهای دارند که

در دنیای امروز، ظهور هوش مصنوعی و ابزارهای مبتنی بر آن مانند چتجیپیتی تحول بزرگی در نحوه تعامل انسانها با فناوری ایجاد کرده است. با

احساسات بخش جداییناپذیر زندگی انسان هستند و ما در طول روز بارها با آنها مواجه میشویم. اما اغلب اوقات به جای پذیرش این احساسات، سعی

مجمع انتخاباتی هیأت ورزشهای ناشنوایان استان کرمانشاه امروز با حضور مصطفی نکولعلآزاد، رئیس فدراسیون ورزشهای ناشنوایان، حمیدرضا عزتی، مدیرکل ورزش و جوانان استان، و سایر

#کمک_معیشت تیر ماه 1404 بند (پ) تبصره (12) معلولان شدید و خیلی شدید تحت پوشش سازمان بهزیستی به حساب کارت بانک رفاه این عزیزان واریز

در حاشیه برگزاری کنفرانس کمیته پارالمپیک آسیا در شهر آستانه، عصر امروز نشستی ویژه با محوریت ایران و حضور مسئولان کمیتههای پارالمپیک کشورهای آسیای میانه

تیم ملی پاراسوارکاری ایران نخستین اردوی آمادهسازی خود را برای حضور در مسابقات المپیک ویژه آغاز کرد. این اردو از ۱۹ تا ۲۱ مردادماه در

در دنیایی که محدودیتها اغلب بهانهای برای توقف میشوند، ژیلا مبشری با ۹۵ درصد کمشنوایی، نهتنها متوقف نشد، بلکه با ارادهای مثالزدنی به اوج رسید.

بوسان، کره جنوبی در آذر ماه امسال میزبان یکی از مهمترین رویدادهای علمی و بینالمللی دنیای ورزش خواهد بود. به گزارش پایگاه خبری پهنه پرواز

گاهی پشت چهره آرام یک بازنشسته، سالها تلاش بیوقفه و زندگی پر از چالش پنهان است. علیرضا کرمانی، متولد ۴ دی ۱۳۵۱ در تهران، با

به گزارش پایگاه خبری پهنه پرواز به نقل از روابط عمومی فدراسیون ورزش های جانبازان و توان یابان، در راستای ترویج فرهنگ ورزش جانبازان و

موفقیت، فقط به استعداد و تمرین وابسته نیست؛ گاهی باید از دیوارهای بلند محدودیتها هم عبور کرد. مهدی پوراسماعیل، قهرمان کمشنوای کشورمان، نمونهای زنده از

در طب رایج، درمان آسم معمولاً با داروهایی انجام میشود که مجاری تنفسی را گشاد کرده و علائم بیماری مانند سرفه، خسخس سینه و تنگی

استفاده بیرویه و نامناسب کودکان از دستگاههای دیجیتال مانند موبایل و تبلت، به ویژه در دوران آموزش آنلاین، تبدیل به یک معضل جدی شده است

بر اساس گزارش ایرنا، ایران پس از مصر و پاکستان، رتبه سوم شیوع دیابت را در منطقه خاورمیانه به خود اختصاص داده است. این آمار،

احساس داغی و سوزش کف پا میتواند نشانه مشکلات مختلفی باشد که از کمبودهای تغذیهای تا اختلالات عصبی را شامل میشود. علل شایع دیابت، کمکاری

علی اشکانی، سرمربی تیم ملی کشتی فرنگی ناشنوایان، با اعلام ترکیب ۶ نفره تیمش برای حضور در بیست و پنجمین دوره بازیهای المپیک ناشنوایان در

علی خادمباشی، کارمند بخش توسعه ورزش همگانی فدراسیون ورزشهای جانبازان و توانیابان، در حرکتی نمادین و سرشار از انگیزه، موفق شد قله ۵۶۱۰ متری دماوند،

محققان ژاپنی دست به ابتکاری جالب زدهاند و یک توالت هوشمند فوقپیشرفته ساختهاند که میتواند هر بار بعد از استفاده، وضعیت سلامتی شما را بهطور

قهرمانی فقط یک مدال نیست؛ نتیجه سالها تلاش، فداکاری و گذشتن از فرصتهایی است که دیگران به راحتی از آنها بهرهمند میشوند. زینب حسنپور، متولد

شهردار لسآنجلس، سند رسمی میزبانی فراگیر و بدون مانع از بازیهای المپیک و پارالمپیک ٢٠٢٨ را امضا کرد. به گزارش پایگاه خبری پهنه پرواز به نقل

موفقیت یعنی شکستن دیوارهای محدودیت. امیررضا حسنزاده، ورزشکار اهل لیفکوی، ثابت کرده که شنیدن و شنواندن، فقط با گوش نیست؛ با قلب و اراده هم

روز شنبه ۱۸ مرداد ۱۴۰۴، قزوین شاهد رویدادی الهامبخش و تاریخی بود. در نشستی صمیمی دکتر فتانه امیری با حسین فرزانه، دبیر هیأت ورزش استان

با وجود محدودیتها و کمبود امکانات فراوان، قهرمانان ناشنوای ایران همچنان پرچم کشور را در میادین بینالمللی با افتخار به اهتزاز در میآورند. یکی از

در دنیای امروز که فضای مجازی بیشتر به میدان فریاد زدن شبیه شده تا شنیدن، گفتوگو با هوش مصنوعی میتواند تمرینی برای «توجه متقابل» باشد؛

تیم ملی هوش مصنوعی جمهوری اسلامی ایران در رقابتهای المپیاد جهانی ۲۰۲۵ درخشید و موفق به کسب دو مدال نقره و دو مدال برنز شد.

آرتریت یا التهاب مفاصل یکی از مشکلات رایج امروزی است که با درد، خشکی و تورم همراه میشود. خوشبختانه با انتخابهای غذایی درست میتوان این

در سال ۱۳۰۸ خورشیدی، در اصفهان، کودکی به دنیا آمد که قرار بود چهره هنر ایران را دگرگون کند؛ محمود فرشچیان. او از همان کودکی

ترکیب نهایی تیم ملی تکواندو ناشنوایان ایران در بخش کیوروگی برای حضور در بیستوپنجمین دوره بازیهای المپیک ناشنوایان مشخص شد. این رقابتها از ۲۴ آبان

هشتمین مرحله از تمرینات ملی پوشان جوان تیم پاراشنا برای آمادگی بازی های پاراآسیایی جوانان دبی ۲۰۲۵ آغاز شد. به گزارش پایگاه خبری پهنه پرواز

در گزارشی از خبرآنلاین (۱۵ مرداد ۱۴۰۴)، به معرفی میوهها و مواد غذایی پرداخته شده که میتوانند نقش مؤثری در تقویت سیستم ایمنی بدن داشته

در گزارشی از خبرگزاری ایرنا (۱۶ مرداد ۱۴۰۴) به جایگاه برجسته و اثرگذار محمود دولتآبادی در ادبیات معاصر ایران پرداخته شده است. نویسنده در این

قهرمان شدن همیشه با امکانات و حمایت همراه نیست. گاهی مسیر رسیدن به افتخار، پر از کمبودها و چالشهاست، اما اراده و عشق به پرچم

اکهارت تله میگوید: آن تصویری که ما از خود داریم، ارتباط مستقیم با رفتار و نگاه دیگران نسبت به ما دارد. بسیاری از افراد از

برندگان جایزه نوبل که نماد عقل و خرد بشری هستند، گاهی پس از کسب این افتخار جهانی، به باورها و نظریاتی فراتر از علم رو

اردوی آماده سازی تیم های ملی پاراوزنه برداری بانوان جوانان و بزرگسالان در کمپ تیم های ملی فدراسیون برگزار می شود. به گزارش پایگاه خبری

افتخارآفرینی برای ایران تنها به توانایی کامل جسمی وابسته نیست؛ اراده، پشتکار و عشق به پرچم میتواند هر محدودیتی را به سکوی موفقیت تبدیل کند.

در دنیای ورزش، قهرمانی تنها به قدرت بدنی و مهارت فنی خلاصه نمیشود؛ گاهی اراده، عشق به میهن و گذشتن از موانع، ارزشمندتر از هر

نتایج یک مطالعهی علمی جدید نشان میدهد افرادی که فقط در تعطیلات آخر هفته ورزش میکنند، همچنان میتوانند از فواید قابل توجه آن در کاهش

در سالهای اخیر، رشد نگرانکنندهای در انتشار مقالات علمی جعلی مشاهده شده که نظام پژوهشی جهان را با بحران بیسابقهای مواجه کرده است. پژوهش جدیدی

۱۷ مرداد، روز خبرنگار، فقط یک تاریخ در تقویم نیست؛ نقطهایست در مسیر حقیقت، که یادآور تلاش بیوقفه زن و مردیست که بیصدا مینویسند، ولی

محمدرضا سراوان به عنوان رئیس جدید انتخاب شد با حضور مصطفی نکولعلآزاد رئیس فدراسیون ورزشهای ناشنوایان، و ادهم کرد سرپرست ادارهکل ورزش و جوانان استان

در راستای اجرای دستورالعملها و ضوابط ابلاغی وزارت ورزش و جوانان،انتخابات کمیسیونهای ورزشکاران، مربیان فدراسیون ورزش های جانبازان و توان یابان برگزار شد. به گزارش

به گزارش پایگاه خبری پهنه پرواز به نقل از روابط عمومی کمیته ملی پارالمپیک، در فاصله ۵۰ روز مانده به مسابقات قهرمانی جهان #پارادوومیدانی دهلی

ــ خدا در خانۀ ماست و این ماییم که برای قدم زدن از خانه بیرون رفتهایم. ــ خدا با افزودن چیزی به روح یافت نمیشود،

راهاندازی ایرلاین امیرکبیر نقطه عطفی در توسعه استان مرکزی به گزارش پایگاه خبری پهنه پرواز امروز پنجشنبه شانزدهم مردادماه ۱۴۰۴ استان مرکزی با همت، توجه

وقتی زندگی با یک تصادف تغییر مسیر میدهد، بعضیها توقف میکنند، اما عدهای راه تازهای برای پیشرفت پیدا میکنند. عظیم عباسی، متولد ۱۳۶۵، از همان

با سابقهای درخشان از مدالهای جهانی و آسیایی، حمیدرضا کنعانی کارشناس تربیت بدنی و علوم ورزشی نهتنها یکی از پرافتخارترین ورزشکاران ناشنوای کشور است، بلکه

در پی انتصاب دکتر فتانه امیری نماینده فدراسیون جهانی کریکت ناشنوایان، به ریاست انجمن کریکت ناشنوایان ایران، مصطفی نکولعلآزاد با حضور در دفتر جشنواره بینالمللی

در حالی که بازنشستگان بیش از هر زمان دیگری نیازمند خدمات درمانی و آرامش خاطر هستند، دسترسی آنها به خدمات بیمه تکمیلی با چالشهای جدی

کمشنوایی یکی از اختلالات شایع اما کمتوجه در نظام سلامت است؛ مشکلی که میتواند از نخستین روزهای زندگی آغاز شود و تا دوران سالمندی ادامه

در حالیکه جامعه با بحرانهای پیاپی زیستمحیطی، اقتصادی و اجتماعی روبهروست، نبود واکنش عمومی به فجایع، برخی را به این اشتباه میاندازد که مردم رضایت

آیا تا به حال با خود فکر کردهاید که چرا بعضیها در نگاه دیگران «باحال» به نظر میرسند؟ مطالعهای جدید با شرکت بیش از ۶

پلاسما تراپی واژن یک روش نوین، ایمن و غیرجراحی است که با هدف جوانسازی، بهبود عملکرد و زیبایی ناحیه تناسلی بانوان انجام میشود. در این

گاهی زندگی، ناگهان مسیرش را عوض میکند؛ راهی که با دو پا شروع شد، ناگهان روی چهار چرخ ادامه مییابد. اما قهرمان، کسی است که

گاهی صدای افتخار از دل سکوتها شنیده میشود. در جهانی که برای موفقیت فریاد میزنند، بعضیها بدون صدا، بدون دیده شدن، و بدون حمایت، مسیر

اردوی تیمهای ملی #بسکتبالباویلچر آقایان و بانوان در کمپ تیم های ملی فدراسیون آغاز شد. به گزارش پایگاه خبری پهنه پرواز به نقل از روابط

به گزارش پایگاه خبری پهنه پرواز به نقل از روابط عمومی فدراسیون ورزشهای جانبازان و توانیابان، دکتر کوهپایهزاده: استعدادیابی به سمت استفاده از فناوری می

وقتی صدا شنیده نمیشود، حرکت باید فریاد بزند. فاطمه زلیکانی، قهرمان ملی و طلایی ناشنوای ایران، یکی از آن زنانیست که سکوتش را با درخشش

محدثه غلامی، جوان ۲۱ ساله و دانشجوی کارشناسی تربیت بدنی، با وجود داشتن شنوایی ۶۵ دسیبل و استفاده از سمعک، توانسته در رقابتهای آسیایی و

امیرحسین زارع، ورزشکار جوان و با استعداد تبریزی، متولد سال ۱۳۷۸، با وجود کاشت حلزونی در گوش، در رشته پرتاب دیسک به افتخارات بزرگی دست

محققان ایرانی در یک پژوهش نوآورانه موفق شدهاند با استفاده از دادههای ژنتیکی، روشی برای درمان هدفمند افسردگی طراحی کنند. این روش به پزشکان کمک

احتباس ادراری حالتی است که در آن فرد نمیتواند ادرار را بهطور کامل تخلیه کند. این وضعیت ممکن است بهصورت حاد (ناگهانی و دردناک) یا

آیا وضعیت خوابیدن میتواند بر احتمال بارداری تأثیر بگذارد؟ اگرچه شواهد علمی قطعی در این زمینه وجود ندارد، برخی توصیهها میتوانند به بهبود شرایط برای

مطالعات علمی نشان میدهند که هر دو روش خواندن و شنیدن اطلاعات، مسیرهای متفاوتی را در مغز فعال میکنند. اما آیا این دو روش در

ریسکپذیری، افزایش آگاهی و حساسیت به خویشتن و وقت گذراندن بیشتر با دوستان همگی نشانههای مرحلهی مهمی از رشد مغز هستند؛ نشانههای سفری که برای

به گزارش پایگاه خبری پهنه پرواز به نقل از روابط عمومی سازمان بهزیستی معاون بازسازی و مسکن روستایی بنیاد مسکن انقلاب اسلامی کشور : تسهیلات

اردوی تیمهای ملی بسکتبال با ویلچر آقایان و بانوان در کمپ تیم های ملی فدراسیون برگزار می شود. به گزارش پایگاه خبری پهنه پرواز به

دویستوبیستوهشتمین نشست هیئت اجرایی کمیته ملی پارالمپیک با حضور دکتر احمد دنیامالی وزیر ورزش و جوانان، دکتر غفور کارگری رئیس کمیته ملی پارالمپیک و معاونین

به بهانهی حضور باشکوه کاروان ناشنوایان ایران در المپیک توکیو در دنیایی که صدا و هیاهو معیار ارتباط است، قهرمانانی هستند که با «سکوت»، فریاد

بیشتر ما زندگیمان را در «انتظار» میگذرانیم: منتظر پایان هفتهایم… منتظر تعطیلات… منتظر وقت مناسب، حال خوب، فرصت طلایی، انگیزهی کامل… اما حقیقت این است

مطالعات اخیر نشان میدهد که هرچه هوش مصنوعی پیشرفتهتر میشود، توانایی بیشتری در رفتارهای فریبکارانه و پنهانکاری آگاهانه از خود بروز میدهد. پژوهشی که از

خلاصه پژوهش برخی پژوهشها نشان دادهاند که افراد با هوش بالا ممکن است اضطراب بیشتری تجربه کنند؛ اما شواهد تازهتر و دقیقتر این فرضیه را

بر اساس گزارشی از کمیسیون لنست، چاقی و بیماری کبد چرب بهعنوان عوامل اصلی رشد سریع سرطان کبد در جهان معرفی شدهاند. این گزارش هشدار

پلاژنتراپی ناحیه تناسلی یکی از روشهای مدرن، غیرتهاجمی و مؤثر برای جوانسازی، رفع تیرگی، سفتسازی و بهبود بافت واژن است. این روش با استفاده از

کارگاه آموزشی روانشناسی ورزشی برای ملی پوشان بوچیا برگزار شد. به گزارش پایگاه خبری پهنه پرواز به نقل از روابط عمومی فدراسیون ورزشهای جانبازان و

در اقدامی هدفمند و در راستای توسعه تیم ملی والیبال بانوان ناشنوا، جلسهای تخصصی بهصورت وبینار با حضور زهرا داودی، نائب رئیس فدراسیون ورزشهای ناشنوایان،

در جهانی که موانع گاهی بلندتر از دیوارهای بتنی بهنظر میرسند، برخی انسانها با ارادهای پولادین و انگیزهای وصفناپذیر، همه محدودیتها را کنار میزنند. فرهاد

در زمانی که معلولیت اغلب با محدودیت گره خورده، هستند افرادی که این باور را به چالش میکشند. بهزاد امیری، کاپیتان تیم ملی تکواندوی ناشنوایان

تصمیمگیری یکی از پیچیدهترین فرآیندهای ذهنی ماست و همیشه هم نتیجهاش درست از آب درنمیآید. گاهی اوقات با وجود اینکه از پیامدهای منفی یک تصمیم

پژوهشگران دانشگاه مرکزی جنوب چین در مطالعهای تازه نشان دادهاند که چاقی با تغییر میکروبیوتای روده، سلامت استخوانها را بهطور مستقیم تهدید میکند. بر اساس

ادبیات کودک در استان مرکزی با وجود ظرفیتهای بومی، همچنان با ضعف در ساختار، نبود انسجام و کمبود حمایت نهادی مواجه است. کتایون آذرپی، نویسنده

در جهانی که کلیشهها همچنان ذهن بسیاری را شکل میدهند، زنانی موفقتر عمل میکنند که با هوشمندی، تدبیر و مرزبندی آگاهانه از قالبهای رایج فراتر

نتایج یک پژوهش گسترده از دانشگاه واخنینگن هلند، معادلات رایج در دنیای تغذیه را زیر و رو کرده است. بر اساس این مطالعه که بزرگترین

دانشگاه علوم پزشکی تهران در جدیدترین نشست مسئولان، رویکردهای جدید خود در حوزه بهداشت و درمان را اعلام کرد. در این برنامه، پیشگیری و ارتقای

کمیته بینالمللی پارالمپیک (IPC) با عضویت فدراسیون بینالمللی سامبو و فدراسیون جهانی بولز بهعنوان فدراسیونهای رسمی بینالمللی موافقت کرد.با این اقدام، شمار فدراسیونهایی که بهصورت

در دنیایی که محدودیتها میتوانند سد راه موفقیت باشند، برخی انسانها هستند که این موانع را به سکوی پرتاب تبدیل میکنند. مریم خدابنده، قهرمان ملی

در دیداری مشترک میان رئیس سازمان بهزیستی کشور و اعضای هیئت مدیره انجمن علمی شنواییشناسی ایران، بر توسعه همکاریهای تخصصی این انجمن با طرح «سلام»

آیا تا به حال واقعاً خودت را دوست داشتهای؟نه آن دوست داشتن سطحی که در مقابل آینه چند جمله مثبت به خود بگویی، بلکه عشقی

مطالعهای جدید از سوی پژوهشگران آکادمی علوم چین نشان میدهد که روند پیری بدن انسان از حدود سن ۵۰ سالگی با سرعت بیشتری آغاز میشود.

غذا خوردن احساسی به معنای مصرف غذا بهعنوان واکنشی به احساسات مانند استرس، اضطراب، تنهایی یا بیحوصلگی است، نه بهدلیل گرسنگی واقعی. این رفتار میتواند

افکار منفی عادتی ذهنی است که به سلامت جسم و روان آسیب میزند. برای غلبه بر آن، تفکر افراطی را کنار بگذارید، بر تنفس و

زویی کلاینمن، سردبیر بخش فناوری بیبیسی، در مقالهای تازه با نگاهی شخصی و پژوهشی به یکی از دغدغههای اصلی والدین در عصر دیجیتال پرداخته است:

برای نخستین بار در تاریخ ورزش ناشنوایان، تیم ملی والیبال ساحلی ایران با دو تیم «الف» و «ب» راهی رقابتهای المپیک ناشنوایان خواهد شد. این

هفتمین مرحله از تمرینات تیم ملی #پاراشنا نابینایان و کم بینایان از امروز ۱۱ مرداد ماه آغاز شد. به گزارش پایگاه خبری پهنه پرواز به

به گزارش پایگاه خبری پهنه پرواز به نقل از روابط عمومی پارالمپیک برخی رفتارهای جوانان به دلیل برخوردهای قیم مآبانه با آنان است /دولت وفاق

در دنیایی که صدای موفقیت گاه پشت دیوارهای بیتوجهی گم میشود، بانوانی چون مژده مردانی با ارادهای ستودنی، تاریخساز میشوند. او با وجود مشکلات شنوایی

مریم حسینیان، نویسنده برجسته ایرانی، پس از سالها مبارزه با بیماری سرطان، در سن ۵۰ سالگی درگذشت. او متولد اول فروردین ۱۳۵۴ در مشهد بود

وزارت ورزش از مسئولان فدراسیون تکواندو برای ارائه توضیحات درباره حواشی اخیر دعوت کرد. به گزارش پایگاه خبری پهنه پرواز به نقل از خبرگزاری خبرآنلاین؛ با

تهران- ایرنا- عضو انجمن اوتیسم ایران گفت: هرچند وقت گذراندن کودکان دارای اوتیسم با سگهای تربیت شده، تاثیر مثبتی بر کاهش علائم اوتیسم دارد اما

قاطعیت یعنی توانایی بیان واضح و محترمانه نظرات، احساسات و حقوق خود، به گونهای که هم به خود و هم به دیگران احترام گذاشته شود.

گسلایت (Gaslighting) یا تحریف ذهنی نوعی سوءرفتار روانی است که در آن فرد آزارگر با انکار، تحریف یا دروغگویی دربارهی واقعیتها، باعث میشود قربانی به

نویسنده: روح ا.. قطبی آگریتوریسم یکی از شاخههای گردشگری پایدار است که افراد را به تجربه مستقیم زندگی کشاورزی و روستایی دعوت میکند. این نوع

با هدف افزایش هماهنگی و آمادگی برای المپیک ۲۰۲۵ توکیو در ادامه مسیر آمادهسازی تیم ملی کاراته بانوان ناشنوایان برای حضور قدرتمند در المپیک ناشنوایان

دکتر کوهپایه زاده با رئیس مرکز آموزش و پژوهش شورای عالی استان ها دیدار و گفتگو کرد به گزارش پایگاه خبری پهنه پرواز به نقل

وزارت ورزش و جوانان در پیامی کسب دهمین عنوان قهرمانی متوالی ایران در مسابقات پاراتکواندوی آسیا را تبریک گفت متن پیام به شرح زیر است:

پنجشنبه، ۳۱ تیر ۱۴۰۴ – مرحلهای دیگر از طرح استعدادیابی تیم ملی والیبال دختران ناشنوا، این بار در استان البرز و سالن اختصاصی ناشنوایان کرج

حرف زدن در خواب یکی از رفتارهای رایج کودکان است که معمولاً جای نگرانی ندارد، اما میتواند برای والدین آزاردهنده باشد. این پدیده که به

کاهش وزن معمولاً با ورزش و فعالیت بدنی همراه است، اما در شرایطی که انجام ورزش برای برخی افراد دشوار یا غیرممکن است، روشهای جایگزینی

ری کورزویل، نظریهپرداز شناختهشده حوزه فناوری، در تازهترین پیشبینی خود اعلام کرده است که تا سال ۲۰۴۵، انسان و ماشین به چنان سطحی از ادغام

مجله سالانه «ادبیات متعهد» در جدیدترین فراخوان خود از تمامی شاعران و نویسندگان فارسیزبان سراسر جهان دعوت کرده تا آثار ادبی خود را برای دریافت

یوتیوب اعلام کرده که از فناوری هوش مصنوعی برای تخمین سن کاربران استفاده خواهد کرد. این سامانه جدید ابتدا بهصورت آزمایشی برای گروهی از کاربران

رئیس سازمان بهزیستی کشور با تشریح رویکردهای کلان این سازمان، بر اجرای برنامهها بر پایه دانش و مشارکت تأکید کرد. وی در توضیح نخستین راهبرد

در پنجمین دوره «جایزه ملی کتاب سال جوانان»، دبیرخانه این رویداد فرهنگی از ثبت ۸۷۴ اثر از سوی نویسندگان، مترجمان و مصححان زیر ۲۹ سال

اوزومین، نماد رسمی بازیهای پاراآسیایی ۲۰۲۶ #آیچی_ناگویا ، با هدف معرفی رشتههای این رقابت قارهای، سفرش را از رشته پارا تنیس روی میز آغاز کرد

اعضای تیم #پاراتکواندو کشورمان رقبای خود را در دهمین دوره مسابقات قهرمانی آسیا شناختند. به گزارش پایگاه خبری پهنه پرواز به نقل از روابط عمومی

به اطلاع میرسد یک رویداد بزرگ و ملی در حوزه ورزش، با محوریت افراد کمشنوا و ناشنوا، در تاریخ ۲۵ شهریور ۱۴۰۴ برگزار خواهد شد.

سازمان بهزیستی خراسان رضوی در راستای ارتقای کیفیت زندگی افراد دارای معلولیت، در دو سال اخیر تمرکز ویژهای بر هنردرمانی و ورزشدرمانی داشته است. این

در حال حاضر، ۱۶ شهر کشور بهعنوان شهر دوستدار سالمند معرفی شدهاند. این شهرها در استانهای تهران، گیلان، یزد، اصفهان، آذربایجان شرقی و غربی، لرستان،

باور نادرستی وجود دارد که ورزش و بدنسازی تنها برای جوانان است؛ درحالیکه بدنسازی برای سالمندان نهتنها ممکن بلکه بسیار ضروری است. با بالا رفتن

نمایشگاه «بهگزارش زنان» در موزه هنرهای معاصر تهران از تاریخ ۱ مرداد ۱۴۰۴ آغاز به کار کرده و تا پایان شهریور ادامه دارد. این رویداد

گروهی از محققان سوئیسی در دانشگاه ژنو به رهبری دکتر کامیلا جاندوس، به نتایج قابلتوجهی دست یافتهاند که میتواند آینده پزشکی را متحول کند. این

پس از چند سال ادغام، جشنواره فیلم فجر بار دیگر به دو بخش ملی و جهانی تفکیک شد. این تصمیم، به گفته رئیس سازمان سینمایی،

با پایان جنگ ۱۲روزه اسرائیل علیه ایران، آثار و تبعات آن بر بخشهای مختلف کشور همچنان پابرجاست. یکی از اصلیترین قربانیان چنین بحرانهایی، صنعت گردشگری

حدود ۹ سال از ثبت جهانی بیابان لوت به عنوان نخستین میراث طبیعی ایران در یونسکو میگذرد، اما این اثر ارزشمند هنوز فاقد ساختار مدیریت

دوره سواد رسانه ای با هدف ارتقای شناخت ورزشکاران تیمهای ملی جوانان و بزرگسالان پاراتنیس روی میز بانوان از فضای مجازی و رسانه، کلاس آموزشی

مجمع انتخاباتی هیأت ورزشهای ناشنوایان استان گیلان با حضور مصطفی نکولعلآزاد، رئیس فدراسیون ورزشهای ناشنوایان، و جمعی از مسئولان استانی از جمله مجتبی موسینژاد، معاون

فدراسیون ورزشهای ناشنوایان در راستای شناسایی و جذب استعدادهای برتر، مرحله انتخابی تیم ملی والیبال بانوان ناشنوا را در استان البرز برگزار میکند. این مرحله

چهارمین مرحله از تمرینات تیم ملی #والیبال_نشسته از فردا ۹ مرداد ماه به میزبانی رشت آغاز می شود. به گزارش پایگاه خبری پهنه پرواز به

ایران به عضویت شورای بینالمللی کریکت ناشنوایان درمی آمد / دکتر فتانه امیری، نماینده DICC و رئیس انجمن کریکت ناشنوایان ایران شد در یک گام

در دنیای امروز، تلفن همراه به یکی از ابزارهای اصلی ارتباطی و اطلاعاتی تبدیل شده است. اما با پیشرفت فناوری، ممکن است شاهد تغییرات چشمگیری

با افزایش هزینههای زندگی و فشار اقتصادی بر بازنشستگان تأمین اجتماعی، چشمانتظاری برای دریافت واریزیهای ویژه به یکی از دغدغههای اصلی این قشر تبدیل شده

سراب ماران، با طبیعتی بکر و منحصر به فرد و حضور مارهای آبی فراوان، یکی از جاذبههای برجسته گردشگری استان کرمانشاه است که همه ساله

تیم رباتیک ایران توانست در سیودومین دوره مسابقات جهانی RoboCup که امسال در شهر سالوادور برزیل برگزار شد، افتخاری بیسابقه و تاریخی برای کشور رقم

آئین رونمایی از کتاب «آوازی برایم بخوان حسون» در اهواز برگزار شد؛ گسترش باورهای شخصی در دل داستان، رمز موفقیت نویسنده است در مراسم رونمایی

در قرعهکشی مسابقات فوتبال بیستوپنجمین دوره المپیک ناشنوایان، تیم ملی فوتبال ناشنوایان ایران با سه تیم قدرتمند در گروه B همگروه شد. بر اساس این

به گزارش پایگاه خبری پهنه پرواز به نقل از روابط عمومی فدراسیون ورزشهای جانبازان و توانیابان و به نقل از کمیته ملی پارالمپیک،امروز ۲۹ جولای،

مسئولان کمیته ملی پارالمپیک عصر امروز با حضور در اردوی تیمهای ملی #پاراتیراندازی و #پاراتنیسرویمیز بانوان جانباز و توان یاب، از روند تمرینات ورزشکاران بازدید

در نگاه نخست به نظر میرسد که ناامیدی مطلقاً امر ناپسندی است و باید به طور کامل خود را از آن دور نگاه داریم، اما

در رقابت جهانی برنامهنویسی AtCoder 2025 که در توکیو برگزار شد، برنامهنویس لهستانی به نام Przemysław Dębiak معروف به «Psyho» با اختلاف کمی نماینده هوش

سریال «تاسیان» با استقبال قابل توجهی مواجه شد، اما پایانبندی آن باعث نارضایتی بخش زیادی از مخاطبان شده است. بسیاری معتقدند پایان داستان منطقی و

بر اساس مطالعات جدید دانشمندان، پایان جهان ممکن است زودتر از پیشبینیهای قبلی رخ دهد. این نتیجه حاصل تحلیل دادههای تازه درباره انرژی تاریک و

زایمان زودرس به تولد نوزاد پیش از هفته ۳۷ بارداری گفته میشود و میتواند سلامت مادر و جنین را به خطر بیندازد. دلایل زایمان زودرس

یائسگی زودرس به توقف عملکرد تخمدانها پیش از سن ۴۰ سالگی گفته میشود. این وضعیت که با عنوان «نارسایی زودرس تخمدان» نیز شناخته میشود، حدود

جنگ ۱۲ روزه اخیر، فرصتی بود تا تابآوری روانی جامعه در برابر بحرانها سنجیده شود. واکنشهای عمومی به تهدید، اضطراب و نااطمینانی نشان داد بسیاری

سردرد یکی از ناراحتیهای شایع دوران بارداری است که میتواند به دلایل مختلفی از جمله تغییرات هورمونی، افزایش حجم خون، کمآبی، استرس و بیخوابی بروز

لختههای خونی زمانی شکل میگیرند که جریان طبیعی خون در رگها مختل شده و خون به صورت غیرطبیعی تجمع مییابد. در حالی که لخته شدن

فدراسیون تنیس روی میز از حضور دو داور ایرانی برای قضاوت رقابت های #پاراتنیسرویمیز در بازی های پاراآسیایی آیچی-ناگویا ۲۰۲۶ خبر داد. به گزارش پایگاه

انجمن کریکت ناشنوایان ایران با هدف توسعه ورزشهای گروهی برای جامعه ناشنوایان، در نظر دارد برای نخستینبار در کشور، اقدام به راهاندازی تیم کریکت ناشنوایان

دکتر فاطمه امیری که نماینده رسمی فدراسیون جهانی کریکت ناشنوایان و بنیانگذار پاراکریکت در ایران است، به عنوان رئیس انجمن کریکت ناشنوایان منصوب شد. امیری

نسل جدید، بهویژه متولدان دهه ۱۳۸۰، در دنیایی بزرگ شدهاند که فناوری، شبکههای اجتماعی و سرعت بالای انتقال اطلاعات، شکل ارتباطات را دگرگون کرده است.

آبشار ذوات (یا زوات)، یکی از گنجینههای طبیعی ناشناخته در نزدیکی شهر چالوس است. این آبشار زیبا در میان جنگلهای انبوه هیرکانی و در نزدیکی

مفهوم کلی ضربالمثل ضربالمثل «حوض نساخته، قورباغه پیدا شد» عبارتی است پرمعنا که در زبان فارسی برای اشاره به افرادی به کار میرود که بدون

ویتامینهای گروه B از مهمترین مواد مورد نیاز بدن هستند که نقش کلیدی در تولید انرژی، بهبود عملکرد سیستم عصبی و حفظ سلامت پوست و

به گزارش پایگاه خبری پهنه پرواز به نقل از روابط عمومی انجمن سینمای جوانان ایران، بنا بر اعلام دبیرخانه این رویداد، متاثر از شرایط جامعه،

سایت عصر ایران در گزارشی به بررسی ۱۰ الگوی نادرست ذهنی پرداخته که مانع رشد فردی میشوند. این خطاهای شناختی میتوانند عملکرد ذهن را منحرف

انجمن سینمای جوانان ایران بهمنظور گسترش آموزش خلاق، ارتقای سطح کیفی دورههای آموزشی و بهرهگیری از توان نیروهای متخصص بومی، برای نخستینبار بهصورت سراسری اقدام

مجمع عمومی و سالانه فدراسیون ورزشهای نابینایان و کمبینایان صبح امروز بهصورت وبیناری در سالن فارسی آکادمی ملی المپیک برگزار شد. به گزارش پایگاه خبری

ملی پوشان بوچیا جهت کسب آمادگی برای حضور در پاراآسیایی 2026 ناگویا وارد اردوی تیم ملی می شوند. به گزارش پایگاه خبری پهنه پرواز به

پوشش سازمان بهزیستی و جویندگان کار به گزارش پایگاه خبری پهنه پرواز به نقل از روابط عمومی سازمان بهزیستی کشور به اطلاع کلیه افراد تحت

تفاهمنامه همکاری بین فدراسیون ورزشهای ناشنوایان و فدراسیون ورزشهای همگانی امضا شد به گزارش پایگاه خبری پهنه پرواز به نقل از روابط عمومی فدراسیون ورزش

آبغوره به عنوان یک چاشنی ترش و کمکالری، میتواند در کاهش وزن موثر باشد، البته به شرطی که در چارچوب یک رژیم غذایی متعادل و

استفاده از الفاظ رکیک و ناسزاگویی در گفتگوهای روزمره، علاوه بر ایجاد فضای منفی و ناپسند، تأثیرات مخربی بر روابط انسانی دارد. چنین سخنانی نه

وقتی کتاب در تاریکی، جانِ تازهای به ما میبخشد شب، تنها وقت خواب نیست؛ لحظهایست برای زیستن واقعی، زمانی که زندگی از هیاهوی روزمره فاصله

سفر، همیشه فقط جابجایی از یک مکان به مکان دیگر نیست؛ گاهی راهی است به درون خود. مسیری که از دل ناآرامیها میگذرد و به

در مواجهه با گرمازدگی، بسیاری افراد به اشتباه برای بهبود حال فرد گرمازده از آبقند، شربت یا نوشیدنیهای شیرین استفاده میکنند. اما متخصصان هشدار میدهند

نویسنده : روح الله قطبی راهنمای گردشگری گردشگری روستایی یکی از انواع گردشگری پایدار است که شامل سفر به روستاها برای تجربه فرهنگ محلی، طبیعت

هر گونه امیدی پسندیده نیست. برخی از امیدها نه تنها مایۀ رشد و پیشرفت انسان نمیشوند، بلکه به طور جدّی به او آسیب میزنند. چنین

به گزارش پایگاه خبری پهنه پرواز به نقل از روابط عمومی سازمان بهزیستی کشور #حقپرستاری تیر ماه 1404 افراد #ضایعهنخاعی تحت پوشش #سازمانبهزیستی به #حسابکارت

به گزارش پایگاه خبری پهنه پرواز به نقل از روابط عمومی کمیته ملی پارالمپیک و به نقل از سایت فدراسیون نابینایان و کم بینایان، دور

نشست مسئولین فدراسیون ورزش های جانبازان و توان یابان با فدراسیون وزنه برداری برگزار شد. به گزارش پایگاه خبری پهنه پرواز به نقل از روابط

در چهارمحال و بختیاری، همزمان با گرامیداشت هفته بهزیستی، ۱۳۰ طرح مختلف بهزیستی به بهرهبرداری رسید که در راستای ارتقای سطح خدمات اجتماعی و رفاهی

خراسان رضوی با ارائه بیش از ۶ هزار فرصت شغلی مناسب، شرایط بهتری را برای مددجویان تحت پوشش بهزیستی فراهم کرده است. این اقدامات در

یلاق آغوزحال در استان مازندران، یکی از مناطق زیبا و کمتر شناختهشده است که طبیعتگردان حرفهای بهدنبال تجربه آرامش و زیباییهای ناب آن هستند. این

عشق، یکی از پیچیدهترین و زیباترین احساسات انسانی است که میتواند زندگی انسان را دگرگون کند. اما گاهی این احساس به شکل بیقراری و ناپایداری

جهان معاصر با بحران عمیق درک و فهم مواجه است. بهنظر میرسد انسان امروز، هرچند به انواع اطلاعات دسترسی دارد، اما از توانایی درک متون

بحران پسماند در ایران به مسئلهای گسترده، ولی کمتوجهشده تبدیل شده است. بر اساس گزارشها، روزانه بین ۵۵ تا ۵۸ هزار تُن زباله شهری و

درمان اوزون واژینال شامل وارد کردن گاز اوزون یا آب اوزوندار به واژن است که با هدف ضدعفونی، کاهش التهاب یا درمان عفونتهای خاص واژینال

در بسیاری از فرهنگها باورهایی وجود دارد که روز تولد میتواند بر شخصیت فرد تأثیر بگذارد. مقالهای در وبسایت روزیاتو به بررسی این باورها پرداخته

رئیس سازمان بهزیستی کشور از افزایش چشمگیر یارانه مددجویان این سازمان خبر داد. به گزارش پایگاه خبری پهنه پرواز و بر اساس اعلام رسمی، میزان

یاد نیاوردن برخی مسائل همیشه به معنای ضعف حافظه یا ابتلا به بیماریهایی مانند آلزایمر نیست. بسیاری از افراد در زندگی روزمره با فراموشیهای کوتاهمدت

انشا با موضوع اگر یک روز فرصت زندگی داشتم به صورت ادبی و توصیفی برای دانش آموزان آماده شده تا با نحوه نگارش و مهارت

دبیرخانه جایزه مهرگان ادب فراخوان دورههای بیستوپنجم و بیستوششم این جایزه را منتشر کرد. ناشران و نویسندگان میتوانند آثار چاپ اول خود در زمینه رمان

بیماریهای قلبی–عروقی همچنان یکی از اصلیترین عوامل مرگومیر در ایران به شمار میروند؛ بهطوریکه حدود ۴۰ درصد از مرگهای سالانه کشور ناشی از این بیماریهاست.

روزنو: مدیرکل بهزیستی مازندران از افزایش ۴۱ درصدی مستمری مددجویان بهزیستی در سال جاری خبر داد و گفت: این افزایش در سطح سراسر کشور اعمال

امروزه استفاده از گوشیهای هوشمند به بخشی جداییناپذیر از زندگی روزمره تبدیل شده است. با وجود مزایای بیشمار این ابزارها، تحقیقات جدید نشان میدهند که

آب، یکی از ضروریترین عناصر برای حیات انسان است و بسیاری از افراد برای اطمینان از سلامت آن، به جوشاندن آب روی میآورند. اما این

موسیقی، هنری کهن و جهانی، همواره بخشی جداییناپذیر از زندگی انسانها بوده است. فراتر از جنبه هنری و سرگرمی، موسیقی میتواند تأثیر چشمگیری بر روحیه،

شهر قاهره میزبان مسابقات قهرمانی جهان پاراوزنه برداری است مسابقات قهرمانی جهان پاراوزنه برداری به میزبانی شهر قاهره در کشور مصر از ۱۷ تا ۲۶

ارائه خدمات تخصصی شامل:

با شروع فصل تابستان و افزایش دما، بسیاری از افراد دچار پرش پرتکرار یا تکرر ادرار میشوند که این مسئله میتواند ناشی از عوامل مختلفی

تکرر ادرار یکی از مشکلات رایج در میان افراد است که میتواند علل متعددی داشته باشد. مصرف زیاد مایعات، عفونتهای دستگاه ادراری، دیابت، مشکلات عصبی

محققان دانشگاه فناوری سیدنی استرالیا موفق به توسعه فناوری پیشرفتهای شدهاند که با استفاده از یک کلاه ویژه مجهز به حسگرهای EEG، امواج مغزی انسان

مطابق گزارش تازه، میزان بیمههای روایی که ناشی از تعامل انسانها با فناوریهای هوش مصنوعی است، به طور قابل توجهی افزایش یافته است. این روند

آرمین امیریان، هنرمند جوان ایرانی، توانست جایزه نخست بخش عکاسی مفهومی (Conceptual Photography) را در جشنواره بینالمللی موزه هنرهای عکاسی فلوریدا (FMoPA) از آن خود

برایان جانسون، کارآفرین و میلیاردر آمریکایی، با اجرای پروژهای به نام بلوبرینت (Blueprint) تلاش دارد فرآیند پیری را متوقف یا حتی معکوس کند. این برنامه،

بر اساس پژوهشی جدید از دانشگاه علوم پزشکی «کارل لندشتاینر» در اتریش، ارتباط با دیگران باعث افزایش انرژی و نشاط در لحظه میشود، اما چند

اداره سلامت معاونت امور اجتماعی و فرهنگی منطقه ۱۸، روز چهارشنبه ۲۵ تیرماه ۱۴۰۴، به مناسبت هفته بهزیستی و با هدف ارتقای نشاط اجتماعی، افزایش

نخستین اردوی آمادگی تیم ملی فوتبال هفت نفره در کمپ تیم های ملی فدراسیون برگزار می شود. به گزارش پایگاه خبری پهنه پرواز به نقل

حکم سرپرست کاروان ناشنوایان در المپیک ۲۰۲۵ توکیو به علی رغبتی اعطا شد به گزارش پایگاه خبری پهنه پرواز به نقل از روابط عمومی فدراسیون

اردوی آمادهسازی تیمهای ملی کشتی فرنگی و آزاد ناشنوایان برای شرکت در بیستوپنجمین دوره بازیهای المپیک ناشنوایان از ۱۷ مردادماه آغاز خواهد شد. در این

تفاهمنامه همکاری میان کمیته ملی پارالمپیک و سازمان آموزش و پرورش استثنایی با هدف توسعه ورزش دانشآموزان دارای نیازهای ویژه، شناسایی استعدادها و توسعه فکری

موضوع شماره ویژه: روشهای مشارکتی در مداخلات توانبخشی و فناوریهای کمکیمجله JMIR Rehabilitation and Assistive Technologies از پژوهشگران، متخصصان و علاقهمندان دعوت میکند تا مقالات

به گزارش پایگاه خبری پهنه پرواز افراد دارای معلولیت ناشی از جنگ تحمیلی از تجربه روزهای جنگ، احساس رهایی پس از پایان آن و مشکلات

محققان علوم اعصاب معتقدند مغز انسان برخلاف ابزارهای دیجیتال، ظرفیت مشخص و محدودی برای ذخیره اطلاعات ندارد و خاطرات بهصورت الگوهای گسترده در نورونها توزیع

بر پایه جدیدترین ردهبندی جهانی ضریب هوشی (IQ) در سال ۲۰۲۵، ایرانیها با میانگین هوشی ۱۰۶٫۳۰ در جایگاه چهارم جهان ایستادند و بالاتر از بسیاری

رویداد ملی «کتابال» با محوریت کتابخوانی و فعالیتهای خلاقانه فرهنگی، مرداد ۱۴۰۴ با حضور پسران نوجوان ۱۳ تا ۱۸ سال از سراسر کشور برگزار میشود.

متخصصان حوزه روان و جامعهشناسی هشدار میدهند در پی آسیبهای ناشی از جنگ و بحرانهای اخیر، جامعه ایران در معرض ابتلا به «اختلال استرس جمعی»

در راستای آمادهسازی تیم ملی فوتبال ناشنوایان برای شرکت در بیستوپنجمین دوره بازیهای المپیک ۲۰۲۵ توکیو، ۲۹ بازیکن در دومین اردوی آمادهسازی با حضور در

به گزارش پایگاه خبری پهنه پرواز به نقل از روابط عمومی پارالمپیک رکوردگیری پارادوومیدانی بانوان انتخابی تیم ملی در مجموعه ورزشی آفتاب انقلاب با حضور

مطالعات علمی متعددی نشان میدهد که در سالهای ابتدایی تحصیل، تفاوت قابل توجهی در مهارتهای ریاضی بین پسران و دختران وجود ندارد. اما با گذشت

تورستن اسلوک، اقتصاددان ارشد شرکت سرمایهگذاری Apollo Global Management، درباره حباب بزرگ حوزه هوش مصنوعی هشدار داد که ممکن است پیامدهایی بدتر از سقوط شرکتهای

مقالهای که در سایت «هشتینو» منتشر شده است، به بررسی نقش هوش مصنوعی در تحلیل و رمزگشایی فعالیتهای مغزی هنگام مکالمه میپردازد. پژوهشگران با استفاده

نتایج یک پژوهش نشان میدهد تمرینات ذهنآگاهی گروهی میتوانند بهطور مؤثری در کاهش فشارخون بالا، افزایش تابآوری روانی و بهبود کیفیت زندگی نقش داشته باشند.

اردوی غیرمتمرکز تیم ملی پاراوزنهبرداری جوانان در بخش مردان، با هدف آمادهسازی برای حضور در رقابتهای پاراآسیایی جوانان ۲۰۲۵ دبی، از ۲۸ تیرماه آغاز شد.

برنامه ملی استعدادیابی والیبال بانوان ناشنوای کشور با هدف شناسایی چهرههای توانمند و آمادهسازی تیم ملی، به میزبانی استان قزوین و با نظارت مستقیم ندا

ارزیابیهای تخصصی ملیپوشان تیمهای بسکتبال با ویلچر بانوان و آقایان، با بهرهگیری از فناوری هوش مصنوعی و سیستمهای پیشرفته بیورزونانس، در اردوی اخیر فدراسیون ورزشهای

روانشناسان تاکید دارند خانوادهها با فراهم کردن تجربههای واقعی چالش و آموزش مهارتهای مقابلهای میتوانند تابآوری روانی کودکان را تقویت کنند؛ این امر در مواجهه

به گزارش پایگاه خبری پهنه پرواز، ابوالفضل پورعرب، بازیگر ماندگار سینمای ایران در دهه ۶۰، در مراسمی ویژه و با حضور جمعی از چهرههای برجسته

به گزارش پایگاه خبری پهنه پرواز، افزایش استفاده کودکان و نوجوانان از چتباتها و دوستهای دیجیتال مبتنی بر هوش مصنوعی، زنگ خطری جدی برای رشد

مرگ خاموشی که با فشارخون بالا آغاز میشود به گزارش پایگاه خبری پهنه پرواز، خونریزی مغزی یکی از خطرناکترین انواع سکته مغزی است که میتواند

به گزارش پایگاه خبری پهنه پرواز، ششم مردادماه سال جاری، همدان میزبان مراسم گرامیداشت ثبت جهانی هگمتانه خواهد بود؛ رویدادی فرهنگی و تاریخی که با

به گزارش پایگاه خبری پهنه پرواز، تجربه کمردرد در ساعات اولیه صبح برای بسیاری از افراد آشناست؛ دردی که ممکن است در ابتدا شدید باشد

بازگشت یک محقق ایرانی از خارج کشور از طریق برنامه «کانکت» معاونت علمی، منجر به طراحی و تولید دو فناوری پیشرفته در حوزه جراحی ستون

پس از چند مرحله رقابت دروناردویی، چهار دختر تکواندوکار کشورمان برای حضور در المپیک ناشنوایان ۲۰۲۵ ژاپن معرفی شدند. به گزارش پایگاه خبری پهنه پرواز،

رکوردگیری پارادوومیدانی آقایان به منظور انتخاب نهایی تیم ملی برای حضور در مسابقات جهانی هند و پاراآسیایی امارات امروز در حال برگزاری است. به گزارش

از انوشیروان، پادشاه بزرگ ساسانی، چندین پندنامه در دست است. دو مورد از مهمترین پندنامههای او به «پندنامۀ تاج» و «پندنامۀ دخمه» معروف هستند. پندنامۀ

به گزارش پایگاه خبری پهنه پرواز، کودکانی که در مفاهیم پایه و محاسبات ریاضی مشکلی ندارند اما در حل مسئلههای کلامی دچار ضعف هستند، نیازمند

به گزارش پایگاه خبری پهنه پرواز، مستند علمی «انسان» با تکیه بر فناوریهای نوین تصویربرداری و دادههای فسیلی، چهره گونههای مختلف انسانتبار را بازسازی کرده

به گزارش پایگاه خبری پهنه پرواز، پژوهشگران روانشناسی معتقدند اختصاص دادن زمان به تفریح و فعالیتهای لذتبخش میتواند احساس خوشبختی و رضایت را در زندگی

جلسه نقد و بررسی کتاب «کشف ایران» تالیف علی میرسپاسی و ترجمه رامین کریمیان از سوی نشر نی برگزار میشود. به گزارش پایگاه خبری پهنه

به گزارش پایگاه خبری پهنه پرواز، پژوهشگران علوم اعصاب میگویند مغز انسان، برخلاف حافظه کامپیوتر یا گوشی هوشمند، از یک سیستم ذخیرهسازی بینهایت برخوردار نیست

به گزارش پایگاه خبری پهنه پرواز، شیوع بالای اختلالات روانپزشکی در ایران، همزمان با کمبود دارو و انگ اجتماعی، سلامت روانی جامعه را با چالشهای

به گزارش پایگاه خبری پهنه پرواز، نتایج یک مطالعه تازه نشان میدهد که قرارگیری کودکان در معرض حتی سطوح پایین از عنصر سمی سرب، میتواند

حمام چهار فصل اراک یکی از آثار تاریخی این شهر است که در دوران احمد شاه قاجار تاسیس شده است . ثبت در فهرست آثار

به گزارش پایگاه خبری پهنه پرواز یارانه نقدی مرحله ۱۷۳ مربوط به تیرماه ۱۴۰۴ به حساب سرپرستان خانوارهای دهکهای اول تا سوم در سراسر کشور

ورزشکاران تیم ملی بسکتبال با ویلچر مردان و بانوان کشورمان در آزمایشگاه های تخصصی پژوهشگاه تربیت بدنی و علوم ورزشی و فدراسیون مورد ارزیابی قرار

فیلم «آهو» به کارگردانی هوشمند میرفخرایی، نهتنها یک درام روانشناختی بلکه سفری درونی در میان لایههای فراموشی، خاطرات، هویت و ناپایداری ذهن است. روایتی هنرمندانه

در آستانه چهلوپنجمین هفته بهزیستی، یارانه مددجویان بهزیستی و کمیته امداد با رشدی بیسابقه به میزان ۵۶ درصد افزایش یافت؛ اقدامی که در کنار افتتاح

تبدیلشدن به نسخهای بهتر از خود، نیازمند معجزه یا تغییرات ناگهانی نیست. تنها کافیست با نگاهی آگاهانه و قدمهایی مستمر، سبک زندگی، ذهنیت و عادتهای

والدین آیندهنگر، فرزندان خود را برای عصر هوش مصنوعی تربیت میکنند در جهانی که هوش مصنوعی با سرعتی فزاینده در حال دگرگونی صنایع و زندگی

هورمون کورتیزول که بیشتر با استرس مزمن شناخته میشود، تأثیر مستقیمی بر عملکرد تخمدان و باروری زنان دارد. تحقیقات نشان میدهد که کاهش سطح این

✍️ اشتباهاتی که نویسندگان کودک باید کنار بگذارند نوشتن برای کودکان، آسان به نظر میرسد؛ اما در واقع، یکی از دشوارترین و تخصصیترین شاخههای نویسندگی

به گزارش پایگاه خبری پهنه پرواز به نقل از روابط عمومی فدراسیون ورزش های جانبازان و توان یابان، ششمین مرحله اردوی آمادگی تيم ملی پاراشنا

نشست هماهنگی کارگروه توسعه جنبش پارالمپیک با مسئولین فدراسیون ورزش های نابینایان و کم بینایان برگزار شد. به گزارش پایگاه خبری پهنه پرواز به نقل

پنجمین مرحله اردوی آمادگی تیم ملی #فوتبال نابینایان و کم بینایان کشورمان، از بیستوهشتم تیرماه تا پنجم مردادماه در استان مازندران برگزار خواهد شد. به

جلسه هیات ورزشهای ناشنوایان شمال شرق تهران با محوریت برنامههای ورزشی برگزار شد.به گزارش پیشرو ورزش، در روز دوشنبه ۲۳ تیرماه ۱۴۰۴, جلسهای با حضور اعضای

نام ایران در میان ۲۰ مقصد برتر گردشگری جهانی نشست ایران، با پشتوانهای از فرهنگ، تاریخ و ظرفیتهای بکر گردشگری، توانست نام خود را در

دوستیهای سالم، پایهگذار رشد اجتماعی و عاطفی کودکان هستند. در این گزارش، به روشهای مؤثر آموزش مهارتهای دوستیابی به کودکان در محیط مدرسه و نقش

صبح امروز نشست شورای فنی پارادو ومیدانی به میزبانی کمیته ملی پارالمپیک برگزار شد. به گزارش پایگاه خبری پهنه پرواز به نقل از روابط عمومی

هشتمین سالگرد درگذشت نخستین زن برنده مدال فیلدز، فرصتی است برای مرور زندگی الهامبخش و دستاوردهای ماندگار مریم میرزاخانی؛ زنی که مرزهای علم و جنسیت

اضطراب احساسی طبیعی است، اما وقتی بیامان و مداوم باشد، زندگی فرد را از ریشه میلرزاند. در این گزارش، با نگاهی تحلیلی به ابعاد مختلف

در دنیای پیچیده و پرتلاطم امروز، کسبوکارها برای بقا و پیشرفت نیازمند استراتژیهای نوآورانه و متناسب با شرایط جدید هستند. در این گزارش، سه راهکار

در مسیر پرتلاطم کنکور، گاه بدن خسته است، گاه ذهن، و گاهی روح. درک تفاوت این سه خستگی میتواند راهی تازه برای عبور از فشارهای

مجموعه شعر «باران کبوتر» از محمدرضا سهرابینژاد ، شاعر پیشکسوت کشورمان به بازار کتاب آمد. به گزارش پایگاه خبری پهنه پرواز به نقل از خبرگزاری

در سالهای اخیر، بسیاری از والدین و معلمان از خستگی همیشگی نوجوانان دهه هشتادی (متولدین دهه ۱۳۸۰ به بعد) گلایه میکنند. به گزارش پایگاه خبری

تا به حال برایتان پیش آمده که در حال تماشای یک سریال باشید و درست در لحظهای حساس قسمت تمام شود؟ یا کتابی را نیمهکاره

به گزارش پایگاه خبری پهنه پرواز به نقل از روابط عمومی عمومی ورزشهای جانبازان و توانیابان، با هدف ارتقای سطح علمی و تخصصی ورزشکاران تیم

در ویژهبرنامهای با عنوان «سینما زیر آتش»، با حضور مسعود اطیابی (کارگردان) و طهماسب صلحجو (منتقد سینما)، درباره نقش سینما و رسانه در ایام جنگ

باستانشناسان در گواتمالا موفق به کشف یک مقبره سلطنتی متعلق به ۱۶۰۰ سال پیش شدند که به تمدن مایا تعلق دارد. این کشف در یکی

شرکت هندی QWR از معرفی Humbl، نخستین عینک هوشمند مبتنی بر هوش مصنوعی ساخت هند، خبر داد. به گزارش پایگاه خبری پهنه پرواز این عینک

با پایان درگیریهای نظامی، نبردی دیگر در ذهن مردم آغاز میشود؛ نبردی با خاطرات تلخ، ترسها و اندوهی که کمتر دیده میشود اما پایدار است.

جلیل کوهپایهزاده، رئیس فدراسیون جانبازان و توانیابان، اعلام کرد که در حال حاضر شرایط برای اعزام تیم ملی والیبال نشسته مردان به آمریکا فراهم نیست.به

مطالعهای تازه نشان میدهد نوجوانان بهطور فزایندهای در حال فاصله گرفتن از شبکههای اجتماعی هستند. یافتههای این تحقیق که در سطح جهانی و توسط شرکت

به گزارش پایگاه خبری پهنه پرواز تاریخ آنطور که خواندهایم، تصویر کاملی ارائه نمیدهد. اخیراً کشفیات جدیدی منتشر شدهاند که حکایت از تواناییها و دانشهای

امروز شنبه ۲۱ تیر ۱۴۰۴ – نشست هماهنگی المپیاد استعدادهای برتر ویژه ورزشهای جانبازان و توانیابان ، با حضور مژگان نصیری نایبرئیس بانوان و مجید

دبیرکل فدراسیون با عباسعلی اسدی، دروازهبان ملیپوش تیم ملی فوتسال ناشنوایان ایران، اهل استان سمنان دیدار و قهرمانی در مسابقات جهانی ایتالیا را تبریک گفتند.

ملی پوشان تیم های #گلبال و #پاراجودو مرحله جدید تمرینات خود را آغاز کردند. به گزارش پایگاه خبری پهنه پرواز به نقل از روابط عمومی

در روزگاری که محدودیت میتواند برای بسیاری به بنبست تبدیل شود، «مرجان محمدی» با تکیه بر هنر، اراده و پشتکار، نهتنها از سد موانع عبور

فیلم ماندگار «باشو، غریبه کوچک» به کارگردانی و نویسندگی بهرام بیضایی، پس از چهار دهه، بار دیگر توجه جهانیان را به خود جلب کرده و

«باران فراموشی» نوشته نائومی سلمان به گزارش پایگاه خبری پهنه پرواز به نقل از خبرنگار خبرگزاری کتاب ایران (ایبنا)، کتاب «باران فراموشی» داستانی بلند در ژانر علمی –

با گسترش استفاده از هوش مصنوعی در زندگی روزمره، این فناوری اکنون به حوزه سلامت روان نیز وارد شده است. برخی کاربران در تلاش برای

بازی شطرنج که قرنهاست بهعنوان ورزشی ذهنی شناخته میشود، حالا بیش از هر زمان دیگری توجه متخصصان علوم اعصاب و سلامت شناختی را به خود

در جهان امروز، جنگها دیگر تنها با انفجار، خون و دود تعریف نمیشوند؛ پسلرزههای خاموش اما ماندگارتری در ذهن و روان انسانها باقی میمانند که

در شرایط بیثبات اقتصادی، بحرانهای اجتماعی، بلایای طبیعی یا شوکهای سیاسی، بسیاری از کسبوکارها دچار فرسایش، ورشکستگی یا توقف رشد میشوند. با این حال، شرکتهایی

در یکی از مهمترین دستاوردهای میراث فرهنگی ایران در سالهای اخیر، مجموعه سکونتگاههای غارهای «هجیج» در استان کرمانشاه، که شواهدی از زندگی انسان در بیش

اضطراب اجتماعی یکی از چالشهای پنهانِ دنیای نوجوانان امروز است که ممکن است بهسرعت تبدیل به مشکلی جدی برای رشد شخصیتی آنها شود. به گزارش

ملی پوشان جوان کشورمان با همراهی فدراسیونهای مربوطه و کادر فنی در حال آماده سازی برای شرکت در این بازی ها هستند. بازی های پاراآسیایی

برگزاری مراسم تعزیه امام حسین(ع) در دهه محرم یکی از سنتهای دیرینه مذهبی مردم میباشد که در همهی شهرهای استان به خصوص روستای تاریخی و هدف گردشگری وفس کمیجان رواج دارد.

ما برای شناختن خودمان میتوانیم از روشهای مختلفی استفاده کنیم. یکی از این روشها خودشناسی تباری است. خودشناسی تباری یعنی این که بدانیم که خانوادۀ

نفرات برتر، مسابقات قهرمانی کشور و انتخابی تیم ملی بدمینتون بانوان ناشنوایان معرفی شدند. به گزارش پایگاه خبری پهنه پرواز به نقل از روابط عمومی

,بر اساس گزارش پایگاه خبری پهنه پرواز بازگرداندن اعتماد در رابطهای که آسیب دیده، فرآیندی زمانبر و حساس است. این کار نیازمند تلاش دو سویه

پژوهشگران دانشگاه فنی کاتالونیا در اسپانیا با بررسیهای علمی و محاسبات جغرافیایی، موفق شدند نقطه مرکزی دقیق کره زمین را شناسایی کنند. این نقطه بهعنوان

سازمان بیمه سلامت ایران جزئیات جدیدی از خدمات درمانی سرپایی تحت پوشش این بیمه را اعلام کرد. این خدمات با هدف کاهش هزینههای درمانی و

نویسنده: تاپاتریشا داسفراموشی گاهبهگاه، مخصوصاً با افزایش سن، امری طبیعی است اما گاهی ممکن است نشانهای از مشکلات جدیتر باشد که نیاز به پیگیری پزشکی

یکی از باورهای رایج درباره چای و نوشیدنیهای گرم این است که جوشاندن مجدد آب میتواند سلامتی را به خطر بیندازد. گفته میشود که جوشاندن

سندرم پیش از قاعدگی یا PMS، مجموعهای از علائم جسمی، روانی و رفتاری است که معمولاً یک تا دو هفته پیش از شروع قاعدگی بروز

در سالهای اخیر، گروه قابل توجهی از نوجوانان بهصورت داوطلبانه تصمیم گرفتهاند استفاده از گوشیهای هوشمند و تبلت را محدود کنند تا سلامت روانی خود

در بسیاری از کشورهای جهان، چراغ راهنمایی سبز رنگ به معنای «حرکت» است. اما در ژاپن، چراغی که به این منظور روشن میشود، بیشتر به

پژوهشگران دانشگاه توکیو موفق به توسعهی یک سامانهی پیشرفته مبتنی بر هوش مصنوعی شدهاند که میتواند تنها با تحلیل تصاویر سادهی رادیولوژی (اشعه ایکس)، بهصورت

جلسه دکتر کوهپایه زاده رئیس فدراسیون با رئیس دانشگاه علوم توانبخشی و سلامت اجتماعی برگزار شد. به گزارش پایگاه خبری پهنه پرواز به نقل از

آقای مصطفی نکو لعل آزادرئیس فدراسیون ورزشهای ناشنوایان جمهوری اسلامی ایران درود گرم ما را از کنفدراسیون ورزشهای ناشنوایان آسیا و اقیانوسیه پذیرا باشید. کنفدراسیون

به گزارش پایگاه خبری پهنه پرواز به نقل از ایسنا، پژوهش جدیدی نشان میدهد که مغز نوزادان تازهمتولد شده تا هفتهها پس از تولد برای

به گزارش پایگاه خبری پهنه پرواز به نقل از خبرگزاری مهر، روانشناس و درمانگر شناختهشده در گفتوگویی اختصاصی، تجربه خود از تحمل ۱۲ روز اضطراب

خلاصه مطلباگر صبحها با قلبی تندتپ، ذهنی پرآشوب یا حالتی گنگ و نگران از خواب بیدار میشوید، احتمال دارد دچار اضطراب صبحگاهی باشید. این حالت

خلاصه مطلبدر میان تمام دروس رسمی، یکی از مهمترین مهارتهایی که کودکان باید یاد بگیرند نه در کتابهای درسی آمده، نه در آزمونهای مدارس سنجیده

خلاصه مطلبکتاب «آموزش قصهنویسی» نوشته محمدرضا سرشار، نویسنده و منتقد ادبی شناختهشده، توسط انتشارات سوره مهر منتشر شد. این اثر گامی عملی برای آموزش اصولی

خلاصه مطلبتحقیقات جدید نشان میدهد که خواب کافی، کلید اصلی تقویت حافظه، تمرکز و یادگیری مؤثر است. برخلاف تصور رایج، بیشتر مطالعه کردن لزوماً یادگیری

خلاصه مطلبگردشگری فقط سفری برای دیدن مناظر تازه نیست؛ این صنعت نقش محوری در ترویج صلح پایدار، گفتگوهای فرهنگی و همزیستی مسالمتآمیز در جهان امروز

خلاصه مطلبآیا تاکنون از خود پرسیدهاید چرا تقریباً تمام آسانسورها یک آینه دارند؟ این عنصر ساده و براق، تنها برای گرفتن سلفی یا چک کردن

اولین مرحله از تمرینات تیم ملی #پارادو_ومیدانی برای آمادگی حضور در بازی های پاراآسیایی آیچی-ناگویا ۲۰۲۶ به صورت غیر متمرکز برگزار می شود. به گزارش

نخستین مرحله اردوی آماده سازی تیم ملی شنا ناشنوایان برای حضور در بازی های المپیک ژاپن آغاز شد. به گزارش پایگاه خبری پهنه پرواز به

چالشهای اصلی: فرزاد بایرامی (کارشناس آموزش): نتیجه کنکور تحت شرایط فعلی بازتابدهنده عوامل روانی، اقتصادی، اجتماعی و سیاسی است، نه صرفاً تلاش فردی فرنوش اصلیپور

استان خوزستان با تنوع قومی – تاریخی – زیستی خود، جلوههای گوناگونی از میراث معنوی را عرضه میکند: از نغمههای موسیقی محلی عربی، لری، بختیاری،

سرمربی تیم ملی تکواندو ناشنوایان برنامه پیش بینی شده برای آماده سازی این تیم تا زمان اعزام به المپیک ۲۰۲۵ را تشریح کرد و گفت

ثبتنام سیزدهمین دوره آزمون استخدامی متمرکز دستگاههای اجرایی کشور از تاریخ 11 تیر 1404 آغاز شده و تا پایان روز 20 تیر 1404 ادامه خواهد

به گزارش پایگاه خبری پهنه پرواز به نقل از روابط عمومی فدراسیون ورزشهای جانبازان و توان یابانچهارمین مرحله تمرینات آمادهسازی تیم ملی بسکتبال 3 نفره

بیشتر خانوادهها به دنبال راهی مؤثر برای آمادهسازی فرزندانشان در مسیر یادگیری خواندن هستند. یکی از سادهترین اما مؤثرترین راهکارها، بلندخوانی کتاب برای کودک است.

نوشیدن آب ساده برای جبران مایعات از دسترفته بدن در هوای گرم کافی نیستنوشیدن آب ساده برای جبران مایعات از دسترفته بدن در هوای گرم

دو هفته غیبت یا فاصله گرفتن از درس خواندن، میتواند برای دانشآموزان یا دانشجویان چالشبرانگیز باشد. به گزارش پایگاه خبری پهنه پرواز وقفه ممکن است

خوشنویسی در ایران نه تنها یک هنر زیبا بلکه بخشی جداییناپذیر از میراث فرهنگی این سرزمین به شمار میرود که با ادبیات فارسی، مفاهیم دینی

ژوزه ساراماگو، نویسنده پرتغالی برنده نوبل، با رمان «کوری» تصویری تکاندهنده از فروپاشی اخلاق و تمدن ارائه میدهد. این رمان که در سال ۱۹۹۵ منتشر

نویسنده : اریک دالزهمه ما این حس را تجربه کردهایم: وقتی کودک بودیم، تابستانها بیپایان به نظر میرسید، اما حالا انگار سالها با سرعت برقمانند

سرویس سلامت | پایگاه خبری پهنه پروازپیشیائسگی مرحلهای طبیعی از زندگی زنان است که به دلایل فرهنگی و علمی، کمتر مورد توجه قرار گرفته است.

انجمن شطرنج فدراسیون ورزش های جانبازان و توان یابان مسابقات آنلاین این رشته را برگزار کرد. به گزارش پایگاه خبری پهنه پرواز به نقل از

پیام تبریک سخنگوی دولت، دستیار اجتماعی رئیسجمهور و معاون امور زنان و خانواده رئیس جمهور به مناسبت قهرمانی تیم ملی فوتسال ناشنوایان ایران در مسابقات

اولین مرحله از تمرینات ملی پوشان تیم بسکتبال با ویلچر جوانان از امروز ۱۶ تیرماه آغاز شد. به گزارش پایگاه خبری پهنه پرواز به نقل

به گزارش پایگاه خبری پهنه پرواز، اصطلاح «قورباغه قورت دادن» در زبان فارسی نمادی است از انجام کارهای سخت و ناخوشایندی که علیرغم بیمیلی، مجبور

پارگی دیسک معمولاً در ناحیه کمر (مهرههای کمری) یا گردن اتفاق میافتد. این بیرون زدگی میتواند به اعصاب مجاور فشار وارد کند و باعث درد، بیحسی، گزگز

سامانه ابداعی محققان تایوانی موسوم به «BrainProbe» از هوش مصنوعی برای تشخیص اسکیزوفرنی با دقت ۹۱ درصد استفاده میکند. به گزارش پایگاه خبری پهنه پرواز

به گزارش پایگاه خبری پهنه پرواز به نقل از ایسنا، یک متخصص قلب و عروق و فوقتخصص آنژیوپلاستی با ارائهی چند توصیهی کلیدی، راهکارهایی برای

به گزارش پایگاه خبری پهنه پرواز، انجمن نابینایان ایران و دفتر فرهنگ معلولین با همکاری سازمانهای دولتی و نهادهای مردمی وظیفه شناس برگزار میکند. پاییز

مطالعهای جدید نشان میدهد در سال ۲۰۲۵، کشورهای قطر (1.7%) و امارات (1.8%) پایینترین نسبت جمعیت بالای ۶۵ سال را دارند—نمادی از جمعیت جوان و

قرص جوشان کلسیم ۵۰۰ میلیگرم پرارین، با فرمولی حاوی کلسیم کربنات، گزینه مناسبی برای تقویت سلامت استخوانها، عملکرد عضلانی و سیستم عصبی است و برای

جذابترین حقایق مهندسی پشت بنای باشکوه تختجمشید پهنه پرواز به نقل از ساعدنیوز گزارش میدهد که تختجمشید، پایتخت بزرگ هخامنشی با نامهای دیگری همچون «صد

پژوهشگران با توسعه ابزاری نوین موفق شدند روند پیری مغز را با دقت بالا اندازهگیری کنند؛ گامی مهم که میتواند به پیشگیری از زوال عقل

مطالعهای تازه نشان میدهد که سرگرمی، پیامک و ناوبری از دلایل اصلی حواسپرتی نوجوانان حین رانندگی هستند. به گزارش پایگاه خبری پهنه پرواز و بر

با نزدیک شدن به فصل تابستان، تغییرات رفتاری نوجوانان و نیاز به استقلال بیشتر آنها، والدین را به چالش میکشد؛ راهکارهای تربیتی مناسب میتواند کمککننده

تعریق در فصل تابستان با افزایش دما، نیاز به تغییرات در برنامه غذایی و سبک زندگی را افزایش میدهد. به گزارش پایگاه خبری پهنه پرواز

پایگاه خبری پهنه پرواز به نقل از دنیای اقتصاد: روزهای اخیر همراه با استرسهای متعدد برای بسیاری از مردم بوده است. کارشناسان روانشناسی و سلامت

شعر حافظ و انعکاس شعارهای ایران؛ پیوند ادبیات و احساس ملی به گزارش پایگاه خبری پهنه پرواز به نقل از ایسنا، شعرهای حافظ همواره جایگاهی

تاثیر دوران پساجنگ بر سلامت روان و عملکرد مغز؛ ضرورت حمایتهای روانی و اجتماعی به گزارش پایگاه خبری پهنه پرواز به نقل از خبر آنلاین،

مکملی برای آرامش، تمرکز و سلامت روان به گزارش پایگاه خبری پهنه پرواز به نقل از نوتری پاد، ویتامینهای گروه B یکی از ارکان اصلی

راهکارهایی ساده و علمی برای بازگشت به وضعیت طبیعی بعد از یک شب بیخوابی به گزارش پایگاه خبری پهنه پرواز به نقل از ایسنا، متخصصان

تأثیر روانیِ توافقهای موقت در دوران جنگ بر جوامع و فرد به گزارش پایگاه خبری پهنه پرواز به نقل از زومیت، روانشناسان میگویند آتشبسهای موقت

به گزارش پایگاه خبری پهنه پرواز به نقل از زومیت؛ پژوهشهای تازه نشان میدهند که نوعی ناهنجاری مغزی–جمجمهای موسوم به “کیاری نوع ۱” ممکن است

نوشته: جاستین جکسونبا وجود توافق کلی میان دانشمندان علوم اعصاب در مورد اینکه حافظههای بلندمدت عمدتاً بر پایه الگوهای اتصال عصبی شکل میگیرند، هنوز در

کودکان نیز مانند بزرگسالان در معرض عوامل استرسزا قرار دارند. اما تجربهی استرس در کودکان، بهویژه در سنین پایین، به شکلی متفاوت و اغلب پنهان

در زندگی روزمره، بسیاری از ما واژههای «لذت» و «شادی» را به جای یکدیگر به کار میبریم؛ اما این دو احساس، اگرچه هر دو مثبتاند،

بررسی دلایل و پیامدهای خشک شدن میراثی ۸هزار ساله چشمهعلی، یکی از کهنترین منابع آبی طبیعی در پایتخت که پیشینهای ۸هزار ساله دارد، این روزها

برداشتی امیدبخش از بیت جاودانه کمالالدین اصفهانی باش تا صبح دولتت بدمدکاین هنوز از نتایج سحر است به گزارش پایگاه خبری پهنه پرواز در این

به گزارش پایگاه خبری پهنه پرواز به نقل از میگنا، طرز فکر رشد (Growth Mindset) مفهومی بنیادین در روانشناسی است که نخستینبار توسط دکتر کارول

به گزارش پایگاه خبری پهنه پرواز به نقل از فرانک آرتا گروه رسانهای شرق:تاریخ سینمای ایران همچنان سرشار از زوایای پنهانی است که پرداختن به

جمشید سهرابی رئیس انجمن #پاراتکواندو برنامه های تیم ملی پاراتکواندو برای حضور در قهرمانی آسیا را تشریح کرد. به گزارش پایگاه خبری پهنه پرواز به

کمیته آموزش و پژوهش فدراسیون ورزشهای جانبازان و توانیابان، کارگاه تخصصی روانشناسی ورزشی با موضوع «عبور از بحران» را به صورت وبینار برگزار میکند. به

در آزمون استخدامی سیزدهم کدام دستگاههای اجرایی اقدام به جذب نیرو میکنند؟ به گزارش پایگاه خبری پهنه پرواز بر اساس دفترچه راهنمای منتشره، فهرست دستگاه

نخستین نشست تخصصی برای هماهنگی و بررسی برنامههای آمادگی سه رشته تیراندازی، کاراته و جودو در آستانه بازیهای المپیک ناشنوایان ۲۰۲۵ در ژاپن، امروز با

نگاهی به ریشه، کاربردها و معنای استعاری این تعبیر فارسی به گزارش پایگاه خبری پهنه پرواز، عبارت «اهل بخیه» در اصل به معنای دوزنده و

اختلال بیشفعالی یا ADHD معمولاً با نشانههایی مثل عدم تمرکز، انرژی بالا، و رفتارهای تکانشی همراه است. اما همین ویژگیها اگر در مسیر درستی قرار

اختلال دوقطبی فقط نوسان خلقی ساده نیست. این بیماری میتواند مثل یک ترن هوایی روح و روان انسان را بالا و پایین ببرد. روزهایی سرشار

گاهی والدین در میانهی یک بحران تربیتی ناگهان به خود میآیند: چرا فرزندم به خواستهاش که “نه” میگویم، جیغ میزند؟ چرا هیچ چیز برایش کافی

کمالگرایی افراطی، گرچه ممکن است در نگاه نخست نشانهای از تلاش برای رشد و پیشرفت باشد، اما در عمل میتواند به روابط خانوادگی، اجتماعی و

به گزارش پایگاه خبری پهنه پرواز، در یک بررسی تازه درباره عملکرد حافظه، محققان دانشگاه رایس به این پرسش پرداختهاند که چرا برخی از رویدادها

آیا جدا خوابیدن میتواند رابطه شما را بهتر کند؟شاید تعجب کنید، اما بسیاری از زوجها برای داشتن خواب بهتر و حفظ رابطهای سالم، تصمیم میگیرند

ابزارهای هوش مصنوعی امروزی در زمینههای مختلفی استفاده میشوند. از مهمترین کاربردهای آنها تکنیک طوفان فکری (Brainstorming) است که در آن تلاش میشود برای حل

متا با جذب چهار دانشمند مطرح OpenAI نشان داد در نبرد هوش مصنوعی هنوز بلندپروازیهایش تمام نشده است. به گزارش پایگاه خبری پهنه پرواز به

موج انفجار در شرایط جنگی میتواند با آسیبهای فیزیکی (مانند پارگی ریه و ضربه مغزی) و روانی (مانند PTSD) سلامت افراد را تهدید کنند. الهه

داشتن خواب کافی و باکیفیت اهمیت زیادی برای سلامت جسم دارد. خواب کافی باعث میشود در طول روز پرانرژی باشید و مغزتان به درستی عمل

بر پایه گزارش تازهای از سازمان جهانی بهداشت (WHO)، نوجوانان بهویژه دختران بیش از هر گروه دیگری در جهان احساس تنهایی میکنند. این گزارش نشان

اختلال استرس پس از سانحه پس از جنگ میتواند تأثیرات عمیقی بر سلامت روان افراد داشته باشد، اما با شناسایی بهموقع علائم، جستوجوی حمایت حرفهای

اگر از صدها دانشآموزی که برای کنکور درس میخوانند بپرسید، اکثر آنها در برهههایی از مسیر با احساساتی روبهرو شدهاند که شبیه یک زنگ خطر

این خاطرات به بیل گیتس یادآوری میکند که انسانها میتوانند حتی با چالشهای عظیم نیز روبهرو شوند. پیامی که بسیاری از ما امروز به آن

رئیس فراکسیون ورزش مجلس شورای اسلامی قهرمانی تیم ملی فوتسال ناشنوایان ایران در پنجمین دوره مسابقات فوتسال ناشنوایان جهان در ایتالیا را تبریک گفت به

امروز نهم تیرماه ۱۴۰۴ و در چهارمین نشست ستاد اجرایی بازیهای پاراآسیایی جوانان دبی ۲۰۲۵ به ریاست دکتر غفور کارگری و با حضور اعضای این

موزهای در انگلستان در کمتر از یک هفته بیش از ۱۰۰هزار دلار برای خرید شاهکار هنری «ترنر» را جمعآوری کرد. به گزارش پایگاه خبری پهنه

هوش مصنوعی فناوری همهجانبهای است و بهشکلهای متفاوتی در زمینههای مختلفی به یاری انسانها میآید؛ برای مثال، ابزارهایی وجود دارند که میتوانند کیفیت زندگی سالمندان

موسیقی، زبانی جهانی است که میتواند احساسات را به بهترین شکل بیان کند و در زمانهای دشوار، همچون دوستی وفادار در کنار ما باشد. به

گلها و برگهای خیس از شبنم، در قابهای ماکروی عکاسی خلاق، به تصاویری رؤیایی و آرامشبخش تبدیل شدهاند که زیبایی طبیعت را نشان میدهند. لوسی

وقتی به بررسی سلامت خود فکر میکنید، احتمالاً به پزشک مراقبتهای اولیه یا دندانپزشک می اندیشید. اما آیا تا به حال به شنوایی خود فکر

اورژانس استان تهران با اعلام یک نشانی اینترنتی و نیز سه شماره تلفن برای جذب نیرو فراخوان داد. به گزارش پایگاه خبری پهنه پرواز به

تاریخچه جواهرات به قدری عمیق و گسترده است که می توان گفت از دیرباز تا کنون نقش مهمی در زندگی انسان ها ایفا کرده اند.

پنهان نیست که «آلفرد هیچکاک» فقید، نهتنها یکی از ستودهشدهترین فیلمسازان تاریخ سینماست، بلکه با لقب «استاد تعلیق» نیز جاودانه شده است. به گزارش پایگاه

قرار است محققان انگلیسی در یک تحقیق جنجالی جدید کد ژنتیک انسان را از ابتدا بسازند. به گزارش پایگاه خبری پهنه پرواز به نقل از

«مرندیز» نام روستایی از توابع بخش «یونسی» شهرستان «بجستان» در استان خراسان رضوی است. به گزارش پایگاه خبری پهنه پرواز به نقل از ایسنا، این

در حالی که نقشه جهان بارها و بارها دستخوش تغییر شده و بسیاری از حکومتها در گذر زمان به خاطرهای دور تبدیل گشتهاند، یازده کشور

فرض کنیم شما یک فضانورد هستید که دور از پایگاه خود روی کره ماه قرار دارید و چراغقوهتان از کار افتاده. ناگهان با جسمی روبهرو

برای رسیدن به حداکثر اثربخشی، باید هوازی را پیش یا پس از وزنه زدن انجام داد؟ پاسخ به هدف شما وابسته است به گزارش پایگاه

آیا استفاده مستمر از هوش مصنوعی در نوشتن و پژوهش، در درازمدت به کاهِش توانایی شناختی و افت هوش واقعی ما منجر میشود؟ به گزارش

هر لبخند، هر گفتوگوی بیدغدغه، و حتی هر جروبحثِ پیشپاافتاده، نشانهای از مقاومتِ شهریست که حیات اش را بازپس گرفته است. این همان “حیاتِ اجتماعی”

طی یک مطالعه جدید، مدلهای رایج «هوش مصنوعی»(AI) در هوش هیجانی از انسانها پیشی گرفتند، با این وجود دانشمندان هشدار میدهند که فراتر از تیتر

استرس بعد از بحران یکی از واکنشهای طبیعی روانی انسان در برابر وقایع شدید، غیرمنتظره و تهدیدکننده است. تجربه اتفاقاتی مانند بلایای طبیعی، تصادف، بیماری

وقتی ارتباطمان را با وب جهانی از دست میدهیم، چگونه میتوانیم در دل خاموشی دوام بیاوریم؟ وقتی هیچ صدایی از بیرون نمیرسد، ذهن خودش شروع

سالگرد نامگذاری کشور عزیزمان ” ایران “ به گزارش پایگاه خبری پهنه پرواز در سال ۱۳۱۴ شمسی طبق بخشنامه وزارت امور خارجه و تقاضای دولت

به گزارش پایگاه خبری پهنه پرواز به نقل از ایسنا/خراسان رضوی گرچه در دنیای امروز، جمعیت و ساختار آن از جمله مهمترین موضوعات مورد توجه در

گفتوگو با یک روانشناس درباره واکنشهای متفاوت روحی در زمان «جنگ» و «آتشبس» به گزارش پایگاه خبری پهنه پرواز به نقل از دنیای اقتصاد –

به گزارش پایگاه خبری پهنه پرواز به نقل از (پانا) – استاد دانشگاه فرهنگیان پردیس شهید بهشتی مشهد در یادداشتی تاکید کرد که باید همگان

به گزارش پایگاه خبری پهنه پرواز به نقل از سایت دلگرم، در دنیای پیچیده و پر از تنوع انسانی، سوالی که همواره ذهن ما را

این کتاب مانیفستی است برای کسانی که در دل تاریکی به جرقهای ایمان دارند که شاید هنوز دیده نشده است بهگزارش پایگاه خبری پهنه پرواز

نویسنده : دکتر کاترینا مککویتعهد به یک عمل خلاقانه میتواند به ساختن یک زندگی پربار و معنادار کمک کند. تحقیقات علوم رفتاری بهوضوح از مزایای

رضایی منفرد، روانشناس بالینی کودک و نوجوان براین باور است که در شرایط جنگ و بحران باید روشهای مراقبت از خود را به بچهها یاد

وزیر تعاون، کار و رفاه اجتماعی اعلام کرد: مرحله سوم طرح کالابرگ الکترونیکی از شنبه هفتم تیر سال جاری با تامین اعتبار به حساب سرپرستان

به گزارش پایگاه خبری پهنه پرواز به نقل از فدراسیون ورزش ناشنوایان دکتر احمد دنیامالی در پیامی قهرمانی تیم ملی فوتسال ناشنوایان ایران در جهان

به گفته یک متخصص طب سنتی ترس زیاد باعث ضعیف شدن کلیهها میشود و شاید تجربه کرده باشید که در مواقع ترس و استرس دچار

حمایت از سالمندان در شرایط جنگی نیازمند توجه به نیازهای جسمی، عاطفی و اجتماعی آنهاست. با تأمین نیازهای اولیه، ایجاد ارتباط عاطفی و فراهم کردن

چگونه میتوانیم بدون افزایش بیش از حد جمعیت در مقاصد محبوب سفر کنیم؟ در این قسمت از برنامه «مناطق هوشمند»، ما به ترانسیلوانیا سفر میکنیم

به گزارش پایگاه خبری پهنه پرواز به نقل از ایرنا- روانشناسان در روزهای سخت همانند جنگ، مبحث «پناهگاه سلامت روان»، را برای ایجاد آرامش و

در بُعد چهارم، قوانین آشنا دیگر کار نمیکنند و آنچه در سه بُعد ممکن نیست، ناگهان ممکن میشود. آمادهاید به این دنیای اسرارآمیز قدم بگذارید؟

کارشناسان حوزه آموزش کودکان هشدار میدهند که نداشتن آمادگیهای پایهای برای یادگیری خواندن، یکی از دلایل اصلی افت تحصیلی در سالهای ابتدایی مدرسه است.به گزارش

در شرایط غیرعادی، پرابهام و استرسزا مانند بحرانهای اجتماعی، بلایای طبیعی یا تهدیدهای مستمر، عملکرد شناختی انسان دچار افتی طبیعی و قابل پیشبینی میشود. به

به گزارش پایگاه خبری پهنه پرواز، دبیرخانه جشنواره ملی «کاما» (کتاب افراد دارای معلولیت ایران) با انتشار فراخوان سومین دوره این رویداد فرهنگی، از تمامی

انتظار از تلویزیون، ایران برزیل را پخش کنید به گزارش پایگاه خبری پهنه پرواز به نقل از روابط عمومی فدراسیون ناشنوایان، برزیل در هر میدانی

به گزارش پایگاه خبری پهنه پرواز به نقل از عصرایران ندانستنِ «چگونه پاسخ دادن»، باعث میشود رابطهای آسیب ببیند یا دلسوزی تبدیل به خشم شود.

از شامگاه جمعه که اسرائیل به ایران عزیز حمله کرده است، بسیاری از ما شرایط جدید و پرتنشی را تجربه میکنیم. این وضعیت، چه مستقیما

دوست داشتن خود، مفهومی است که شاید در نگاه اول ساده به نظر برسد، اما در واقع یکی از عمیقترین و تأثیرگذارترین فرآیندهای روانی است

تهران- ایرنا- خانۀ پدری خواهران اسکندری (لاله و ستاره) که از بازیگران مطرح سینما و تلویزیون هستند در اثر حملات هوایی رژیم صهیونسیتی ویران شده

در عصر دیجیتال، فناوری میتواند به ابزاری مؤثر برای حمایت روانی در بحرانها تبدیل شود. اپلیکیشنهایی مانند Headspace یا Sanvello که مراقبه ذهنی و درمان

در آشوب ناشی از شرایط جنگی، روان انسان بیش از همیشه آسیبپذیر است؛ اما حتی در تاریکی، راهکارهایی برای تابآوری و بازیابی سلامت روان وجود

به گزارش پایگاه خبری پهنه پرواز، فدراسیون ورزش های جانبازان و توان در پیامی مدال آوری ملی پوشان تیم ملی پاراکانو کشورمان در قاره کهن

مغز ما در شرایط استرس بالا مثل جنگ، وارد حالت «بقا» میشود، جایی که تمام انرژیاش را صرف مقابله با خطر میکند و کمتر به

جنگ، آرامش را به تاراج میبرد؛ اما نمیتواند امید را از بین ببرد. چگونه در این شرایط سخت، اضطراب را مهار کرده و به آرامش

یک روانشناس به بیان توصیههایی برای گذران اوقات فراغت کودکان و نوجوانان پرداخت و گفت: تعدادی از والدین به سبب شاغل بودن و نداشتن زمان

آیا میدانید برای حفظ سلامتی واقعا چقدر آب بنوشیم؟ قانون قدیمی ۸ لیوان در روز دیگر معتبر نیست و میزان دقیق نوشیدن آب به عواملی

وقتی صحبت از معلولیت میشود، اغلب نگاهها به محدودیتها معطوف میگردد؛ اما برخی انسانها هستند که این واژه را نه بهعنوان مانع، بلکه بهعنوان بخشی

همزمان با ایام میلاد باسعادت امام هادی علیه السلام و دهه امامت و ولایت اعضای تیم ملی شنا جانبازان و توان یابان در حرم مطهر

در آخرین روز از سفر دکتر کارگری رییس کمیته ملی پارالمپیک ایران به ازبکستان بازدید از امکانات ورزشی شهر سمرقند صورت گرفت. به گزارش پایگاه

زندگی روزمره، با تمام پیچیدگیهایش، بتدریج میتواند به چرخهای تکراری و بیروح تبدیل شود؛ بیدار شدن، کار کردن، خوردن، خوابیدن و دوباره از نو. این

با شرایطی که پیش آمده است و آمارهایی که درباره شیوه های زایمان زنان ایرانی منتشر می شود، نگرانی های جدی درباره سلامت آنها در

به گزارش پایگاه خبری پهنه پرواز محققان مؤسسه تحقیقاتی KITE در دانشگاه UHN، به سرپرستی دکتر کاترین کریون، با همکاری تیمی بینرشتهای، یک مدل مراقبتی

به گزارش پایگاه خبری پهنه پرواز حسن حسننتاج عضو کمیسیون بهداشت و درمان مجلس شورای اسلامی : از تذکر 55 نماینده به وزیر تعاون، کار

به گزارش پایگاه خبری پهنه پرواز به نقل از روابط عمومی فدراسیون ورزش های جانبازان و توانیابان، اردوی متصل به اعزام تیمهای ملی بسکتبال با

هفتمین مرحله از تمرینات تیم ملی #گلبال مردان به میزبانی خرم آباد برگزار می شود. به گزارش پایگاه خبری پهنه پرواز به نقل از روابط

فدراسیون ورزش های ناشنوایان ، فراخوان استعدادیابی برای انتخاب تیم ملی والیبال بانوان ناشنوایان صادر کرد به گزارش پایگاه خبری پهنه پرواز به نقل از

نویسنده: بیژن همدرسی امروز اگر گوش شنوایی باشد شنیدن حرفهای ساده خانوادههای اتیسم سخت نیستاین حرفها ساده و روشن هستند: ما خستهایم… فرسودهایم… و بیش

در روستای بوگر از توابع شهرستان خانمیرزا، تحصیل نه تنها حق مسلم کودکان نیست، بلکه تجربهای است پرمخاطره، آمیخته با ترس، رنج و بیتوجهی. جایی

تعطیلات فرارسیده، هنوز هیچی نشده، بچهها از شدت بیحوصلگی شروع می کنند به غر زدن که «بابا، مامان حوصله ام سررفته چه کار کنم؟» نگران

رئیس انجمن پزشکان کودکان ایران ضمن تشریح شرایط تجویز هورمون رشد برای کودکان، گفت: رشد نهایی هر کودک تا حد زیادی بر اساس ژنتیک او

ترسهای کودکان نیز الگوی روشن و واضحی دارند، چراکه هر مقطع سنی بحرانهای سازگاری یا اضطراب خودش را دارد. به گزارش پایگاه خبری پهنه پرواز

پژوهشگران اپل در تحقیقی تازه دریافتند که عملکرد مدلهای مختلف هوش مصنوعی در حل مسائل پیچیده، شباهتی به انسان ندارد. به گزارش پایگاه خبری پهنه

دکتر فتانه امیری بیستم خرداد ، ۱۰ ژوئن، جهان به احترام و بزرگداشت هنرِ برخاسته از دل فرهنگها، روز جهانی صنایعدستی را جشن میگیرد؛ روزی

لو از چین به عنوان رئیس و علیرضا معمری از ایران به عنوان مسئول کمیته مربیان انتخاب شد در حاشیه رقابتهای قهرمانی آسیا و اقیانوسیه

مسابقات جایزه بزرگ حرکات پایهای برای دختران و پسران ناشنوا و شنوا در سطح ملی برگزار می شود به گزارش پایگاه خبری پهنه پرواز به

آیا شما هم دائماً نگران این هستید که دیگران درباره شما چه فکری میکنند؟ رهایی از نگرانی نظر دیگران میتواند به شما کمک کند تا زندگی آزادتر

سه نشان افتخار و ۸ دیپلم افتخار، جایزههایی است که داوران مسابقه بینالمللی هنرهای تجسمی «لوئی فرانسوا» کشور فرانسه در سال ۲۰۲۴ برای کودکان و

تیم ملی والیبال نشسته بانوان در اولین دیدار خود در رقابتهای قهرمانی آسیا و اقیانوسیه برابر تیم استرالیا به برتری دست یافت. به گزارش پایگاه

یکی از آشکارترین ویژگیها در افراد بسیار باهوش اما ناراحت، تمایل بیشازحد به «بیشفکری» (overthinking) است. ذهن آنها همیشه در حال تحلیل و مقایسه است،

حملات پانیک ممکن است ناگهانی، نگرانکننده و فلجکننده باشند، اما خوشبختانه کاملا قابلدرمان هستند. با ترکیبی از رواندرمانیهای اثباتشده مانند CBT، درمان مواجههای یا ACT

کارشناس مسئول آزمایشگاه کنترل مواد غذایی، با اشاره به مطالعات صورت گرفته به تشریح اثرات ظروف نچسب بر سلامت و ایمن بودن یا نبودن آشپزی

دومین مرحله اردوی تیم ملی بسکتبال با ویلچر 3 نفره آقایان در کمپ تیم های ملی فدراسیون برگزار می شود. به گزارش پایگاه خبری پهنه

مدیرکل میراثفرهنگی، گردشگری و صنایعدستی استان مرکزی از برنامهریزی برای واگذاری کاروانسرای تاریخی ورده به بخش خصوصی با هدف مرمت و بهرهبرداری گردشگری خبر داد.

دومین وبینار از مجموعه وبینارهای پنج گانه کمیته پزشکی پارالمپیک آسیا با محوریت آسیبهای ورزشی و استراتژی های پیشگیری از آن برگزار می شود. علاقه

ندا مولاهویزه سرمربی تیم ملی والیبال بانوان ناشنوایان شد به گزارش پایگاه خبری پهنه پرواز به نقل از روابط عمومی فدراسیون ورزش های ناشنوایان، با

دو مقاله از فعالیتهای جشنواره بینالمللی فیلم پرواز با محوریت توانمندیهای دختران نابینا، در شماره ماه ژوئن مجله معتبر بینالمللی “معلم” پذیرفته شدهاند. در یکی

سندروم سیندرلا، عقده سیندرلا یا اختلال ترس از استقلال همگی به یک مشکل روانشناختی اشاره دارند که در آن زنان از استقلال واقعی میترسند و

کتاب «داریوش خنجی» نوشته جردن مینرز در خانه سینما مورد نقد و بررسی قرار میگیرد. این نشست با حضور علیرضا زریندست، عباس یاری، محمد آلادپوش

پژوهشگران در مطالعهای جدید نشان دادند که «کافئین» مغز ما را حتی در خواب هم بیدار نگه میدارد. به گزارش پایگاه خبری پهنه پرواز به

دبیر کانونهای خدمت رضوی شهرستان ساوه گفت: ۹۰ نفر از زائران اولی، شامل کودکان و افراد دارای معلولیت ذهنی و استثنایی، برای زیارت حضرت علی

هادی رضایی سرمربی تیم ملی از مشخص شدن میزبان مسابقات قهرمانی جهان والیبال نشسته خبر داد. به گزارش پایگاه خبری پهنه پرواز به نقل از

با وجود تلاشهای بی وقفه فدراسیون جهانی تکواندو برای حضور بخش پومسه در بازی های پارالمپیک لس آنجلس ۲۰۲۸، این رشته در دور بعدی بازی

نشستی مشترک با حضور نایبرئیس فدراسیون ورزش ناشنوایان، سرمربی تیم ملی والیبال بانوان ناشنوا و دکتر فتانه امیری، فعال حوزه معلولیت در سطح ملی و

ملی پوشان شنا جانبازان و توان یابان از امروز وارد اردوی تیم ملی می شوند. به گزارش پایگاه خبری پهنه پرواز به نقل از روابط

به گزارش پایگاه خبری پهنه پرواز سازمان بهزیستی با ارائه مشوقهای متنوع، مددجویان را به سمت مشاغل خانگی، کسبوکارهای خورشیدی و مهارتآموزی هدفمند هدایت میکند؛

در بیست سال گذشته ۲۴۰۰ فرد از گونه های مختلف در پارک ملی گلستان تلف شده اند به گزارش پایگاه خبری پهنه پرواز به نقل

الفبا اولین درسی که هر کودکی در زندگی خود می آموزد. اما آموزش آهنگ الفبا برای خانواده هایی که با کودکان کم شنوا یا ناشنوا

تهیهکننده فیلم «صددام» مدعی است روزی از این فیلم به عنوان یک اثر ملی تقدیر میکنند زیرا فیلمش تنها یک کمدی صرف نیست بلکه تلاش

کتاب «رمان نوجوان امروز در بوته نقد بوم گرا» توسط زهرا عباسی پژوهشگر دانشگاه فردوسی مشهد منتشر شد. به گزارش پایگاه خبری پهنه پرواز زهرا

یک مطالعه جدید در دانشگاه ایالتی اوهایو(Ohio) نشان میدهد که مدلهای زبانی بزرگ مانند «چتجیپیتی» و «جمینای» نمیتوانند گلها را مانند انسانها درک و توصیف

به گزارش پایگاه خبری پهنه پرواز به نقل از مهر : دانشیار دانشگاه علوم پزشکی ایران، با اشاره به اهمیت پیشگیری از کلوئید، گفت: این عارضه

تیم های ملی #پارامچ_اندازی جوانان در بخش آقایان و بانوان از امروز تمرینات خود را آغاز می کنند. به گزارش پایگاه خبری پهنه پرواز به

به گزارش پایگاه خبری پهنه پرواز به نقل از روابط عمومی فدراسیون ورزش های جانبازان و توان یابان و به نقل از پایگاه خبری وزارت

سه اثر برجسته از ایران، که پیشتر در جشنواره بینالمللی فیلم پرواز برگزیده و مورد تقدیر قرار گرفته بودند، به جشنواره معتبر Ability Foundation در

سنگکلیه، یکی از بیماریهای شایع است و با رعایت برخی نکات میتوان از ابتلا به این بیماری پیشگیری کرد. به گزارش پایگاه خبری پهنه پرواز

لایف کوچینگ، یا مربیگری زندگی، فرآیندی است که به افراد کمک میکند تا به اهداف شخصی و حرفهای خود دست یابند و کیفیت زندگیشان را

ملاتونین، هورمونی طبیعی که چرخه خواب و بیداری را تنظیم میکند، بهعنوان مکملی محبوب برای بهبود خواب شناخته میشود. اما زمان مصرف آن نقش کلیدی

سبک جدیدی از آموزش در آمریکا با نام جنبش «ریزمدرسهها» محبوبیت فزایندهای پیدا کرده است. به گزارش پایگاه خبری پهنه پرواز به نقل از سایت

نسل امروز، بیش از هر زمان دیگری، تشنهی آموزش واقعی، درکشدن، شنیدهشدن و رشد فردی است. در دنیای پرسرعت و پیچیدهی امروز، آموزش باید پاسخگوی

دوش گرفتن کاری است که اکثر ما حداقل یک بار در روز انجام میدهیم. اما بهتر است صبحها دوش بگیریم یا شبها؟ به گزارش پایگاه

به گزارش پایگاه خبری پهنه پرواز به نقل از آفتابنیوز :محققان آکسفورد ژنی را کشف کردهاند که حساسیت درد را با تقویت سیگنالهای درد در

مراسم بدرقه تیم ملی والیبال نشسته بانوان کشورمان در کنار مزار شهید گمنام برگزار شد. به گزارش پایگاه خبری پهنه پرواز به نقل از روابط

آیا تا به حال تجربه کردهاید که وسط انجام کارهای روزمره، افکارتان بیوقفه هجوم بیاورند؟ گویی دهها صدا در ذهنتان همزمان در حال گفتوگو هستند؛

بازی سایهسازی با نور، روشی سرگرمکننده برای تقویت تخیل و تمرکز کودک است که پیوند احساسی بین والد و فرزند را نیز عمیقتر میکند. به

مدیرعامل انجمن دوستداران تیمره گلپایگان گفت: سنگنگارههای بینظیر تیمره و قلعههای تاریخی گلپایگان به دلیل بیتوجهی اداره کل میراث فرهنگی اصفهان در حال تخریب است.

هنگامی که قلب شما آنطور که باید کار نمیکند، نمیتواند خون را به طور مؤثر پمپاژ کند و باعث تجمع خون در اندامهای تحتانی شما،

«گاسترونومی» (gastronomie) از ادغام کلمات یونانی «gaster» (معده) و «nomas» (قانون) تشکیل شده است. به گزارش پایگاه خبری پهنه پرواز اگرچه «گاسترونومی» در بسیاری از

جذب ورزشکاران مستعد دارای معلولیت(جسمی–حرکتی یا قطع عضو، سن ۸ سال به بالا) تهران – ورزشگاه شهید شیرودی – سالن شهید کلاهدوز – کمپ تیم

مرکز آموزش، سنجش و ارزیابی عملکرد فدراسیون ورزشهای جانبازان و توانیابان، وبینار تخصصی کاربرد هوش مصنوعی در ورزش معلولین را برگزار می کند. به گزارش

نمایش «زندگی بسیار کوتاه است» بر صحنه بینالمللی درخشش میآفریند به گزارش پایگاه خبری پهنه پرواز، برای نخستین بار در تاریخ هنرهای نمایشی، گروهی از

میگویند میان نبوغ و جنون، تنها یک مرز باریک وجود دارد. تاریخ هنر پر است از نامهایی که آثارشان نهتنها جهان را متحول کرده، بلکه

معمار با طراحی خلاقانه “ویلای بید مجنون” در محمدشهر کرج، کلبهای قدیمی را به عمارتی مسکونی-تفریحی تبدیل کرد که ضمن حفظ خاطرات کهن، ارتباطی عمیق

معاون امور توانبخشی بهزیستی سیستان و بلوچستان گفت: تعداد ۵۰ دستگاه تبلت ویژه توانخواهان بهرهمند از خدمات توانبخشی از راه دور، به جامعه هدف در

خوابیدن با جوراب موضوعی است که در شبکههای اجتماعی و بحثهای روزمره درباره سلامت خواب و گردش خون همواره مطرح است. به گزارش پایگاه خبری

تحقیقات جدید نشان میدهد که چاقی با تغییرات در مغز و میکروبیوم روده میتواند منجر به افزایش اضطراب شود. به گزارش پایگاه خبری پهنه پرواز

به گزارش پایگاه خبری پهنه پرواز به نقل از روابط عمومی فدراسیون ورزشهای جانبازان و توانیابان “ملیپوشان والیبال نشسته ایران در مراسم اهدای مدال طلای

این غار در ۱۸ کیلومتری جنوب شهر اراک و در کوه سفید خانی واقع است. وجه تسمه آن، برف فراوان این کوه می باشد که

محل برگزاری رقابتهای مختلف پارالمپیک ٢٠٢٨، برای اولین میزبانی لسآنجلس از این رویداد بزرگ اعلام شد. به گزارش پایگاه خبری پهنه پرواز به نقل از

مدل تابلو نقاشی شیک این روزا دیگه فقط یه وسیله تزئینی نیست، بلکه تبدیل شده به یه عنصر مهم توی دکوراسیون خونههامون. به گزارش پایگاه خبری پهنه پرواز

درحالیکه زاکربرگ Meta AI را بستری عالی برای درآمدهای تبلیغاتی میبیند، کارشناسان حریم خصوصی و روانشناسان در مورد استفاده از آن هشدار میدهند. به گزارش

معاون میراث فرهنگی درباره شائبههای حذف قلعه فلکالافلاک از پرونده ثبت جهانی «دره خرم آباد» توضیحاتی داد و گفت: این قلعه بخشی از پرونده است

بخشیدن دیگران آن هم بعد از آن که دل فرد شکسته شود، کار آسانی نیست؛ ولی لازم است اطلاعات کافی در خصوص روش های بخشیدن

راز بهرهوری خارقالعادهی برخی مدیران فقط در لیست کارها نیست و باید سبک زندگیشان را ببینید تا بفهمید تفاوت از کجا شروع میشود. به گزارش

رفتارهای پرریسک انسانها در شرایط نابرابر و استرسزا، مشابه زنبورها از مکانیزمهای روانشناختی و اقتصادی ریشه میگیرد. به گزارش پایگاه خبری پهنه پرواز به نقل

تلهای عینکی، اکسسوری جدیدی هستند که با الهام از فریم عینک، استایلی خاص، خلاقانه و مدرن ایجاد میکنند. به گزارش پایگاه خبری پهنه پرواز به

«بهترین زمانها بود، بدترین زمانها بود. عصر خرد بود، عصر حماقت بود. دوران ایمان بود، دوران ناباوری بود. فصل نور بود، فصل تاریکی بود. بهار امید

اولین مرحله از تمرینات ملی پوشان تیم #پارادوچرخه_سواری از ۱۷ خرداد ماه به میزبانی مجموعه ورزشی آزادی تهران برگزار می شود. به گزارش پایگاه خبری

برای مدیریت اضطراب در روابط عاشقانه میپردازد و جلوگیری از بروز واکنشهای دوریجویانه از سوی شریک عاطفی این راهکارها را در نظر بگیرید. به گزارش

نوشتهی ایزابلا چیسهمه ما فروتنی را ویژگی مثبتی میدانیم. در دنیایی که خودنمایی زیاد دیده میشود، فروتنی میتواند مثل نفسی تازه باشد. اما گاهی آنچه

بیست و سومین دوره مسابقات قهرمانی کشور #گلبال مردان با معرفی تیمهای برتر به پایان رسید. به گزارش پایگاه خبری پهنه پرواز به نقل از

بقعه شاه قلندر مربوط به اواخر سدهٔ 8 ه.ق – دوره ایلخانی است منتسب به شاه مستنصربالله ثانی امام سی و دوم فرقه قاسم شاهیان اسماعیلیه میباشد که

«کافه های سرگردانی» عنوان نمایشگاه نقاشی «بزرگمهر حسین پور» است که از جمعه 26 اردیبهشت ماه که گالری سهراب برپا شد.نمایشگاه «کافه های سرگردانی» از

هر ساله در اولین روز از ماه ژوئن، جهان به احترام و قدردانی از کسانی که ستونهای اصلی خانواده و جامعه هستند، یعنی والدین، گرد

دوره سواد رسانه ای با هدف ارتقای شناخت ورزشکاران تیمهای ملی والیبال نشسته بانوان و پاراوزنه برداری آقایان از فضای مجازی و رسانه، کلاس آموزشی

سفیر جمهوری ترکیه در ایران، با تأکید بر اشتراکات عمیق فرهنگی و تمدنی دو کشور، روابط ایران و ترکیه را فراتر از همسایگی دانست و

چطور با تغییرات زندگی سازگار شویم و به جلو برویم؟ سوالی است که بسیاری از افراد در مواجهه با تحولات مختلف زندگی با آن روبهرو

به گزارش پایگاه خبری پهنه پرواز به نقل از خبرآنلاین بسیاری از والدین بدون آنکه خود متوجه باشند با برخی روشهای تربیتی نادرست، سطح اضطراب

واقعیت میدانی نشان میدهد، بخش مهمی از فشار روانی نوجوانان، نهفقط از ضعف خانواده، بلکه از ساختار آموزشی ناکارآمد در مدارس خاص نشأت میگیرد. به

مصرف مکملهای ویتامین D برای افرادی که به کمبود این ویتامین مبتلا هستند، میتواند در درمان افسردگیشان موثر باشد. به گزارش پایگاه خبری پهنه پرواز

اولین مرحله از اردوی آمادگی تیم ملی #بسکتبال با ویلچر بانوان از امروز ۱۱ خرداد ماه آغاز می شود. به گزارش پایگاه خبری پهنه پرواز

به گزارش پایگاه خبری پهنه پرواز به نقل از عصر ایران، کیومرث ایراندوست برای شروع این بحث بخشی از کتاب فاولا نوشته جانیس پرلمن را

با وجود افزایش آگاهی عمومی درباره اهمیت سلامت روان، هنوز بسیاری از افراد در مواجهه با خود درمان دچار اضطراب، تردید و نگرانی می شوند.

درباره معنی سووشون داستان سریال سووشون نرگس آبیار به گزارش پایگاه خبری پهنه پرواز به نقل از سایت نمناک، سریال سووشون نرگس آبیار که از

مجله آتلانتیک به قلم شرلی لی، روزنامهنگار برجسته فرهنگی، با نگاهی ژرف و تحلیلی، یکی از پرسشهای قدیمی و همیشگی درباره ادبیات کودک را دوباره

یک استاد جامعهشناسی با اشاره به کاهش سهم محتوای زبان فارسی در فضای آنلاین از سال ۲۰۲۲ تا سال ۲۰۲۵ گفت: زبان فارسی در معرض

نشست مشترک کمیته ملی پارالمپیک و فدراسیون ورزشهای جانبازان و توانیابان در راستای توسعه فکری جنبش پارالمپیک برگزار شد. به گزارش پایگاه خبری پهنه پرواز

به گزارش پایگاه خبری پهنه پرواز به نقل از روابط عمومی کمیته ملی پارالمپیک و به نقل از سایت فدراسیون ورزشهای نابینایان و کمبینایان؛ هفتمین

به گزارش پایگاه خبری پهنه پرواز به نقل از خبرنگارایلنا، امیر رهبر، فعال صندوق بازنشستگی لشکری، در رابطه با چگونگی بهرهمندی بازماندگان معلول بعد از

بخش راهنمای انتخاب ورزشکاران بازی های پاراآسیایی #آیچی_ناگویا۲۰۲۶ در وب سایت کمیته ملی پارالمپیک ایجاد شد. به گزارش پایگاه خبری پهنه پرواز به نقل از

نویسندگی یک شغل است. برای بعضیها حتی یک شغل تمام وقت محسوب میشود. برخی از نویسندهها سالهای سال وقت میگذارند تا اثر خود را بنویسند

اندرو پارسونز در سفر به استرالیا که با هدف دیدار با دستاندرکاران و مقامات در بریزبن و سیدنی انجام شده، تأکید کرد که میزبانی از

رئیس فدراسیون ورزش های جانبازان و توان یابان و معاونت تحقیقات و فناوری دانشگاه تهران تفاهم نامه همکاری و هم افزایی امضا کردند. به گزارش

آواز ایرانی از اصلیترین پایههای موسیقی سنتی ما است؛ هنری که در کنار شعر، احساسات مردم ایران را طی قرنها بیان کرده و با فرهنگ

حس عقبافتادگی در زندگی، که اغلب با مقایسه خود با دیگران یا انتظارات ناتمام همراه است، میتواند به استرس و کاهش سلامت روان منجر شود. بسیاری از افراد،

یک فوقتخصص چشمپزشکی با اشاره به علایم آلرژی چشمی، گفت: مبتلایان به این بیماری معمولا تمایل زیادی به مالش چشمها دارند؛ این درحالیست که مالش

یکی از مشکلات شایع در میان افراد مختلف درد زیر کشکک زانو است که می تواند دلایل متفاوتی داشته باشد و بسته به شدت و نوع درد، راهکارهای

با افزایش شتاب زندگی شهری، آلودگی صوتی، تراکم جمعیت، و استرس محیطی، مفهوم «سلامت روان در طراحی شهری» به یکی از دغدغه های جدی معماران، شهرسازان و

انسانها در طول عمر نسبتاً کوتاه خود به دستاوردهای شگفتانگیزی رسیدهاند. بااینحال در پس این پیروزیهای دستهجمعی، بسیاری از ما همچنان در رسیدن به احساس

به گزارش ایسنا، کتاب «روانشناسی دموکراسی» نوشته دَرِن ج. لیلِکِر و بیلور اَسلان اوزگول با ترجمه نازی اکبری در ۱۵۸ صفحه با شمارگان ۷۷۰ نسخه

امیرعباس علیزمانی، دانشیار فلسفه دانشگاه تهران، در همایش «از شفا تا قانون» به بحران معنای زندگی در دنیای امروز پرداخت. به گفته دکتر علیزمانی، بحران

دنیایی را تصور کنید که در آن نه بردهٔ نوتیفیکیشنها هستید، نه اسیر اسکرول بیپایان شبکههای اجتماعی. جایی که فناوری ابزاری در خدمت شماست، نه

نشست مسئولین فدراسیون ورزش های جانبازان و توان یابان با معاون تربیت بدنی و سلامت وزارت آموزش و پرورش و رئیس فدراسیون ورزش های دانش

اندرو پارسونز در سفر به استرالیا که با هدف دیدار با دستاندرکاران و مقامات در بریزبن و سیدنی انجام شده، تأکید کرد که میزبانی از

به گزارش پایگاه خبری پهنه پرواز به نقل از میراث آریا، سفیر چین در ایران، با ستایش ژرفای تاریخی و جایگاه راهبردی ایران در معادلات

به گزارش پایگاه خبری پهنه پرواز محل زندگی تمساح گاندو سیستان و بلوچستان است. خوشبختانه فرهنگ بالای مردم بلوچ در نگهداری این حیوان سبب شده

تبخال یک عفونت ویروسی شایع است که معمولاً به دلیل ضعف سیستم ایمنی بدن بروز میکند. این ویروس بهویژه در شرایطی که بدن دچار کمبود

به گزارش پایگاه خبری پهنه پرواز به نقل از سایت دانشیاری اضطراب، این هیولای خاموش، میتواند آرام و بیصدا زندگی ما را تسخیر کند. در

سرپرست ادارهکل میراثفرهنگی، گردشگری و صنایعدستی استان کرمان بههمراه اعضای هیئت مدیره انجمن حرفهای راهنمایان گردشگری از اکونوموزه بانو حیاتی کرمان بازدید کرد. به گزارش

هر ماه بیش از دو میلیارد زن در سراسر جهان قاعدگی را پشت سر میگذارند، اما بسیاری از آنها به امکانات کافی برای مدیریت مناسب

دانشمندان میگویند ذرات پوشش داده شده با قند ممکن است از نورونها در برابر بیماری آلزایمر محافظت کنند. به گزارش پایگاه خبری پهنه پرواز به

اولین وبینار از مجموعه وبینارهای پنج گانه کمیته پزشکی پارالمپیک آسیا با محوریت آنتی دوپینگ برگزار شد. به گزارش پایگاه خبری پهنه پرواز به نقل

کمپ تیم های ملی فدراسیون میزبان اردوی آمادگی تیم ملی وزنه برداری جانبازان و توان یابان است. به گزارش پایگاه خبری پهنه پرواز به نقل

تیم ملی #والیبال_نشسته بانوان آماده رقابت های قهرمانی آسیا و اقیانوسیه می شود. به گزارش پایگاه خبری پهنه پرواز به نقل از روابط عمومی کمیته

با دریافت تایید اولیه درمان سلولی ترمیمی جهان، نحوهی درمان آسیب نخاعی وارد مرحلهی تازهای شد. این یک نقطه عطف تاریخی برای یک بیماری لاعلاج

بازی آزاد و بدون قانون مشخص، زمینهساز رشد خلاقیت، استقلال و تصمیمگیری در کودک است. گاهی باید شلختگی را بپذیرید! به گزارش پایگاه خبری پهنه

مهر : رئیس و اعضای هیئت مدیره انجمن متخصصین گوارش و کبد ایران، به مناسبت هفته سلامت گوارش، به علل بروز بیماری ها و سرطان های

به گزارش پایگاه خبری پهنه پرواز به نقل از ایسنا : حسنلو با تأکید بر لزوم غربالگری تیروئید در برخی گروهها از جمله زنان، زنان باردار،

زندگی پرشتاب امروزی، استرس و اضطراب را به بخشی جداییناپذیر از روزمرگیها تبدیل کرده است. فشارهای کاری، مشکلات خانوادگی و حتی اخبار، ذهن را آشوبزده

کمیته برگزاری بازیهای LA۲۸ و «اسنوفلیک»، از همکاری خود در المپیک و پارالمپیک #لس_آنجلس۲۰۲۸ پیشرو خبر دادند. به گزارش پایگاه خبری پهنه پرواز به نقل

مرحله نیمه نهایی مسابقات قهرمانی کشور فوتبال هفت نفره به میزبانی شهر ماهان استان کرمان برگزار شد. به گزارش پایگاه خبری پهنه پرواز به نقل

به گزارش پایگاه خبری پهنه پرواز نگار واشقانی فراهانی، بانوی پرتلاش و افتخارآفرین عضو کانون افراد دارای معلولیت منطقه۱۴ تهران، در چهارمین دوره مسابقات

چهارمین جایزه مستقل ادبی واژه، با معرفی برگزیدگان بخشهای مختلف، به کار خود پایان داد. به گزارش پایگاه خبری پهنه پرواز در همین خصوص مرتضا

طی حکمی از سوی دکتر غفور کارگری رییس کمیته ملی پارالمپیک، دکتر سینا کلهر به عنوان دستیار ارشد رییس کمیته ملی پارالمپیک در امور فرهنگی

ملی پوشان بسکتبال با ویلچر 3 نفره کشورمان از هفتم خردادماه وارد اردوی تیم ملی می شوند. به گزارش پایگاه خبری پهنه پرواز به نقل

عضو هیئت علمی گروه علوم اجتماعی دانشگاه علوم اسلامی گفت: ریشه اصلی طلاق، تنها در انتخاب نادرست همسر نیست، بلکه در نظام تربیتی ناقص، نظام

طبق نظرسنجی جدیدی در بریتانیا نزدیک به نیمی از جوانان آرزو میکنند ای کاش اینترنت هرگز اختراع نشده بود و همیشه آنلاین نبوند. به گزارش

سندروم کودکان دیجیتال زمانی ایجاد میشود که کودکانِ کمتر از ۳ سال ساعات زیادی را در روز در معرض نمایشگرهای دیجیتال باشند. به گزارش پایگاه

رئیس سازمان بهزیستی کشور آخرین تصمیمات این سازمان در خصوص افزایش مستمری معلولان را تشریح کرد. به گزارش پایگاه خبری پهنه پرواز به نقل از

با بالا رفتن سن، بسیاری از ما احساس میکنیم که زمان زودتر میگذرد؛ اما آیا این فقط یک حس است؟ پژوهشی جدید نشان میدهد گذر

به گزارش پایگاه خبری پهنه پرواز به نقل از ايسنا : یک مطالعه جدید، ارتباط بین عادت نشستن طولانیمدت و افزایش خطر زوال شناختی و کاهش

سریال «یزدان» با تمرکز بر آسیبهای اجتماعی شهر تهران، فرصت مناسبی برای گفتوگو درباره ریشههای روانی و اجتماعی بحرانهایی مانند کودکان کار، اعتیاد و زبالهگردی

متخصصانی که یک آزمایش به نام «وایتال» (VITAL) را به مدت پنج سال روی زنان و مردان بالای ۵۰ سال انجام دادند، دریافتند مکملهای «ویتامین دی» ممکن

هفتمین نشست شورای راهبردی فنی کمیته ملی پارالمپیک برگزار شد. به گزارش پایگاه خبری پهنه پرواز به نقل از روابط عمومی کمیته ملی پارالمپیک، نشست

به گزارش پایگاه خبری پهنه پرواز مراسم گرامیداشت دهمین سالروز “موزه و معلولیت”، همزمان با هفته میراث فرهنگی، روز شنبه ۳ خردادماه ۱۴۰۴ در موزه

با حکمی از سوی رئیس فدراسیون ورزش های جانبازان و توان یابان، پورکیانی به عنوان مشاور رئیس در امور استعدادیابی فدراسیون منصوب شد. به گزارش

صبح زود است و با صدای زنگ موبایل از خواب بیدار میشویم، هنوز چشم باز نکرده، دستمان میرود سمت گوشی و نوتیفیکیشنها، پیامها، ایمیلها و

عضو هیات علمی پژوهشکده مغز و علوم شناختی دانشگاه شهید بهشتی نسبت به ابتلای کودکان به «سندرم اوتیسم» پس از مواجهه با وسایل دیجیتال هشدار

سعید روستایی با انتشار یک عکس در کنار پیمان معادی با این دوره از جشنواره کن خداحافظی کرد. به گزارش پایگاه خبری پهنه پرواز به

راههای مختلفی برای افزایش عملکرد هوش مصنوعی مولد و دریافت خروجی موردنظر وجود دارد. «سرگی برین»، همبنیانگذار گوگل، در مصاحبه جدیدی راهکار عجیبی برای این

به گزارش پایگاه خبری پهنه پرواز به نقل از سایت مدیناست ویتامین D یکی از ویتامینهای ضروری برای حفظ سلامت استخوانها، تقویت سیستم ایمنی و

اگر بخواهیم بدون معطلی به این سوال پاسخ بدهیم، باید بگوییم هر دو. در واقع بستگی دارد که در چه معنایی به کار رفته باشد.

به گزارش پایگاه خبری پهنه پرواز به نقل از بهداشت نیوز : عضو هیات علمی دانشگاه علوم پزشکی همدان با تأکید بر اهمیت مراجعه سریع به

تریلر «فقط یک تصادف بود» ساخته جعفر پناهی، فیلمساز ایرانی، روز شنبه موفق به کسب نخل طلای جشنواره فیلم کن در هفتاد و هشتمین دوره

مراسم اعطای جوایز هفتاد و هشتمین جشنواره فیلم کن برگزار شد و برندگان بخشهای مختلف این دوره جشنواره معرفی شدند. به گزارش پایگاه خبری پهنه

زنان بالای 40 سال با سابقه خانوادگی سرطان، علائم غیرعادی یا عوامل خطر، باید فوراً برای غربالگری بیماریهای کشنده اقدام کنند تا از تشخیص زودهنگام

پیروزی تیمهای کرمان، کرمانشاه، فارس و قم در روز نخست رقابتها مسابقات قهرمانی کشور فوتبال هفت نفره به میزبانی شهر ماهان استان کرمان در حال

نویسنده الهام خادم حسینی به گزارش پایگاه خبری پهنه پرواز، الهام خادم حسینی دانشآموخته مدیریت جهانگردی، گردشگری دسترسپذیر را چنین تعریف میکند: “گردشگری دسترسپذیر یکی

کمخوابی نوجوانان تأثیرات جدی بر سلامت روان، عملکرد تحصیلی و تصمیمگیری آنها دارد، اما با ایجاد تغییراتی ساده در روال خواب شبانه میتوان این وضعیت

ستوننویس روزنامه مایرور در مروری ادبی بر «در جستوجوی زمان از دسترفته» اثر مارسل پروست اعتقاد دارد هرچند خواندن این رمان طولانی شاید برای بعضیها

زرین شهراصفهان میزبان پنجمین مرحله از تمرینات تیم ملی #پاراتیراندازیباکمان شد. به گزارش پایگاه خبری پهنه پرواز به نقل از روابط عمومی کمیته ملی پارالمپیک

به گزارش پایگاه خبری پهنه پرواز به نقل از روابط عمومی سازمان بهزیستی کشور حق پرستاری خانواده محور اردیبهشت ماه 1404 #معلولان #جسمی حرکتی #شدید

بر اساس اعلام رسمی کمیته برگزاری بازی های پاراآسیایی جوانان دبی ۲۰۲۵، رشته پارامچ اندازی به جمع رشته های حاضر در بازی های پاراآسیایی جوانان

حمیدرضا حسنآبادی، مدیرکل دفتر مشاوره، سلامت و سبک زندگی سازمان امور دانشجویان: انگیزه که برای تحصیل کم شود، دانشجو دچار افت تحصیلی، مشروطی، انصراف، حذف

به گزارش پایگاه خبری پهنه پرواز به نقل از عصرایران، چهارمین رنگ چراغ راهنمایی طرح پیشنهادی پژوهشگران دانشگاه ایالتی کارولینای شمالی بهمنظور سریعتر و ایمنتر

به گزارش پایگاه خبری پهنه پرواز اگر به دنبال یک سفر کوتاه، ارزان و پر از طبیعت بکر در اطراف تهران برای آخر هفته هستید،

ضعف عضلات کف لگن در بدن انسان، بسیاری از عضلات هستند که ما آن ها را نمی بینیم، اما نقش حیاتی در عملکرد و کیفیت زندگی

اضطراب، همان هیولای خاموشی است که آرام و بیصدا زندگی ما را تسخیر میکند. به گزارش پایگاه خبری پهنه پرواز به نقل از عصر ترکیه

ظاهراً اپل میخواهد پس از انجام آزمایشیهای موردنظرش، اولین نسل عینک هوشمند خود را سال آینده رونمایی کند. به گزارش پایگاه خبری پهنه پرواز به

ملی پوشان تیم بسکتبال با ویلچر مردان کشورمان از امروز وارد اردوی تیم ملی می شوند. به گزارش پایگاه خبری پهنه پرواز به نقل از

ملی پوشان تیراندازی با کمان جانبازان و توان یابان از امروز وارد اردوی تیم ملی می شوند. به گزارش پایگاه خبری پهنه پرواز به نقل

اعظم مهدیزاده، بانوی پرتلاش و الهامبخش، با وجود معلولیت جسمی، نه تنها در عرصه ورزش درخشیده بلکه در راهاندازی و توسعه ورزش بانوان دارای معلولیت

بر اساس نوشتهای از فارلی لجروودآیا تا به حال برایتان پیش آمده که صبح هنگام از خواب بیدار شوید و احساس کنید از همان لحظهی

باباطاهر عریان یکی از بزرگترین دوبیتیسرایان تاریخ ادبیات فارسی است. حالا دست بر محبوبترین شعر او گذاشتهایم که نام او را تا نسلهای جدید به

فراموش کنید قدمشماریهای یکنواخت و هدف روزانه ۱۰هزار قدم را. در میان انبوهی از ترندهای مربوط به سلامت و تندرستی، «پیادهروی ژاپنی» بهخاطر اثربخشی شگفتانگیز

به گزارش پایگاه خبری پهنه پرواز مطالعهای جدید در مجله Frontiers in Pharmacology نشان داده است که اسید تائورورسودئوکسیکولیک (TUDCA)، یک ترکیب طبیعی مشتق از

ملی پوشان بسکتبال با ویلچر مردان کشورمان از فردا وارد اردوی تیم ملی می شوند. به گزارش پایگاه خبری پهنه پرواز به نقل از روابط

با افتخار، به مناسبت روز جهانی تنوع زیستی هفته میراث فرهنگی و همزمان با دهمین سال گرامیداشت «روز موزه و معلولیت»، از شما عزیزان دعوت

انجمن اهدا عضو استان مرکزی طی نشست خبری با اصحاب رسانه به تشریح برنامه های این نهاد پرداخت . به گزارش پایگاه خبری پهنه پرواز

به گزارش پایگاه خبری پهنه پرواز به نقل از مهر : عضو هیات علمی دانشگاه علوم پزشکی ایران با اشاره به نقش مستقیم مصرف بالای نمک

گوگل در کنفرانس I/O که روز گذشته برگزار شد، از ارتقای هوش مصنوعی و افزایش هزینه اشتراک خبر داد و عینکی هوشمند را نیز رونمایی

فراخوانی با عنوان «نوآورانه» از سوی کانون پرورش فکری منتشر شده است تا بر اساس آن کودکان و نوجوانان ایرانی و خانوادهها ایدهها و راهکارهای

نشست عصری با ادبیات اقلیم کردستان پیرامون بررسی کتاب «بندر فِیلی» در شهر کتاب ساری برگزار میشود. به گزارش پایگاه خبری پهنه پرواز به نقل

استاندار لرستان از پیگیری جدی برای ثبت جهانی قلعه فلکالافلاک در تابستان امسال خبر داد. به گزارش پایگاه خبری پهنه پرواز به نقل از خبرگزاری

شـــــاید باورتون نشه، ولی سنجاققفلی که الان توی جعبه خیاطیتون یا پشت پردههای اتاق هست، بیش از ۱۷۰ ساله همینطوره که هست! به گزارش پایگاه

مصرف ویتامین D و K مانع از ابتلا به پوکی استخوان میشود. به گزارش پایگاه خبری پهنه پرواز به نقل از خبرآنلاین از ایسنا، ویتامین

به گزارش پایگاه خبری پهنه پرواز در جریان رویداد اخیر گوگل، این شرکت از نسل جدید عینکهای هوشمند خود با سیستمعامل Android XR پرده برداشت؛

به گزارش پایگاه خبری پهنه پرواز به نقل از روابط عمومی سازمان بهزیستی یارانه کمک معیشتی مرحله ۱۷۱ مربوط به اردیبهشت ماه ۱۴۰۴ به حساب

در فاصله ۲۰۰ روز مانده به آغاز پنجمین دوره بازی های پاراآسیایی جوانان که به میزبانی دبی برگزار میشود، دکتر سعید سلگی معاون ورزش قهرمانی

با تعامل و همکاری فدراسیون شمشیربازی و بهزیستی استان تهران ویلچرهای ویژه رشته #پاراشمشیر_بازی در ایران تولید می شود. به گزارش پایگاه خبری پهنه پرواز

به گزارش پایگاه خبری پهنه پرواز روز ملی بومگردی با هدف پاسداشت فرهنگ، تاریخ، محیط زیست و تغذیه سالم در ایران شکل گرفته است. اقامتگاههای

جعفر پناهی با فیلمی تکاندهنده و انتقامجویانه، پس از مدتی سکوت، بار دیگر درخشید؛ یک تصادف ساده نهتنها پنجرهای تازه به زندگی کارگران و قربانیان

به گزارش پایگاه خبری پهنه پرواز به نقل از ایسنا/فارس با نزدیک شدن به روزهای پایانی ترم، فصل امتحانات برای دانشجویان فرا میرسد؛ دورانی پر از

به گزارش پایگاه خبری پهنه پرواز به نقل از ایسنا دروازه ایشتار هشتمین دروازه بابل است که در حدود سال ۵۷۵ پیش از میلاد به

هر انسانی در طول روز با یک نفر گفتوگوی مداوم دارد: خودش. این مکالمه درونی، که روانشناسان آن را “خودگویی” (Self-Talk) مینامند، یکی از قویترین عوامل شکلدهنده

مرکز فوریتهای پلیسی تهران اعلام کرد: سامانه پیامکی «۱۱۰۱۱۰» با هدف پشتیبانی از شهروندان دارای اختلالات شنیداری یا گفتاری راهاندازی شده است. این افراد یا

گوگل و شرکت Xreal از عینک هوشمندی مبتنیبر پلتفرم اندروید XR پرده برداشتند. به گزارش پایگاه خبری پهنه پرواز به نقل از سایت زومیت در

به گزارش پایگاه خبری پهنه پرواز یک دستگاه ون ویژه معلولان در بزرگراه امام علی دچار نقص فنی شد؛ حادثهای که لزوم نوسازی فوری ناوگان

نشست شورای فنی رشته #پاراشنا در بخش نابینایان و کم بینایان برگزار شد. به گزارش پایگاه خبری پهنه پرواز به نقل از روابط عمومی کمیته

بسیاری از افراد مبتلا به افسردگی، حتی پس از دریافت خدمات رواندرمانی رایج، همچنان با علائم این بیماری دست و پنجه نرم میکنند. این مسئله

به گزارش پایگاه خبری پهنه پرواز به نقل از ایسنا/خراسان رضوی بیماری آلزایمر، یکی از شایعترین بیماریهایی است که افراد مسن در سراسر جهان را تحت

یکی از عواملی که بیشترین تأثیر را بر مسیر زندگی و موفقیت انسان دارد، نه شرایط بیرونی یا موقعیت جغرافیایی، بلکه «طرز فکر» یا همان

رئیس کمیته بینالمللی پارالمپیک (IPC)، در سفر سهروزهای به کامبوج، با مقامات و ورزشکاران پارالمپیکی این کشور دیدار کرد و از امکانات ورزشی بازدید به

«ساتوا»، تأمینکننده رسمی تخت و کالای خواب بازیکنان المپیک و پارالمپیک بازیهای لسآنجلس ۲۰۲۸ شد. به گزارش پایگاه خبری پهنه پرواز به نقل از روابط

رئیس فدراسیون های ورزش های جانبازان و توان یابان و رئیس انجمن مویتای تفاهم نامه همکاری امضا کردند. به گزارش پایگاه خبری پهنه پرواز به

آرتیستبوک علی اکبر صادقی شامل برگزیدهای از آثار این هنرمند پیشکسوت به همراه رونمایی از یک اثر برنزی ملهم از آثار او در گالری ایرانشهر

دو هنرمند منتخب استان مرکزی با هدف معرفی ظرفیتهای صنایعدستی و گسترش تعاملات فرهنگی، به نمایندگی از ایران در نمایشگاه بینالمللی صنایعدستی سلیمانیه شرکت میکنند.

اولین دوره جشنواره استعدادیابی فوتبال پنج نفره بانوان در استان زنجان برگزار شد. به گزارش پایگاه خبری پهنه پرواز به نقل از روابط عمومی فدراسیون

دکتر غفور کارگری، رئیس کمیته ملی پارالمپیک، عصر امروز (یکشنبه ۲۸ اردیبهشتماه) با عباس واحدی، مدیرعامل و رئیس هیأتمدیره صندوق حمایت از قهرمانان و پیشکسوتان

ویتامین B در بدن ساخته نمیشود و به همین دلیل باید آن را از غذاها جذب کنید. در این مطلب میخواهیم با مواد غذایی حاوی

موزهها، دریچهای به گذشته و چراغی برای آیندهاند. امروز، در روز جهانی موزه، با افتخار میراث فرهنگیمان را جشن میگیریم و زیبایی تاریخ را پاس

تسنیم : ۳۲ درصد ایرانیها به فشار خون بالا مبتلا هستند و حدود ۴۰ درصد از این مبتلایان نیز از ابتلای خود به بیماری بیاطلاعاند. به

انزوای مدرن چالشی جدی برای سلامت روان است، اما با اقدامات آگاهانه میتوان اثرات آن را کاهش داد. تقویت روابط انسانی و ایجاد تعادل بین

زوال عقل (دمانس) معمولا افراد مسن را تحت تاثیر قرار میدهد، بنابراین زمانی که در میانسالی رخ میدهد، تشخیص آن دشوار است. به گزارش پایگاه

به گزارش پایگاه خبری پهنه پرواز به نقل از آی تی هوم در دورانی که بسیاری از مشاغل تحت تأثیر هوش مصنوعی قرار گرفتهاند یا

احساس پیری بیش از سن، تجربه تنهایی یا داشتن برداشتهای منفی در مورد پیری میتواند علائم اولیه ضعف، حتی در دهه ۴۰ زندگی باشد. به

وقتی هوش مصنوعی بتواند بهتر از معلمها آموزش بدهد، چه بر سر مدارس میآید؟ پاسخ این سؤال احتمالاً تصور شما را از آموزش دگرگون کند.

علائم پارگی رباط صلیبی زانو، روش تشخیص و درمان سریع مفصل زانو به گزارش پایگاه خبری پهنه پرواز به نقل از سایت دکترفوت، زانو یکی از

به گزارش پایگاه خبری پهنه پرواز دکتر احمد دنیامالی در پیامی ۲۷ اردیبهشتماه روز ملی ارتباطات و روابطعمومی را به فعالان این عرصه در ورزش

به گزارش پایگاه خبری پهنه پرواز به نقل از روابط عمومی کمیته ملی پارالمپیک، با پایان رقابت های باشگاهی پارادو ومیدانی گرامیداشت شهید مختار نورافشان

در این جلسه مریم دهقان تنها، فعال فرهنگی و مدرس دانشگاه اظهار داشت: این رمان نخستین بار در سال ۱۳۷۴ منتشر شد. به گزارش پایگاه

معاون واژه گزینی فرهنگستان زبان فارسی بیان کرد: اگر واژهای عربی مثل «عشق» را در فارسی درنظر بگیریم و بخواهیم آن را از زبان حذف

بر اساس پژوهشهای اخیر در حوزه روانشناسی و علوم اعصاب، پیامهای سادهای مانند “صبح بخیر” و “شببخیر” میتوانند تأثیر شگرفی بر فعالیت مغز و بهویژه

روز جهانی فشار خون بالا World Hypertension Day هر سال در ۱۷ می (۲۸ اردیبهشت ۱۴۰۳) برای افزایش آگاهی در مورد فشار خون بالا و

تیم پارادوومیدانی کرمانشاه جام قهرمانی ماده دوها را از آن خود کرد / تیم فارس قهرمان ماده پرتابها شد رقابتهای لیگ باشگاههای کشور پارادوومیدانی تحت

محل برگزاری مسابقات رشتههای ورزشی مختلف پنجمین دوره بازیهای پاراآسیایی اعلام شد. به گزارش پایگاه خبری پهنه پرواز به نقل از روابط عمومی کمیته ملی

بازار سرپوشیده اراک یکی از بناهای نخستین شهر اراک است که در زمان فتحعلی شاه قاجار و توسط یوسف خان گرجی در سال ۱۲۲۸ هجری

مطالعههای علمی که بدن انسان را انجام داده است و دیگر موجودات زنده نوری ضعیف میتوانند از مرگ ناپدید شوند. به گزارش پایگاه خبری پهنه

امر آموزش مؤثر زمانی ممکن است که با زیستشناسی بدن، شرایط روانی و واقعیتهای اجتماعی هماهنگ باشد، نه در تقابل با آنها. اگر هدف از

اپل برای رقابت با متا میخواهد عینکهای هوشمندش را به تراشهی اختصاصی مجهز کند. بهگزارش پایگاه خبری پهنه پرواز به نقل از بلومبرگ، اپل درحال

کاهو یکی از مفیدترین و مغذیترین سبزیجات برگدار است و ویتامین فراوانی دارد. انواع مختلفی از این سبزی پرطرفدار موجود است و همگی آنها سرشار

در این نوشتار با دنیای رنگارنگ «سِث گلوبپِینتِر» آشنا میشوید؛ هنرمند خیابانی فرانسوی که دیوارهای بیروح را به آثاری شگفتانگیز و رؤیایی تبدیل میکند. نام

آیا میخواهید از مغز در حال پیر شدن خود محافظت کنید؟ محققان توصیه میکنند تحرک داشته باشید. به گزارش پایگاه خبری پهنه پرواز به نقل

نخستین مرحله اردوی آمادگی تیم ملی #والیبال_نشسته مردان از فردا در تهران آغاز میشود. به گزارش پایگاه خبری پهنه پرواز به نقل از روابط عمومی

جلسه ای با حضور مسئولین فدراسیون ورزش های جانبازان و توان یابان با جهاد دانشگاهی صنعتی شریف برگزار شد. به گزارش پایگاه خبری پهنه پرواز

به گزارش پایگاه خبری پهنه پرواز در جریان بازدید محمدعلی جعفربگلو از نمایشگاه بینالمللی کتاب تهران و گفتوگوی وی با دکتر محمدرضا عارف، معاون اول رئیسجمهور، موضوع

تصویبنامه درخصوص تعیین یارانه پرداختی سازمان بهزیستی کشور به مراکز غیر دولتی بابت نگهداری، مراقبت و خدمات توانبخشی، آموزشی، حرفه آموزی معلولان و حق پرستاری

رقابتهای لیگ باشگاههای کشور پارادوومیدانی بانوان تحت نظارت IPC، گرامیداشت شهید نورافشان با معرفی تیمهای برتر به پایان رسید. به گزارش پایگاه خبری پهنه پرواز

به گزارش پایگاه خبری پهنه پرواز به نقل از روابط عمومی کمیته ملی پارالمپیک و به نقل از فدراسیون ورزشهای جانبازان و توانیابان، طی احکامی

همزمان با مراسم اختتامیه نمایشگاه «نقاشی بازی»؛ کتاب «با کودکان قصهها را نقاشی کنیم» رونمایی شد و در این مراسم اکبر نیکان پور گفت: کودکان

با افتخار، به مناسبت روز جهانی تنوع زیستی هفته میراث فرهنگی و همزمان با دهمین سال گرامیداشت «روز موزه و معلولیت»، از شما عزیزان دعوت

نتایج تحقیق کنونی نشان داد که تمرکز کردن در کار مسری است. به گزارش پایگاه خبری پهنه پرواز به نقل از پارسینه پلاس، سایکولوژی، دانشمندان دریافتند،

همزمان با هفته گرامیداشت مقام معلم، از دو استاد برجسته زبان و ادبیات فارسی دانشگاه شیراز: دکتر محمدمهدی جعفری و دکتر محمدیوسف نیری، تقدیر شد.

ویتامین E از طریق تغذیه بهخصوص روغنهای گیاهی تامین میشود. در این مطلب به ۷ علامت هشدار کمبود این ماده مغذی خواهیم پرداخت. به گزارش

معاونت اموراجتماعی و فرهنگی منطقه ۱۸ همزمان با اختتامیه هفته ملی سلامت و خجسته زاد روز هشتمین اختر تابناک آسمان امامت و ولایت امام رضا (ع)،

در حاشیه چهلوپنجمین مجمع عمومی شورای المپیک آسیا در کویت، رئیس و دبیرکل کمیته ملی المپیک کشورمان با حسین المسلم، مدیرکل شورای المپیک آسیا دیدار

مجتبی احمدلو، مدیرکل بهداشت، بیمههای اجتماعی و درمان کمیته امداد: به گزارش پایگاه خبری پهنه پرواز هیات دولت در ۲۸ اسفندماه سال ۱۴۰۳، فرانشیز بستری مددجویان در مراکز

نشست هماهنگی مسابقات قهرمانی کشور پارادوومیدانی (گرامیداشت شهید مختار نورافشان)، با حضور نماینده کمیته بینالمللی پارالمپیک (IPC)، صبح امروز در محل فدراسیون ورزشهای جانبازان و

به گزارش پایگاه خبری پهنه پرواز به نقل از روابط عمومی کمیته ملی پارالمپیک، نخستین جلسه کارگروه #پارادوومیدانی با هدف بررسی راهکارهای توسعهای این رشته،

به گزارش پایگاه خبری پهنه پرواز به نقل از فرارو/ لغو برنامههای اجتماعی ممکن است در ابتدا دلسردکننده به نظر برسد، اما اغلب احساسی از

به گزارش پایگاه خبری پهنه پرواز به نقل از ایسنا/آذربایجان شرقی آنها میخندند، در کلاس حاضرند، گاهی شوخی میکنند، اما در درونشان طوفانی خاموش در جریان

آیا نهادهای نظارتی بازیچهی اهداف مغرضانه ساترا میشوند؟ شنیدهها حاکی از آن است که مدیران ساترا یک نسخه پنج دقیقهای تقطیع شده و مغرضانه از

اردوی تیم ملی وزنه برداری بانوان جانباز و توان یاب در راستای کسب آمادگی برای بازی های پاراآسیایی ناگویا برگزار می شود. به گزارش پایگاه

برنامه تلویزیونی «۱۰۰۱» در قسمت تازه خود میزبان جمعی از بانوان پرافتخار کاروان پارالمپیک ایران خواهد بود. به گزارش پایگاه خبری پهنه پرواز به نقل

به گزارش پایگاه خبری پهنه پرواز ، انسیه مقدی رئیس اداره سلامت منطقه 11 با بیان اینکه مناسب سازی فضاهای شهری از نکات مهم مورد

22 اردیبهشت ماه به مناسبت زادروز پروفسور مریم میرزاخانی، روز جهانی زن در ریاضیات نامگذاری شده است. پروفسور مریم میرزاخانی درباره علایقهای خودش در زندگی

سینمای ایران پر است از چهرههایی که پیش از آنکه حتی دیالوگی بگویند، نام خانوادگیشان توجهها را جلب میکند. بازیگرانی که از خانوادههای هنرمند آمدهاند؛

یک موج صوتی خاص که گوش درونی را تحریک میکند، میتواند علائمی مانند تهوع و سرگیجه ناشی از ماشین گرفتگی را به طرز محسوسی کاهش

گروه علمی: دانشمندان طی پژوهشهای جدید خود کشف کردند که وقتی آهنگ مورد علاقهتان پخش میشود، مغزتان به صورت فیزیکی موسیقی را تجسم میکند. به

به گزارش پایگاه خبری پهنه پرواز به نقل از ایران طب، بسیاری از بیماریهای زنان مختص شرایط خاص جسمی یا سنی هستند و ممکن است

درمان بیماریهای زنان درمان بیماریهای زنان : علائم هشداردهنده در سلامت زنان و لزوم مراجعه به متخصص زنانچرا توجه به سلامت زنان اهمیت دارد؟ به

در خویش مانده؛ ایستادن در مرز تنهایی و عشق«درخویش مانده»عنوان ششمین نمایشگاه انفرادی بهزاد اسلامی است که این روزها در گالری بام برپاست در این

به گزارش پایگاه خبری پهنه پرواز، کلانشهر اصفهان از سوی مجمع شهرداران آسیایی بهعنوان «پایتخت گردشگری شهرهای آسیایی در سال ۲۰۲۵» برگزیده شد. مجمع شهرداران

به گزارش پایگاه خبری پهنه پرواز دولت ثبتنام وام ودیعهٔ مسکن را با سقف ۲۷۵ میلیون تومان در تهران و ۱۴۰ میلیون در سایر شهرها

به گزارش پایگاه خبری پهنه پرواز مدیرکل بهداشت، درمان و بیمههای اجتماعی کمیته امداد:فرانشیز بستری در مراکز دولتی و دانشگاهی برای مددجویان کمیته امداد و

به گزارش پایگاه خبری پهنه پرواز، رئیس سازمان بهزیستی کشور با اشاره به فعالیت سه هزار و ۵۰۰ مرکز توانبخشی در کشور گفت: هر کجا

شاید تصویری که امروز از نمایشگاه کتاب میبینیم تصویر واقعیتری از وضعیت کتاب و کتابخوانی باشد. این روزها احتمالاً کمتر جوانی را بشود دید که

این جهانی است که در آن درختها راه میروند و آدمها با بستن پنجرهها از زندگی خداحافظی میکنند، استعارهای از دل کندن دو عاشق از

یک فوق تخصص کبد، از انجام فعالیت های ورزشی به عنوان یکی از موثرترین روش های کاهش چربی کبد نام برد. به گزارش پایگاه خبری

یک مطالعه جدید نشان داد که کمخوابی باعث افزایش سطح پروتئینهایی میشود که با افزایش خطر بیماریهای قلبی – عروقی مانند نارسایی قلبی و بیماری

استیون هاوکینگ یکی از فیزیکدانان برجسته در جهان است. او با مطالعه سیاهچالهها و شکلگیری کیهان، انقلابی در زمینه فیزیک و کیهانشناسی بهوجود آورد. به گزارش

حجتالله ایوبی با حکم سیدرضا صالحیامیری بهعنوان مشاور عالی وزیر میراث فرهنگی، گردشگری و صنایع دستی و رئیس مرکز بینالملل این وزارتخانه منصوب شد.

ملی پوشان جوان بوچیا از فردا وارد اردوی تیم ملی می شوند. به گزارش پایگاه خبری پهنه پرواز به نقل از روابط عمومی فدراسیون ورزش

به گزارش پایگاه خبری پهنه پرواز به نقل از روابط عمومی سازمان بهزیستی، مدیرعامل شرکت واحد اتوبوسرانی تهران از توسعه و بهسازی ناوگان ویژه معلولان

درویشدوزی (یا تفرشیدوزی)، یکی از انواع رودوزیهای متنوع و هنرمندانۀ ایرانی است؛ که در گذشته، تولیدکنندۀ عمده و اصلی آن، مردم تفرش (در شمال شرقیِ

به گزارش پایگاه خبری پهنه پرواز به نقل از سرویس مجله خانواده ساعدنیوز، آموزش دستشویی رفتن کودک یکی از مراحل کلیدی در پرورش کودکان است که

کفش طبی کودکان و اطفال، بهترین مرکز ساخت کفش ارتوپدی پای پرانتزی کودکان پای پرانتزی یکی از ناهنجاری های شایع در کودکان است که معمولاً در سال های

تحقیقات جدید حاکی از آن است که روند سالمندی در زنان ممکن است برای همیشه تغییر کند. پژوهشگران در حال بررسی پرسشی هستند که تا

به گزارش پایگاه خبری پهنه پرواز به نقل از ایرنا : با افزایش سن، حفظ قدرت پاها برای تحرک و سلامتی ضروری میشود. ویتامین برای پاهای

انتخاب رنگ لباس نهتنها سبک شخصی را نشان میدهد، بلکه بر رفتار، خلقوخو، و حتی تعاملات اجتماعی اثر میگذارد. به گزارش پایگاه خبری پهنه پرواز

نشست هم اندیشی توسعه فکری جنبش پارالمپیک به ریاست سیدمحمدپولادگر نایب رییس کمیته ملی پارالمپیک برگزار شد. به گزارش پایگاه خبری پهنه پرواز به نقل

رقابتهای قهرمانی آسیا و اقیانوسیه والیبال نشسته در بخش بانوان با حضور ۷ تیم برگزار می شود. به گزارش پایگاه خبری پهنه پرواز به نقل

شاید شما هم فکر میکنید افراد درونگرا افرادی گوشه گیر و بی استعداد هستند، اما اینگونه نیست افراد درونگرا در بسیاری از کارها موفق تر

در دنیایی که پر از اعلانها و حواسپرتیهای بیپایان است، عادت به کتابخوانی مانند یک هنر گمشده به نظر می رسد. با این حال، پرورش

خم نشدن زانو مشکلی جدی است که می تواند فعالیت های روزمره مانند نشستن، راه رفتن یا بالا رفتن از پله ها را مختل کند.این عارضه

ا کمیته برگزاری بازیهای المپیک و پارالمپیک لسآنجلس ۲۰۲۸، امروز هجدهم اردیبهشت ماه ١۴٠۴، از برگزاری مراسم افتتاحیه و اختتامیه این رویدادها، در دو ورزشگاه

در دیدار قائممقام وزیر میراثفرهنگی، گردشگری و صنایعدستی با محمد میرشکرایی پژوهشگر برجسته، بر جایگاه ممتاز استان مرکزی در منظومه فرهنگی ایران تأکید شد؛ استانی

جلسه مشترک مسئولین فدراسیون ورزش های جانبازان و توان یابان با محمدیان معاون توسعه ورزش بانوان وزارت ورزش و جوانان برگزار شد. به گزارش پایگاه

جامعهشناس و عضو هیات علمی دانشگاه تهران گفت: ۷۰ درصد تجرد قطعی در دختران بر اساس انتخاب بوده است و ۳۰ درصد آن ناشی از

مراسم بزرگداشت مختومقلی فراغی، شاعر ترکمن، با هدف پاسداشت ادبیات اقوام ایرانی و تأکید بر جایگاه فرهنگی این شاعر، در پیوند ادبیات بومی با هویت

به گزارش پایگاه خبری پهنه پرواز به نقل از سایت دکترفوت ، صدای تق تق یا کلیک زانو، یکی از شکایات شایع در میان نوجوانان، جوانان و حتی سالمندان

به گزارش پایگاه خبری پهنه پرواز به نقل از روابط عمومی فدراسیون ورزشهای جانبازان و توانیابان، اردوی آمادگی تيم ملی بوچیا برای حضور در بازیهای

به مناسبت هفته ملی سلامت و در راستای اجرای برنامههای حمایتی و ارتقاء سطح سلامت، محمدرضا پوریافر شهردار منطقه ۵ به همراه معاون امور اجتماعی

فدراسیون سوارکاری کشورمان از اجرای برنامههای توسعهمحور در بخش پارادرساژ خبر داد. به گزارش پایگاه خبری پهنه پرواز به نقل از روابط عمومی کمیته ملی

به گزارش پایگاه خبری پهنه پرواز به نقل از ايسنا : گروهی از محققان کشف کردهاند که قلبهای افرادی که با بیماریهایی از جمله چاقی مفرط،

اواسط بهار، تاریخ ایران ما را به یاد قانونی غرورآفرین در حوزه صنعت نفت میاندازد بر اساس گزارش پایگاه خبری پهنه پرواز به نقل از

ساری میزبان دومین مرحله از تمرینات ملیپوشان تیم فوتبال نابینایان خواهد بود. به گزارش پایگاه خبری پهنه پرواز به نقل از روابط عمومی کمیته ملی

دکتر دنیامالی: اعتقاد دارم که افراد توانمندی در حوزه مدیریت ورزش جانبازان و توانیابان فعالیت میکنند / ورزشکاران توانیاب فراتر از انتظار در میادین بزرگ

آیین اختتامیه مسابقه نام نویسی «شهر من سلام» با برگزیدن ۵۰ نامه و رونمایی از این تعداد نامه در قالب یک کتاب برگزار شد. به

بر اساس توافقنامهای میان سازمان بهزیستی کشور و وزارت نیرو، طرحی با هدف ایجاد درآمد پایدار برای مددجویان دارای معلولیت شدید و خیلی شدید در

نشست صمیمانه رئیس انجمن msایران با رئیس سازمان بهزیستی کشور بعد از ظهر امروز با حضور دکتر افروز صفاری فرد مدیرکل دفتر پیشگیری از معلولیت

نوشته: لاکلان براونآنها میدانند چه کسی به تعطیلات رفته، چه کسی بهتازگی از رابطهای جدا شده یا شغل جدیدی پیدا کرده است. در سکوت همهچیز

محققان دانشگاه مینهسوتا اولین کارآزمایی بالینی انسانی را که روش ویرایش ژن CRISPR/Cas۹ را برای کمک به سیستم ایمنی در مبارزه با سرطانهای پیشرفته دستگاه گوارش

نویسنده: ریچل وانبین وادار کردن خود به انجام یک کار و فریب دادن مغز برای اینکه خودش بخواهد آن را انجام دهد، تفاوت زیادی وجود

جعفر ذهنی، هنرمند پیشکسوت تئاتر گیلان درگذشت. به گزارش پایگاه خبری پهنه پرواز به نقل از ایسنا، جعفر ذهنی، هنرمند پیشکسوت و برجسته تئاتر گیلان،

نویسنده دو رمان تاریخی «نجیببنیامیه» و «صراط» با اشاره به استفاده از تاریخ برای ادبیات، گفت: نویسنده برای خلق ادبیات باید دست به کشف تاریخی

سازمان ثبت احوال کشور اعلام کرد: در سال ۱۴۰۳ تعداد ۹۷۹هزار و ۹۲۳ واقعه ولادت در کل کشور به ثبت رسیده است. سازمان ثبت احوال

به گزارش پایگاه خبری پهنه پرواز ، معاون توانبخشی سازمان بهزیستی کشور، درباره نگهداری ۹۳ درصد افراد دارای معلولیت در خانه و برنامه این سازمان

در ادامه نشستهای تخصصی کمیته ملی المپیک با رشتههای منتخب اعزامی، صبح امروز (دوشنبه ۱۵ اردیبهشت ۱۴۰۴)، نشست هماهنگی با حضور مسئولان کمیته ملی پارالمپیک

بانوی پاراتیراندازی کشورمان در هشتمین جشنواره نظرسنجی ورزشی شهر مشهد به عنوان برترین ورزشکار این شهر انتخاب شد. به گزارش پایگاه خبری پهنه پرواز به

به گزارش پایگاه خبری پهنه پرواز این قنات چند هزار ساله، آخرین نسل باقیمانده از قنات های فعال در کشور هست که شاهکاری تاریخی ساخته

گلپایگان _ معلم و مهندس گلپایگانی، با بیش از دو دهه فعالیت در حوزه آموزش و صنعت، با تکیه بر دانش، پشتکار و خودباوری، از

دکتر رضا ملکزاده، استاد ممتاز دانشگاه علوم پزشکی تهران و از چهرههای برجسته آموزش و پژوهش پزشکی کشور، در گفتوگویی، ضمن تبیین مسیر علمی و

نویسندگان: دکتر جان ال. ولز و دکتر دورین مکآلی قدردانی، در ظاهر، یک احساس مثبت و تقویتکننده است که باعث روابط بهتر، آرامش روانی و

در طول تاریخ هنر، زنان هنرمند اغلب در سایه همتایان مرد خود قرار گرفتهاند و سهم آنها در جنبشهای هنری بزرگ نادیده گرفته شده است.

فراخوان چهلودومین دوره جشنواره بینالمللی فیلم کوتاه تهران توسط انجمن سینمای جوانان ایران منتشر شد و بر اساس آن، این رویداد از ۲۷ مهر تا

یکی از ویژگیهایی که برای مراقبت از روابط لازم است، تواناییِ دیدنِ نقاط قوّتِ دیگران و چشمپوشی از عیبها و نقصهای آنان است. گفتنی است

چهارمین مرحله از تمرینات ملیپوشان تیم گلبال به میزبانی همدان برگزار میشود. به گزارش پایگاه خبری پهنه پرواز به نقل از روابط عمومی کمیته ملی

رقابت های آزاد تیراندازی با کمان جانبازان و توان یابان در مجموعه شهید شیرودی برگزار شد. به گزارش پایگاه خبری پهنه پرواز به نقل از

نویسنده ریچل وان ایجاد اعتماد به نفس در یک مرد همیشه نیاز به کارهای بزرگ ندارد. چیزهای کوچک هم میتوانند تفاوت بزرگی ایجاد کنند.اغلب به

دانشآموزان بیتفاوت به درس، چالشی رایج در سیستم آموزشی هستند. این بیتفاوتی ممکن است ناشی از عوامل مختلفی مانند ناامیدی از یادگیری، عدم ارتباط با

محققان با مشاهده نمونههای در یک آزمایش حیوانی برای «رفتارکمکی»(helping behavior)، دریافتند که موشها بیشتر به همسالانی که تجربیات اجتماعی مثبتی با آنها داشتهاند، کمک

هویت فردی، یعنی شناخت فرد از خودش از جمله باورها، ارزشها، تجربیات و نقشهای اجتماعیاش، نقش کلیدی در سلامت روان دارد. به گزارش پایگاه خبری

ملی پوشان تنیس روی میز کم توانان ذهنی از پانزدهم اردیبهشت ماه وارد اردوی تیم ملی می شوند. به گزارش پایگاه خبری پهنه پرواز به

به گزارش پایگاه خبری پهنه پرواز به نقل از روابط عمومی بهزیستی، نماینده ایذه درباره عیدی مددجویان گفت: از آقای میدری وزیر تعاون، کار و

ملی پوشان جوان تیم #گلبال بانوان چهارمین اردوی آمادگی خود را به میزبانی قزوین برگزار می کنند. به گزارش پایگاه خبری پهنه پرواز روابط عمومی کمیته

تاریخچه روز جهانی آزادی مطبوعاتپس از مجموعهای از حملات به خبرنگاران در طول جنگهای داخلی آفریقا در پایان قرن بیستم، روزنامهنگاران و خبرنگاران تصمیم گرفتند

معاون اجتماعی و فرهنگی منطقه 11 از برگزاری جشن فراتر از مادری، ویژه مادران صبورو فداکار ، دارای فرزند معلول ” نخبه ” در این

جمعی از راهنمایان گردشگری استان های مرکزی و قم روز جمعه ۱۲ اردیبهشت ماه ۱۴۰۴ از روستای تاریخی و گردشگری کهک دلیجان بازدید کردند. به

مصلی امام خمینی تهران، اردیبهشتماه هر سال میزبان بزرگترین رویداد فرهنگی کشور است؛ به گزارش خبرنگار پایگاه خبری پهنه پرواز نمایشگاه بینالمللی کتاب تهران، فرصتی

در دورانی که جامعه ایران با چالشهای پیچیدهای در مسیر ازدواج جوانان روبهرو است، از بحران اقتصادی تا سردرگمیهای فرهنگی، هر تلاشی برای تسهیل و

انتشارات واج شش داستان کوتاه از فروغ فرخزاد، شاعر بزرگ معاصر را در یک کتاب گردآوری و منتشر کرده است. به گزارش پایگاه خبری پهنه

حفظ تعادل در تمام زمینههای زندگی به پیشرفت و موفقیت کمک میکند. این امر شامل ایجاد تعادل در بدن هم میشود. به گزارش پایگاه خبری

دولینگو با اشاره به موفقیت پیشین خود در سرمایهگذاری روی فناوری موبایل در سال ۲۰۱۲، هوش مصنوعی را کلید رشد آینده میداند. شرکت دولینگو، پلتفرم

یک خواهر روحانی به نام «اینا کانابارو لوکاس» که تا پیش از این عنوان مسنترین فرد جهان را در اختیار داشت، روز چهارشنبه دهم اردیبهشت

آرتروز لگن یک بیماری التهابی که به تدریج باعث فرسایش و آسیب به غضروف های مفصل لگن می شود آرتروز لگن است . این بیماری یکی از

به گزارش پایگاه خبری پهنه پرواز در یک دستاورد چشمگیر علمی، پژوهشگران دانشگاه واشنگتن در سنت لوئیس موفق به توسعه سیستمی شدهاند که میتواند شکاف

چگینی رئیس هیأت ورزشهای ناشنوایان استان سمنان بهمراه اعضای هیات و جمعی از قهرمانان به دیدار دکتر گلرو نماینده مردم در مجلس شورای اسلامی رفتند.

نشست مسئولین فدراسیون ورزش های جانبازان و توان یابان با نواب رئیس انجمن های ورزشی برگزار شد. به گزارش پایگاه خبری پهنه پرواز به نقل

زینب قهرمانی، بانویی با همتی ستودنی، نمونهای درخشان از غلبه بر محدودیتها و ساختن مسیری روشن در دل دشواریهاست. او که به دلیل هیپوکسی حین

رسیدن ماه اردیبهشت میتواند بهانه مناسبی برای سعدیخوانی باشد، چرا که علاوه بر مصادفشدن با روز بزرگداشت او، روایت است که گلستان نیز در این

بلومبرگ در گزارشی اختصاصی میگوید اپل پروژهی عینک هوشمندش را با جدیت به پیش میبرد. بر اساس گزارش پایگاه خبری پهنه پرواز به نقل از

تا حالا به این فکر کردهاید که چرا برخی کودکان زودتر عصبی میشوند یا نمیتوانند احساساتشان را بیان کنند؟ شاید در درونشان زخمهایی باشد که

رئیس انجمن مددکاران اجتماعی ایران و معاون سلامت اجتماعی سازمان بهزیستی در پیامی درگذشت «دکتر محترم رمضانلو» استاد پیشکسوت مددکاری و نایب رئیس انجمن مددکاران

منیر طه مؤسس و مدرس بخش زبان و ادبیات ایتالیایی دانشگاه تهران بود، سرپرستی دپارتمان زبانهای خارجی دانشگاه تهران و مدیریت دپارتمان زبانهای خارجی دانشگاه

به گزارش پایگاه خبری پهنه پرواز به نقل از عصرایران، یک روانشناس با بیان اینکه نارضایتی نوجوانان از ظاهر خود پدیدهای شایع اما قابل پیشگیری

مرکز آموزش، سنجش و ارزیابی عملکرد فدراسیون ورزش های جانبازان و توان یابان دوره مربیگری درجه ۲ پاراتیروکمان را در محل فدراسیون برگزار می کند.

اردوی تیم ملی #والیبال_نشسته بانوان از پانزدهم اردیبهشت ماه آغاز می شود. به گزارش پایگاه خبری پهنه پرواز به نقل از روابط عمومی کمیته ملی

در میان همهمه روزهای پرشتاب زندگی، معلمان آرام و بیادعا گام برمیدارند و در سکوت، آینده را میسازند. دوازدهم اردیبهشت، روزی برای یادآوری این حقیقت

پژوهشی تازه با معرفی معیار «مدتزمان انجام کار» نشان میدهد فناوری هوش مصنوعی چنان سریع پیشرفت میکند که توانایی آن در انجام وظایف طولانیمدت (چندساعته)

نتفلیکس مجموعهای از آثار آلفرد هیچکاک را به صورت آنلاین و همچنین در در سالن تاریخی پاریس در نیویورک به نمایش میگذارد. به گزارش پایگاه

در حالی که فراموشی گاهبهگاه بخشی طبیعی از زندگی است، آگاهی از تفاوتهای میان خطاهای معمول حافظه و نشانههای احتمالی زوال عقل اهمیت زیادی دارد.

اردوی آمادگی تیم ملی شنا جانبازان و توان یابان به میزبانی استان خراسان رضوی برگزار می شود. به گزارش پایگاه خبری پهنه پرواز روابط عمومی

کمیته بینالمللی پارالمپیک در گزارشی به تأثیر جهانی برنامههای توسعه محور پرداخت به گزارش پایگاه خبری پهنه پرواز به نقل از روابط عمومی کمیته ملی

به گزارش پایگاه خبری پهنه پرواز، حق_پرستاری خانواده محور فروردین ماه 1404 معلولان جسمی حرکتی شدید و خیلی شدید و #معلولان ذهنی تحت پوشش سازمان

به گزارش پایگاه خبری پهنه پرواز مشاور رئیس و مسئول دبیرخانه پیگیری قانون حمایت از حقوق افراد دارای معلولیت سازمان بهزیستی با اشاره به تغییر

آقای روانشناس، تو بگو من چرا حالم خوب نمیشود؟ یعنی روانی ام؟ حتماً روانی ام که تازه در عصرگاه روز تو، تازه یادم افتاده برایت

در تقویم رسمی جمهوری اسلامی ایران، دهم اردیبهشت ماه بهعنوان «روز ملی خلیج فارس» ثبت شده؛ روزی که یادآور اخراج نیروهای استعمارگر پرتغالی از سواحل

طی احکامی جداگانه ای از سوی رئیس فدراسیون ورزش های جانبازان و توان یابان، مدیران ورزش قهرمانی و ورزش همگانی، روسای کمیته طرح و برنامه

معاون گردشگری وزارت میراثفرهنگی خطاب به تورگردانان خارجی گفت: شما میتوانید با ارائه تصویری زیبا و امن از ایران، که دارای جاذبههای بینظیر و زیرساختهای

با حکمی از سوی رئیس فدراسیون ورزش های جانبازان و توان یابان، نیک فرجام به عنوان سرمربی تیم ملی بوچیا جوانان منصوب شد. به گزارش

روانشناسی علمی برای مطالعه و بررسی ذهن و رفتار با شاخههای متفاوت شامل توسعه انسانی، ورزش، سلامت، پزشکی، رفتار اجتماعی و فرآیندهای شناختی است. روانشناسی

آرتروز یکی از شایع ترین بیماری های مزمن مفصلی است که می تواند هر بخشی از بدن را درگیر کند. به گزارش پایگاه خبری پهنه پرواز

باستانشناسان سنگنبشتهای با نام رامسس سوم، فرعون سرشناس مصر باستان در جنوب اردن کشف کردند. به گزارش پایگاه خبری پهنه پرواز به نقل از لایو

به گزارش پایگاه خبری پهنه پرواز به نقل از ایرنا : تماشای مداوم مانیتورها، تلویزیون و صفحات موبایل که همگی منابع نور هستند، میتواند اثرات نامطلوبی

اولین نشست شورای نشر و توسعه پژوهش کمیته ملی پارالمپیک در سال ۱۴۰۴ برگزار شد. به گزارش پایگاه خبری پهنه پرواز به نقل از

همزمان با هفته سلامت و به منظور پاسداشت تلاشهای خالصانه فعالان حوزه سلامت، روز یکشنبه ۷ اردیبهشت ۱۴۰۴ مراسمی با حضور جمعی از مسئولان شهری،

معاون امور اجتماعی و فرهنگی منطقه ۱۴تهران در حاشیه برگزاری جشن «لبخند فرشتهها» بر لزوم گسترش برنامههای هدفمند فرهنگی و اجتماعی برای افراد دارای معلولیت

همزمان با گرامیداشت هفته ملی سلامت، دورهمی «از خواستن تا توانستن» با حضور حمید صاحب، مدیرکل سلامت شهرداری تهران، معاونین این اداره کل و جمعی

قلب طعمها و سنتها ایران، سرزمین رنگها، طعمها و فرهنگهای گوناگون، میزبان جشنوارهای بینظیر است که اقوام مختلف را گرد هم میآورد تا سفرههای سنتی

دیدن یا شنیدن خمیازه دیگران میتواند باعث شود خودتان هم خمیازه بکشید. این پدیده فقط به انسانها محدود نمیشود و برخی حیوانات نیز خمیازهی واگیردار

به گزارش پایگاه خبری پهنه پرواز به نقل از رویداد۲۴، ایام تعطیل و وقتی از سر کار برمیگردید یا اوقات فراغت دارید، فرصت خوبی است

دانشمندان به تازگی در پژوهشی که درک رایج از دوپامین را گسترش میدهد، نشان دادهاند این ماده شیمیایی مغز علاوه بر نقش شناخته شده در

با اندوهی جانسوز، خبر آتشسوزی گسترده در بندرعباس و جان باختن و آسیب دیدن شماری از هممیهنان گرامی، دل هر ایرانی را لبریز از اندوه

شعور و بیشعوری دو مفهوم کلیدی هستند که در زندگی روزمره، تأثیر عمیقی بر کیفیت روابط اجتماعی و تعاملات انسانی دارند. به گزارش پایگاه خبری

به گزارش پایگاه خبری پهنه پرواز قلعه حاج وکیل که با نام عمارت کلاه فرنگی نیز شناخته میشود، یکی از بناهای تاریخی دوره قاجار شهر

مارسل پروست (Marcel Proust)، یکی از نویسندگان برجسته و معروف فرانسوی، در خانوادهای پولدار متولد شد. شهرت او بیشتر به خاطر آفرینش اثر بزرگ “در

نشست مسئولین فدراسیون ورزش های جانبازان و توان یابان با نماینده مجلس شورای اسلامی برگزار شد. به گزارش پایگاه خبری پهنه پرواز به نقل از

طی حکمی از سوی دکتر غفور کارگری، رئیس کمیته ملی پارالمپیک، دکتر رضا قراخانلو به عنوان رئیس شورای راهبردی آکادمی ملی پارالمپیک منصوب شد. به

مجید مظفری بازیگر کهنهکار سینمای ایران در هفتاد و چهار سالگی با بازی در نقش رییس ساواک در سریال تاسیان ساخته تینا پاکروان، بار دیگر

عینکهای هوشمند جدید با استفاده از فناوری هوش مصنوعی و هشدارهای صوتی و لمسی، به نابینایان این امکان را میدهند که بهطور مستقل در مسیر

دنیای اقتصاد: روستای چهارفصل «سنگان» در فاصلهای نزدیک به تهران میتواند یکی از بهترین انتخابهای سفر یک تا دو روزه در تعطیلات آخر هفته در

ایستگاه وکیل الرعایا یازدهمین ایستگاه خط ۱ متروی شیراز است. این ایستگاه در نزدیکی بازار وکیل، مسجد وکیل و حمام وکیل واقع شده است و

مدیر مرکز میکروفیلم نور با اشاره به انتخاب زبان فارسی بهعنوان زبان کلاسیک کشور هند، تاکید کرد که حفظ این زبان نیازمند عزم جدیتر مسئولان

به گزارش پایگاه خبری پهنه پرواز به نقل از روابط عمومی سازمان بهزیستی، دانشمندان چینی موفق به توسعه یک سیستم پوشیدنی مبتنیبر هوش مصنوعی شدهاند

ملی پوشان تیم #پارادوومیدانی از امروز ششم اردیبهشت ماه تمرینات خود را برای آمادگی حضور در بازی های پاراآسیایی جوانان دبی ۲۰۲۵ آغاز کردند. به

نمایندگان فارس، آذربایجان غربی و البرز به قهرمانی در بخشهای ویلچر، قطع عضو و حسی رقابتهای پارا بیلیارد کشوری دست پیدا کردند. به گزارش پایگاه

روستای رندان، در ۳۰ کیلومتری شمال غربی تهران، با طبیعتی بکر و زیبا همچون آبشار رندان و باغهای سرسبز، به مقصدی جذاب برای علاقهمندان به

تصور کنید وارد مکالمهای میشوید که طرف مقابلتان آنقدر طبیعی، شوخطبع و هوشمندانه پاسخ میدهد که بدون شک فکر میکنید با یک انسان در حال

زندگی همیشه روی خوش نشان نمیدهد؛ گاهی برنامهها نقش بر آب میشوند و مشکلات از راه میرسند. زندگی همیشه روی خوش نشان نمیدهد؛ گاهی برنامهها

به گزارش پایگاه خبری پهنه پرواز به نقل از خبرآنلاین : ضروری است که چشمها را همیشه آماده و کارآمد نگه داریم تا در سالهای آینده

کتاب «یک قدم در بهشت» نوشته ران رَش از مجموعه ادبیات جنوب نشر چام از زبان انگلیسی با ترجمه شاهین نعمتی برای اولین بار در

اکوایران: پژوهشگران با استفاده از نانوذرات طلا یک پروتز شبکیهای توسعه دادهاند که به سلولهای خاص شبکیه هدفگیری شوند. در موشهای با دژنراسیون شبکیه، این

The Time Machineاین رمان یکی از آثار شکلدهنده به ژانر «علمی تخیلی» در نظر گرفته می شود. به گزارش پایگاه خبری پهنه پرواز به نقل

به گزارش پایگاه خبری پهنه پرواز به نقل از روابط عمومی سازمان بهزیستی کشور، مدیرعامل شرکت واحد اتوبوسرانی تهران با تاکید بر لزوم ارتقای خدماترسانی

پنجمین دوره مسابقات پارابیلیارد کشوری با همکاری فدراسیون های ورزش های جانبازان و توان یابان و بولینگ و بیلیارد و برگزار در حال برگزاری است.

در چهارم اردیبهشت ۱۳۱۹، نخستین فرستنده عمومی رادیو در ایران با نام «رادیو تهران» آغاز به کار کرد و از آن روز تاکنون، این رسانه

هالیوود ریپورتر خبر داد که پیمان معادی، بازیگر مطرح ایرانی، قرار است در پروژه جدید کریستوفر نولان، «اودیسه»، ایفای نقش کند.بر اساس گزارش پایگاه خبری

طبق گفته دو محقق هوش مصنوعی ChatGPT دیگر قدیمی شده و با دوران تجربه ، هوش مصنوعی دیگر نیازی به انسان نخواهد داشت. به گزارش

اصفهان – گالری «دیدار» اصفهان این هفته میزبان نمایشگاهی از آثار هنرمندی خودآموخته به نام «رقیه دبیری» بود که پس از چاپ کتابی به نام

تأثیر روانشناسی مثبتگرا بر بهبود روابط یکی از موضوعات مهم در ارتباطات انسانی است. به گزارش پایگاه خبری پهنه پرواز به نقل از عصرایران، این

یافتههای پژوهشی جدید نشان میدهد سپری کردن وقت با خانواده عامل اصلی احساس داشتن روزی خوب است و ورزش روزانه حتی تا پنج ساعت همچنان

طی احکامی جداگانه ای از سوی رئیس فدراسیون ورزش های جانبازان و توان یابان، کادر فنی تیمهای ملی بسکتبال با ویلچر مردان و بانوان معرفی

به گزارش پایگاه خبری پهنه پرواز همزمان با ۲۴ آوریل، روز جهانی ورزش نابینایان و کمبینایان، پایگاه خبری پهنه پرواز این روز را به تمامی

اثر تاریخی فرهنگی پل هفت چشمه ضامنجان اراک با قدمت دوره پهلوی اول در فهرست آثار ملی ثبت شد. به گزارش پایگاه خبری پهنه پرواز

یک مطالعه دو ساله و نخستین آزمایش بالینی روی پیوند مدفوع برای درمان اوتیسم نشان داده است که این پیوند میتواند علائم اوتیسم را تا

آرش عباسی، نویسندهی سریال پایتخت ۷ که از نویسندگان و کارگردانهای تئاتر است در صفحهی اینستاگرام خود نوشت: نشانهای از امید نیست! به احتمال زياد

بر اساس جدیدترین اطلاعات منتشر شده از سوی کمیته برگزاری بازی های پاراآسیایی آیچی-ناگویا، پنجمین دوره از بازی های پاراآسیایی با حضور ۲۷۰۰ ورزشکار در

با حکمی از سوی رئیس فدراسیون ورزش های جانبازان و توان یابان، پورحسن به عنوان مشاور رئیس در امور رسانهای فدراسیون منصوب شد. به گزارش

مشارکت شرکت معدنی املاح ایران در پویش پاکسازی مسیرهای دسترسی به تالاب میقان اراک به گزارش پایگاه خبری پهنه پرواز به نقل از روابط عمومی

تقریباً همه افراد در مقطعی از زندگی خود نشخوار فکری را تجربه کرده اند. گاهی اوقات عبور از موضوعی با تاثیر منفی و یادگیری نحوه

نقش زبان مادری در درک ما بیشتر از آن است که فکر میکنیم. مغز انسان برای درک جملهها، بسته به ساختار زبان، راهبردهای پردازشی متفاوتی

بیست و سوم آوریل، برابر با سوم اردیبهشت روز جهانی کتاب و حق مولف نامگذاری شده است. روزی که در برخی از کشورها با جشن

اگر علائم بلوغ زودتر از حد معمول ظاهر شود، ممکن است رشد قدی کودک متوقف یا محدود شود. به گزارش پایگاه خبری پهنه پرواز به

مهشید چوبداری، دکتری روانشناسی بالینی، در یادداشتی به بررسی پنج ویژگی ساده اما تأثیرگذار در جذابیت فردی از نگاه روانشناسی پرداخت. به گزارش پایگاه خبری

یکی از بهترین راهها برای پایان دادن به منازعاتِ میان انسانها این است که اندیشۀ یکساننگری را در میان آنها رواج دهیم و پیش و

پژوهشگران ایرانی در تحقیقات خود به ساخت یک نمونه آزمایشگاهی داربست کشت سلولی پرداختند. این داربست جهت کشت سلولهای عصبی به منظور ترمیم ضایعه نخاعی

به گزارش پایگاه خبری پهنه پرواز، اگر این فن آوری در اختیار همه معلولان ضایعه نخاعی و ویلچر نشین در ایران قرار بگیرد چقدر مشکلات اجتماعی

روانشناسی فرزندان اول می گوید که افرادی قانونمند، ساختارگرا، کنترل گر، محتاط و موفق هستند. آنها تمایل دارند در نقش رهبر، دیگر فرزندان را راهنمایی

رنگ ارغوانی ویژگی منحصربهفردی دارد که آن را از بقیه رنگهایی که میبینیم، متمایز میکند: این رنگ ساخته مغز ماست و شاید بهتر باشد آن

تا۱۴۳۰، بیش از یکسوم جمعیت ایران سالمند میشوند به گزارش پایگاه خبری پهنه پرواز به نقل از ایسنا رئیس انجمن علمی طب سالمندی ایران با

تفاهم بین زوجین یکی از ارکان اصلی موفقیت در زندگی مشترک است که به حفظ آرامش، کاهش اختلافات و تقویت روابط عاطفی کمک می کند.

ارتباطات موثر یکی از مهارتهای الزامی برای هر فردی است که میتواند با استفاده از آن با دیگران روابط خوب و سازندهای را ایجاد کرد.

سعدی یکی از تأثیرگذارترین چهرههای ادب فارسی است که آثارش فراتر از مرزهای ایران شناخته شده و شعرهایش به بسیاری از زبانهای دنیا ترجمه شدهاند.

خودانگیزشی مفهوم جدیدی در روانشناسی است که شناخت آن بسیار مهم است به گزارش پایگاه خبری پهنه پرواز به نقل از عصرایران ،خودانگیزشی یا self-motivation

تفاهم نامه همکاری میان فدراسیون ورزشهای جانبازان و توانیابان با فدراسیون کوه نوردی و صعودهای ورزشی امروز امضا شد. به گزارش پایگاه خبری پهنه پرواز

در ساختار اجتماعی هر جامعه، خانواده نخستین و بنیادیترین نهاد تربیتی و روانی تلقی میشود. در این میان حضور کودک نه تنها یکی از مولفههای

در عصری که مغز ما دائماً تحت بمباران اطلاعات قرار دارد، آیا تا به حال احساس کردهاید که ذهنتان شبیه یک مرورگر با صدها تب

نمایشنامه «شاهموش و مارا و دیوار» شامل سه نمایشنامه است که به گفته ناتاشا محرمزاده، هرکدام در سالی نوشته شدهاند. به گزارش پایگاه خبری پهنه

آیا تا به حال فکر کردهاید که چرا برخی اتفاقات، حتی سالها پس از وقوع، همچنان بر ذهن و روح ما سنگینی میکنند؟به گزارش پایگاه

در دنیایی که گاه محدودیتها مرزهای موفقیت را تعیین می کنند ، برخی انسانها هستند که با ارادهای پولادین، ثابت میکنند هیچ مانعی نمیتواند آنها

با شعار: «مشارکت مردم برای نجات زمین»سهشنبه ۲ اردیبهشت ۱۴۰۴ساعت ۹ تا ۱۲ پارک طبیعت پردیسان – موزه تنوع زیستیهمراه با:ایستگاه نفس پاک در خانه

به گزارش پایگاه خبری پهنه پرواز مدیرعامل سازمان ورزش شهرداری تهران در نشست خبری خود به سوالی مبنی بر برگزاری مسابقات پایتختهای کشورهای آسیایی پاسخ

پل ورسک: معاون گردشگری میراث فرهنگی، صنایع دستی و گردشگری مازندران گفت: باغ عباس آباد، جنگل هیرکانی، راه آهن شمال و ساز دوتار این خطه

سعدی یکی از بزرگترین شاعران و نویسندگان ادب فارسی است که در قرن هفتم هجری (حدود قرن سیزدهم میلادی) میزیست. نام کامل او «ابومحمد مشرفالدین

تشخیص زودهنگام بیماریها همیشه نقش حیاتی در پیشگیری از عوارض آنها دارد. در این راستا، برای بیماریهایی مانند آبمروارید که بهمرور زمان بینایی افراد را

اگر فکر میکردید ارسال یک «ممنونم» بیهزینه است، بد نیست بدانید پشت هر جمله، هزاران سرور و پردازش پرمصرف فعالیت میکنند. این سرورها برای هر

به گزارش پایگاه خبری پهنه پرواز به نقل از سایت دیجیاتو دانشمندان چینی موفق به توسعه یک سیستم پوشیدنی مبتنیبر هوش مصنوعی شدهاند که میتواند جایگزین چشم شده و

چاپ هشتم کتاب «گامهای گمشده؛ پژوهشی در مبانی و مفاهیم موسیقی ایرانی» تألیف مرتضی حنانه از سوی انتشارات سروش منتشر و روانه بازار نشر شد.

وزیر میراث فرهنگی، گردشگری و صنایع دستی درباره پروژه بر زمین مانده موزه مشاهیر فارس گفت: در سفر قبلی خودبه فارس از این پروژه بازدید

سیدجعفر حمیدی، نویسنده، پژوهشگر ادبی و استاد زبان و ادبیات فارسی در ۸۹ سالگی از دنیا رفت به گزارش پایگاه خبری پهنه پرواز به نقل

متخصصان فنلاندی دریافتهاند اختلال رایجی که میلیونها نفر از آن رنج میبرند، احتمال سکته مغزیِ مرگبار را تا ۷۰ درصد افزایش میدهد. به گزارش پایگاه

زمان برگزاری سومین آزمون صلاحیت حرفهای اعضای سازمان نظام روانشناسی و مشاوره اعلام شد. به گزارش پایگاه خبری پهنه پرواز به نقل از ایسنا، سومین آزمون

اهمالکاری، یک عادت مخرب است که میتواند بر بهرهوری و سلامت روان شما تاثیر منفی بگذارد. اما نگران نباشید، راهکارهایی برای غلبه بر این مشکل

لحظه تولد یک کودک، سرآغاز عشقی بیپایان در دل مادر و پدر است؛ عشقی که گاهی آنقدر پررنگ میشود که حتی لحظهای دوری از نوزاد

همهی ما هر روز صبح در مقابل کمد لباس میایستیم و تصمیم میگیریم چه بپوشیم. گاهی این انتخاب ساده است، گاهی گیجکننده به گزارش پایگاه

علی کفاشیان به عنوان مسئول پروژه راهبردی توسعه و ارتقا رشته پارادو ومیدانی معرفی شد طی حکمی از سوی دکتر غفور کارگری رییس کمیته ملی

یک شرکت چینی توانست اولین کتابخوان الکترونیکی جهان را با امکانات قابلتوجه معرفی کند. به گزارش پایگاه خبری پهنه پرواز به نقل از زومیت ،

معاون امور توانبخشی سازمان بهزیستی گفت: ۸۴ درصد از افراد تحت پوشش سازمان بهزیستی مربوط به دهکهای ۴ به پایین هستند و ۳۰ درصد آنها

رئیس سازمان بهزیستی کشور با اشاره به رشد ۴۰ درصدی مستمری معلولان، گفت: رقم جدید از فروردین امسال پرداخت میشود. به گزارش پایگاه خبری پهنه

رمان «سرهای استفانی» نوشته رومن گاری با ترجمه ابوالفضل اللهدادی منتشر شد. به گزارش پایگاه خبری پهنه پرواز به نقل از خبرنگار خبرگزاری کتاب ایران (ایبنا)

فیلم «کاناپه» ساخته کیانوش عیاری، در ظاهر روایتی ساده از یک ماجرای خانوادگی است: پدری که برای حفظ آبروی خانوادهاش، تلاش میکند کاناپهای کهنه اما

مدیرعامل منطقه گردشگری عباسآباد که برای شرکت در اجلاس منطقهای سازمان گردشگری ملل متحد به جاکارتا سفر کرده از توافق برای میزبانی نخستین اجلاس مجمع

به مناسبت انتخاب قهرمانان جانباز و توانیاب در جمع برترینهای ورزش کشور در سال ۱۴۰۳ و کسب بیشترین جوایز جشنواره قهرمان ایران به گزارش پایگاه

میزبانی دبی از بازیهای پاراآسیایی جوانان ۲۰۲۵، یکی از موضوعات اصلی مورد بحث در این جلسه بود. به گزارش پایگاه خبری پهنه پرواز در این

افسردگی در دوران سالمندی میتواند بهدلیل مختلفی از جمله تغییرات جسمی، انزوای اجتماعی یا از دست دادن عزیزان بروز کند و زندگی فرد را تحت

تسلط بر ذهن به معنای آگاهی و کنترل بهتر از فرآیندهای ذهنی و افکار است و امکان ایجاد تغییرات مثبت در زندگی فرد را فراهم

کندوکاو در دوران کودکی همیشه راهحل درمان رنجهای امروز نیست به گزارش پایگاه خبری پهنه پرواز به نقل از سایت ترجمان، نیکلاس سرنینگ، رواندرمانگر و

چرا خاکستری میپوشیم؟ چرا بعضی از ما از مهمانی تا محیط اداری شیفته رنگ خاکستری هستیم و همیشه خاکستری میپوشیم؟ به گزارش پایگاه خبری پهنه

در دهههای اخیر، زندگی روزمره بسیاری از افراد بالای ۵۰ سال به طرز فزایندهای با فناوری دیجیتال گره خورده است. این تغییر در سبک زندگی،

معاونت میراث فرهنگی با اعلام برنامههای روز جهانی بناها و محوطههای تاریخی سال ۱۴۰۴ اطلاع داد که بازدید از موزهها، محوطهها و بناهای تاریخی زیرنظر

«بوستان سعدی» برنده جایزه بهترین اثر ترجمه شده ادبیات جهان به زبان بوسنیایی شد. به گزارش پایگاه خبری پهنه پرواز به نقل از خبرگزاری مهر،

چگونه میتوانیم با افراد پررو در زندگی خود برخورد کنیم؟ رفتار درست و اصولی با آدم های پررو باید چگونه باشد تا بتوانیم جلوی پرروی

پژوهشی تازه با نشاندادن اینکه حافظه زیستی تروما واقعی است، نتیجه میگیرد که بدن ما ممکن است اثرات تروما را حتی پس از بهبود روانی

پاراوزنهبردار کشورمان که مدال طلای پارالمپیک ۲۰۲۴ پاریس را به گردن آویخت، حرکت مسعود پزشکیان در اهدای جایزه به او را اتفاقی ماندگار توصیف کرد.

به گزارش پایگاه خبری پهنه پرواز مدیرکل دفتر امور حمایتی وزارت کار: امروز برای حدود ۲ میلیون مادر باردار، شیرده و دارای کودک زیر ۲

برترین های ورزش ایران در سال ۱۴۰۳ طی مراسمی در حضور رییس جمهور و وزیر ورزش و جوانان معرفی شدند. به گزارش پایگاه خبری پهنه

کمتر کسی در دنیا پیدا میشود که از گوش دادن به موسیقی لذت نبرد ، به همین دلیل درباره چرایی لذت بردن از موسیقی گزارشی

پیمان قانع، طراح صحنه «پایتخت۷» درباره ماجرای ساخته شدن کمپر، آوردن خرس در شبِ +۱۴ سریال «پایتخت» و پرایدی که برای اولین بار پرنده شد،

با تلاش دوستداران میراثفرهنگی، دو سنگ قبر تاریخی از دوران صفوی به موزه شهرداری نیمور منتقل شد تا به غنای فرهنگی این منطقه افزوده شود.

کیانوش عیاری از « دکتر قریب» و ایراداتی که به آن وارد شد میگوید. به گزارش پایگاه خبری پهنه پرواز به نقل از خبرگزاری خبرآنلاین،

نشست مشترک کمیته ملی پارالمپیک و مرکز پژوهشهای مجلس شورای اسلامی در خصوص توسعه فکری جنبش پارالمپیک در محل این کمیته برگزار شد. به گزارش

به گزارش پایگاه خبری پهنه پرواز به نقل از سایت «آپارات» از امروز دسترسی عمومی به سرویس ویدیوهای کوتاه، با عنوان «آپارات شورتس» را برای

جلسه کارشناسی با موضوع بررسی میزان کمک هزینه (یارانه) قابل پرداخت به مراکز غیردولتی توانبخشی و حق پرستاری معلولان،در دفتر معاونت توانبخشی سازمان بهزیستی کشور

در دنیایی که موانع گاه میتوانند ارادهها را به چالش بکشند، افرادی هستند که با وجود محدودیتهای شدید جسمی، پرواز را باور دارند. ساجده چعباوی،

جدیدترین درمان اوتیسم چیست؟ اختلال طیف اوتیسم یکی از شایعترین اختلالات عصب-رشدی است، و میزان شیوع آن همواره درحال افزایش است. اختلال اوتیسم، اختلال جدیدی در میان

به گزارش پایگاه خبری پهنه پرواز به نقل از مهر : بر اساس طب ایرانی، هر فرد با یک طبع خاص متولد میشود که بر تمام

به گزارش پایگاه خبری پهنه پرواز به نقل از خبرآنلاین، بنیاد سینمایی فارابی در سال ۱۳۶۲، با هدف بازسازی و ساماندهی به سینمای ایران پس

این تمدن که از سواحل شمالی خلیج فارس تا مناطق کوهستانی زاگرس گسترش یافت، در طول دوران باستان، نقش مهمی در توسعه فرهنگ، هنر و

فوکو، متفکر معروف علوم انسانی، خودپروری را آموختن چیزهایی میداند که به ما امکان میدهد در برابر رخدادها، حوادث ممکن و ناملایمات پیشرو تاب بیاوریم،

طاهره ایبد میگوید: «کتابهای کودک پر از فریادند؛ فریادهایی از جنس هیجان، شادی، ترس، خشم، هشدار، اعتراض… آنها به کودکان حق میدهند احساس کنند، بترسند،

مراسم اختتامیه جشنواره «قهرمان ایران» چهارشنبه ۲۷ فروردین ساعت ۱۹:۳۰ در مرکز همایش های صدا و سیما برگزار خواهد شد. به گزارش پایگاه خبری پهنه

یکی از شایعترین مشکلات روانشناختی نوجوانان و جوانان افسردگی است؛ اختلالی که در صورت درمان نکردن، عملکرد اجتماعی، تحصیلی، شغلی و اجتماعی افراد را مختل

به گزارش پایگاه خبری پهنه پرواز به نقل از روابط عمومی سازمان بهزیستی کشور, یارانه کمک معیشتی مرحله ١٧٠ مربوط به فروردین ماه 1404 به

کمیته برگزاری بازیهای میلان و کورتینا ۲۰۲۶، از مشعلهای رسمی این دو رویداد رونمایی کرد. به گزارش پایگاه خبری پهنه پرواز به نقل از روابط

به گزارش پایگاه خبری پهنه پرواز به نقل از معاون وزیر آموزش و پرورش:افزایش درصدی شهریه به صورت یکنواخت برای مدارس و مراکز غیر دولتی

در دنیای امروز، اعطای پولتوجیبی به فرزندان موضوعی چالشبرانگیز است. آیا پولتوجیبی به آنها کمک میکند ارزش پول را درک کنند و مسئولیتپذیر شوند، یا

مدرسه، به شکل سنتی، در حال فروپاشی است. اما این به معنای پایان آموزش نیست. آینده آموزش به سوی مدلهای خلاقانه، هوشمند و شخصیسازیشده حرکت

لار شهری از استان فارس است که زلزله آن را با خاک همرنگ کرده و در منطقه ای کوهستانی، حال و هوای شهرهای جنوبی را

آشفتگی ذهنی میتواند زندگی را فلج کند. در این مقاله، نویسنده تجربه شخصی خود از مواجهه با بحران ذهنی و سه راهکار ساده اما مؤثر

سرپرست مرکز توسعه کارآفرینی، اشتغال و توانمندسازی سازمان بهزیستی گفت: در حوزه کمکهزینه درمان، برای افراد زیر ۱۸ سال تحت پوشش سازمان بهزیستی، کل هزینهها

ملی پوشان تیم #گلبال جوانان برای برگزاری پنجمین مرحله از تمرینات خود وارد بابلسر شدند. به گزارش پایگاه خبری پهنه پرواز به نقل از روابط

چهارمین نشست شورای عالی فنی کمیته ملی پارالمپیک به میزبانی این کمیته برگزار شد. به گزارش پایگاه خبری پهنه پرواز به نقل از روابط عمومی

هفدهمین نمـایشگاه نقــاشی شاگردان تارا بهبهانی با آثاری از 66 هنرمنـدکـودک و نوجــوان با عنوان “سرزمین جدید” به مدت دو روز ۳۰ و ۳۱ فروردین

به گزارش پایگاه خبری پهنه پرواز، بخارا یکی از دو شهر بزرگ تاجیک نشین و فارسیزبان ازبکستان است.مردم بخارا تا امروز نیز به زبان فارسی با گویش ویژه آسیای

به گزارش پایگاه خبری پهنه پرواز به نقل از رئیس شورای اسلامی شهر تهران: افراد در شهرهای دور و نزدیک معاینه فنی میگیرند و در

گزارش اختصاصی از پایگاه خبری پهنه پرواز – پنجشنبه ۲۱ فروردین ۱۴۰۴ در فضایی آکنده از شور، نشاط و صمیمیت، جشن ویژهای با محوریت آموزش،

آثار «زن گریان» و «تروماکیا» روی دیوارهای موزه هنرهای معاصر قرار گرفت به گزارش پایگاه خبری پهنه پرواز به نقل از هفت صبح | این روزها

کتابها در فیلمها نهفقط ابزار مطالعه که نشانههایی از شخصیتپردازی، درونمایههای فلسفی و حتی عنصر محرک روایت هستند. به گزارش پایگاه خبری پهنه پرواز به

هولوگرامهای آیندهنگرانه که لمسشدنی و قابل دستکاری هستند، به لطف فناوری آزمایشی جدید محققان، زودتر از آنچه فکر میکردیم به واقعیت تبدیل شدند. به گزارش

به گزارش پایگاه خبری پهنه پرواز به نقل از میراث آریا، قلعه آکروپل شوش، بنایی جذاب با قدمتی بیش از ۱۲۰ سال، نهتنها بخشی از

انتشارات نشر «نی» تازهترین کتاب خود را در قالب ترجمه «انبارشدگان» منتشر کرد. به گزارش پایگاه خبری پهنه پرواز به نقل از خبرنگار خبرگزاری کتاب ایران (ایبنا)، انبارشدگان

به گفته یکی از مسئولین سازمان بهزیستی : در مورد واریز 840 و 532… که چند روز پیش به حساب رفاه مددجویان واریز گردید. بنا

کودکان دارای این اختلال در یادگیری و یادآوری #اعداد مشکل دارند و نمیتوانند واقعیات پایه مربوط به اعداد را به خاطر بسپارند و در #محاسبه

رقابتهای پاراشنا سری جهانی ژاپن با کسب ۵ مدال رنگارنگ برای تیم ملی کشورمان به پایان رسید. به گزارش پایگاه خبری پهنه پرواز به نقل

مضاعفدوزی، یک نوع رودوزی یا دوخت بخیهایِ دو مرحلهای است؛ که بر روی هم دوخته میشوند. مضاعف، در معنای لغوی، یعنی «دو برابر شده» یا

رقابتهای پاراشنا سری جهانی ژاپن با کسب ۵ مدال رنگارنگ برای تیم ملی کشورمان به پایان رسید. به گزارش پایگاه خبری پهنه پرواز به نقل


چین به تازگی اولین مرکز آموزش رباتهای انساننما را راهاندازی کرده است؛ یک مرکز 5 هزار متر مربعی در شانگهای که بیش از 100 ربات

او خودش را در آینده تصور میکند: پیر، ثروتمند، با زندگیای آرام در عمارت یا ویلایی دلخواه. سپس فکر میکند که این نسخهٔ مسن برای

مطالعه جدید نشان میدهد کمبود خواب عمیق و REM با کاهش حجم مغز و افزایش خطر آلزایمر مرتبط است. محققان نوشتند که به نظر میرسد

خاموش کردن اینترنت موبایل، شاید راهی برای جوانسازی مغز باشد در این پژوهش، شرکتکنندگان با کمک یک اپلیکیشن مخصوص، دسترسی به اپلیکیشنها، مرورگر اینترنت و

همه ما یه وقتایی تو فکرای بیخود و تکراری گیر میکنیم، مگه نه؟ این فکرا مثل یه مهمون ناخونده میمونن که آرامشمون رو به هم

به گزارش پایگاه خبری پهنه پرواز براساس آمار مرکز ملی مطالعات و تحقیقات دریای خزر، سطح آب این دریا از سال ۱۳۷۵ تاکنون ۲ متر

در حاشیه رقابتهای سری جهانی پاراشنا ۲۰۲۵ در فوجی ژاپن، دکتر علی رغبتی، سرپرست تیم اعزامی ایران با “کاوای جونیچی”، رئیس فدراسیون پاراشنای ژاپن (JPSF)،

ما غالباً نمیتوانیم زمان و شیوۀ عاشق شدن خود را تعیین کنیم. عشق معمولاً ناگهانی و بیخبر از راه میرسد، اما برای این که بتوانیم

پارکينسون، يک بيماری است که در اثر افزايش سن بروز می کند. روز جهانی پارکينسون در ۱۱ آوريل به منظور ايجاد آگاهی در مورد اين

طراح ، گرافیست و تدوینگر طراح گرافیک و تبلیغات با تجربه در طراحی لوگو، پوسترهای تبلیغاتی، سینمایی و تئاتر، تدوین تیزر، اصلاح رنگ و صداگذاری

دیابت مادر در دوران بارداری با افزایش خطر اختلالات رشد عصبی در کودکان، از جمله اوتیسم، مرتبط است؛ این نتیجهٔ پژوهشی گسترده است که دادههای

موشهای درونگرا برخلاف دوستان جسورتر خود، به احتمال زیاد به طور مکرر وظایف حل مساله را مرور میکنند. به گزارش پایگاه خبری پهنه پرواز به

نهال تجدد با نگاهی شاعرانه و با بهرهگیری از تجربههای شخصیاش در دوری از وطن، روایتی از عشق، غربت و اشتیاق به زندگی را ارائه

٧٩ هزار و چهارصد میلیارد ریال مستمری مددجویان تحت پوشش کمیته امداد و بهزیستی واریز شد. به گزارش پایگاه خبری پهنه پرواز به نقل از

بررسی و ارزیابی همه چیز درباره درد لگن سمت چپ علتها درد لگن و پای چپ درد در ناحیه لگن و پای چپ یکی از مشکلات رایج است که بسیاری از

به گزارش پایگاه خبری پهنه پرواز بر اساس نتایج یک تحقیق جدید، مغز انسان بهطور تدریجی و خطی پیر نمیشود، بلکه در دورههای مختلف به

به گزارش پایگاه خبری پهنه پرواز به نقل از روابط عمومی فدراسیون ورزش های جانبازان و توان یابان، نخستین المپیاد ملی علمی-مهارتی دانشجویان دارای معلولیت،

به گزارش پایگاه خبری پهنه پرواز به نقل از ایسنا/خوزستان در پی برگزاری موفق برنامههای نوروزی ۱۴۰۴ در استان خوزستان، وزیر میراث فرهنگی، صنایع دستی و

به گزارش پایگاه خبری پهنه پرواز مسابقات المپیک دانشآموزی (ژیمنازیاد) در صربستان درحال برگزاری است و در رشته پارادوومیدانی در ماده پرتاب نیزه، هستی شکوری

ظریف پور و ضیغمی نژاد موفق به کسب سهمیه رقابت های قهرمانی جهان شدند / راهیابی ملی پوشان پاراشنا به فینال مسابقات رقابتهای جهانی پاراشنا

۸۵ تا ۹۰ درصد دانش آموزان دیگر هیچ انگیزهای برای یادگیری این محتواها ندارند. مدارس ما از تحولات جهانی عقب افتادهاند. در حالی که جهان

به گزارش پایگاه خبری پهنه پرواز به نقل از دیجیاتو ، در بیشتر کشورها، اگر در محل کار چرت بزنید یا بخوابید، ممکن است

محققان به تازگی دریافتهاند که پرش ذهنی هنگام انجام کارهایی که نیاز به تمرکز زیادی ندارند میتواند به تقویت یادگیری کمک کند و بر خلاف

به گزارش پایگاه خبری پهنه پرواز به نقل از ایرنا- یک نویسنده با تاکید به اینکه «شیوه نوشتن» و «نوع روایت» در ادبیات کودک و

سخنگوی طرح کالابرگ: مرحلۀ دوم برای دهکهای درآمدی یک تا ۳ هر نفر ۵۰۰ هزار امروز واریز میشود و فردا قابل خرید است. به گزارش

به گزارش پایگاه خبری پهنه پرواز، ثبتنام اصحاب رسانه و فعالان فضای مجازی برای حضور در سیوششمین نمایشگاه بینالمللی کتاب تهران از امروز (بیستم فروردینماه)

نوروز ۱۴۰۴ دوربین فعالان میراث فرهنگی در یکی از شبستانهای مسجد جامع قزوین عکس شوکآوری را ثبت کرده است که گفته میشود به فیلمبرداری سریال

مدالهای تاریخی پارادومیدانی/ یک نقره و سه برنز نصیب کاروان ایران شد به گزارش پایگاه خبری پهنه پرواز به نقل از روابط عمومی کمیته پارالمپیک،

تغذیه در بیماری آرتروز مانند همه بیماریهای دیگر اهمیت زیادی دارد و نمیتوان این اصل را کتمان کرد. برای کسی که با مشکل آرتروز مواجه

فکر میکنید حواسپرتی یک عادت بد است؟ دوباره فکر کنید. تحقیقات جدید نشان میدهد که خیالپردازی و سرگردانی ذهنی ممکن است ابزار پنهانی مغز برای

خوابیدن برای کودکان گاهی شبیه یک ماجراجویی بزرگ است؛ سفری به سرزمین رویاهایی که با قصههای جذاب و آرامشبخش آغاز میشود. به گزارش پایگاه خبری

معاون سلامت اجتماعی سازمان بهزیستی کشور با بیان اینکه اکنون ۲۸۰ هزار و ۵۰۰ زن سرپرست خانوار تحت پوشش این سازمان هستند، گفت: حمایت از

یکی از معماهای بزرگ تاریخ ایران باستان تفاوت میان مقبره کوروش کبیر با دیگر شاهان هخامنشی بعد از خود است، تفاوتی که بحث و جدلهای

هر ساله نزدیک به نیم میلیون نفر در سراسر جهان بر اثر آنوریسم مغزی جان خود را از دست میدهند. به گزارش پایگاه خبری پهنه

آیا تا به حال متوجه شدهاید که گاهی اوقات، علیرغم تصمیمگیریهای قاطع، باز هم در دام عادتهای قدیمی میافتید؟ مثلاً با خود عهد میکنید که

به گزارش پایگاه خبری پهنه پرواز به نقل از منابع مطلع، تغییرات زیستمحیطی پیشبینینشده در منطقه خلیج فارس، پایههای برج خلیفه – بلندترین سازه جهان

نخستین مرحله اردوی آمادگی تیم ملی با دعوت از 20 پاراتیرانداز برگزار می شود. به گزارش پایگاه خبری پهنه پرواز به نقل از روابط عمومی

معاون اول رئیس جمهور آئین نامه ساماندهی معافیت بیمهای اقشار مختلف که چهار دهک درآمدی پایین جامعه را در بر می گیرد، ابلاغ کرد. به

دکتر غفور کارگری، رئیس کمیته ملی پارالمپیک، با صدور پیامی، شهادت جانباز گرانقدر و مدال آور سه دوره بازیهای پارالمپیک، زندهیاد عوض آزموده را تبریک

در جهانی که گاه چالشها میتوانند سد راه پیشرفت باشند، افرادی هستند که با ارادهای آهنین و عشقی بیپایان به زندگی، نهتنها از سد این

به گزارش پایگاه خبری پهنه پرواز به نقل از ایرنا – مدیرکل بهزیستی مازندران گفت که هم اکنون ۲۴۰ کودک مبتلا به بیماری اوتیسم از

مدیرکل میراث فرهنگی، گردشگری و صنایع دستی آذربایجان غربی گفت: تخت سلیمان تکاب در ایام تعطیلات نوروزی میزبان بیشترین گردشگر و مسافر نوروزی شد. به

اگر دنبال انگیزه هستید، با هدفی کوچک شروع کنید و بدون معطلی وارد عمل شوید؛ قدرت و انگیزه در مسیر شکل میگیرند. به گزارش پایگاه

رئیس سازمان بهزیستی کشور با اشاره به اجرای «طرح توانمندسازی و فرصتآفرینی» گفت: با اجرای این طرح در شش ماه گذشته، گام بلندی در راستای

این حجاببانها به حدی در کار خود سختگیر بودند که حتی در مواردی با مردم درگیر شدند و فیلمهای منتشرشده از چهلستون اصفهان نشان داد

نوید انصاری معلول جسمی حرکتی شدید رکورد جدید خود که جابهجایی کامیون با ویلچر بود را به نام خود ثبت کرد. به گزارش پایگاه خبری

به گزارش پایگاه خبری پهنه پرواز به نقل از مرکز مستند سینمای ایران، مستند سینمایی «شگرد» به کارگردانی و تهیهکنندگی جعفر صادقی، محصول مرکز مستند

دومین مرحله از اردوی آمادگی و انتخابی تیم ملی #پاراوزنه_برداری بانوان از ۲۰ فروردین ماه آغاز می شود. به گزارش پایگاه خبری پهنه پرواز به

ملی پوشان پاراوزنه برداری جوان در راستای کسب آمادگی برای بازی های پاراآسیایی 2025 تمرینات خود را آغاز می کنند. به گزارش پایگاه خبری پهنه

مطالعهای جدید نشان میدهد که فعالیت بدنی، رژیم غذایی و کیفیت خواب نهتنها بر حافظه و توجه، بلکه بر فراشناخت—توانایی نظارت و کنترل فرآیندهای فکری—نیز

همه ما روزهایی را تجربه کردهایم که افکارمان همچون طوفانی در ذهنمان میچرخند و تمرکز کردن را برایمان سخت میکنند. به گزارش پایگاه خبری پهنه

در سال ۱۴۰۴، سطح پوشش هزینههای درمان از ناحیهی دولت و صندوقهای بیمهگر کاهش مییابد و طبیعتاً کسری این هزینهها باید از جیب مردم پرداخت

به گزارش پایگاه خبری پهنه پرواز به نقل از ایرنا- کتاب «هنرِ هوشِ مصنوعی» مباحث بنیادین مربوط به هنر و خلاقیت از دیدگاه هوش مصنوعی

باستانشناسان با کاوش در شهر باستانی «پمپئی» (معروف به شهر سوخته در ایتالیا)، مجسمه یک کاهن را کشف کردند. به گزارش پایگاه خبری پهنه پرواز

به گزارش پایگاه خبری پهنه پرواز به نقل از دکتر فوت ، دیابت یکی از شایع ترین بیماری های مزمن متابولیکی در جهان است که میلیون

دانشمندان دریافتهاند که با افزایش سن، بدن توانایی خود را در پاکسازی مواد زائد مغز از دست میدهد. این وضعیت ممکن است در ایجاد بیماریهایی

ابوالقاسم خوشرو عکاس ایرانی به عنوان ۱۰ عکاس برتر در شاخه مینیمالیسم مفهومی در یک مسابقه جهانی انتخاب شد. به گزارش پایگاه خبری پهنه پرواز

علی پازوکی رئیس هیات استان تهران بهمراه اعضای هیات رئیسه با مصطفی نکولعلآزاد رییس و دیگر مسؤلین فدراسیون، دیدار و گفتگو کردند به گزارش پایگاه

به گزارش پایگاه خبری پهنه پرواز به نقل از روابط عمومی کمیته ملی پارالمپیک؛ در جریان معرفی و تجلیل از برگزیدگان جایزه روز جهانی زن

مرکز توانبخشی و آموزشی نابینایان و کمبینایان خزانه، تنها مرکز جامع ارائه خدمات تخصصی به افراد دارای آسیب بینایی در استان تهران، با همت مجدد

شعار امسال (2024) روز جهانی بهداشت «سلامت من ، حق من» (My health، my right) است. به گزارش پایگاه خبری پهنه پرواز به نقل از

اردوی تیم ملی دوومیدانی جانبازان و توان یابان در رده جوانان به صورت غیر متمرکز برگزار می شود. به گزارش پایگاه خبری پهنه پرواز به

تیم ملی پاراشنا برای حضور در رقابت های جهانی راهی کشور ژاپن شد. به گزارش پایگاه خبری پهنه پرواز به نقل از روابط عمومی فدراسیون

به گزارش پایگاه خبری پهنه پرواز به نقل از روابط عمومی سازمان بهزیستی، تعدادی از افراد دارای معلولیت میتوانند برای خودروهای سواری، پلاک ویژه دریافت

سازمان ملل هشدار میدهد که هوش مصنوعی میتواند تا سال ۲۰۳۳ حدود ۴۰ درصد مشاغل جهان را تحت تاثیر قرار دهد، با این حال، این

مایکل لوین معتقد است هوشیاری یک طیف است و آنچه ما به عنوان هوشیاری میشناسیم ممکن است در سلولها یا هوش مصنوعی به شکل کاملاً

بیش از 100 سال است که پلیس به کمک اثر انگشت جنایتکاران را تشخیص میداد و تصور این بود که اثر انگشت هر فرد کاملا

اولین مرحله اردوی تیم ملی پاراکانو در سال ۱۴۰۴، از فردا در تهران آغاز میشود. به گزارش پایگاه خبری پهنه پرواز به نقل از روابطعمومی

زندگی برخی انسانها چنان الهامبخش است که تنها شنیدن بخشی از مسیرشان، میتواند چراغی روشن در دل دیگران بیفکند. مهدی ملکی یکی از همین افراد

به گزارش پایگاه خبری پهنه پرواز بنای تاریخی منارجنبان اصفهان، مربوط به قرن ۸ هجری قمری، با معماری منحصربهفرد و پدیده جذاب تکان خوردن منارهها،

به گزارش پایگاه خبری پهنه پرواز به نقل از فرارو- عطار نیشابوری، در تذکرهالاولیا، از ابو یزید بسطامی بهعنوان یکی از بزرگترین وادیپیمایان حقیقت یاد

آزادی یکی از مفاهیم بنیادی در فلسفه و حقوق بشر است که از دیرباز مورد بحث اندیشمندان قرار گرفته. هر فیلسوف تعریفی خاص از آن

«اگر شازده کوچولو بودی با چه کسی ملاقات میکردی؟» عنوان یک مسابقه داستاننویسی است که از سوی نوین کتاب برگزار میشود تا علاقهمندان روایتهای تازه

آلفرد هیچکاک، نابغهی سینمای تعلیق، همیشه با فیلمهایش ذهن مخاطب را به چالش کشیده است. او نهتنها وحشت و هیجان را در ژانر تریلر بازتعریف

چرا مطالعه رمان برای نوجوانان مهم است به گزارش پایگاه خبری پهنه پرواز به نقل از آژانس کتاب، نوجوانی دورهای پر از تغییرات، چالشها و

یکی از بازیها که به #حافظه افراد و #دانش_آموزان کمک میکند، بازی با افزایش کلمات است. به گزارش پایگاه خبری پهنه پرواز به نقل از

مراسم تجلیل از قهرمانان و مدال آوران جانباز و توان یاب استان هرمزگان برگزار شد. به گزارش پایگاه خبری پهنه پرواز به نقل از روابط

به گزارش پایگاه خبری پهنه پرواز ، محققان دانشگاه استراليا چشم بیونیکی اختراع کرده اند که به كم بينايان كمك مى كند تا بهتر ببينند.

کارگردان مستند «بر کرانههای کاسپین» معتقد است این اثر برای همه ایرانیها مناسب است تا به اهمیت حفاظت از محیط زیست پی ببرند. به گزارش

برخلاف تصور کلیشهای رایج که زوال عقل را با استفاده از فناوریهای مدرن ناسازگار میداند، تحقیقات جدید دانشگاه بَث در انگلیس نشان داد که افراد

علامت مساوی نخستین بار در سال ۱۵۵۷ میلادی توسط رابرت رکورد، ریاضیدان ولزی، معرفی شد. اما مفهوم «برابری» در ریاضیات از همان ابتدا پیچیدگیهایی داشت

تاثیر مستقیم ِ احساسی که به بدن مان داریم یا همان خودآگاهی بدنی، بر کیفیت زندگی و سلامت روان مان شگفت انگیز است. شاید باورش

گروهی از پژوهشگران نشان دادهاند هوش مصنوعی از پس کار بسیار سادهای که حتی دانشآموز کلاس دوم میتواند انجام دهد، برنمیآید. به گزارش پایگاه خبری

۲ آوریل روزی است که جهان برای افزایش آگاهی درباره اوتیسم و حمایت از افراد دارای این شرایط متحد میشود. سازمان ملل از سال ۲۰۰۷

سازمان ملل متحد هر ساله دوم آوریل را به عنوان روز جهانی آگاهی از اوتیسم گرامی میدارد و با برگزاری برنامههای متنوع، بر اهمیت حمایت از افراد دارای

پروژه تولید مدالهای بازیافتی برای بازیهای آسیایی و پاراآسیایی آیچی-ناگویا ۲۰۲۶ آغاز شد. به گزارش پایگاه خبری پهنه پرواز به نقل از خبرگزاری مهر و به

سامسونگ احتمالاً در سال ۲۰۲۵ عینک هوشمند اندرویدی خود با دوربین ۱۲ مگاپیکسلی را عرضه میکند. به گزارش پایگاه خبری پهنه پرواز به نقل از

به گزارش پایگاه خبری پهنه پرواز جشنواره «نور تهران» با هدف زیباسازی فضای شهری و ایجاد محیطی پرنشاط برای شهروندان و مسافران نوروزی در «پارک

شاید فکر کنید که دیابت و افسردگی دو بیماری کاملاً مجزا از هم هستند، اما حقیقت این است که این دو مشکل سلامتی بهطور عمیق به هم مرتبطاند. آیا

«ارزانخورها» رمانی نوشتهی توماس برنهارد، یکی از نویسندگان جنجالی قرن بیستم است. او در سال ۱۹۳۱ در هلند متولد شد، اما در اتریش بزرگ شد.

کهگیلویه و بویراحمد- در دل شهر سوق، آرامگاهی وجود دارد که نهتنها یادبودی برای یک هنرمند، بلکه نمادی از پیوند عمیق مردم با ادبیات و

در حالی که مردم نسیمشهر هنوز از تبعات پایانه حملونقل کالا و ترافیک فلجکننده آن رنج میبرند، گزارشها از تحویل زمینهای اوقافی در مسیر پرتردد

جیسون استاتهام بار دیگر با کارگردان فیلم «زنبوردار» همکاری کرده است که فیلمنامه آن را سیلوستر استالونه نوشته است. به گزارش پایگاه خبری پهنه پرواز

معاون وزیر تعاون، کار و رفاه اجتماعی و رییس سازمان بهزیستی گفت: افزون بر ۱۱ درصد جمعیت کشور معادل ۱۰ میلیون نفر، بر طبق پیمایش

فلاح میگوید: مفهوم «دیپلماسی کودک و نوجوان» بهعنوان یک ظرفیت گفتمانی در تعاملات بینالمللی نقشآفرینی میکند. به گزارش پایگاه خبری پهنه پرواز به نقل از

باغ عمارت مسعودیه در گذشته به دستور مسعودمیرزا ملقب به ظلالسلطان فرزند ناصرالدین شاه قاجار در سال ۱۲۹۵ هجری قمری (۱۲۵۷ خورشیدی) در زمینی به

سنین نوجوانی با تب و تاب و فراز و نشیب در اخلاق و رفتار همراه است؛ دورهای که بیش از هر زمان دیگر در برابر

مهمترین راز کاریزما این است که خودتان باشید، اما روی بهترین ویژگیهای خود کار کنید و آنها را بهبود دهید. به گزارش پایگاه خبری پهنه

دارو های خوراکی کاهش دهنده قند خون اثربخشی بالا با کمترین عوارض، بهترین قرص قند را پیدا کنید! دیابت یکی از بیماریهای مزمن و شایع است

اوتیسم یک اختلال عصبی است که بر تعامل اجتماعی و کارکردهای ترتیبی تأثیر میگذارد. این اختلال در طیف وسیعی از شدتها و نمونهها ظاهر میشود.

رئیس اداره میراث فرهنگی، گردشگری و صنایعدستی شهرستان دامغان از برگزاری آیین کهن و مذهبی کیسهدوزان دامغان در مسجد تاریخانه این شهر خبر داد. به

هوش اجتماعی (SQ) چیست و چگونه میتوان آن را تقویت کرد؟، عنوان موضوعی است که در این پست به آن خواهیم پرداخت به گزارش پایگاه

فیلم همنشین (Companion) اثری جنایی و علمیتخیلی است که روایت عاشقانهای را همراه خود دارد. با نقد این فیلم همراه زومجی باشید. به گزارش پایگاه

از گذشته تا کنون، کتاب کودک از مهمترین ابزار برای کمک به خلاقیت، مهارت و هویتبخشی آنهاست، بهطوری که همواره یکی از دغدغههای خانوادههای فرهیخته،

به گزارش سرویس گردشگری ساعد نیوز، کاخ مرمر یکی از زیباترین و ارزشمندترین جاهای دیدنی تهران محسوب میشود که در مرکز شهر جا خوش کرده

ویتامین B12 برای رشد و عملکرد بافت عصبی و مغز و برای تشکیل گلبولهای قرمز خون و DNA مورد نیاز است. به گزارش پایگاه خبری

خودکاوی یعنی یک گام به عقب برداشتن و ارزیابی زندگی، رفتارها و باورهای خودتان ، فرایند فکر کردن به رویدادهای گذشته و تفسیر آنها از

غلبه بر خشم ناگهانی، فقط به ارادهی لحظهای وابسته نیست، بلکه نیازمند آمادگی ذهنی در طول روزها و هفتههاست. بسیاری از ما سالها تمرین صبوری

امروز، شنبه ۹ فروردین ۱۴۰۴ (۲۹ مارس ۲۰۲۵)، یک خورشیدگرفتگی جزئی رخ خواهد داد که نخستین خورشیدگرفتگی سال ۲۰۲۵ و سال جدید خورشیدی محسوب میشود.

معلولیت مسیری متفاوت برای رسیدن به موفقیت است. بسیاری از افراد دارای معلولیت با تلاش و پشتکار توانستهاند بر چالشهای پیش روی خود غلبه کرده

به گزارش پایگاه خبری پهنه پرواز به نقل از ایرنا- پنج کیلومتر به سمت جنوب تربتحیدریه قلعه به نسبت بزرگی در مجاورت کویر متصل به

ایران با ثبت ۱۱ شهر و ۳ روستا در فهرست جهانی صنایعدستی، جایگاه خود را بهعنوان یکی از مهمترین مراکز تولید و توسعه صنایعدستی در